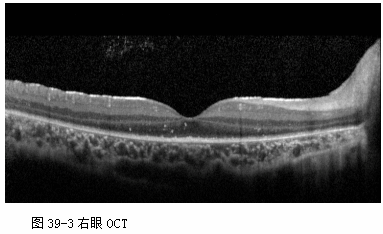
ZY016_211_4.gif

测试题目和答案
案例分析题
问题 1176
患者,男性, 28岁,主诉“双眼先后眼红、畏光、流泪、异物感9天, 左眼视力下降2天”。患者半月前曾至公共浴室洗浴,其后出现左眼红, 流泪,异物感等症状, 无明显分泌物,2天后右眼亦出现同样症状, 去医院就诊为“急性结膜炎”,予以局部抗病毒、抗生素滴眼液治疗, 但病情进一步发展,而且左眼出现视力下降, 遂至我院就诊。
既往史:
全身疾病: 否认高血压、糖尿病等。
外伤手术史:无。
过敏史: 否认。
查体:
眼科专科检查如表1-1所示。




辅助检查: 无。
【问题1】
该患者的诊断及诊断依据
【问题2】
还需要与哪些疾病相鉴别?
【问题3】
该患者的处理方案及基本原则
答案:
1.诊断和诊断依据
(1)半月前曾至公共洗浴中心洗浴。
(2)洗浴五天后双眼先后眼红、流泪、畏光。无明显分泌物。
(3)眼科检查睑结膜、球结膜充血,睑结膜假膜形成。
(4)耳前淋巴结肿大
(5)发病1周后左眼角膜中央上皮下散在数枚圆形灰白色浸润。
基于以上几点分析:流行性角结膜炎诊断成立。
2.鉴别诊断
(1)症状的鉴别诊断。
①眼红:常见于结膜炎、角膜炎、葡萄膜炎、巩膜炎,等等。流行性角结膜炎引起的眼红多伴明显流泪,无明显分泌物。
②流泪:泪道阻塞性疾病。各种结膜炎,眼睑倒睫、各种原因导致的角膜上皮剥脱,角膜异物,角膜炎均会造成流泪。流行性角膜炎多双眼先后发病,伴明显眼红,且无明显的分泌物。
(2)流行性角结膜炎的鉴别诊断。
①急性卡他性结膜炎:急性卡他性结膜炎是细菌感染引起的急性结膜炎。潜伏期较流行性角结膜炎短,其潜伏期大约为1~2天。症状上与流行性角结膜炎最主要的区别在于其分泌物多,呈黏液脓性,常于晨起时将上下睑粘住,另一方面该病不会产生角膜上皮下的圆形浸润,因而视力不受影响。
②流行性出血性结膜炎:流行性出血性结膜炎是微小RNA病毒感染而引起的急性结膜炎。该病起病最急,往往在接触传染源后的24小时左右即发病,有少量粘性分泌物,结膜下可伴有出血,一般不产生角膜病变。
3.处理方案及基本原则
本病为传染性疾病故治疗时首先要嘱患者做好隔离,避免传染他人。此外该病为自限性疾病,缺乏特效治疗方法,治疗目的主要是缓解患者眼部不适症状。若睑结膜假膜形成需擦除,以避免假膜对角膜上皮的摩擦和减轻眼部刺激症状,局部药物可使用人工泪液、抗病毒药物以及为防止继发感染和混合感染而使用抗生素滴眼液。若眼部刺激症状显著或角膜上皮下浸润影响视力可酌情使用低浓度的局部皮质类固醇滴眼液。
问题 1178
现病史:
患者, 女性,54岁, 主诉“左眼红痛、视力下降1月”。1月前清洗抽油烟机时不慎污水溅入左眼,后出现眼红、眼痛、视力下降。曾于当地医院就诊, 诊为角膜炎,予可乐必妥眼水, 托百士眼水,更昔洛韦滴眼液频点, 但病情未见明显好转,今为求进一步诊治来我院门诊。
既往史:
全身疾病:否认高血压、糖尿病等。
外伤手术史: 1月前污水溅入左眼,否认手术史。
过敏史: 否认
用药史:眼部用药见现病史, 否认全身用药
查体:
眼科专科检查如表3-1所示。




辅助检查:
(1)角膜刮片:未找到细菌及真菌菌丝, 见棘阿米巴包囊(图3-3)。

(2)角膜共聚焦显微镜检查:见棘阿米巴包囊(图3-4)。

(3)细菌培养、真菌培养(—)。
【问题1】
该患者的诊断及诊断依据
【问题2】
还需要与哪些疾病相鉴别?
【问题3】
该患者的处理方案及基本原则
答案:
1.诊断和诊断依据
(1)左眼红视力下降伴明显眼痛1月。
(2)发病前污水溅入史。
(3)角膜病变呈现基质环形浸润。
(4)经局部抗生素、抗病毒药物治疗无效。
(5)角膜刮片、角膜共聚焦显微镜检查发现棘阿米巴包囊。
基于以上几点分析:左眼棘阿米巴角膜炎诊断成立。
2.鉴别诊断
(1)症状的鉴别诊断。
①眼痛:各种原因导致的角膜片状剥脱,例如外伤、大泡性角膜病变;角膜异物;各种感染性角膜炎均会造成眼痛。但是由于棘阿米巴的神经亲和性,约有一半的患者会在发病早期即表现为与体征不相符的神经痛。
②眼红:常见于结膜炎、角膜炎、葡萄膜炎、巩膜炎,等等。但感染性角膜炎引起的眼红均伴有角膜病变。
(2)棘阿米巴角膜炎的鉴别诊断。
①单疱病毒性角膜炎:单疱病毒性角膜炎上皮病损常常有典型的末端膨大的树枝样形态,进一步发展可以成地图状,角膜荧光素染色可清晰显示病灶的形态,而棘阿米巴角膜炎上皮的病损并无这些特点。但是有时二者鉴别较为困难,对于感染性角膜炎应及早进行病原学检查,对于治疗效果不佳的病毒性角膜炎要考虑到棘阿米巴角膜炎的可能。
②细菌性角膜炎:细菌性角膜炎一般起病急,发展快,角膜刮片细菌涂片和培养可明确诊断,对抗生素治疗反应好。
③真菌性角膜炎:真菌性角膜炎多有外伤史,例如植物外伤史,病程发展相对于细菌性角膜炎要缓慢,角膜病灶刮片、共聚焦显微镜检查可以发现菌丝结构。
3.处理方案及基本原则
本病以局部药物治疗为主,基本原则是局部频繁使用抗棘阿米巴原虫的药物,并保证足够的疗程和患者的依从性。若药物治疗无法控制,角膜频临穿孔可以行治疗性穿透性角膜移植术。
(1)抗阿米巴药物治疗:目前抗阿米巴的药物较少,缺乏市售药物,临床使用的药物多为各单位自行配制的。棘阿米巴角膜炎的药物治疗应及早、足量并持续长期用药才能取得较好的治疗效果。目前临床常用的抗阿米巴药物包括:0.02%洗必泰和0.2%甲硝唑滴眼液,治疗初期可以每30min~1h滴眼,病情控制后可酌情减量至每1h~2h滴眼,治疗期间应密切随访,合理使用共聚焦显微镜观察病情转归,治疗应保证足够疗程,一般治疗应维持3~6个月。由于棘阿米巴角膜炎可合并细菌感染,治疗时可联合使用局部抗生素滴眼液。
(2)手术治疗:棘阿米巴角膜炎手术治疗效果欠佳,术后复发可能性大,一般仅在药物治疗病变无法控制,角膜频临穿孔时可以行治疗性穿透性角膜移植术。术后继续联合抗阿米巴药物治疗,早期禁用皮质类固醇激素。
问题 1180
现病史:
患者, 女,69岁, 主诉“双眼异物感8月余”。8月患者在当地医院就诊为“双眼真菌性角膜炎”,开始频点那他霉素, 逐渐出现双眼异物感,伴眼红、畏光, 无分泌物增多,无虹视, 无眼胀等,且未曾停用那他霉素, 遂来我院就诊。
既往史:
眼部: 否认眼部疾病史。
全身疾病:否认高血压、糖尿病等。
外伤手术史: 否认
过敏史:否认
查体:
眼科专科检查如表5-1所示。




辅助检查:
荧光素染色: 如图5-3、图5-4所示。


泪液分泌实验:右眼12mm/5min, 左眼10mm/5min
【问题1】
该患者的诊断及诊断依据
【问题2】
还需要与哪些疾病相鉴别?
【问题3】
该患者的处理方案及基本原则
答案:
1.诊断和诊断依据
(1)双眼异物感8月余;
(2)8月前外院曾诊断“双眼真菌性角膜炎”,经那他霉素频滴(次数不详),且持续8月;
(3)经停那他霉素,并给予玻璃酸钠眼液(无防腐剂)、0.1%氟美瞳眼液、小牛血清蛋白凝胶治疗后,角膜基质浸润及上皮损伤有明显好转;
(4)辅助检查:荧光素染色明确角膜上皮修复明显改善。
基于以上几点分析:“双眼药物毒性角膜炎”诊断成立。
2.鉴别诊断
(1)症状的鉴别诊断。
①异物感:常见于干眼症、睑缘炎、结膜炎、眼表异物、角膜疾病、隐形眼镜相关疾病、角结膜挫伤,等等。
②眼红:常见于角膜疾病、结膜炎、睑缘炎、葡萄膜炎、巩膜炎、青光眼,等等。
(2)双眼药物毒性角膜炎的鉴别诊断。
①病毒性角膜炎:患者往往有反复发作病史,常有感冒、熬夜、疲劳等前驱病史,角膜上皮较少出现糜烂的体征。
②干眼症:以眼部干涩、不适症状为主,可伴有结膜充血,以泪膜破裂时间和泪液分泌测试为主要检测方法确诊。
③睑缘炎:睑缘充血、肿胀,挤压睑板腺未见/可见牙膏状分泌物溢出,睫毛根部见油性分泌物附着,若继发睑缘炎相关角结膜病变,则出现结膜充血,角膜浸润,有助于确诊。
3.处理方案及基本原则
本病治疗的基本原则是消除病因、拮抗炎症、促进修复:
(1)立即停用所有原来眼部用药
(2)玻璃酸钠眼液(无防腐剂)ou q2h;0.1%氟美瞳眼液ou tid;小牛血清蛋白凝胶ou tid。
问题 1181
现病史:
患者, 男性,68岁, 因“左眼视力下降2月余”。2月前无明显诱因下出现左眼视力下降,伴眼红、异物感等不适, 无脓性分泌物。曾于当地医院就诊,诊为“虹膜炎、继发性青光眼”, 予以局部皮质类固醇激素、降眼压药物治疗,病情曾好转, 但不久病情反复并进一步加重,遂来我院就诊。
既往史:
眼部:曾有类似病史2次, 后缓解,具体治疗不祥。
全身疾病: 否认高血压、糖尿病等。
外伤手术史:否认
过敏史: 否认
查体:
眼科专科检查如表6-1所示。



辅助检查:
右眼眼部B超检查:玻璃体后脱离。
角膜共聚焦显微镜检查: 未见明显真菌菌丝和阿米巴包囊。
【问题1】
该患者的诊断及诊断依据
【问题2】
还需要与哪些疾病相鉴别?
【问题3】
该患者的处理方案及基本原则
答案:
1.诊断和诊断依据
(1)左眼视力下降、眼红2月。
(2)曾局部使用皮质类固醇激素好转,提示局部角膜病变可能与免疫相关。
(3)角膜灰白色混浊水肿增厚、后弹力层皱褶,上皮局部有水泡并伴轻微前房葡萄膜反应。提示角膜内皮炎症可能。
(4)既往曾有类似病史2次。单纯疱疹病毒性角膜炎有反复发作的特征。
基于以上几点分析:初步诊断为:单纯疱疹病毒性角膜炎内皮型。
2.鉴别诊断
(1)症状的鉴别诊断。
①视力下降:角膜病往往会造成不同程度的视力下降,包括免疫性角膜炎、感染性角膜炎、角膜上皮病变、角膜营养不良、角膜外伤,等等。
②眼红:常见于结膜炎、角膜炎、葡萄膜炎、巩膜炎,等等。
(2)单纯疱疹病毒性角膜炎内皮型的鉴别诊断。
①大泡性角膜病变:绝对期青光眼、晚期虹膜睫状体炎、外伤或眼内手术等导致的角膜内皮功能失代偿。病程较长,早期有晨起视力模糊,随起床后时间延长视觉逐渐清晰的情况,病程发展严重时出现持续性的视力下降,畏光,眼痛和异物感。眼科检查显示轻度结膜充血,角膜上皮水泡,基质水肿增厚。角膜内皮镜检查,内皮细胞密度显著减少。
②虹膜炎:单疱病毒性角膜炎内皮型常伴有前房的炎症反应,被误诊为虹膜炎。但虹膜炎不伴有角膜的病变,是鉴别的要点。
③继发性青光眼:单疱病毒性角膜炎内皮型可引起小梁网的炎症,部分患者会出现眼压升高,可予以降眼压治疗,一般经抗炎抗病毒治疗眼压可恢复正常。
3.处理方案及基本原则
本病治疗主要以药物治疗为主,包括抗病毒治疗和皮质类固醇激素治疗,病变反复发作内皮功能失代偿或引起角膜白斑可行角膜移植术提高视力。
(1)抗病毒药物治疗:可使用局部抗病毒药物,如阿昔洛韦滴眼液、更昔洛韦滴眼液或凝胶。对于病情严重和反复发作的患者可口服抗病毒药物,如阿昔洛韦、伐昔洛韦或更昔洛韦。目前阿昔洛韦片应用较多,治疗剂量为400mg口服每天5次,维持剂量为400mg每天2次。长期口服维持量阿昔洛韦可减少复发。
(2)糖皮质类固醇激素治疗:大部分患者局部用糖皮质激素滴眼液即可,如妥布霉素地塞米松滴眼液、醋酸泼尼松龙滴眼液。
(3)降眼压药物治疗:少数患者会伴有眼压升高,可予以局部降眼压药物治疗。
(4)角膜移植手术:内皮功能失代偿,角膜基质无明显混浊的患者可行角膜内皮移植术,明显的角膜基质混浊或形成白斑者可行穿透性角膜移植手术改善视力。
问题 1182
现病史:
患者, 男性,58岁, 因“左眼红痛、视力下降4月”。5月前患者左侧头面部带状疱疹,经全身口服抗病毒药物后皮肤损害消退。其后出现眼红、眼痛、视力下降。曾于当地医院就诊, 诊为角膜炎,予可更昔洛韦滴眼液、可乐必妥滴眼液频点, 但病情未见好转,视力进一步下降, 为求进一步诊治来我院门诊。
既往史:
全身疾病: 否认高血压、糖尿病等。
外伤手术史:无。
过敏史: 否认
用药史:眼部用药见现病史, 曾口服伐昔洛韦。
查体:
眼科专科检查如表7-1所示。



辅助检查:
(1)角膜刮片:未找到细菌、真菌菌丝及棘阿米巴包囊。
(2)角膜共聚焦显微镜检查: 未见真菌菌丝及棘阿米巴包囊.
(3)细菌培养、真菌培养(—)。
(4)患侧角膜知觉较检测显著降低。
【问题1】
该患者的诊断及诊断依据
【问题2】
还需要与哪些疾病相鉴别?
【问题3】
该患者的处理方案及基本原则
答案:
1.诊断和诊断依据
(1)左侧头面部带状疱疹5月。
(2)左眼红痛视力下降4月。
(3)患侧角膜知觉减退。角膜病变上皮缺损区边缘上皮过度增生并高起。
(4)经局部抗生素、抗病毒药物治疗无效。
(5)角膜刮片、角膜共聚焦显微镜检查未发现病原微生物。
基于以上几点分析:神经麻痹性角膜炎诊断成立。
2.鉴别诊断
(1)症状的鉴别诊断。
①眼痛:各种原因导致的角膜片状剥脱,例如外伤、大泡性角膜病变;角膜异物;各种感染性角膜炎均会造成眼痛。该患者虽主诉眼痛,但是眼部刺激症状不明显,与眼痛主诉不符。实际其眼痛是头面部皮肤带状疱疹病愈后遗的神经痛。
②眼红:常见于结膜炎、角膜炎、葡萄膜炎、巩膜炎,等等。
(2)神经麻痹性角膜炎的鉴别诊断。
①单疱病毒性角膜炎:单疱病毒性角膜炎也是引起神经麻痹性角膜炎的主要原因之一。当经常规治疗单纯疱疹病毒性角膜炎炎症消退,但角膜上皮或溃疡仍不愈合时应考虑神经麻痹性角膜炎可能。
②细菌性角膜炎:细菌性角膜炎一般起病急,发展快,角膜刮片细菌图片和培养可明确诊断,对抗生素治疗反应好。
③真菌性角膜炎:真菌性角膜炎多有外伤史,例如植物外伤史,病程发展相对于细菌性角膜炎要缓慢,角膜病灶刮片、共聚焦显微镜检查可以发现菌丝结构。
3.处理方案及基本原则
本病治疗包括病因治疗、局部药物治疗和手术治疗。首先找到造成神经麻痹的病因进行相应治疗,但往往各种原因造成的三叉神经麻痹不可恢复。治疗中最主要的是停止使用角膜上皮毒性的药物,并根据疾病的不同阶段来选择局部治疗方法。若仅角膜上皮缺损但不伴有明显的角膜基质病变可以使用无防腐剂的人工泪液联合预防性局部抗生素,对同时存在的炎症可以谨慎使用糖皮质激素滴眼液或局部环孢素滴眼液。当上述治疗无效,病变进一步发展时可行羊膜覆盖、睑裂缝合等手术治疗。
问题 1184
现病史:
患者, 男,22岁, 因“右眼出现白点,伴视力下降1周”。1周前无明显诱因下发现右眼出现白点, 伴视力下降、畏光,无虹视, 无眼胀等,在当地医院就诊为“右眼角膜炎”, 经左氧氟沙星眼液、阿昔洛韦眼液,牛重组促上皮生长因子凝胶治疗, 未见好转,遂来我院就诊。
既往史:
眼部:近视, 双眼视力欠佳。
全身疾病:否认高血压、糖尿病等。
外伤手术史: 否认
过敏史:否认
查体:
眼科专科检查如表9-1所示。



辅助检查:
验光: OD: 视力无法矫正提高, OS: -5.00DS/-2.00DC×175=0.7
角膜地形图: 图9-3.

【问题1】
该患者的诊断及诊断依据
【问题2】
还需要与哪些疾病相鉴别?
【问题3】
该患者的处理方案及基本原则
答案:
1.诊断和诊断依据
(1)右眼出现白点,伴视力下降1周;
(2)于外院曾诊断“右眼角膜炎”,左氧氟沙星眼液、阿昔洛韦眼液,牛重组促上皮生长因子凝胶治疗后,症状未见好转;
(3)右眼角膜中央圆形隆起,可见空泡,基质水肿、浑浊,而左眼角膜中央稍前凸;
(4)辅助检查:
角膜地形图: 高度散光,角膜屈光力>48D
基于以上病史、眼部表现及辅助检查结果分析:双眼圆锥角膜(右眼急性圆锥)诊断明确。
2.鉴别诊断
(1)症状的鉴别诊断。
①白点:常见于眼表异物、眼表新生物、眼表瘢痕、角膜疾病、角结膜挫伤,等等。
②视力下降:常见于角膜疾病、眼表新生物、眼表异物,眼表瘢痕、角结膜挫伤,等等。
(2)双眼圆锥角膜(右眼急性圆锥)的鉴别诊断。
①病毒性角膜炎:患者往往有反复发作病史,常有感冒、熬夜、疲劳等前驱症状,角膜基质和或上皮浸润、水肿,严重者可出现坏死。
②角膜新生物:角膜出现新生物,质实,密度高于角膜组织,界限较明确,表面高于角膜上皮面,部分有滋养血管长入,可以前段OCT了解其与角膜组织的关系,以辅助诊断。
③角膜瘢痕:既往有角膜炎症、外伤或手术史,角膜病变区域基质混浊,无水肿,病史有助于确诊。
④云片状角膜营养不良:角膜盘状浅基质混浊,不影响后弹力层和内皮层,界限清晰,视力一般比较稳定,进展缓慢,前段OCT和共聚焦有助于明确诊断。
⑤角膜带状变性:既往眼部有慢性疾病或手术史,起病于睑裂区角膜边缘部,上皮下或前弹力层出现细点状白色钙质沉着,病变外侧与角膜缘之间有透明区域间隔,病变进展缓慢。
3.处理方案及基本原则
圆锥角膜治疗的基本原则是早期框架眼镜矫正、中期控制进展、晚期角膜移植:
1、早期:对于规则散光或低度不规则散光进行框架眼镜矫正,角膜表层镜片术;
2、中期:无角膜瘢痕者,可选择RGP佩戴,角膜厚度>400 um,可进行核黄素紫外线角膜交联术治疗,深板层角膜移植术;
3、晚期:穿透性角膜移植术。此患者右眼可行穿透性角膜移植术,左眼可选择RGP佩戴。
问题 1185
现病史:
患者, 女,26岁, 主诉“双眼红,伴不适1月余”。1月前无明显诱因下出现双眼红, 伴不适,稍有畏光, 无分泌物增多,无虹视, 无眼胀等,曾于外院就诊, 诊为“双眼结膜炎”,予可乐比妥、阿昔洛韦眼水点眼tid, 未见明显好转,今为求进一步诊治来我院门诊。
既往史:
眼部:目前用药治疗, 1年前曾发作过。
皮肤:颜面部经常疖肿
外伤手术史: 否认
过敏史:否认
查体:
眼科专科检查如表10-1所示。




辅助检查:
共聚焦显微镜观察睑板腺腺泡的改变, 如图10-3、图10-4所示。


(1)泪膜破裂时间:右眼 2s, 左眼1s。
(2)泪液分泌实验:双眼 2mm/5min。
【问题1】
该患者的诊断及诊断依据
【问题2】
还需要与哪些疾病相鉴别?
【问题3】
该患者的处理方案及基本原则
答案:
1.诊断和诊断依据
(1)双眼红,伴不适1月余
(2)1年前曾经发作过,且颜面部经常疖肿
(3) 睑缘充血、肿胀,睫毛根部见油性分泌物,挤压睑板腺未见分泌物,结膜充血,角膜周边部见浅基质浸润,可考虑双眼睑板腺功能障碍,双眼睑缘炎相关角结膜病变
(4)辅助检查共聚焦显微镜观察睑板腺腺泡发现左眼睑板腺泡密度下降和萎缩,右眼睑板腺泡密度下降及阻塞性腺泡增大
基于以上几点分析:双眼睑板腺功能障碍,双眼睑缘炎相关角结膜病变。
2.鉴别诊断
(1)症状的鉴别诊断。
①眼红:常见于青光眼发作、干眼症、睑缘炎、结膜炎、表层巩膜炎、发炎的胬肉、眼表异物、角膜疾病、隐形眼镜相关疾病、眼前段缺血综合征,等等。
②畏光:常见于角膜疾病、结膜炎、后葡萄膜炎、巩膜炎、白化病、先天性青光眼,等等。
(2)双眼睑板腺功能障碍的鉴别诊断。
①结膜炎:结膜充血,水肿,伴或不伴有分泌物增多。
②干眼症:以眼部干涩、不适症状为主,可伴有结膜充血,以泪膜破裂时间和泪液分泌测试为主要检测方法确诊。
③巩膜炎:结膜充血,局部巩膜肿胀、压痛,B超发现巩膜厚度增加,巩膜间隙增宽,水肿,有助于确诊。
3.处理方案及基本原则
本病治疗的基本原则是拮抗炎症、消除病因。
(1)传统治疗:清洁、热敷、按摩
①清洁:无泪婴儿洗发液或生理盐水清洗睫毛根部,bid;睑缘区涂抗生素眼膏(典必殊、托百士、红霉素、夫西地酸等),bid。如图10-5、图10-6所示。


②热敷:正常人睑板分泌脂质需要温度28~32°C,睑板腺功能障碍患者溶点35°C,所以热敷温度要达45°C。
③按摩:顺着睑板腺走行并向开口方向按摩,即顺着垂直于睑缘的方向并向着睑缘按摩。
④伴有双眼睑缘炎相关角结膜病变治疗:1.清洁、热敷、按摩;2.局部0.1%氟米龙或氯替泼洛bid~tid,渐减量或0.05%环孢素;3.人工泪液;4.口服:多西环素50~100mg,bid,1~2w;或红霉素125mg,bid,1~2w;或阿奇霉素100mg,qd,1周。补充维生素B、C、ω-3脂肪酸;调整饮食习惯,避免辛辣、油腻及甜食,戒烟酒。
(2)LipiFlow ® Thermal Pulsation System
利用仪器同时对上下眼睑进行机械性加压并恒温加热,使睑板腺内的分泌物溶解排出,管道通畅,其仪器及使用如图10-7所示,设计原理如图10-8所示。


(3)Blephasteam® device新型眼睑加热装置
对上睑进行加热,使睑板腺分泌物溶解排出。其装置如图10-9所示。

(4)睑板腺管内探针使用特制的睑板腺探针(直径仅76微米)进行阻塞腺管的探通。并可联合腺管内注药,探针如图10-10所示,探道治疗如图10-11所示。


问题 1187
现病史:
患者, 女性,56岁, 因“双眼视物模糊2年,左眼加剧1年”。患者2年前无明显诱因下出现双眼视物模糊, 视远、视近均不清楚,无眼红、畏光、流泪、虹视、眼痛等不适, 今为求进一步诊治来我院门诊。
既往史:
家族史: 无殊;
用药史: 无殊;
外伤手术史: 否认
过敏史:否认
查体:
眼科专科检查如表12-1所示。



辅助检查:
B超: 双眼玻璃体轻度后脱离,未见视网膜脱离改变。
【问题1】
该患者的诊断及诊断依据
【问题2】
还需要与哪些疾病相鉴别?
【问题3】
该患者的处理方案及基本原则
答案:
1.诊断和诊断依据
1)诊断:双眼年龄相关性白内障(右未成熟期,左成熟期)
2)诊断依据
(1)女性,56岁,双眼视物模糊2年,右眼加剧1年;
(2)双眼不同程度晶状体混浊,视力下降与晶状体混浊程度成正比;
(3)没有明确的外伤、手术史,不伴有糖尿病、高血压等全身性疾病;
(4)B超未见玻璃体视网膜疾病。
2.鉴别诊断
(1)糖尿病性白内障:有无糖尿病史可供主要鉴别。糖尿病性白内障一般分为二类:真性糖尿病性白内障和糖尿病患者的年龄相关性白内障。前者多见于Ⅰ型青少年糖尿病患者,双眼发病,晶状体短期内可发展为白色混浊。后者是糖尿病因素使年龄相关性白内障提前出现或进展加速,早期密集的前囊膜下小空泡形成,进而发展为灰白色斑片状混浊,位于前、后囊膜下皮质浅层,最后可发展成全混浊。发病进程中随血糖高低变化而出现屈光近视和远视改变。
(2)并发性白内障:由于眼部疾病引起的晶状体混浊。眼部炎症或退行性变导致晶状体营养或代谢发生障碍,出现晶状体混浊。常见于葡萄膜炎、视网膜色素变性(RP)、视网膜脱离、青光眼、眼内肿瘤、高度近视、低眼压等。由眼后节病变引起的白内障多最早出现晶状体后极部的后囊下混浊,后渐向晶状体核心部及周边部扩展,继之向前皮质蔓延,逐渐使晶状体全混浊;由眼前节炎症形成的虹膜后粘连附近可出现局限性的晶状体前囊下混浊;由青光眼引起者多由前皮质和核开始;由高度近视所致者多为核性白内障。
3.处理方案及基本原则
1.手术
摘除是目前白内障唯一有效的治疗方法。具体手术方案选择要根据实际情况如核的硬度、角膜内皮情况、其他眼部手术史、手术者的经验、患者的经济状况等综合评估后决定,表12-2所列可供参考。

2.手术适应证
①当白内障影响患者的学习、工作和生活,而根据术前评估手术后可以改善视功能并提高生活质量者。一般情况下,矫正视力下降至0.1~0.5左右时手术比较合适;而驾驶员、精细工作者等对视力要求较高的人,视力下降至0.6~0.8以下时也可手术,具体根据术者的经验加以把握。
②晶状体混浊妨碍眼后节疾病的最佳治疗如视网膜脱离、糖尿病视网膜病变、眼内炎等。
③晶状体炎症或膨胀导致其他威胁眼部视力的并发症出现如晶状体溶解、过敏或膨胀导致继发青光眼时。
④虽然患眼视力已丧失,但白内障使瞳孔区变白,影响外观者。
3.手术禁忌证
(1)患者不愿手术,不能获得患者及其代理人的知情同意;
(2)患者的生活质量未受到明显影响,或通过眼镜及其他辅助装置能获得患者的满意生活视力时;
(3)全身重大疾病或眼部其他疾病,估计不能安全完成手术者。
问题 1188
现病史:
患儿, 女,3岁, 因“家长发现双眼瞳孔区发白1月余”。1月余前无明显诱因下家长发现患儿双眼瞳孔区发白,但能追光, 无眼红,无畏光流泪, 无明显结膜分泌物增多。曾于当地医院就诊,具体治疗不详。为进一步诊治于我院就诊, 拟诊“双眼先白性白内障、弱视”,为进一步手术治疗收治入院。
既往史:
外伤手术史:否认
过敏史: 否认
用药史:否认最近使用大量抗菌药物
系统回顾: 无特殊
个人史:足月剖宫产。否认早产、吸氧史。
家族史: 否认家族遗传病史,否认家族内先天性白内障病史。
查体:
眼科专科检查如表13-1所示。



辅助检查:
胸部X线: 心肺未见明显活动性病变。
心电图:正常。
B超: 双眼内未见明显异常回声。
【问题1】
该患者的诊断及诊断依据
【问题2】
还需要与哪些疾病相鉴别?
【问题3】
该患者的处理方案及基本原则
答案:
1.诊断和诊断依据
(1)家长发现患儿双眼瞳孔区发白
(2)否认外伤史
(3)检查发现双眼晶状体绕核性混浊,右眼明显。
(4)B超提示双眼内未见明显异常回声
基于以上几点分析:初步诊断为双眼先天性白内障,双眼弱视。
2.鉴别诊断
(1)白瞳征的鉴别诊断。
①永存胚胎血管:见于足月顺产的婴幼儿,90%为单眼发病。患侧眼球小,前房浅,晶状体小而扁平,瞳孔不易散大。晶状体后面可见坚硬的纤维膜,中心部位最厚,其上血管丰富。散大瞳孔常可发现睫状突因牵拉而聚向晶状体后极部,形成放射状条纹。
②早产儿视网膜病变:又称未成熟儿视网膜病变。见于早产儿,吸入高浓度氧和低出生体重可能是其危险因素。根据国际分类法,按病情轻重将本病分为5期,最终以广泛结缔组织增生和机化膜形成为其主要表现。在晶状体后面形成纤维血管组织,并向心性牵拉睫状体,可同时发生白内障和视网膜脱离。如晶状体透明,检查眼底可以发现视网膜血管扩张迂曲,周边部视网膜新生血管形成,伴视网膜水肿。
③视网膜母细胞瘤:是儿童期最常见的原发性眼内恶性肿瘤,多发生于2-3岁以前,但也有出生后数月乃至数日发病者。双眼发病占60%,单眼发病为40%。早期由于肿瘤在眼内有限范围内生长,不易被发现,特别是单眼患儿。仅当肿瘤长到一定大小,合并继发性视网膜脱离时,在玻璃体内可见到黄白色肿瘤团块。由于肿瘤本身呈现乳白色或黄白色,此时瞳孔区即可出现黄白色反光,即白瞳症,俗称“猫眼”。此外,常见的临床表现还包括斜视、眼红、前房积脓、青光眼、葡萄膜炎等。所以B超需首先排除眼内占位。
④外层渗出性视网膜病变:又称Coats病。本病大多数见于男性儿童,女性比较少见。90%单眼罹患,偶为双眼。发病隐匿,进展缓慢,早期很难被发现,直到视力明显减退、斜视或出现“白瞳”时,才会引起家长注意到医院检查。典型改变为视网膜血管异常及视网膜渗出病变,病变可位于眼底任何象限,多位于赤道部和周边部,以颞侧最为常见。眼底可见单个或多发性病灶,病变部位视网膜呈黄白色隆起,间或类脂样渗出。视网膜动脉和静脉均受累,尤以动脉为著。血管扩张、迂曲,管径粗细不均,囊样、梭形扩张可排列呈串珠样,伴有新生血管和血管瘤形成。FFA检查显示典型“灯泡”样高荧光,为毛细血管扩张所致。同时也可以观察到毛细血管阻塞和无灌注,晚期可见弥漫性荧光素渗漏。
⑤弓蛔虫病:通常有接触猫狗宠物病史,弓蛔虫感染。临床分两型:肉芽肿型,表现为后极部、周边部视网膜可见灰白色隆起;弥漫性眼内炎型。也可见眼组织局限性炎症。玻璃体牵拉带伴黄斑牵拉、视网膜脱离和并发性白内障。多发于2-10岁儿童,以单眼发病为主很少双眼发病,血、前房水中可查到嗜伊红细胞,酶联免疫吸附试验弓蛔虫抗体阳性可确诊。
⑥其他:如视网膜星形细胞瘤、视网膜脉络膜缺损、视网膜脱离、家族性渗出性玻璃体视网膜病变、有髓神经纤维、葡萄膜炎、色素失调症。
(2)先天性白内障病因的鉴别诊断。
①特发性:原因不明,即散发病例。
②家族性:多为常染色体显性遗传。
③风疹病毒感染(母体风疹综合征):晶状体核性或完全性混浊,并常伴有小眼球,角膜混浊,瞳孔不易扩大,视网膜色素沉着。可有先天性心脏病、耳聋等。
④半乳糖血症:乳激酶或半乳糖-1-磷酸尿苷转移酶缺乏,可出现晶状体典型的油滴状混浊。可有精神发育迟滞和肝脾肿大。
⑤眼脑肾综合征(Lowe综合征):有先天性白内障,角膜混浊,青光眼,肾小管功能异常,精神迟滞,为X连锁隐性遗传。
⑥其他:包括宫内感染、外伤、药物以及代谢障碍等。
3.处理方案及基本原则
手术是治疗先天性白内障的主要方法。
(1)先天性白内障的手术指征为:直径大于3mm、位于视轴中心显著影响视力的白内障;致密的核性白内障;影响检查者观察眼底及伴发斜视的白内障。其他类型如前极性、缝性和点状白内障可能对视力无影响,可随访观察其进展。
(2)手术时机:手术应在出生后及早进行,最迟不超过6个月。双眼白内障者另一眼应在较短的间隔时间内完成手术,一般间隔一周比较合适。
(3)手术方式:可选择前部入路或后部入路的白内障吸除/切除术,对于6岁以下的儿童,由于其无法配合激光后囊膜切开,手术时必须联合后囊膜切开及前段玻璃体切除,以(避免)减少后囊膜混浊的发生。
(4)人工晶状体植入:婴幼儿由于眼球的生长发育较为迅速,且手术并发症相对较多,对于人工晶状体的植入年龄尚有争议。目前多数学者认为2岁以上植入人工晶状体是安全的。而在人工晶状体度数的选择上,一般也是保留相应程度的远视以补偿将来的近视漂移,剩余的屈光不正使用眼镜矫正。
(5)术后应及时积极治疗弱视,这和手术本身一样重要。可以佩戴框架眼镜、RGP、遮盖等方法来进行并坚持视功能的重建治疗。
(6)预后:单眼、年龄越大的先白或伴有眼球震颤、斜视者视功能重建效果差。
问题 1189
现病史:
患者, 女性,59岁, 主诉“双眼视力进行性下降2年余,加重3月”。无眼红、眼痛, 无视物变形,今为求进一步诊治来我院门诊。
既往史:
内分泌系统:患者诊断有2型糖尿病8年, 目前服用降糖药物控制血糖。
用药史:目前服用二甲双胍, 阿卡波糖控制血糖。
外伤手术史:1年前曾行双眼视网膜激光光凝术。
过敏史: 否认
查体:
眼科专科检查如表14-1所示。



辅助检查:
空腹血糖:7.8mmol/L, HBA1C:6.3%。
OCT: 右眼黄斑部视网膜轻度增厚,黄斑前膜形成。左眼中心凹形态基本正常。
FFA: 右眼造影早起见微血管瘤,视网膜下方和鼻侧见片状毛细血管无灌注区, 晚期黄斑区见荧光渗漏。左眼因屈光间质混浊,造影图像不清。
【问题1】
该患者的诊断及诊断依据
【问题2】
还需要与哪些疾病相鉴别?
【问题3】
该患者的处理方案及基本原则
答案:
1.诊断和诊断依据
(1)双眼视力下降2年余,无视力变形,无眼红、眼痛;视力矫正无助
(2)2型糖尿病8年,曾行双眼视网膜激光光凝术
(3)双眼晶状体皮质混浊,前囊下混浊明显,玻璃体絮状混浊,视网膜平,见激光瘢痕,余无明显阳性体征
(4)辅助检查显示空腹血糖:7.8mmol/L,HBA1C:6.3%
基于以上几点分析:初步诊断为双眼糖尿病性白内障,双眼糖尿病性视网膜病变(右眼糖尿病性视网膜病变中度非增殖期)。
2.鉴别诊断
(1)白内障类型的鉴别诊断。
①年龄相关性白内障:是白内障中最常见的一种类型,多发生在40~50岁以上的老人。晶状体本身逐渐混浊,而全身和局部未查出明显病因。常为双侧发病,可先后或同时发生,从发病到成熟可历时数月至数年,多数情况下双眼晶状体混浊程度对称。
②并发性白内障:由其他眼部疾病引起的白内障,眼前节、眼后节的许多疾病引起眼内环境的改变,是晶状体营养或代谢发生障碍,产生混浊,如青光眼、葡萄膜炎、视网膜脱离、眼内肿瘤、高度近视等;常有原发病的相应表现,其晶状体混浊与原发病成正比。该患者病史及眼部表现不符,暂不考虑此诊断。
3.处理方案及基本原则
糖尿病性白内障处理须结合患者血糖控制情况及有无糖尿病性视网膜病变及黄斑水肿、程度如何、治疗等情况综合加以决定。
1.无DR,或NPDR不需光凝治疗:Phaco+IOL
2.NPDR或PDR需光凝治疗
(1)视网膜会诊需光凝治疗,先光凝。
(2)如眼底因白内障看不清,先行Phaco+IOL,1~2周尽快光凝,以防术后糖尿病视网膜病变进展加快。
对于该患者,建议先行左眼Phaco+IOL术,术后进一步行糖尿病性视网膜病变检查及治疗;右眼先行视网膜激光光凝术,稳定至少3个月后再行Phaco+IOL术。
问题 1190
现病史:
患者, 男性,56岁, 主诉“双眼视物模糊2年”。2年前无明显诱因下出现双眼视物模糊伴近视度数加深,无眼红、畏光等不适, 无虹视、无眼痛等不适,今为求进一步诊治来我院门诊。
既往史:
家族史:父母近视, 具体不详
用药史:无殊
外伤手术史: 否认
过敏史:否认
查体:
眼科专科检查如表15-1所示。




辅助检查:
(1)B超: 双眼玻璃体后脱离,双眼后巩膜葡萄肿。
(2)A超: 右眼眼轴33.25mm左眼眼轴32.16mm
【问题1】
该患者的诊断及诊断依据
【问题2】
还需要与哪些疾病相鉴别?
【问题3】
该患者的处理方案及基本原则
答案:
1.诊断和诊断依据
1.第一次手术前诊断依据
(1)主要根据晶状体的混浊程度、多以核性白内障为主
(2)眼轴长度大于26mm
(3)没有明确的外伤、手术史,不伴有糖尿病等全身代谢性疾病
(4)注意是否有悬韧带的松弛或离断,尤其在黑核状态下易发
(5)若能窥清眼底的情况下,除了B超、OCT常规眼底检查外,建议双眼散瞳彻查周边眼底,以便充分了解病情及预后
2.第二次手术前诊断依据
(1)高度近视并发性白内障患者术后再次出现明显视力下降
(2)排除眼底的病变及后发障后要考虑到囊袋收缩综合征的可能
(3)为明确诊断可以散瞳检查,建议双眼散瞳,如一眼已经发生明显囊袋收缩,另一眼发生囊袋收缩的可能性也很大
2.鉴别诊断
(1)症状的鉴别诊断。
①眼轴跟屈光状态的的匹配性:如果眼轴不长(通常<26mm),患者近视很深且跟眼轴轴长明显不匹配,除了老年性白内障的核性近视,也要警惕球形晶状体可能,此时可询问患者年轻时是否有近视,及借助UBM或者Lenstar等测量晶状体的厚度等予以参考鉴别。
②悬韧带的状态:高度近视并发性白内障容易伴有悬韧带自发的松弛或离断,因此术前仔细评估悬韧带的状态,也为手术方案的制定和手术的顺利进行提供保障,可以借助眼部查体下的虹膜震颤现象、辅助检查的UBM等。
③囊袋收缩综合征:高度近视、视网膜色素变性、葡萄膜炎等是囊袋收缩的高危因素,高度近视并发性白内障术后要警惕其发生的可能性。
3.处理方案及基本原则
高度近视并发性白内障的手术方案选择参考,具体还是要根据实际情况比如角膜内皮情况等综合评估,如表15-2所示。

此外在综合考虑核分级、脱位程度、术者手术操作熟练程度等的情况下,还可以借助囊袋张力环(标准或改良CTR)、囊膜或囊袋拉钩等工具,减少手术创伤,进一步提高手术效果,具体参考晶状体脱位章节。
高度近视并发性白内障术后囊袋收缩综合征的处理:此类白内障术后往往会发生一定程度的囊袋收缩,需评估收缩环的大小决定处理原则,如收缩环直径已经小于自然瞳孔大小,影响视力,则需要积极处理:如只是囊袋收缩,悬韧带虽受拉伸但无明显离断,IOL无明显移位,可考虑YAG激光前囊收缩环松解;如IOL移位严重甚至脱位,可能需要原有IOL取出改为悬吊式植入。
问题 1191
现病史
患者,男性, 15岁,因“一周前右眼不慎被眼镜玻璃碎片划伤”就诊, 急诊至我院,检查见右眼角膜裂伤, 晶状体混浊,诊断为“右眼角膜穿孔伤, 右眼外伤性白内障”,急诊行“右眼角膜裂伤修补术”, 术后予抗炎、抗感染治疗,恢复可。患者于我院门诊随访, 诉右眼视物模糊加重,诊断为“右眼外伤性白内障, 角膜裂伤缝合术后”,拟行进一步治疗收住入院。
既往史:
呼吸、循环、消化、血液、内分泌、皮肤五官、精神神经、运动骨骼系统:无异常。家族史: 无异常。
个人史:出生于原籍, 无烟酒等不良嗜好。
外伤手术史:同现病史。
过敏史: 否认。
查体:
眼科专科检查如表16-1所示。



辅助检查:
【问题1】
该患者的诊断及诊断依据
【问题2】
该患者的处理方案及基本原则
答案:
1.诊断和诊断依据
(1)明确外伤史。
(2)外伤眼晶状体混浊,皮质外溢。
(3)B超提示未见玻璃体积血及视网膜脱离改变。
2.处理方案及基本原则
1.晶状体局限性混浊,视力影响不大者(例如视力超过0.5),可暂随访观察。
2.晶状体已变为弥漫性混浊,视力明显下降(小于0.3或0.4)则可行白内障摘除术及人工晶状体植入,白内障摘除可行囊外或超声乳化术。
3.晶状体皮质散入前房,应尽早行白内障摘除及人工晶状体植入术,如已引起继发性青光眼或葡萄膜炎者,应立即行晶状体摘除术,并尽可能除净皮质,同时按青光眼或葡萄膜炎治疗。
4.外伤性白内障如后囊膜完整,或后囊膜缺如小于二分之一后囊膜面积者,大多可植入人工晶状体。对后囊膜缺如过大者,可考虑巩膜缝线固定后房型人工晶状体,虹膜夹型人工晶状体或前房型人工晶状体植入术,如有虹膜损伤,应同时修补。
问题 1192
现病史
患者,男性, 30岁,主诉“右眼被木棒撞击后视物模糊伴胀痛3天”。3天前患者右眼被木棒击中, 即感右眼视物模糊伴眼痛,至当地医院就诊, 诊断为“右眼角膜穿孔伤”,因创口自闭, 未予缝合,给予局部应用糖皮质激素、抗生素眼药水点眼。1天后右眼胀痛明显加重, 且视物更加模糊,为求进一步诊治来我院门诊。
既往史:
用药史:眼部用药见现病史, 否认全身用药
外伤手术史:3天前右眼外伤见现病史
查体:
眼科专科检查如表17-1所示。



辅助检查:
眼眶X线: 未见明显眼眶异物。
眼B超:玻璃体腔内少量点状回声, 视网膜平伏,未见明显异常。
UBM: 右眼瞳孔直径:4.2mm, 右眼前房深度:1.34mm, 右眼前房浅,右眼下方角膜局限水肿浑浊, 虹膜周边前粘,睫状突轻度旋前, 各方位房角关闭,除上方外各方位晶状体悬韧带稀少, 晶状体赤道-睫状体距离增宽。
【问题1】
该患者的诊断及诊断依据
【问题2】
还需要与哪些疾病相鉴别?
【问题3】
该患者的处理方案及基本原则
答案:
1.诊断和诊断依据
(1)右眼木棒击伤史。
(2)受伤1天后右眼胀痛明显加重,伴视物模糊。
(3)体检见角膜穿孔伤、虹膜震颤、瞳孔对光反应迟钝、前房变浅,瞳孔放大后见下方及两侧悬韧带离断、晶状体半脱位。
(4)眼压34mmHg。
(5)UBM:右眼前房浅,除上方外各方位晶状体悬韧带稀少,晶状体赤道-睫状体距离增宽。
(6)辅助检查排除眼内异物及眶内异物、B超未见明显异常。
基于以上几点分析:初步诊断为右眼晶状体半脱位,右眼继发性青光眼,右眼角膜穿通伤。
2.鉴别诊断
患者存在眼穿孔伤史,伴眼胀痛、视物模糊,应考虑以下密切相关的鉴别诊断:
(1)眼内炎:患者存在角膜穿孔伤,且未予缝合,伤后1天出现眼痛加重,故应密切关注是否存在眼内炎。患者体检见下方角膜穿孔伤,创口对合良好,Seidel试验阴性,无前房积脓,B超示玻璃体腔内少量点状回声,X线片排除眼眶异物,故暂排除眼内炎可能。
(2)造成继发性青光眼的原因:除晶状体半脱位造成瞳孔阻滞或周边虹膜前粘连可导致继发性青光眼外,眼外伤还有诸多因素可能导致继发性青光眼,包括:晶状体前囊膜破裂、晶状体皮质溢出于前房、堵塞房角及造成炎症反应等;前房积血;血影细胞性青光眼;前房角后退继发青光眼;炎症性青光眼;外伤性睫状环阻滞等,需根据患者的体征予以鉴别。
(3)角膜内皮失代偿:患者存在晶状体半脱位,且脱位范围大,伴有前房变浅,应考虑是否存在角膜内皮失代偿可能。因患者受伤后时间短、且前房存在、晶状体未脱入前房,故体检仅发现下方角膜裂伤周围局限性水肿,余角膜尚透明,故暂排除角膜内皮失代偿可能。
(4)其他并发的眼部损伤:眼外伤患者应仔细体检并行相应辅助检查,排除玻璃体积血、视网膜裂孔、视网膜脱离、脉络膜脱离等可能同时存在的损伤性病变。
3.处理方案及基本原则
除抗炎、抗感染、降眼压对症处理外,对于晶状体半脱位的处理应遵循以下原则:
1.晶状体半脱位或全脱位并非都需要立即手术。晶状体半脱位若没有明显影响视力、也没有引起相关并发症,可以暂不手术,配戴眼镜矫正,定期随访。但是,对于晶状体半脱位患者,需要密切随访眼压;对于晶状体全脱位到玻璃体腔的患者,需要密切观察视网膜情况;对于晶状体全脱位到前房的患者,则需要关注是否引起角膜内皮损伤和水肿。依据患者的具体情况,有时会建议早做手术,避免严重并发症的发生。
2.若晶状体全脱位到前房,或者晶状体发生了混浊、溶解,或发生了青光眼及视网膜脱离等严重并发症,则应当及时手术。本例患者视力明显下降(0.04),且已发生继发性青光眼,故采取了手术治疗。
3.晶状体脱位的手术治疗是比较困难的,摘除脱位的晶状体比一般白内障摘除难度高、风险大。因此应慎重决定手术方案,方案的选择取决于晶状体的位置、晶状体的硬度、有无出现其他并发症等。可选择的摘除方式有超声乳化术吸除、囊外摘除、囊内摘除、经睫状体平坦部切除等。摘除晶状体后,由于晶状体半脱位或脱位的患者已经没有放置人工晶状体的稳定囊袋,因此不能像常规白内障手术一样直接将人工晶状体植入晶状体囊袋内。可选择的植入方式有标准囊袋张力环或改良张力环植入术(悬吊)联合囊袋内人工晶状体植入、虹膜夹人工晶状体植入、人工晶状体巩膜缝线固定或虹膜缝线固定术等。选择的原则是保证人工晶状体的稳定与居中。
问题 1193
现病史
患者,男性, 19岁,主诉“双眼反复胀痛伴视物模糊12年, 加重半年”。半年前无明显诱因下出现左眼胀痛,视力下降伴雾视、虹视, 无畏光、流泪、眼分泌物增多等不适,曾于当地医院就诊, 予甘露醇250ml静滴及局部降眼压药物(毛果芸香碱滴眼液、美开朗滴眼液、派立明眼液、阿法根眼液等)治疗,未见明显好转, 今为求进一步诊治来我院门诊。
既往史:
外伤手术史: 否认;
过敏史: 否认;
用药史: 眼部用药见现病史;
其他眼病史: 双眼高度近视18余年,框架眼镜矫正; 双眼闭角型青光眼病史10余年,局部降眼压眼液治疗, 疗效欠佳;
眼部治疗史: 双眼激光周边虹膜切除术史。
查体:
体格检查见该患者身材矮小、肌肉丰满, 具有短指畸形。
眼科专科检查如表18-1所示。





辅助检查:
胸部X线: 未见明显异常。
眼部B超:双眼玻璃体全段少量点状回声, 后脱离带状回声不明显,眼内未探及明显视网膜脱离回声带。
眼轴测量: 右眼:22.38mm; 左眼:23.19mm。
角膜内皮CD: 右眼:2886/mm

; 左眼2769/mm

。
晶状体厚度测量:右眼: 5.4mm;左眼5.5mm。
视野: 右眼:视敏度下降; 左眼:管状视野。
超声生物显微镜检查(UBM): 双眼前房深度:R: 0.65mm/L1.22mm。双眼晶状体呈球形(见图18-4),右眼鼻侧及鼻下方, 左眼鼻上、鼻侧及鼻下方见晶状体悬韧带稀疏,悬韧带拉长明显。右眼鼻下、下方见房角开放, 余各方位均见虹膜小梁网接触。左眼各方位均见虹膜小梁网接触(见图18-5)。


【问题1】
该患者的诊断及诊断依据
【问题2】
还需要与哪些疾病相鉴别?
【问题3】
该患者的处理方案及基本原则
答案:
1.诊断和诊断依据
(1)双眼反复眼部胀痛,加重半年,局部降眼压眼液无法控制眼压。
(2)缩瞳药可进一步促使眼压升高;睫状肌麻痹眼液可使眼压下降。
(3)有高度近视病史,但眼轴属于正常范围,属于晶状体源性近视。
(4)裂隙灯检查发现前房极浅,以中央前房浅明显。散瞳后可见晶状体呈球形,前突,悬韧带拉长,稀疏,伴晶状体脱位。
(5)A超测量晶状体厚度较厚,超声生物显微镜检查可见晶状体呈球形,不同方位虹膜小梁网接触,房角关闭,晶状体半脱位。
基于以上几点分析:初步诊断为球形晶状体、继发性闭角型青光眼。
2.鉴别诊断
①原发性闭角型青光眼:原发性闭角型青光眼患者有着特征性的眼部解剖结构:前房较浅,尤其是周边前房,角膜(相对)较小,房角入口狭窄,加之眼球轴长较短,形成晶状体位置相对偏前,使得相对狭小的眼前段更为拥挤,使用拟胆碱作用药物,如毛果芸香碱滴眼液可缩小瞳孔降低眼压。而球形晶状体导致的继发性青光眼,由于高度前凸的前表面以及晶状体悬韧带的松弛使晶状体进一步前移,前房浅,尤其是中央前房浅,晶状体前移导致反复发生瞳孔阻滞,从而形成虹膜粘连的房角关闭,形成继发性青光眼,使用拟胆碱作用药物可进一步加重眼压升高,而使用睫状肌麻痹剂反而使得眼压下降。
②轴性近视:主要是由于眼轴长度超过正常范围而导致的平行光线经眼球屈光系统后聚焦在视网膜之前,眼轴长度大于24.00mm。球形晶状体导致的高度近视属于屈光性近视,是由于晶状体呈球形,前后表面的曲率过大,是晶状体源性近视。
③外伤性晶状体脱位:由于钝伤引起的晶状体悬韧带断裂,从而导致晶状体脱位,一般患者有明确的外伤史,且常伴有外伤性白内障的形成。
3.处理方案及基本原则
本病治疗的基本原则是解除晶状体导致的瞳孔阻滞,降低眼压:
(1)非手术治疗:对尚未引起严重并发症的球形晶状体可作密切随访。
晶状体源性近视可通过凸透镜或角膜接触镜矫正以获得部分视力。早期继发性青光眼可给予睫状肌麻痹剂、局部降眼压药物及激光虹膜周切术等控制眼压。禁忌给予拟胆碱药物(如:毛果芸香碱滴眼液)治疗。
(2)手术治疗:根据晶状体半脱位的范围及眼压控制情况可行晶状体摘除手术及抗青光眼手术治疗。
①晶状体手术:部分患者仅行晶状体手术就可良好的控制眼压。晶状体脱位范围小于1/2-1/4象限,可行Phaco+IOL+CTR术。术中可使用虹膜拉钩或囊袋拉钩稳定晶状体囊袋,使其居中;晶状体脱位范围大于1/2象限,可行经睫状体平坦部/角巩膜缘晶状体切除+巩膜缝线固定IOL悬吊术。
②抗青光眼手术:当患者存在长时间的虹膜前粘连、房角关闭导致小梁功能的不可逆损伤或原先就已存在的小梁功能发育不良,单纯行晶状体手术不能良好控制眼压。可行小梁滤过手术或者引流钉植入术等进一步控制眼压,防止视神经的损伤。
问题 1195
现病史
患者,男, 66岁,农民, 维吾尔族,主诉“右眼视力下降3年”。3年前, 患者无明显诱因出现右眼视力下降,无眼痛、无畏光、流泪等不适。由于左眼视力佳, 未引起重视,未进行治疗。近日来, 患者右眼视力下降明显,影响日常生活, 今为求进一步诊治来我院门诊。
既往史:
系统回顾: 无特殊
家族史:无特殊。
用药史: 否认全身及局部用药
外伤手术史:否认
过敏史: 否认
查体:
眼科专科检查如表20-1所示。






辅助检查:
前房角镜检查:宽角, 前房角见灰白色头皮屑样物质沉积。
【问题1】
该患者的诊断及诊断依据
【问题2】
还需要与哪些疾病相鉴别?
【问题3】
该患者的处理方案及基本原则
答案:
1.诊断和诊断依据
(1)老年男性,从事农业劳动工作(长期接触外界紫外线),维吾尔族(患病率高)
(2)右眼无痛性视力下降
(3)右眼视力:0.1(矫正不提高);角膜透明,前房深浅正常,有少量色素性颗粒浮游,瞳孔直径3mm,瞳孔缘见大小不等灰白色头皮屑样物质沉积,晶状体轻度混浊,扩瞳见瞳孔中央区晶状体表面圆盘状半透明膜样物质沉积,周边部环状灰白色颗粒样混浊带,二者之间为透明区。玻璃体未见明显混浊。视盘边界清,色泽淡,C/D=0.9,视网膜血管无异常,黄斑中心凹反射不清。眼压:47mmHg。
(4)右眼前房角镜检查:宽角,小梁网色素沉着,房角见灰白色头皮屑样物沉积。
基于以上几点分析:初步诊断为右眼假性囊膜剥脱综合征;右眼并发性白内障;右眼继发性开角型青光眼。
2.鉴别诊断
(1)假性囊膜剥脱综合征的鉴别诊断。
①色素播散综合征:是一种自发性疾病,主要表现在30~40岁近视患者,在男性患者更易伴发青光眼,而女性少见,二者之比为2∶1~3∶1。从虹膜释放的色素颗粒较小,不弥散于虹膜表面,而是堆积在虹膜皱褶内。常有角膜后Krukenberg梭形色素沉着。透照法检查在虹膜中周部有裂隙状、放射状色素缺失。小梁网上的色素带常比XFS更为致密,在老年人鉴别较困难,色素带则较平滑,紧贴在小梁网的后带,而XFS的色素带呈明显的沙砾状。一些色素播散综合征的患者可发展为XFS,双侧青光眼也易出现。因色素播散综合征几乎是双侧对称性的,一个伴有双侧色素播散综合征和单眼眼压高的老年的患者,应怀疑有XFS的可能。
②真性晶状体囊膜剥脱症:本病见于眼外伤、重度葡萄膜炎及暴露于高温作业等。裂隙灯检查见晶状体前囊有透明的伴有卷曲边缘的薄片,与本病的剥脱物呈霜样不同,且常不伴有青光眼。异物如铜、铁眼外伤也可出现晶状体剥脱,但十分少见。
3.处理方案及基本原则
本病治疗的基本原则控制眼压,早期手术,防治并发症:
(1)控制眼压:合并有青光眼的假性囊膜剥脱综合征患者,时常由于眼压控制不佳而失去手术时机,眼压的控制对于手术而言较为重要,不仅如此,控制眼压对患者视盘、以及视力预后均有重要意义。
(2)早期手术:由于合并有并发性白内障及继发性开角型青光眼。本患者手术选择为青光眼白内障联合手术。在治疗白内障的基础上,通过滤过性手术,进一步控制眼压和改善视力。
问题 1196
现病史
患者,男性, 13岁,主诉“双眼视物模糊10年, 加重1年”。10年前无明显诱因下出现双眼视物模糊,无眼痛, 眼红、虹视,畏光、流泪等不适, 曾于当地医院就诊,诊断为晶状体半脱位, 建议上级医院择期手术治疗,今为求进一步诊治来我院门诊。
既往史:
外伤手术史:心脏二尖瓣脱垂手术和脊柱侧弯矫正手术史;
过敏史:否认;
用药史:眼部用药见现病史;
其他眼病史:无;
遗传史:无家族类似疾病史。
查体:
体格检查见该患者身材瘦长、四肢细长、肌肉发育不良,皮下脂肪减少, 如图21-1所示。
眼科专科检查如表21-1所示。





辅助检查:
胸部X线: 未见明显异常。
眼部B超:双眼玻璃体全段少量点状回声, 后脱离带状回声不明显,眼内未探及明显视网膜脱离回声带。
眼前节OCT: 晶状体脱位处悬韧带明显伸长((见图21-4)。

【问题1】
该患者的诊断及诊断依据
【问题2】
还需要与哪些疾病相鉴别?
【问题3】
该患者的处理方案及基本原则
答案:
1.诊断和诊断依据
(1)双眼视物模糊10年,加重1年。
(2)裂隙灯检查发现向鼻上方移位,可见晶状体赤道部及过度拉伸的悬韧带。
(3)眼前节OCT:晶状体脱位处悬韧带明显伸长。
(4)全身体格检查见身材瘦长、四肢细长、肌肉发育不良,皮下脂肪减少,有骨科脊柱侧弯及心脏二尖瓣脱垂手术史。
基于以上几点分析:初步诊断为晶状体半脱位、马凡综合征。
2.鉴别诊断
①其他先天性晶状体半脱位:先天性晶状体半脱位一般分为单纯性晶状体半脱位、伴有眼部其他发育异常晶状体半脱位和伴有全身系统发育异常的晶状体半脱位。单纯性晶状体半脱位有较明显的遗传倾向,多为常染色体显性遗传,双眼对称发病,其发生原因尚不明确,但不伴有眼部其他发育异常或伴有全身系统发育异常。伴有眼部其他发育异常晶状体半脱位:常见有小球形晶状体、晶状体缺损、虹膜缺损或无虹膜症、瞳孔异位。
②其他伴有全身系统发育异常的晶状体半脱位:常见有马切山尼综合征(Weil-Marchesani综合征)、同型胱氨酸尿症。马切山尼综合征为染色体隐性遗传病,患者身材矮胖,胸、颈、指趾短粗,肌肉丰富而富于脂肪。心血管系统正常。眼部典型表现为小球形晶状体,晶状体脱位以鼻下方为主,常合并高度近视。同型胱氨酸尿症也为染色体隐性遗传病,患儿血中胱氨酸增多,随尿排出,称为高胱氨酸尿症。除马凡综合征表现外,常伴有骨质疏松和全身血栓形成趋势、智力缺陷、癫痫等。眼部表现为双侧对称性晶状体脱位,以鼻下方多见,可合并先天性白内障、视网膜脱离和无虹膜症等病变。
③外伤性晶状体半脱位:由于眼外伤尤其是钝挫伤引起的晶状体悬韧带断裂,从而导致晶状体脱位,一般患者有明确的外伤史,多为单侧,且常伴有外伤性白内障、房角后退、继发性青光眼或视网膜震荡伤等其他眼部的外伤病变。
④自发性晶状体半脱位:常由于眼部炎症或变性疾病引起的悬韧带薄弱或眼内病变引起的悬韧带机械性拉长。炎症见于眼内炎或全眼球炎,长期慢性虹膜睫状体炎;变性见于视网膜脱离、高度近视、过熟期白内障、假性囊膜剥脱综合征、铁或铜锈症;机械性拉长见于牛眼、葡萄肿或眼球扩张也可见于其他眼内病变的牵拉或推拉如睫状体炎症粘连、PHPV、玻璃体条索、眼内肿瘤等。
3.处理方案及基本原则
(1)非手术治疗:对晶状体尚透明、未引起严重并发症的晶状体半脱位可作密切随访。
晶体源性屈光不正可通过凸透镜或角膜接触镜矫正以获得部分有用视力。
(2)手术治疗:
如晶状体脱位范围较大或无法完成前囊膜环形撕囊的患者,可行经睫状体平坦部/角巩膜缘晶状体切除联合前段玻璃体切割术,人工晶状体植入方式可选经巩膜固定后房型人工晶状体植入术、前房虹膜夹持型IOL植入术或周边虹膜缝线IOL固定术,术后需密切随访视网膜脱离等并发症发生。前房型人工晶状体植入因远期角膜内皮失代偿、继发性青光眼等并发症较多,不宜植入。对于晶状体脱位能完成前囊膜环形撕囊的患者,目前较为理想的手术方式是行晶状体吸除、MCTR和人工晶状体囊袋内植入术。术中可使用虹膜拉钩或囊袋拉钩稳定晶状体囊袋,使其居中;MCTR巩膜缝线固定,本术式最大的优点是尽量恢复晶状体囊袋的正常生理位置、不扰动玻璃体,减少玻璃体视网膜并发症的发生。
问题 1198
现病史
患者,男性, 71岁,主诉“左眼红痛3天伴视物模糊1天”, 14天前在我院行“左眼phaco+IOL术”。术中植入RaynerIOL,+19.5D, 术后常规可乐必妥眼药水、百力特眼药水、普南扑灵眼药水osqid。术后第一天情况:左眼视力0.3, 角膜透明,前房中深, Tyn(-),cell(-), IOL在位,玻璃体清亮, 黄斑水肿。今为求进一步诊治来我院门诊。
既往史:
眼部其他疾病: 左眼黄斑前膜史,右眼自幼外斜, 视力差。
全身系统:糖尿病病史2年。
用药史: 眼部用药见现病史。全身用胰岛素控制血糖。
外伤手术史:否认
过敏史: 否认
查体:
1)眼科专科检查如表23-1和图23-1所示。


辅助检查:
眼科辅助检查:包括B超/Pentacam等检查
B超: 左眼内未见明显异常回声。
Pentacam检查(图23-2):左眼前房浅伴周边虹膜前粘。

【问题1】
该患者的诊断及诊断依据
【问题2】
还需要与哪些疾病相鉴别?
【问题3】
该患者的处理方案及基本原则
答案:
1.诊断和诊断依据
(1)白内障手术史。
(2)术后2周左右出现眼红眼痛伴视力下降。
(3)前房变浅,虹膜前粘以及眼压升高。
(4)最早前房无积脓,虹膜激光打孔后出现前房积脓。
(5)虽然眼后段反应无或轻。
(6)激素全身和局部治疗后无好转,不断加重。
(7)玻璃体腔注药后前房积脓消失。
(8)糖尿病病史,患者免疫能力较低。
(9)玻璃体切除术后好转。
(10)囊袋内液细菌涂片阳性。
基于以上几点分析:初步诊断为1.左眼白内障术后眼内炎,尤其需与术后葡萄膜炎相鉴别。2.左眼继发闭角型青光眼(瞳孔阻滞型)。
2.鉴别诊断
(1)症状的鉴别诊断。
①白内障术后眼红眼痛:常见于青光眼发作、角结膜炎、感染性眼内炎和非感染性葡萄膜炎反应。
②视力下降:角膜水肿、感染性眼内炎,非感染性葡萄膜炎反应和眼底病变等等。
(2)眼内炎的鉴别诊断。
①非感染性术后炎症反应(葡萄膜炎反应):往往这类患者存在残留晶状体皮质或核块,或者切口玻璃体嵌顿等等,症状不严重,常被误诊为早期眼内炎。主要表现为前葡萄膜炎,且容易继发青光眼,B超眼后段反应无或轻,清除残留的晶状体物质可使炎症不再复发。目前由于IOL材料及加工物不合格,从而引起葡萄膜炎较少见。另外,眼内积血(沉积在IOL表面)也可能被误以为炎症渗出。一般激素治疗有效。糖尿病患者容易发生葡萄膜炎,绝大多数双眼受累,易发生虹膜红变、继发性青光眼等并发症,内眼术后容易发生严重的反应性葡萄膜炎或感染性眼内炎。两者往往难以区分,前房水、玻璃体或者晶状体囊袋内涂片或者细菌培养等进一步明确诊断。
②Tass综合征:葡萄膜炎反应的一个亚型,继发于眼前段手术后的急性、无菌性眼前段炎症,原因多种多样,术后短期内(12~48h);群发;无疼痛;角膜水肿;前房渗出/积脓;B超、病原学(-)。激素治疗有效。
③囊袋阻滞综合征:表现为囊袋内液体积聚,多位于IOL后表面,可发生在术后早期:1d-2w或者术后晚期2周以后。
④恶性青光眼:眼压高或部分可正常;前房浅;多发生在小梁切除或白内障术后。UBM检查可表现为:睫状体前旋,睫状突与晶状体赤道部和玻璃体前界面距离减少;晶状体(或人工晶状体)-虹膜隔或玻璃体-虹膜隔(无晶状体)显著前移;前房极浅或消失。需与瞳孔阻滞型青光眼鉴别(表23-4)。

3.处理方案及基本原则
本病治疗的基本原则是玻璃体腔注药或者玻璃体手术。
(1)玻璃体腔注药:目前治疗眼内炎最适合的玻璃体注射用药为:万古霉素1mg/0.1ml或去甲万古霉素0.8mg/ml+头孢他啶2-2.25mg/0.1ml;万古霉素1-2mg/0.1ml+阿米卡星0.4mg/0.1ml。
(2)玻璃体切除手术: 美国眼内炎玻璃体切除术研究(Endophthalmitis vitrectomy study, EVS)治疗规范:视力手动或以上:前房和玻璃体针吸活检以及玻璃体内注射抗生素;视力光感或以下:前房活检联合睫状体平坦部玻璃体切除术(PPV),以及玻璃体腔内注射抗生素。对于病情迅速恶化、糖尿病或者免疫功能低下患者,依临床情况判断是否积极采取PPV。也有研究认为早期玻璃体切除手术联合玻璃体抗生素注射比单纯玻璃体抗生素注射效果要好。
(3)全身抗生素:由感染因素引起的应选用敏感的抗生素全身或局部应用。尽管EVS认为全身抗生素治疗作用可能有争议,但相关研究可能存在一定的局限性,包括细菌种类以及采用的抗生素都不太一致。多数医师使用静脉滴注的方法来治疗细菌性眼内炎。随着技术的发展,全身抗生素如第四代氟喹诺酮类,抗细菌谱在扩大,且眼内渗透性不断增强,尤其对于眼内感染期,此时血眼屏障相对较弱。
(4)局部抗生素:在细菌药物敏感结果出来之前,可局部频点光谱抗生素眼水,可选择前房穿透性较好的抗生素,如氟喹诺酮类,尤其是第三代甚至第四代氟喹诺酮类眼水。
(6)激素的作用:同时联合抗生素治疗,降低眼内炎症反应。
问题 1199
现病史
患者,女性, 55岁,主诉“左眼白内障摘除玻切术后9个月”。患者9个月前因左眼孔源性视网膜脱离, 左眼白内障行左超声乳化,玻璃体切除视网膜复位注气术, 术后恢复良好,此次为行Ⅱ期人工晶状体植入来我院治疗。
既往史:
其他眼病史:近视, 度数不详
外伤史:否认
查体:
眼科专科检查如表24-1所示。




辅助检查:
眼部B超: 右眼玻璃体前中断少量点状回声,双眼视网膜未探及脱离回声带。
【问题1】
该患者的诊断及诊断依据
【问题2】
还需要与哪些疾病相鉴别?
【问题3】
该患者的处理方案及基本原则
答案:
1.诊断和诊断依据
无晶状体眼的诊断根据眼部的裂隙灯检查及既往的外伤手术史,不难诊断。
2.鉴别诊断
无晶状体眼有时要与晶状体全脱位鉴别。晶状体全脱位可以由外伤或先天因素导致晶状体悬韧带完全离断,使晶状体完全离开正常的生理位置,向前房或玻璃体腔移位。当晶状体完全脱位于玻璃体腔时,容易与无晶状体眼混淆。此时通过仔细询问病史和查体,不难鉴别。
3.处理方案及基本原则
无晶状体眼是一个高度远视眼。只有附加一个适当度数的凸透镜,才能使无晶状体眼得到光学矫正,形成清晰的影像。对无晶状体眼的光学矫正可分为三种类型:
角膜前矫正,即通过框架眼镜矫正
角膜平面矫正,即通过角膜接触镜矫正
眼内镜片矫正,即通过人工晶状体植入矫正
通过人工晶状体矫正无晶状体眼,与前两种矫正方法相比,由于人工晶状体最接近晶状体的生理位置,成像质量上具有如下优点:基本无放大作用,无球面差的烦扰。而且通过一次手术,免去了角膜接触镜那样每天清晰取戴的繁杂操作。
问题 1200
现病史
患者,女性, 58岁,主诉“左眼球胀痛伴头痛、恶心、呕吐2天”。2天前与家人吵架后出现左眼球胀痛, 伴有眼红、眼眶痛、头痛、恶心、呕吐等不适,有视力下降, 无脓性分泌物,曾至消化科就诊, 给予解痉治疗,未见好转反而加重, 遂至眼科就诊。
既往史:
家族史: 母亲有青光眼病史,具体不详。
用药史: 消化科就诊曾予654-2解痉,眼部尚未用药。
外伤手术史: 否认。
过敏史:否认。
眼部其他疾病史: 年轻时远视,且不到40岁即有老花眼。
查体:
眼科专科检查如表25-1所示。





辅助检查:
眼轴: 右眼21.68mm,左眼21.25mm。
B超: 左眼玻璃体全段少量混浊,未见视网膜脱离光带。
超声生物显微镜(UBM): 双眼前房浅,ACD: OD 1.57mm OS 1.49mm;双眼前房浅, 虹膜膨隆,根部附着点中前位, 睫状突轻度肥大旋前,右眼全周房角裂隙状或窄开(见图25-4), 左眼各方位虹膜-小梁接触(见图25-5)。


视野:右眼正常, 左眼弥漫性视敏度下降(见图25-6)。

【问题1】
该患者的诊断及诊断依据
【问题2】
还需要与哪些疾病相鉴别?
【问题3】
该患者的处理方案及基本原则
答案:
1.诊断和诊断依据
(1)左眼胀痛,发病2天,属于急性。
(2)有远视、眼轴短、前房浅的解剖基础,加上因吵架而导致情绪激动的诱因,后又使用654-2解痉药导致瞳孔阻滞进一步加重。
(3)结膜充血,角膜水肿,有色素性kp,前房浅,瞳孔中度大不圆,晶体见青光眼斑,眼压高达55mmHg。
(4)辅助UBM检查显示左眼全周房角关闭。
基于以上几点分析,以及三联征“角膜后色素性kp,虹膜局限萎缩,晶体青光眼斑”,初步诊断为“双眼原发性急性闭角型青光眼(右眼:临床前期,左眼:急性发作期)”。
2.鉴别诊断
(1)症状的鉴别诊断。
①眼痛:常见于葡萄膜炎、干眼症、睑缘炎、结膜炎、表层巩膜炎、发炎的胬肉、眼表异物、角膜疾病、隐形眼镜相关疾病、眼前段缺血综合征,等等。
②眼红:常见于角膜疾病、结膜炎、结膜下出血、葡萄膜炎、巩膜炎,等等。
(2)青光眼的鉴别诊断。
①继发性青光眼:多有原发病因,比如:外伤导致晶体半脱位继发闭角型青光眼、外伤导致房角后退,仔细询问病史,仔细检查对比双眼前房深度,通常晶体半脱位的眼前房更浅;仔细检查有无晶体、虹膜震颤等,加上UBM检查,可以帮助晶体半脱位的诊断。或者葡萄膜炎、全身有扩瞳作用药物引起继发闭角型青光眼,可双眼同时发病,不像原发性闭角型青光眼一般单眼发病,即使双眼发作通常也有先后顺序。
②原发性慢性闭角型青光眼:顾名思义其病情较慢,房角逐渐关闭,眼压多缓慢升高,患者大多无症状,体检或视野缺损至一定程度才发现。结合眼压、房角、眼底、视野等通常不难鉴别。
③原发性开角型青光眼:房角开放,发病隐匿,不易发现,没有明显症状,眼底可出现特征性青光眼损害(视神经杯盘比扩大、盘沿切迹、线状出血、神经纤维层缺损等)。
3.处理方案及基本原则
本病治疗的基本原则是缩小瞳孔、降低眼压、拮抗炎症:
(1)缩瞳:一旦临床诊断确定应立即使用缩瞳眼药水,可以频点,使瞳孔缩小,这是治疗的关键措施,其目的在于通过收缩瞳孔,解除瞳孔阻滞,使房水能顺利从后房流至前房,同时拉开房角,使房水能顺利经由小梁网排出。
(2)降眼压药物:可以全身使用高渗剂(甘露醇250ml静脉滴注)或口服降眼压药物(尼目克司1片 bid po,氯化钾缓释片1片 bid po),迅速把眼压降低,减轻患者眼痛症状,同时使用局部降眼压眼药水(美开朗眼药水 os bid,阿法根眼药水 os bid)来持久控制眼压。需要注意的是,口服降眼压药物尼目克司属于磺胺类药物,有该药过敏患者禁用;而且长期口服会引起手麻、肾结石、甚至剥脱性皮炎等严重并发症,不宜长期使用。
(3)抗炎治疗:青光眼急性发作时由于眼压很高,伴有强烈炎症,使用局部糖皮质激素类消炎药如:百力特眼药水,可以控制炎症,利于病情缓解。
(4)其他疗法:如药物不能缓解急性发作,可以试行激光治疗,发作眼做氩激光虹膜周边成形联合YAG激光虹膜打孔,对侧眼做YAG激光虹膜打孔预防发作;或者对于眼痛明显患者,可以对发作眼行前房穿刺放出部分房水,降低眼压。
(5)手术治疗:如经过前面保守治疗无效患者,或者经过药物治疗后急性发作缓解的患者,需要行青光眼手术,发作眼做小梁切除术或白内障摘除联合房角分离术;对侧眼可做激光或手术的虹膜根切治疗。
问题 1204
现病史
患者,男性, 46岁,主诉“左眼疼痛伴视物模糊3天”。3天前无明显诱因下出现左眼疼痛伴视物模糊, 伴有左侧头痛,偶有虹视现象伴恶心不适, 无明显眼部充血,未见脓性分泌物、无眼眶痛等不适, 今为求进一步诊治来我院门诊。
既往史:
眼部疾病史: 否认
外伤手术史:否认
过敏史: 否认
查体:
眼科专科检查如表28-1所示。


辅助检查:
青光眼OCT:双眼视乳头神经纤维层厚度及黄斑区神经节细胞复合体厚度位于正常范围。
电脑自动视野计: 双眼正常中心视野
UBM:双眼各方位均可见房角开放、虹膜平坦、晶体悬韧带位置正常。
【问题1】
该患者的诊断及诊断依据
【问题2】
还需要与哪些疾病相鉴别?
【问题3】
该患者的处理方案及基本原则
答案:
1.诊断和诊断依据
(1)单眼急性发作的眼痛头痛伴视力下降,检查提示眼压升高、角膜水肿,前房深度正常,视神经杯盘比、视网膜神经纤维层厚度、视野检查均正常,提示患者存在急性眼压升高的疾病。
(2)该患者房角镜下双眼睫状体带均可见,房角全周开放,UBM提示房角开放、虹膜平坦、晶体悬韧带正常。因此考虑继发开角型青光眼。
(3)该患者同时有睫状充血、角膜后羊脂状KP,前房轻度炎症细胞反应,因此首先考虑为青睫综合征。
基于以上几点分析:初步诊断为青睫综合征。
2.鉴别诊断
(1)症状的鉴别诊断。
①眼痛:急性发作的眼痛常见于青光眼、巩膜炎、葡萄膜炎、角膜疾病、隐形眼镜相关疾病等等。
②视力下降:常见于屈光不正、角膜疾病、白内障、青光眼、黄斑变性及视神经病变等。
(2)青光眼的鉴别诊断。
①房角的开放情况:依据房角镜及UBM的检查,需鉴别患者为开角型或者闭角型青光眼。
②原发与继发开角型青光眼的鉴别:继发开角型青光眼可见于色素性青光眼,假性剥脱性青光眼,部分外伤性或者晶体相关青光眼,眼内出血继发青光眼,玻切术后继发青光眼、巩膜静脉压升高等。
③前房炎症合并青光眼的鉴别:Fuch’s异色性虹膜炎,虹膜睫状体炎继发青光眼,晶体溶解性青光眼,部分表现为急性眼压升高合并前段不同程度的炎症反应并伴有其自身的特殊体征如虹膜颜色淡、瞳孔常用后黏连、晶状体溶解等,尤其是它们Kp的形态特征也不一样。
3.处理方案及基本原则
本病治疗的基本原则是首先局部使用抗炎和降眼压药物治疗,必要时使用全身静脉或者口服降眼压药物。当病情转变为慢性病程并且药物无法控制疾病进展时可施行滤过性手术治疗:
(1)局部抗炎药物治疗:如百力特眼水,前部炎症反应严重时可频点抗炎眼水。
(2)降眼压药物治疗:根据患者病情,可使用一种或者数种降眼压眼水,如β受体阻滞剂、α受体激动剂、碳酸酐酶抑制剂。必要时可加用全身或口服降眼压药物,如高渗药物或者碳酸酐酶抑制剂。
(3)滤过性手术:当病情转变为慢性病程并且药物无法控制疾病进展时可施行滤过性手术治疗,如小梁切除术。
问题 1205
现病史
患者、男、30岁,主诉“右眼被木棍打伤胀痛5天”。5天前, 患者不慎被木棍打伤右眼,当即眼痛视力下降, 在当地医院就诊,未手术治疗, 予典必殊tid点眼治疗后,视力无明显提高, 眼胀痛有加重趋势,伴恶心呕吐, 今为求进一步诊治来我院门诊。
既往史:
家族史: 无家族性遗传病史。
用药史:眼部用药见现病史, 否认全身用药史。
外伤手术史:详见现病史
过敏史: 否认
查体:
眼科专科检查如表29-1所示。



辅助检查:
超声生物显微镜:显示右眼前房不浅, 前房内探及中量点状回声(血细胞或炎症细胞可能),下方房角处探及凝血块形成, 如图29-2所示。

B超:右眼玻璃体内少-中量点状回声, 视网膜未探及明显异常。
【问题1】
该患者的诊断及诊断依据
【问题2】
还需要与哪些疾病相鉴别?
【问题3】
该患者的处理方案及基本原则
答案:
1.诊断和诊断依据
(1)患者有明确外伤史,外伤后导致的眼部视力下降伴眼部胀痛
(2)患者既往体检,否认糖尿病,高血压,也否认其他全身疾病史
(3)眼部体征可见前房积血,伴眼部高眼压的表现
(4)辅助检查可见患眼房角开放,但前房内较多红细胞或炎症细胞,下方凝血块在房角处,推测高眼压可能是前房积血导致的红细胞堵塞小梁网,或者炎症细胞堵塞小梁网,或者外伤导致的小梁网炎症水肿所致。
基于以上几点分析,初步诊断为:右眼钝挫伤,右眼前房积血,右眼继发性青光眼。
2.鉴别诊断
(1)症状的鉴别诊断。
①视力下降:可见于角膜炎、前房积血、白内障、晶体脱位、玻璃体出血、视网膜脱离、葡萄膜炎等
②眼胀痛:多见于青光眼眼压高,也可见于视物疲劳,虹膜炎等。
(2)前房积血继发青光眼的鉴别诊断。
①血影细胞青光眼:眼内出血后红细胞变形形成血影细胞,不能通过小梁网,阻碍了房水外流,引起眼压升高。其临床特征是多见于玻璃体积血后约2周,变性的红细胞通过破损的玻璃体前界面进入前房,前房内有许多小的土黄色的血影细胞在慢慢地循环,后期可沉淀如同前房积脓,房角开放。
②溶血性青光眼:为大量眼内出血后数天至数周内发生的一种开角型青光眼,系含血红蛋白的巨噬细胞、红细胞碎片阻塞小梁网,小梁细胞因因吞噬过多的血细胞后发生暂时功能障碍,造成房水引流受阻。临床特征是前房内红棕色的血细胞,房角检查见红棕色色素,房水细胞学检查含棕色色素的巨噬细胞。这种继发的高眼压多为自限性,主要用药物控制眼压和伴发的炎症,待小梁细胞功能恢复后可逐渐清楚这些阻碍物,使青光眼缓解。
③血黄素性青光眼:少见,发生在长期眼内出血者,系血红蛋白从变性的红细胞内释放出,小梁细胞吞噬该血红蛋白,血红蛋白中的铁离子释出,过多的铁离子可造成小梁网组织的铁锈症,使小梁组织变性,失去房水引流作用。一旦发生这种青光眼,小梁网的功能已失代偿,需行滤过性手术治疗。一般也可见到眼部组织也存在程度不同的铁锈症。
3.处理方案及基本原则
本病治疗的基本原则是促进血吸收和降眼压。
(1)减少继续出血和促进血吸收:通过限制活动以减少再出血,可药物治疗促进积血吸收。
(2)降眼压治疗:全身或局部降眼压药物应用降眼压治疗。
(3)若上述的办法无法使眼压下降,可前房穿刺放血冲洗,如果眼压仍不能控制,则应施行滤过性手术。
问题 1206
现病史
患者、男、60岁,主诉“右眼逐渐视力下降半年”。半年来, 患者无明显诱因下自觉右眼视力逐渐下降,否认眼红眼痛, 否认视物变形,今为诊治来我院门诊。
既往史:
家族史:否认家族性遗传病史。
用药史: 近期无全身及眼部用药史
外伤手术史:10年前右眼曾被石子打伤, 当时曾有前房出血视力下降,后经过保守治疗后视力恢复。
过敏史: 否认药物过敏史
查体:
眼科专科检查如表30-1所示。
辅助检查:
中心视野检查显示右眼出现明显的鼻侧视野缺损,如图30-4所示






【问题1】
该患者的诊断及诊断依据
【问题2】
还需要与哪些疾病相鉴别?
【问题3】
该患者的处理方案及基本原则
答案:
1.诊断和诊断依据
(1)患者右眼逐渐视力下降半年
(2)体检发现右眼眼压升高,视神经损伤明显,房角有大范围房角后退表现。
(3)患者十年前有右眼受钝挫伤史,曾出现过前房出血,后出血吸收视力好转。
基于以上几点分析,患者应该为右眼钝挫伤,房角后退,继发性青光眼。
2.鉴别诊断
(1)症状的鉴别诊断:
无眼痛的视力下降视野缩小:主要见慢性的青光眼,视网膜脱离,视网膜血管性疾病,白内障,视神经疾病等。
(2)青光眼的鉴别诊断:
①原发性开角型青光眼:多双眼发病,偶尔可见单眼发病,发病隐匿,表现为视野缩小或视力下降,眼压升高,有特征性视神经损害。房角检查为开角,一般看不到房角结构包括小梁网的明显异常。
②青睫综合征:多单眼发病,发作时表现为角膜上羊脂状KP,眼压升高,如果反复发作可以造成特征视神经损伤。房角结构为正常。
③激素性青光眼:由于局部或全身使用激素造成的眼压升高,可单眼患病,也可以双眼患病,有激素使用史,如果眼压控制不佳,会造成视神经的特征性损伤,可伴有后囊混为特征的并发性白内障,房角表现为开角。
3.处理方案及基本原则
本病治疗的基本原则是降眼压治疗,首选药物,若控制不佳,可选择手术治疗。
(1)药物治疗:用药原则与开角型青光眼类似。
(2)手术治疗:可选用各种滤过性手术。
但房角后退不一定都伴有眼压升高,如果仅有房角后退,而无眼压升高时,可建议定期随访。
问题 1207
现病史
患者,男性, 38岁,主诉“右眼疼痛伴视物模糊半月”。半月前无明显诱因下出现右眼胀痛、视物模糊, 伴眼红、畏光等不适,为求治疗来我院门诊。
既往史:
其他眼病史:近视。
系统回顾: 无殊
家族史:否认其他家族性遗传性疾病史。
用药史: 眼部用药见现病史,否认特殊全身用药史
外伤手术史: 否认手术外伤史
过敏史:否认
查体:
1)初诊眼科专科检查如表31-1所示。


辅助检查:
UBM检查如图31-5所示, OCT检查如图31-6所示,视野检查如图31-7所示。







【问题1】
该患者的诊断及诊断依据
【问题2】
还需要与哪些疾病相鉴别?
【问题3】
该患者的处理方案及基本原则
答案:
1.诊断和诊断依据
(1)年轻患者,中度近视;
(2)房角大量色素沉着,角膜后色素沉着;
(3)没有眼外伤、晶状体半脱位的继发因素;
(4)UBM提示虹膜中周部后凹,与晶状体悬韧带接触;
(5)测眼压明显高于正常,OCT显示上、下方RNFLD,并且视野出现上方弓形暗点。
基于以上几点分析:可以诊断右眼色素性青光眼。
2.鉴别诊断
(1)原发性开角型青光眼(原发性开角型青光眼):部分色素性青光眼患者角膜后色素比较少,不仔细查找容易遗漏,因而常误诊为原发性开角型青光眼,房角镜检查是鉴别两者的关键,原发性开角型青光眼房角正常,色素性青光眼患者房角可见致密、均匀的深棕色色素沉积在功能小梁网和schwalbe线上。合并高度近视眼的原发性开角型青光眼患者也会有周边虹膜的后凹,但通常不会造成色素播散。
(2)葡萄膜炎:反复发作的葡萄膜炎可导致房角色素增多,与色素性青光眼有类似之处。要做出正确的判断,必需注意到色素性青光眼的典型体征并且缺乏葡萄膜炎的其他症状,如结膜充血和虹膜后粘连。带状疱疹性角膜葡萄膜炎可引起扇形虹膜萎缩,单纯疱疹性角膜葡萄膜炎可引起广泛的虹膜萎缩,二者均与PDS样的虹膜透照缺损有区别。
(3)剥脱综合征:会出现类似色素性青光眼那样出现虹膜透照缺损、小梁色素沉着和眼压升高。然而剥脱综合征为年龄相关性疾病,下列情况容易做出鉴别:①60岁以上老年人多见,少见于40岁以下年龄;②50%患者为单侧性,无性别、屈光不正(近视)倾向;③透照缺损常见于瞳孔缘及其周围虹膜,罕见在中周部虹膜,小梁网色素沉着不如色素性青光眼那么浓密,且不规则;④最具鉴别特征的是瞳孔缘灰白色头皮屑样颗粒或絮片,周边晶状体前囊上的灰色假性剥脱物质。
(4)眼前节色素播散性疾病:可见于眼外伤,前、后节黑色素瘤。 虹膜、睫状体或后节黑色素瘤(如果玻璃体前界膜破裂)可能伴有色素播散。色素性瘤细胞或充满色素的吞噬细胞可以引起前、后房相当程度的变黑。但是缺乏色素播散综合征(pigment dispersion syndrome,PDS)和色素性青光眼(pigmentary glaucoma,PG)的体征:没有Krukenberg梭,没有任何透照缺损,且易于发现原发肿瘤,虹膜的炎症偶尔可有中等数量的色素释放,经常在下方房角内聚集成团,同时伴有炎症的表现。
(5)其他植入后房型人工晶状体后有时可引起PG,此时位置异常的后房型IOL与虹膜在术后长期接触、摩擦,导致色素释放。
3.处理方案及基本原则
对色素性青光眼常规治疗通常是先采用药物治疗、激光治疗,最后考虑手术治疗。
1.药物治疗:
缩瞳剂:既能解除虹膜悬韧带接触,从而阻止虹膜色素的播散,又能促进小梁网清除色素颗粒从而预防疾病进展和青光眼的发生。另外,它还能通过增加房水外流而降低眼压。
前列素类衍生物在PDS患者中有很好的降眼压效果。
房水生成抑制剂在理论上存在缺陷。它通过减少房水生成降低眼压,这样会降低小梁网对色素的清除率,从而促进疾病的进展。而且分泌到后房的房水减少会加重虹膜后凹从而使虹膜与悬韧带的接触更频繁,播散的色素更多。
2.激光治疗:
激光虹膜切开术(1aser peripheraliridotomy,LPI):PG的病因推测可能是由于反向性瞳孔阻滞造成虹膜向后弯曲导致虹膜-悬韧带摩擦。LPI能明显改善PDS患者的虹膜后凸状态,并可减少虹膜与晶状体悬韧带之间摩擦而导致的色素播散。国内学者对19例PDS患者实施LPI,经过6.5年的随访观察发现,所有患者的虹膜后凸消失、房角色素沉着减轻、眼压明显下降、视野稳定。国外也有不少研究证实LPI能够改善PDS的虹膜状态,但其是否有利于对色素性青光眼长期控制眼压,尚需通过随机对照临床研究加以证实。2011年英国Moorfields眼科医院完成了为期3年的前瞻性随机对照研究,将116例已经出现眼压升高的PDS患者随机分为LPI治疗组和无LPI对照组,结果发现不论是视野缺损进展,还是降眼压用药情况,两组均无显著差别,提示对于眼压已经升高的PDS患者,LPI虽然可能减少色素播散,但是长期控制眼压的作用甚微。
氩激光小梁成形术(ALT)和选择性小梁成形术(SLT):ALT已被报道用于PG患者获得成功,但是与开角型青光眼患者相比,大部分PG患者治疗一段时间后眼压失控。有报道尽管在10个PG患者(13只眼)最初眼压平均下降10.6mmHg,9个月内眼压升高到治疗前水平。成功率与年龄相关。有报道显示33只眼,ALT治疗结果发现,1年成功率80%,2年62%,6年45%。年轻人5年内眼压控制率72%。说明ALT用于色素性青光眼是有效的,而且年轻人比老年患者有较多的成功机会,而且3年后有显著性差异(P<0.001)。ALT时需要注意的是小梁网色素的增加使其对能量的吸收增大,所以治疗中需要的能量较低,避免治疗过度损害小梁网,引起永久性眼压升高。有研究对30例确诊为色素性青光眼的患者行SLT治疗,其治疗标准为有以下任意一项者为治疗失败:眼压降低幅度小于20%;改为药物降眼压;需要再次进行SLT治疗;最终需要手术治疗,结果显示SLT术后1年的成功率为85%,术后2年的成功率约为67%。
周边虹膜成形术:氩激光周边虹膜成形术治疗后,使后陷的虹膜立即变平。但是PDS/PG中周部虹膜变平不是永久的,虹膜会再次变得后陷。目前还没有阻止虹膜再次后陷的方法。经氩激光周边虹膜成形术的患者长期观察,显示在虹膜治疗区域,虹膜后陷比治疗前增大。因此不建议采用激光周边虹膜成形术。
3.手术治疗:
药物和激光治疗后,若眼压降低不理想,或仍不能避免视盘进一步损害和视野恶化,需要考虑滤过手术。
问题 1208
现病史
患者,男性, 45岁,主诉“左眼小梁切除术后, 眼胀2周”。患者左眼视力下降3月,3周前在当地医院就诊, 检查发现眼压od 25mmHg,os 30mmHg, 左眼C/D0.8伴视野缺损,房角部分关闭, 拟“慢性闭角型青光眼”予1%毛果芸香碱ou tid,Timolol ou bid。2周前局麻下前左眼行小梁切除术, 手术顺利,术后抗炎治疗。术后第一天即发现浅前房、眼压40mmHg, 予阿托品眼药水 os tid,典必殊眼药水 os tid, 尼目克司 25 mg bid,Timolol os bid。经扩瞳、降眼压治疗未见好转, 转我院治疗。
既往史:
消化系统: 无殊
家族史:母亲患闭角型青光眼曾行抗青光眼手术, 姐姐患急性闭角型青光眼曾行双眼周边虹膜切除术
用药史:眼部用药见现病史, 否认全身用药
外伤手术史:眼部手术见现病史
过敏史: 否认
查体:
眼科专科检查如表32-1所示。


辅助检查:
眼B超:左眼玻璃体少量混浊伴后脱离。
UBM: 左眼仅存中央前房,ACD=0.56mm, 前房见点状混浊(见图32-1)。晶状体虹膜隔前移,虹膜贴于角膜, 全周后房消失,睫状突受压扁平, 玻璃体前界膜前突(见图32-2),玻璃体前界膜-睫状突-晶状体赤道部三者紧密相贴。上方小梁内口为晶状体赤道部阻塞。


周边及中心视野: Goldmann视野右眼正常,左眼管状视野。Octopus 30-2右眼鼻上旁中心暗点, 左眼管状视野。
【问题1】
该患者的诊断及诊断依据
【问题2】
还需要与哪些疾病相鉴别?
【问题3】
该患者的处理方案及基本原则
答案:
1.诊断和诊断依据
(1)闭角型青光眼外引流术后浅前房、高眼压
(2)可见通畅的周边虹膜切除口,UBM也排除瞳孔阻滞
(3)UBM见周边玻璃体前隆,证实睫状体-玻璃体-晶状体阻滞
基于以上几点分析:初步诊断为恶性青光眼。
2.鉴别诊断
外引流术后浅前房的鉴别诊断。
①浅前房伴低眼压:常见于结膜伤口漏、引流过畅、睫状体和或脉络膜脱离。
②浅前房伴高眼压:常见于恶性青光眼、脉络膜上腔出血、瞳孔阻滞伴引流口堵塞。
本例为浅前房伴高眼压,B超排除脉络膜上腔出血,UBM排除瞳孔阻滞。
3.处理方案及基本原则
本病约一半的恶性青光眼通过药物治疗可以缓解,另一半需要手术,药物治疗缓解后又复发的病例也建议手术治疗。
药物治疗
(1)强力散瞳:2%阿托品tid或1%阿托品qid,可辅以美多丽tid。散瞳药扩张睫状环、减轻睫状体水肿,并能后拉前移的晶状体。部分病例需低频度阿托品维持使用,停药后易复发。
(2)抑制房水生成:减少流入玻璃体的房水,并降低眼压。
(3)皮质激素:加强抗炎治疗,改善睫状环-(周边玻璃体)-晶状体阻滞程度。
(4)脱水剂:静滴甘露醇通过玻璃体脱水、脉络膜缩容有向后回拉晶状体的作用。
手术治疗
目的是勾通玻璃体腔和前房,打破晶状体(或人工晶状体)虹膜隔对房水的阻碍作用,使得向后异常引流的房水能够回流到前房,可采用的方式为:
(1)超声乳化晶状体吸除+全玻璃体切除+周边虹膜切除及对应周切口的悬韧带、囊膜切除:要求彻底清除周切口附近的周边前玻璃体,可囊袋内植入IOL或保留原来的IOL。
(2)超声乳化晶状体吸除+中央后囊切除+中央玻璃体切除:IOL植入睫状沟,要求CCC有部分超过IOL光学区。
如无玻璃体切割条件,也可采用经扁平部玻璃体穿刺抽液术:向后异常引流的房水积存在玻璃体中形成水囊,抽吸出水囊内的液体同时做前房成形术可使周边玻璃体向后回退,房水不再向后引流。使用该方法复发机会较多。
问题 1209
现病史:
患者, 女性,49岁, 汉族,主诉“双眼视物模糊伴胀痛二十余天”。患者二十余天前自觉“感冒”头痛后出现双眼视物模糊, 不伴眼红、畏光等不适,无脓性分泌物、无虹视、无眼眶痛等不适, 于当地医院就诊,拟诊为“双眼原发性急性闭角型青光眼大发作”, 予毛果芸香碱眼水q15min点眼×4次,后改Bid, 派立明眼水Bid点眼,美开朗眼水Bid点眼, 治疗近一周,未见明显好转, 今为求进一步诊治来我院门诊。
既往史:
眼病史: 无殊
家族史:无殊
用药史: 无殊
外伤手术史:否认
过敏史: 否认
查体:
眼科专科检查如表33-1所示。


辅助检查:
B超示双眼玻璃体中后段少量点状回声,后脱离带状回声不明显, 双眼各方位睫状体脉络膜脱离回声带0.5~1mm,双眼视网膜脱离回声带0.5~1mm, 方位:后极、下方, 双眼后极脉络膜水肿增厚。
【问题1】
该患者的诊断及诊断依据
【问题2】
还需要与哪些疾病相鉴别?
【问题3】
该患者的处理方案及基本原则
答案:
1.诊断和诊断依据
(1)双眼视物模糊伴胀痛,发病二十余天
(2)有类似感冒的头痛症状,可能提示某种有全身症状的综合征
(3)原发性闭角型青光眼急性大发作多为单眼发作,自然情况下双眼同时发作较为少见。
(4)近视漂移现象,发病后表现为近视-3.25D,-4.0D
(5)常规原发急性闭角型青光眼大发作的治疗,如缩瞳降眼压、周边虹膜切除术治疗无效甚至恶化
(6)视网膜水肿,渗出性视网膜脱离表现
(7)UBM检查显示双眼前房浅,房角大部关闭,全周睫状体-脉络膜浅脱离
(8)FFA提示葡萄膜炎表现
基于以上几点分析:双眼继发性闭角型青光眼(睫状体/脉络膜渗出),双眼伏格特-小柳-原田综合征(VKH综合征)
2.鉴别诊断
(1)症状的鉴别诊断
①视物模糊:为非特异性症状,从角膜开始往后的屈光间质至视中枢的任何一个环节出现问题均可出现,但双眼同时同程度的急性发作常见于青光眼发作(原发性开角型)、严重干眼症、隐形眼镜相关疾病、葡萄膜炎、免疫或中毒相关的视神经疾病等等。
②眼球胀痛:常见于视疲劳、青光眼时眼压增高等等。
(2)青光眼的鉴别诊断。
①开角型/闭角型:确定好房角状态是诊断的第一步,裂隙灯下房角镜检查是区分前房角开/闭的金标准,本患者房角镜下动态检查右眼上方和鼻侧关闭,余间断可见巩膜突;左眼下方可见功能小梁,余象限全关闭。双眼房角关闭均在半圈以上,可认为其眼压升高的机制为房角关闭。
②原发性/继发性:确立了闭角型的诊断后需判断闭角有否继发于其他因素,本患者的临床特征与常见原发性闭角型青光眼大发作有诸多差异(见2.诊断与诊断依据部分)
③引起继发性闭角型青光眼的原因:可分为炎症性、占位性、手术或外伤源性、晶体源性和药物源性等。继发性房角关闭发病机制分为瞳孔阻滞和非瞳孔阻滞,而非瞳孔阻滞包括前部牵拉或后部顶压引起房角关闭。
本病例即为由于后部顶压机制引起非瞳孔阻滞型继发性闭角型青光眼,其发病机制为睫状体水肿、旋前,晶体虹膜膈前移,后部顶压引发房角关闭。
3.处理方案及基本原则
本病治疗的基本原则是治疗原发疾病VKH,以及应用睫状肌松弛剂、降低眼压。如误诊为原发性闭角型青光眼,应用缩瞳剂治疗常引起病情加重,激光虹膜周切术治疗无效。
(1)皮质类固醇:全身口服或静脉滴注糖皮质激素维持三个月或更长时间后逐渐减量;局部眼球旁注射甲基强的松龙20-40mg。
(2)免疫抑制剂:不能耐受激素治疗或无效者可使用环孢素。
(3)睫状体松弛剂:其目的在于放松睫状肌,拉紧晶状体韧带,促使晶体虹膜膈后移,房角开放,降低眼压,对于存在眼前段炎症的VKH患者,应用睫状体松弛剂还可以同时扩大瞳孔预防虹膜后粘连。
(4)降低眼压:眼压增高时,可同时应用降眼压药物。
问题 1210
现病史:
患者, 男性,42岁, 主诉“体检发现双眼视杯扩大1个月”。1月前患者单位体检发现双眼杯盘比偏大,并伴有双眼眼干, 胀痛不适,不伴眼红、畏光等不适, 无脓性分泌物、无虹视,曾可乐必妥眼水tid点眼一周, 未有明显好转,今为求进一步诊治来我院门诊。
既往史: 无特殊
家族史:无
用药史: 眼部用药见现病史,否认全身用药史
外伤手术史: 否认
过敏史:否认
查体:
眼科专科检查如表34-1所示。


辅助检查:
(1)影像学检查: 如图34-31~图34-5所示。





(2)头颅CT:未见异常。
(3)角膜厚度: 右眼554μm,左眼551μm。
(4)24小时眼压: 右眼10.4~17.3mmHg,左眼10~16mmHg。
【问题1】
该患者的诊断及诊断依据
【问题2】
还需要与哪些疾病相鉴别?
【问题3】
该患者的处理方案及基本原则
答案:
1.诊断和诊断依据
(1)前节正常,眼底检查尤为重要,发现C/D扩大,双眼下方盘沿变窄,可见RNFLD;
(2)辅助检查OCT出现RNFLD,并在相对应部位出现视野暗点及缺损;
(3)24小时眼压检测显示患者眼压始终在正常范围之内;
(4)X线,CT,MRI等显示颅内和眶内无异常。
2.鉴别诊断
(1)原发性开角性青光眼:在《我国原发性青光眼诊断和治疗专家共识》中,将正常眼压型青光眼与高眼压型原发性开角型青光眼同归类为原发性开角型青光眼,归属于一类疾病的两个亚型,分界点在于眼压是在正常范围还是高于21mmHg(1mmHg=0.133kPa)。已有多项研究结果显示两者的发病机制、临床特征、进展危险因素及治疗方法均有差异。例如眼压降至12mmHg以下可以基本阻止原发性开角型青光眼视野恶化,但是对于NTG而言,只能延缓视野进展,这些都提示:NTG发病机理中非压力依赖因素成分较多。多项研究已描述了NTG和高眼压性开角型青光眼在视神经和视野损害中的差异,与原发性开角型青光眼相比,NTG患者的视盘更大,盘沿更窄更倾斜,且视神经颜色较苍白;NTG患者的视盘出血更为常见,通常是典型的线状、梭形或火焰状,最常见的视盘出血位于视盘的上下两极,多在颞下方,并且视盘出血是NTG疾病进展的预测指标;NTG患者的盘沿切迹更常见,通常在视盘出血的同一部位;在NTG患者中,楔形RNFLD的发生频率较弥漫性RNFLD更高;NTG的视神经损害和视野缺损可能更呈局限性;另外NTG较原发性开角型青光眼具有较大的C/D值、较小的C/D面积比和较窄的盘沿面积,RNFLD严重。原发性开角型青光眼患者的RNFLD以弥漫性为主,而NTG则以局限性为主。
(2)其他类型的青光眼:如慢性闭角型青光眼的早期,青光眼睫状体炎综合征、激素性青光眼、色素播散综合征、眼外伤及葡萄膜炎引起的青光眼均有可能存在一过性眼压升高,造成青光眼性视神经及视盘损害,易误诊为NTG,需要详细询问病史,进行仔细的眼部检查,包括房角检查加以鉴别。
(3)近视:近视眼尤其是高度近视眼的视盘凹陷常常比一般人大,容易误认为青光眼性视盘凹陷,并且部分患者因脉络膜视网膜变性萎缩可有视野缺损而更易误诊。同时有些高度近视的患者由于视盘有斜度,视杯呈斜坡状,因此合并青光眼有视杯扩大时不易鉴别。应仔细检查视盘凹陷的形态及视网膜脉络膜萎缩的部位并与视野缺损对照比较,评估视野缺损的诊断价值,早期病例可以随访观察一段时间,评估视野及OCT是否有进展。
(4)缺血性视神经病变:本病多发生视盘萎缩或部分萎缩,一般不发生凹陷增大,但也有一些患者在视神经急性缺血性损害之后也出现了类似于青光眼性的视杯扩大,例如巨细胞动脉的患者。需要与NTG患者相鉴别。但缺血性视神经病变的患者有以下特点:①起病较急,呈急性或亚急性经过,常有视力突然下降的病史,可伴有头疼或眼疼等不适。②视盘萎缩以受累区域颜色苍白为著,苍白范围明显大于凹陷范围。③视野缺损常累及固视点,表现为不以水平中线或垂直中线为界限的与生理盲点相连的弧型缺损,呈水平半盲或象限盲。④FFA早期表现为小血管扩张,异常荧光渗漏,使视盘边界呈模糊的强荧光。到晚期可表现为迟缓充盈及弱荧光。⑤常伴有巨细胞动脉炎、梅毒型动脉炎、胶原病及糖尿病、高血压动脉硬化等。因此,仔细询问病史并结合眼底检查及荧光血管造影,必要时动态观察其视盘变化多可鉴别。
(5)视交叉和视神经压迫性病变:视神经和视交叉的压迫性病变引起的视盘萎缩一般不同于青光眼性视杯扩大,但也有少数非青光眼性视神经萎缩患者的视杯很大,容易误诊为NTG。有些颅内病变还可造成与青光眼相似的视野缺损。因此,在诊断NTG患者时应排除颅内压迫性病变的可能
3.处理方案及基本原则
NTG的眼压虽然在正常范围内,但已超过患者视神经所能耐受的能力,眼压仍为NTG进展的“危险因素”,据此提出将眼压降到低于正常的治疗方案,即维持低眼压水平,以保护视神经,减缓视野缺损的进展。除眼压外,还存在其他多种因素对NTG的影响。因此,在治疗上降低眼压的同时要联合运用改善视盘血液灌注的药物,以及保护视神经的药物等多种治疗手段。
降压药物的选择:适用于原发性开角型青光眼的药物都可应用于NTG患者。但有报道噻吗心安可加重NTG患眼的视野缺损,可能是β-肾上腺素能阻滞剂可诱发或加重夜间低血压,从而减少视盘的血流灌注之故。前列腺素类药,降眼压作用显著,并且能产生持续恒定的眼压下降,可以作为NTG的一线用药。
手术降眼压治疗有报道NTG的眼压必须降低基础眼压的30%以上,才可能阻止视野的进一步损害。仅仅依靠药物,部分NTG的眼压是达不到这一水平的,所以对于病情进展明显、不能耐受药物治疗的患者,可以考虑SLT以及青光眼滤过性手术。
问题 1211
现病史:
患者, 男性,3月龄, 主诉“畏光流泪2个月”。患儿自生后一个月起,出现畏光流泪现象, 无明显眼红,不伴脓性分泌物, 并逐渐出现眼黑发雾,在当地医院就诊后, 使用托百士滴眼液,间断使用一个月, 未见好转,为求进一步诊治来我院门诊。
既往史:
出生史:足月顺产, 无吸氧史
家族史:父母否认眼部疾病史
用药史: 眼部用药见现病史,否认全身用药
外伤手术史: 否认
过敏史:否认
查体:
眼科专科检查如表35-1所示。



辅助检查:
B超: 双眼玻璃体全段少量点状回声,双眼视盘轻度凹陷
UBM: 双眼前房中深,虹膜平坦僵直, 虹膜偏薄,根部附着点前位, 睫状突细长拉伸,各方位房角开放
【问题1】
该患者的诊断及诊断依据
【问题2】
还需要与哪些疾病相鉴别?
【问题3】
该患者的处理方案及基本原则
答案:
1.诊断和诊断依据
(1)畏光、流量、眼睑痉挛的典型症状
(2)眼压:服用水合氯醛,Tonopen眼压计测量为OD32mmHg,OS37mmHg
(3)角膜:双眼角膜直径12mm左右,混浊,Haab(+)
(4)眼底:C/D扩大,ODC/D0.5,OSC/D0.6
(5)房角:房角检查常见厚实的深棕色带覆盖在从整个小梁网到周边虹膜的区域
基于以上几点分析:初步诊断为发育性青光眼(原发性婴幼儿型)。
2.鉴别诊断
(1)症状的鉴别诊断。
①大角膜:需和先天性大角膜鉴别。
②角膜混浊:需和巩角膜、代谢性疾病、角膜后部多形性营养不良、先天性遗传性角膜内皮营养不良、产伤、先天性梅毒性角膜实质炎鉴别。
③畏光流泪:需和倒睫、先天性泪道阻塞、角膜营养不良鉴别。
④视神经异常:需和先天性视乳头小凹、先天性视乳头缺损、先天性大视杯鉴别。
⑤高眼压:需和球内占位、代谢性疾病、伴有其他发育异常鉴别。
(2)几个比较容易混淆的疾病。
①先天性大角膜:双眼发病,90%见于男性,属性连锁隐性遗传。角膜透明,直径常为14~16mm,可伴有深前房、虹膜震颤以及屈光度异常,但是大角膜无后弹力层的破裂,无眼压升高及视神经乳头杯凹扩大等原发性婴幼儿型青光眼征象、
②先天性遗传性角膜内皮营养不良:常染色体隐性遗传性疾病。临床表现畏光流泪及视力下降,特点是双眼角膜水肿混浊,但角膜大小正常,无眼压升高。初期角膜呈雾状混浊,实质层呈毛玻璃样混浊,角膜中央较重,逐渐向周边扩张,最后全角膜弥漫性极度增厚。后期角膜可有带状变性,瘢痕以及新生血管。
③Axenfeld-Rieger综合征:常染色显性遗传,双眼发病,无性别差异,可起病于婴儿、但更多见于青少年,典型的改变为角膜后胚胎环,即Schwalbe线增殖突出和前移,虹膜可以从完全正常到轻微的基质变薄,到明显的虹膜萎缩,并有孔洞的形成,瞳孔异位,色素领外翻,全身异常最常见的的是牙齿和面骨的发育异常。
④先天性无虹膜:多为常染色体显性遗传。常有严重的畏光,可伴有黄斑发育不良,角膜混浊,白内障,青光眼,屈光不正,脉络膜缺失,上睑下垂等。有较多的患者早期就有周边角膜血管翳及角膜混浊,随着年龄增长逐渐紧张至角膜中央部。无虹膜伴泌尿生殖系统先天异常和智力低下被称为ARG三联征。
3.处理方案及基本原则
本病治疗的基本原则是尽早手术治疗:
(1)外路小梁切开术和房角切开术为首选,特点是术后不需滤过泡引流,其房水循环仍未生理性的外流途径,可多次施行,还可再行滤过性手术。首次手术成功率很高,特别是1岁以内的患者。50%的先天性青光眼患儿的角膜不透明,影响到房角的观察,所以外路小梁切开术比房角切开术更适用。小梁切开术后通常需要使用毛果芸香碱滴眼液3个月,以防止周边虹膜的粘连到小梁切开口。
(2)药物治疗效果不满意,只能作为辅助或者过渡手段,常用的药物有:缩瞳剂,β受体阻断剂,碳酸酐酶抑制剂等。这些药物可以有效的暂时性的降低眼压,使得角膜水肿好转,便于手术,也可以作为术后眼压控制不理想的辅助治疗。
(3)滤过性手术:包括小梁切除术,减压阀植入术,Express植入术等,手术方法和成人相同,但术后效果均明显地差于成年人,且婴幼儿青光眼眼球增大,角膜缘增宽,球壁变薄,手术难度加大,术中术后眼压的骤降容易导致脉络膜上腔的爆发性出血。
问题 1213
现病史:
患者, 男性,65岁, 主诉“双眼红,视力下降3月”, 3月前无明显诱因下出现双眼红,伴有视力下降, 无眼痛、无畏光、无虹视、无视物变形等不适,1月前曾于外院就诊, 诊断为双眼葡萄膜炎,予以头孢呋欣1.5静滴bid+地塞米松5mg静滴qd, 治疗了一周,无改善, 继续恶化,为求进一步诊治, 来我院就诊。
既往史:
眼部: 双眼近视-4.0D。
全身:糖尿病史6年, 口服降糖药物,控制尚可。
用药史: 眼部用药史见现病史,2月前曾有牙痛史, 口服抗生素药物治疗。
否认外伤史及其他全身病史。
否认过敏史。
否认家族史。
查体:
既往体格检查: 发病后2月于外院的体格检查记录
(1)裸眼视力:OD: LP/OS:0.04
(2)眼压: OD12mmHgOS16mmHg
(3)双眼结膜充血,前房积脓, 瞳孔不规则中等大,光反应消失, 眼底不清
(4)初诊:双眼葡萄膜炎?
(5)辅检:C反应蛋白升高
入院时眼科专科检查如表37-1所示。




我院治疗半月后, 视力进一步下降,OD: HM/BE(矫无助)
角膜病灶略好转,但前房积脓明显加重, 见图37-3,图37-4所示。


辅助检查:
(1)结核菌素纯蛋白衍化物(PPD)检查:阴性。
胸部X线: 未见明显异常。
血管紧张素酶(ACE):阴性。
人类白细胞抗原HLA-B27: 阳性。
梅毒检测:阴性。
HIV检测: 阴性。
血常规:WBC11.42, N68%。
肾功能:BUN11.1mmol/L。
(2)眼部B超检查
首诊B超(见图37-5)结论: 右眼玻璃体前中段中-大量点状回声,颞下球壁前波浪样带状强回声, 距离球壁3~4,脉脱1~6mm, 左眼前中段少-中量点状回声,双眼后极球壁前带状回声, 双眼玻璃体混浊伴后脱离可能,后极网膜水肿可能, 右眼玻璃体混浊伴网脱脉脱可能。

2日后复查B超(见图37-6)结论:右眼玻璃体前中段中-大量点状回声, 后极下方球壁前带状强回声,距离球壁1~3, 后极球壁前轻度隆起低-中等回声。后极偏下球外壁短条状强回声,声影, 左眼前中段少-中量点状回声,后极球壁前带状回声, 双眼玻璃体混浊伴后脱离可能,右眼网脱、后极脉络膜水肿增厚可能, 右眼球壁钙化?左眼后极网膜水肿低脱可能。

高频B超检查(见图37-7)结果: 右眼除上方外球壁前波浪样双线状回声,距离球壁1~3mm
双眼后极及各方位球壁前弥漫性轻度增厚中等回声, 右眼0.75mm,左眼0.41mm。双眼弥漫性葡萄膜增厚, 右眼视网膜脱离伴睫状体脱离可能。转移性葡萄膜实质性占位?肉芽肿性葡萄膜炎?

(3)超声生物显微镜(UBM)检查(图37-8)

结论:右眼角膜水肿, 前房不浅伴大量浮游颗粒(下方为甚),各方位睫状突水肿肥厚伴睫状体浅脱离, 各方位虹膜根部与小梁组织接触,虹膜较厚, 各方位悬韧带回声稀疏,晶体赤道部与睫状突间距未见明显不对称。
左眼前房不浅伴浮游颗粒(下方为甚), 各方位睫状突水肿肥厚伴睫状体浅脱离,下方房角见点状中等回声(渗出? ),余方位房角开放, 虹膜膨隆,各方位瞳孔区虹膜与晶体前表面接触(虹膜后粘? )。各方位悬韧带回声稀疏,晶体赤道部与睫状突间距未见明显不对称。
提示: 双眼睫状体水肿浅脱前房积脓,左眼瞳孔后粘连。
复查UBM检查, 结果如下:双眼前后房混浊, 下方见致密积脓,虹膜弥漫性增厚伴荷叶样皱褶, 以右眼为甚,回声不均匀减低, 各方位睫状体显著增厚,回声不均匀减低, 睫状突融合,伴裂隙状浅脱离, 各方位房角基本开放。
提示:双眼葡萄膜实质性占位? 肉芽肿性葡萄膜炎?
建议排查淋巴造血系统肿瘤。
(4)CT检查:
肺纹理增双多,右肺上叶见小片状模糊影, 右肺门结构增大,胸膜增厚, 少许胸腔积液双侧肾上部见增大肿块,约6.1X8.9cm左侧胰尾区见肿块, 约5.3X7.3cm,密度不均
(5)前房积脓细胞病理
非霍奇金氏淋巴瘤可能。
【问题1】
该患者的诊断及诊断依据
【问题2】
还需要与哪些疾病相鉴别?
【问题3】
该患者的处理方案及基本原则
答案:
1.诊断和诊断依据
(1)双眼红,视力下降3月。
(2)双眼“前房积脓”,玻璃体大量点状混浊。
(3)排除其他种类葡萄膜炎可能。
(4)B超及UBM示葡萄膜广泛增厚。
(5)细胞病理示非霍奇金氏淋巴瘤可能。
(6)CT示肺部、肾脏、胰腺多发占位。
基于以上几点分析:考虑诊断为淋巴瘤可能。
2.鉴别诊断
(1)症状的鉴别诊断
1)眼红:可见于结膜炎,包括细菌性、病毒性、化学性、过敏性、药物毒性,见于角结膜炎,结膜下出血或结膜异物,类天疱疮,角膜炎,角膜异物,眼外伤,干眼症,眼内炎,葡萄膜炎,巩膜炎,青光眼等。
2)视力下降:
①一过性视力丧失:常见于视乳头水肿,一过性缺血发作,椎基底动脉供血不足,偏头疼,视网膜中央静脉阻塞前兆,缺血性视神经病变,眼部缺血综合征,中枢神经系疾病。
②持续性视力丧失:
急性无痛性视力丧失,常见于视网膜动静脉阻塞,缺血性视神经病变,玻璃体积血、视网膜脱落,球后视神经炎。
③渐进性无痛性视力障碍,常见于开角型青光眼,黄斑病变,糖尿病视网膜病变。
伴有眼痛的视力丧失,常见于急性闭角型青光眼,眼内炎,葡萄膜炎,圆锥角膜等。
3)前房积脓:
常见于感染性角膜溃疡,眼内炎,重度虹膜睫状体炎,人工晶体刺激,白内障术后晶体皮质残留,眼前节毒性综合征,眼内肿瘤坏死等导致的假性前房积脓。
(2)淋巴瘤的鉴别诊断
2)淋巴瘤的鉴别诊断
(1)与眼部相关的淋巴瘤概论
主要包括原发性眼内淋巴瘤、原发性葡萄膜淋巴瘤、转移性眼内淋巴瘤:①病理来源以非霍奇金淋巴瘤NHL多见,霍奇金淋巴瘤少见。②总体临床表现特点为眼红、视物模糊、眼前漂浮物等难治性葡萄膜炎。③全身NHL转移至眼部:集中浸润脉络膜;全身表现:发热、体重下降、淋巴腺病;④中枢神经系统淋巴瘤(原发性眼内淋巴瘤):浸润视网膜、视神经、玻璃体;起源于CNS或眼部的,CNS外全身转移罕见;⑤原发性葡萄膜淋巴瘤:是相对少见的淋巴瘤类型;临床病程上为惰性,多属于低度恶性B细胞型;预后非常好,通常不侵犯中枢神经系统。
(2)原发性眼内淋巴瘤的具体情况
①视网膜出血、渗出,血管炎、视网膜炎、玻璃体混浊、前房积血或积脓、视盘水肿、视网膜下肿物。
②视网膜表面多发性病灶:黄白色奶油状、小的圆形或椭圆形、边界清晰。
③神经系统症状
④放化疗为主,预后较差
(3)转移性眼内淋巴瘤的具体情况
①淋巴瘤是一类原发于淋巴结和(或)结外淋巴组织的恶性肿瘤,侵犯全身各个部位或组织。
②B细胞型NHL:胃肠道(20%)、眼部(10%)、扁桃体(9%)。
③T/NK细胞型NHL:鼻腔及咽喉部(47%)、皮肤(11%)、胃肠道(6%)。
④HL:淋巴结起病。
⑤约1/3的NHL可同时累及胰腺,肿瘤直径2~15cm,平均约6.0cm。
⑥累及肺淋巴瘤影像学表现多样性。
(4)葡萄膜的无色素性黑色素瘤:B型超声波特征性改变包括球形或蘑菇状实性肿物、肿瘤内声空区、脉络膜凹陷等FFA显示斑点状高荧光和双循环现象(即瘤体内血管和视网膜血管同时显影)。
(5)眼内炎。
(6)葡萄膜炎:结核、梅毒等。
(7)其他眼部原发肿瘤:弥漫生长型Rb、黑色素瘤。
(8)其他眼部转移癌:乳腺癌、肺癌。
3.处理方案及基本原则
成人原发性中枢神经系统淋巴瘤和原发性眼内淋巴瘤诊断及治疗指南。
1.原发性中枢神经系统淋巴瘤的诊断必须通过组织学诊断确立。一旦怀疑为PCNSL,立体导向活检优于外科手术,手术切除治疗没有意义。PCNSL和PIOI的活检标本应送病理中心复核。在取活检之前,尽可能避免使用皮质激素(c级,Ⅳ)。
2.分期应包括胸部、腹部和盆腔CT扫描,老年男性应超声检查睾丸,腰穿脑脊液应定量检测蛋白/糖、细胞学检测、流式细胞学和免疫球蛋白基因重排检测,以及眼前房、玻璃体和眼底的检查。对于眼内的病变应该取活检,对怀疑HIV感染的患者应确认或者排除(c级,N)。
3.应对预后进行评分,包括:年龄>60岁、体力状态>1、LDH增高、脑脊液蛋白定量增高和深部脑实质受累(C级,N)。
4.在征得治疗知情同意时,应告知患者及家属治疗可能导致神经认知损害的风险(c级,IV)。
5.地塞米松是短期缓解疾病的姑息性治疗措施,但在活检之前应避免使用(C级,IV)。
6.全脑放疗(WBRT)是有效的姑息治疗手段,但对于十分适合化疗的患者而言,不作为一线治疗方案(B级,Ⅲ)。
7.在中枢神经系统淋巴瘤的治疗上,CHOP样的化疗方案没有作用(A级,lb)。
8.如果十分适合化疗,所有患者都应以化疗作为一线治疗手段。化疗方案应包括大剂量氨甲蝶呤(HD—MTX),3~5次,每次剂量至少≥3g/m

,2~3小时内输完,每次间隔不超过2~3周。HD—MTX与能透过血脑屏障的药物(如阿糖胞苷)联用可能会提高疗效,但这样的治疗应以现有的方案为基础,最好能够进入临床试验(B级,Ⅱa)。
9.对于通过以MTX为基础的化疗获得完全缓解的患者应考虑WBRT巩固治疗,对于60岁以下的患者也应提供WBRT,除非存在化疗后明显的神经认知障碍。对60岁或60岁以上的患者,神经认知障碍的弊有可能超过WBRT巩固治疗的利(B级,Ⅱa)。
10.目前尚无证据支持在大剂量静脉MTX的基础上加上鞘内化疗对PCNSI.治疗的作用(B级,Ⅲ)。
11.以大剂量化疗为一线方案联合自体干细胞移植仍然处于试验中,不应在临床试验以外的情况下实施(B级,m)。
12.除临床试验以外,通过鞘内或者脑室使用利妥昔单抗不应作为治疗PCNSL的常规手段(B级,m)。
13.除临床试验外,药物破坏血脑屏障不应作为PCNSL治疗的组成部分(B级,11b)。
14.对于之前没有接受过WBRT的复发或难治患者,应进行拯救性放疗。地塞米松可作为短期的对症姑息治疗。其他的化疗方案,如替莫唑胺或者大剂量的化疗,联合自体干细胞移植显示出了一些希望,但还需要进一步的临床试验来评价(B级,Ⅲ)。
15.同时发生眼内和中枢神经系统淋巴瘤者应该给予以HD-MTX为基础的系统化疗,再予以双侧眼球照射,如果患者年龄小于60岁且有条件,还应给予全脑放疗。对孤立的眼内病变处理方法也相同。对局限于眼内复发的患者,玻璃体内注射MTX是一个有效的可选用的治疗措施(B级,m)。
问题 1214
现病史:
患者, 女性,39岁, 主诉“双眼视物模糊1月余,右眼前黑影飘动10日”。1月余前无明显诱因下出现双眼视物模糊, 偶有飞蚊症,无眼红、眼痛、畏光、流泪等不适, 无眼部分泌物,无虹视、雾视, 无眼眶痛等不适。8天前曾于当地医院就诊,外院B超提示双眼玻璃体点状回声, 眼前节检查及眼底检查无殊,诊断为“双眼玻璃体混浊”, 予氨碘肽眼水tid点眼一周,未见明显好转, 右眼前黑影飘动感有加重,今为求进一步诊治来我院门诊。
既往史:
系统回顾:无殊
家族史: 父亲有糖尿病,否认其他家族性遗传性疾病史。
用药史: 眼部用药见现病史,否认特殊全身用药史
外伤手术史: 10年前剖腹产手术史,6月前摔伤史, 但未碰及眼部及眼周部。
追问外伤史,诉摔倒时碰坏三颗门牙, 有牙医诊所拔牙和植牙史
过敏史:否认.
查体:
1)初诊眼科专科检查如表38-1所示。






2)12天后随访眼科专科检查如表38-2所示。






辅助检查:
1)眼部B超: 右眼玻璃体前中段中-大量点状回声,左眼玻璃体中后段中-大量点状回声, 双眼玻璃体混浊可能,右眼玻璃体后脱离可能, 双眼视盘及后极网膜水肿可能。
2)结核菌素纯蛋白衍化物(PPD)检查:阴性。
3)胸部X线: 未见明显异常。
4)血管紧张素酶(ACE):阴性。
5)人类白细胞抗原HLA-B27: 阴性。
6)快速血浆反应素(RPR):阴性。
7)性病研究实验室(VDRL)实验: 阴性。
8)荧光螺旋体吸收试验(FTA-ABS):阴性。
9)人免疫缺陷病毒(HIV): 阴性。
10)血培养:细菌(-), 真菌(-)。
【问题1】
该患者的诊断及诊断依据
【问题2】
还需要与哪些疾病相鉴别?
【问题3】
该患者的处理方案及基本原则
答案:
1.诊断和诊断依据
(1)双眼发病,右眼为主,病程约一月余,属于渐进性发展。
(2)全身情况良好,仅有外伤,拔牙、植牙病史,有全身内源性感染发展至眼部可能。
(3)结膜无充血,前房无丁达尔现象,前房无炎症细胞,玻璃体炎症,见玻璃体细胞,标志性雪球样团块状玻璃体混浊,视网膜见灰白色病灶,病灶形态似由脉络膜突破至视网膜,故考虑后葡萄膜炎中的内源性真菌性感染。
(4)辅助检查显示HLA-B27阴性,梅毒、结核、结节病等疾病未见阳性指标,血培养亦为阴性。
基于以上几点分析:可经验性诊断为内源性真菌性眼内炎。金标准为玻璃体培养,本例培养结果为白色念珠菌。
2.鉴别诊断
(1)症状的鉴别诊断。
①渐进性无痛性视力障碍(病程历时数周、数月甚至数年):常见于白内障、屈光不正、开角型青光眼、慢性视网膜病变如年龄相关性黄斑变性和糖尿病视网膜病变;较常见于慢性角膜病变如角膜营养不良、中枢神经系统肿瘤所致的视神经病变,或视神经萎缩,等等;均需加以鉴别。
②眼前黑影飘动:一过性眼前黑影常见于偏头痛;持续存在的眼前黑影常见于玻璃体后脱离、后葡萄膜炎、玻璃体积血、玻璃体浓缩或碎片;较常见于视网膜裂孔或视网膜脱离、角膜混浊或角膜异物等等。均需加以鉴别。
(2)后葡萄膜炎的鉴别诊断。
后葡萄膜炎的主要症状为视物模糊、眼前黑影;如果合并前房炎症,可见眼红、眼痛和畏光。后葡萄膜炎伴有明显眼痛常提示有细菌性眼内炎或后巩膜炎。
1)在免疫功能障碍患者应考虑以下疾病:
①巨细胞病毒性视网膜炎:玻璃体反应轻度或无;视网膜白色坏死灶,伴出血,常沿血管分布,血管白鞘;多见于艾滋病患者。
②弓形体病:视网膜局限性黄白色病灶,伴有相邻的脉络膜视网膜瘢痕。玻璃体细胞和碎屑,玻璃体炎症明显,无玻璃体脓肿和“棉花球”样改变。
③肺囊虫性脉络膜病变:广泛播散性卡氏肺囊虫感染的罕见临床表现。通常见于艾滋病患者,通常无症状,患者有卡氏肺囊虫感染史和使用戊烷眯气雾剂治疗史。临床表现为多灶性、黄色、圆形的深层脉络膜病变,大约1/2~2个视盘直径大小,位于后级部,无玻璃体炎,患者通常病情很重,全身状况很差。
④其他:如单纯疱疹病毒感染,胞内鸟型分枝杆菌(MAI)感染,诺卡氏菌感染,曲真菌感染,隐球菌感染,球孢子菌病。
2)免疫功能相对正常患者亦需鉴别以下疾病:
①全葡萄膜炎
结节病:静脉周围血管鞘和黄色蜡滴状渗出,肉芽肿性羊脂状KP、虹膜结节、玻璃体“雪堤样”和“雪球状”改变;
梅毒:急性脉络膜视网膜炎和玻璃体炎;手掌或/和足底皮肤斑丘疹;晚期出现视网膜色素堆积,有时类似于视网膜色素变性;可与视网膜血管阻塞性疾病有关;先天性梅毒患者可出现典型的椒盐样眼底;螺旋体抗体吸附荧光测定(FTA-ABS)阳性;
Vogt-小柳-原田综合征:浆液性视网膜脱离伴玻璃体细胞、视盘水肿;或视网膜色素上皮萎缩斑伴前房炎症。多发生于色素较重的人种,如亚洲人和美洲土著。伴有或继发全身性病变包括脑膜刺激征、白癜风、脱发和白发。原田病表现为后级部及神经受累;
Behcet病:前葡萄膜炎表现明显,见于年轻患者,可见前房积脓、虹膜炎、口腔溃疡、生殖器溃疡、结节性红斑、视网膜血管炎(动脉性和/或静脉性)和视网膜出血,可反复发作;
晶状体过敏性眼内炎:由于损伤了晶状体囊膜,造成严重的前房反应和葡萄膜炎反应,可继发青光眼,常见外伤或手术后,对侧眼不受累;
交感性眼炎:双眼肉芽肿性葡萄膜炎,有一侧眼穿通伤史或内眼手术史,通常是在发病前4-8周,但时间范围可以是5天-66年内,大部分发生于1年之内;双眼严重的前房反应伴粗大的羊脂状KP,视网膜色素上皮层小的脱色素结节(Dalen-Fuchs结节),葡萄膜增厚;
结核:产生的临床表现各异。确诊通常依赖于实验室检查。粟粒型结核可产生多灶性、小的、黄白色的脉络膜病变。大多数患者伴发肉芽肿性或非肉芽肿性前葡萄膜炎。
②手术后或外伤性眼内炎症:
表现各异,多有明确眼部手术史或眼部外伤史。
③脉络膜炎
匐行性脉络膜病变:患者年龄多在30-60岁;典型表现为双侧反复发作的脉络膜视网膜炎,特征是急性病变(视网膜下边界模糊的黄白色斑片)包绕陈旧性萎缩性瘢痕;脉络膜视网膜病变通常由视盘开始向外蔓延,而1/3的病例的病变首先出现在周边部;可出现脉络膜新生血管。强烈建议全身使用免疫抑制剂;
急性后部多灶性盾鳞状色素上皮病变(AMPPE):年轻患者,急性视力丧失,通常继发于病毒感染。双眼多灶性、黄白色、奶油状的斑片状视网膜下病变,眼底荧光血管造影早期病变呈现遮蔽荧光,晚期荧光着染;
多灶性脉络膜炎:患有近视的年轻女性出现视力丧失,通常双眼受累。视网膜色素上皮层和脉络膜毛细血管层多灶性、小圆形、灰白色炎性病灶(与组织胞质菌病相似)。与组织胞质菌病不同的是,98%的患者可见玻璃体炎。病变主要位于黄斑区,口服或球周注射类固醇有效,但易复发。常见脉络膜新生血管。告知患者如果出现视力下降应尽快就诊;
鸟枪弹样视网膜脉络膜病变:常见于中年人,双侧视网膜深层出现多发的乳黄色斑点,直径约1mm,散在分布于全眼底,玻璃体细胞多余房水细胞;可有视网膜和/或视神经水肿;约90%的患者HLA-A27阳性,可考虑全身使用免疫抑制剂;
眼弓蛔虫病:多见于儿童,单眼发病。最常见黄斑区肉芽肿(隆起的白色视网膜或视网膜下病变),伴视力低下。单侧睫状体平坦部炎伴有周边部肉芽肿或眼内炎,周边部肉芽肿与延伸至视盘的纤维带相连,有时纤维带的牵拉可使黄斑区血管移位;可有严重的玻璃体炎和前葡萄膜炎。如果免疫力低下患者的未经稀释的弓蛔虫滴度为阴性,通常可排除本病;
眼拟组织胞质菌病综合征(POHS):常见于气候温和地区(如俄亥俄-密西西比河流域),可见凿除状脉络膜视网膜瘢痕,直径小于1mm,视盘周边部萎缩,常见脉络膜新生血管,无玻璃体细胞。
④视网膜炎:
多发性短暂性白点综合征(MEWDS):闪光感,急性单侧视力丧失,常继发于病毒感染,常见于年轻女性,偶有双眼同时或相继发病,视网膜深层或色素上皮层多发性、小的乳白色病灶,伴有黄斑中心凹颗粒和玻璃体细胞;视野检查常见生理盲点扩大,可有闪烁暗点。无需治疗,数周内视力恢复正常;
急性视网膜坏死(ARN):常表现为急性虹膜睫状体炎,单眼或双眼周边部白色片状增厚的坏死视网膜伴血管鞘,严重的玻璃体炎。
进展性外层视网膜坏死(PORN):临床表现与急性视网膜坏死相似,但可无玻璃体细胞,常见于免疫力低下患者。
念珠菌感染:见于长期接受抗生素治疗的住院患者,经静脉吸毒者以及长期留置导尿管、留置针的患者。当然也可见于相对正常患者,见本病例以上讨论。早期散在的玻璃膜疣样脉络膜病变进展为黄白色绒状的视网膜或视网膜前病变,随后,玻璃体内出现棉花团样改变。血样、尿样和静脉注射部位可能培养出念珠菌。
⑤视网膜血管炎
静脉周围炎:结节病,梅毒,睫状体平坦部炎、镰状细胞视网膜病变、Eales病、Behcet病、Crohn病
动脉炎:巨细胞性动脉炎、结节性多动脉炎、急性视网膜坏死、Behcet病、系统性红斑狼疮、IRVAN(特发性视网膜血管炎、动脉瘤和神经视网膜炎)
⑥后葡萄膜炎的其他感染性病因:
猫抓病:单侧发病,黄斑区星芒状渗出,视神经水肿,玻璃体细胞,血清巴尔通体(Bartonella)阳性;
弥漫性单侧亚急性神经视网膜炎(DUSN)好发于儿童和青少年,表现为单侧视力丧失,是由线虫感染引起。早期视神经水肿、玻璃体细胞、深灰白色视网膜病变,后期发展为视神经萎缩、视网膜血管变窄、色素上皮萎缩。视力、视野和视网膜电图随时间进展进一步恶化,治疗可采用激光光凝线虫;
莱姆病:常见于新英格兰、大西洋中部各州,特别是户外露营者;蜱咬史;表现为各种形式的后葡萄膜炎,皮疹,Bell麻痹(面神经麻痹),而关节炎常被忽视;
其他:诺卡氏菌、球孢子菌、曲真菌、隐球菌、脑膜炎球菌、盘尾丝虫病、囊虫(多发于非洲和中南美洲)等。
(3)玻璃体细胞的其他致病原因:
(1)眼缺血;
(2)前葡萄膜炎向眼后节的扩散;
(3)伪装综合征:多种疾病可以引起,常累及老年患者或年幼患者,需警惕眼部的恶性肿瘤;
(4)大细胞淋巴瘤:中老年多见,玻璃体细胞持续存在,全身应用类固醇治疗完全无效,其他表现有视网膜下黄白色渗出、视网膜水肿和出血、前房炎症或神经系统病变;
(5)恶性黑色素瘤:视网膜脱离和玻璃体炎常掩盖其下方的肿瘤,使之模糊不清,间接检眼镜漏诊的病例,B超和MRI可以协助诊断;
(6)视网膜色素变性:玻璃体细胞和黄斑水肿,可伴有视盘蜡样苍白,骨细胞样色素沉着,视网膜血管变细,视盘玻璃膜疣可被误诊为视盘水肿,视网膜电流图(ERG)有助于诊断;
(7)孔源性视网膜脱离(RRD):常伴有前玻璃体少量的色素细胞和前房细胞;
(8)眼内异物残留:眼球穿孔伤后炎症持续存在,或有虹膜异色。部分患者并无明确眼部外伤史,查体可见眼球穿通伤的陈旧性伤道;可以通过间接检眼镜、前房角镜、B超、超声生物显微镜检查(UBM)、眼部CT做出诊断;
(9)视网膜母细胞瘤:几乎均发生于幼儿,可见假性前房积脓和玻璃体细胞;常见一处或多处视网膜白色隆起,有时无,视网膜脱离和/或虹膜新生血管,眼底荧光血管造影、CT和B超有助于诊断;
(10)白血病:患者可有单侧的视网膜炎和玻璃体炎,可有典型的视网膜Roth斑;
(11)淀粉样变性:少见,晶状体后踏板样沉积物,玻璃体内可见水珠样或膜样改变,无眼前节炎症,血清蛋白电泳和诊断性玻切术可以确诊;
(12)星状玻璃体变性:小的、白色的反光颗粒(钙沉积物)粘附在胶原纤维上,在玻璃体内漂浮,通常无症状,无临床意义;
(13)后巩膜炎:伴或不伴有前巩膜炎;玻璃体炎伴有视网膜下斑块、视网膜增厚,有时有渗出性视网膜脱离;可见脉络膜视网膜皱折;眼底荧光血管造影、B超(显示T征)有助于诊断。
3.处理方案及基本原则
本病治疗的基本原则是及时正确的诊断、早期玻璃体手术联合眼内抗真菌药物注射以及全身抗真菌治疗:
(1)及时正确的诊断:早期的临床经验性诊断尤其重要,对于高度疑似的病例,尽早进行玻璃体手术以及抗真菌的治疗,可以极大程度地挽救患者的视功能。
(2)玻璃体手术联合眼内抗真菌药物注射:手术的目的是取标本进行培养以及清除有炎症的玻璃体。玻璃体内注射二性霉素B通常用于治疗早期内源性真菌性眼内炎,少数对二性霉素耐药的真菌可使用玻璃体内可注射伏立康唑。由于二性霉素B穿透力差,且会引起结膜坏死,故不主张球旁注射。全身可使用毒性较低的咪唑类复合物如氟康唑。
(3)全身抗真菌药物的使用:建议及时、有效的抗真菌药物口服,如伏立康唑、伊曲康唑。
(4)眼局部滴用睫状肌麻痹剂:对于前房反应和玻璃体炎症严重,以及术后患者可使用,如1%阿托品眼液,一天3次。
(5)念珠菌感染患者禁用类固醇类:必要时可在全身抗真菌的同时,适当眼局部使用类固醇激素以减轻术后炎症反应。
(6)必要时眼压控制:药物降眼压。
问题 1215
现病史:
患者, 男性,7岁, 主诉“双眼视力差,夜间视物不清2年”。2年前家长发现患儿双眼视力差, 夜间视物不清,无眼红、眼痛, 无眼胀,无脓性分泌物等不适, 曾于当地医院就诊,未行特殊治疗, 于2012-7-20为求进一步诊治来我院门诊。
既往史:
运动系统: 出生后15月龄时(2007-12-2)发现左髂骨肿块,手术活检提示朗格汉斯组织细胞增生症1型(骨嗜酸性肉芽肿), 予(VCR/VBL/6-TG/MTX)化疗,发病前三个月, 每半月住院化疗,之后每月门诊进行化疗, 化疗第三个月植入化疗泵后,静滴改为泵入, 一年后停止化疗。停止化疗后2个月,发现右耳前肿块, 穿刺活检后证实LCH复发,继前化疗方案治疗, 每月门诊化疗,一年后停止化疗。之后, 患儿门诊随诊,三年来LCH未复发, 2012-12取出化疗泵。5岁时其父母发现患儿视力差,外院就诊, 前置镜检查发现其视网膜后极部点状病灶,推荐来我院就诊。
家族史: 无家族史。
用药史:眼部用药见现病史, 否认全身用药
外伤史:否认
过敏史: 否认
查体:
眼科专科检查如表39-1所示。




辅助检查:
OCT(2012-7-31,本院): 双眼后极视网膜各层高反射点,IS/OS和ELM消失, RPE较毛糙。(见图39-3和图39-4)


FFA(2013-7-31,本院): 双眼视网膜动静脉充盈时间正常范围,视网膜后极和中周荧光轻度渗漏, 视乳头荧光渗漏,边界模糊——考虑“双眼葡萄膜炎? ”(见图39-5)

静态视野(2013-7-31,本院): 右眼颞下方视野缺损,左眼下方视野缺损。(见图39-6)

动态视野(2013-7-31, 本院):右眼颞下方视野缺损, 左眼下方视野缺损。(见图9-7)

F-ERG(2013-7-31,本院): 双眼峰时延迟,杆反应未引出波形, 余反应残留微弱波形,振幅重度下降。
颅、眼眶MR增强(2012-8-2, 外院):双侧眼球形态大小对称, 未见异常信号影,球后软组织未见增大, 视神经未见明显异常,增强扫描未见明显异常强化灶, 所见诸脑室、脑池未见明显异常,脑沟未见明显增宽, 中线结构居中。
实验室及影像学检查或特殊检查:
葡萄膜炎全套: IgA 74.4 mg/dL (-);IgG 686.10 mg/dL(升高); IgM 78.10 mg/dL(-);血管紧张素酶 57.00 u/L(-); C3c 110.50 mg/dL(-);C4 21.10 mg/dL(-); 超敏C反应蛋白 2.119 mg/L(-);抗‘O’ <200 IU/ml(-); 类风湿因子 <30 IU/ml(-);抗HIV1/2(-); TPPA (–);RPR (–); 抗血管内皮细胞抗体 1:100(+); ENA谱(-)
结核感染T细胞检测:阴性。
胸部X线: 未见明显异常。
【问题1】
该患者的诊断及诊断依据
【问题2】
还需要与哪些疾病相鉴别?
【问题3】
该患者的处理方案及基本原则
答案:
1.诊断和诊断依据
(1)双眼视力差,夜间尤著。
(2)辅助检查显示目前患儿眼部疾病类似于视网膜色素变性。
(3)葡萄膜炎全套+结核,无明显有意义的阳性指标,排除感染性疾病的可能。
(4)确诊为朗格汉斯组织细胞增生症1型(骨嗜酸性肉芽肿),接受过2次各长达1年的化疗。
(5)头颅、眼眶MR增强显示:均无眼内肿瘤转移的病灶。(6)通过文献检索:目前尚没有文献表明患儿所使用的化疗药物有明显的视网膜毒性。据报道VCR(长春新碱)、VBL(长春花碱)和6-TG(6-硫代鸟嘌呤),多表现为血液系统毒性。MTX(甲氨蝶呤),多表现为胃肠道反应、骨髓抑制。
基于上述几点,患者最有可能为原发肿瘤诱导的自身免疫相关的视网膜病变和视神经水肿,即副肿瘤综合征(paraneoplastic syndrome, PNS)的一种。
2.鉴别诊断
(1))葡萄膜炎的鉴别诊断:分为感染性和非感染性两大类,首先需排除感染性的指标,该患儿的葡萄膜炎全套均未阴性。
①强制性脊柱炎:年轻男性,腰背部疼痛,也有可能无全身症状,HLA-B27阳性,30%会发生前葡萄膜炎。
②莱特综合征:年轻男性,关节炎、尿道炎(80%)和结膜炎(合并虹膜炎),血沉ESR升高。
③炎症性肠病:包括克罗恩病和溃疡性结肠炎。多双眼发病。慢性间歇性腹泻,伴有便秘。克罗恩继发前葡萄膜炎少见(2.4%),溃疡性结肠炎相对较多(5%~10%)。
④白塞氏病:年轻人,有前房积脓,合并口腔溃疡和生殖器溃疡三联症。
⑤弓形虫病性葡萄膜炎:单眼常见局灶黄白色坏死灶,伴有玻璃体炎。
⑥结节病:肉芽肿型KP,弥漫玻璃体炎或下方棉花球样玻璃体炎症,黄白色渗出,静脉周围白鞘。
⑦梅毒性葡萄膜炎:多灶脉络膜视网膜炎,玻璃体炎。梅毒检测阳性。
⑧巨细胞病毒感染:视网膜白色坏死灶,伴出血,血管白鞘,多见于HIV。
(2)伪装综合征的鉴别诊断:是一种表现与葡萄膜炎相似的疾病,分为肿瘤性和非肿瘤性两大类,需全身筛查,避免遗漏一些严重的肿瘤性疾病。
①视网膜色素变性:可以有玻璃体细胞,甚至黄斑囊样水肿,可以有家族史。
②眼缺血综合征:由于缺血致低灌注压,组织缺血,细胞坏死而引起炎症反应。表现为视力下降,可偶有眼痛,FFA可帮助诊断。
③Schwartz综合征:孔源性视网膜脱离后脱离的视网膜外节碎片经过后房进入房水循环阻塞小梁网而引起眼压升高。眼底表现和视网膜复位后,炎症消失为其特点。
④色素播散综合征:是虹膜或者睫状体的色素释放进入前房,呈颗粒状浮游,容易和前葡萄膜炎混淆。色素颗粒可以沉积于角膜内皮、小梁网、晶状体后表面、悬韧带和前玻璃体。该病多发生于白人,男性,高度近视者。
(3)副瘤综合征的鉴别诊断:在某些恶性肿瘤或潜在恶性肿瘤患者体内,肿瘤未转移的情况下,肿瘤细胞产生与释放生理活性物质,引起其他远隔部位、器官功能的异常改变,又称为恶性肿瘤的远达效应。任何组织结构均有可能成为PNS累及的部位,眼部也不例外。癌症相关性视网膜病变(cancer associated retinopathy,CAR):以无痛性、进行性视力下降、闪光感、视野环形暗点和瞳孔对光反射迟钝为主要表现。眼底表现多为正常或轻度异常,比较典型的改变是视网膜小动脉变细,并随病程的延长而加重,视网膜电图(ERG)表现为波幅低平,病理改变主要是光感受器严重变性或丧失,与本病例表现最相似。其他类型包括:
①副肿瘤性视神经病变(paraneoplastic optic neuropathy,PON):视乳头可呈腊黄样改变,视网膜动脉变细。ERG可以正常,VEP未能引出正常波形。视力通常在数天或者数周迅速下降,甚至丧失。
②黑色素瘤相关性视网膜病变(melanoma-associated retinopathy,MAR):眼底最初正常,发病一段时间后视网膜色素上皮出现色素增生和脱失,视网膜小动脉变细,视盘苍白,也有视网膜血管炎以及玻璃体炎的报道。临床表现为闪光,夜盲,轻度周边视野异常,ERG显示类似于视网膜色素变性样改变,即明适应相对正常而暗适应b波显著减少或熄灭,震荡电位缺失或降低。
③双眼弥漫性葡萄膜黑色素细胞增生(bilateral diffuse uveal melanocytic proliferation,BDUMP):表现为视力下降、白内障、多发的色素性或非色素性鳞状虹膜和脉络膜结节,甚至出现渗出性视网膜脱离。
3.处理方案及基本原则
针对CAR的自身免疫发病机制,利用免疫抑制剂或降低自身抗体滴度疗法有一定的疗效。目前已有数种疗法报道。
(1)糖皮质激素:全身使用糖皮质激素以发挥免疫抑制作用。但是免疫抑制治疗有加快肿瘤转移的风险,因此治疗的方向是低剂量和脉冲疗法,或采取球后注射局部用药,以尽量减少治疗的不良反应,其合适的使用剂量仍在探索中。
(2)血浆过滤疗法:以降低循环中自身抗体为目的,但对患者视力预后无影响。
(3)免疫球蛋白:有个案报道利用静脉阻塞免疫球蛋白治疗CAR,患者视力提高。但其机制尚不明确,缺乏说服力。
(4)免疫调节剂:有研究利用TolpaTorf制剂(TTP)治疗CAR患者,发现TTP能明显降低抗恢复蛋白抗体水平,同时具有免疫增强和免疫抑制的双向作用,可能对抑制光感受器的进一步损害起作用,但是对已经造成的视力丧失,无明显的改善效果。
(5)针对恶性肿瘤的放射或化学药物治疗:单纯实施治疗恶性肿瘤的全身放射或化学药物治疗措施,对于CAR患者预后并无改善。在切除肿瘤及放射或化学药物治疗后,视力仍进行性恶化,推测可能是自身抗体继续造成视网膜细胞的凋亡。
问题 1216
现病史:
患者, 女性,45岁, 主诉“左眼视力下降4月”。4月前无明显诱因下出现左眼视力下降,不伴眼红, 眼痛,畏光流泪, 无分泌物增多,虹视, 眶周痛等不适。为进一步诊治来我院门诊。
既往史:
系统性疾病史: 否认
外伤手术史:否认
过敏史: 否认
家族史:否认
用药史: 否认眼部及全身用药史
查体:
眼科专科检查如表40-1所示。




辅助检查:
血管紧张素转换酶(ACE):阴性
结核菌素纯蛋白衍化物(PPD)检查: 阴性
胸片:未见明显异常
快速血浆反应素(RPR): 阴性
性病研究实验室(VDRL)实验:阴性
犬弓蛔虫抗体检查: 阴性
弓形体抗体检查:阴性
疱疹病毒检查(HSV, VZV):阴性
HIV抗体检查: 阴性
B超检查:左眼下方高回声占位, 如图40-3所示。

荧光血管造影:早期可见肿物处血管充盈, 随时间,荧光逐渐增强, 局部伴出血荧光遮蔽,晚期可见血管渗漏, 伴周围网膜下渗出性改变,如图40-4所示。

【问题1】
该患者的诊断及诊断依据
【问题2】
还需要与哪些疾病相鉴别?
【问题3】
该患者的处理方案及基本原则
答案:
1.诊断和诊断依据
结合患者症状,病史,眼部专科检查及辅助检查,做出诊断。
(1)左眼视力下降4月。
(2)玻璃体细胞(+)~(++)。
(3)视网膜前增殖。
(4)周边、孤立视网膜血管性肿物伴出血、渗出。
(5)回顾病史:无系统性疾病及眼部疾病史。
(6)实验室检查:
血管紧张素转换酶(ACE):阴性。
结核菌素纯蛋白衍化物(PPD)检查:阴性。
胸片:未见明显异常。
快速血浆反应素(RPR):阴性。
性病研究实验室(VDRL)实验:阴性。
犬弓蛔虫抗体检查:阴性。
弓形体抗体检查:阴性。
疱疹病毒检查(HSV,VZV):阴性。
HIV抗体检查:阴性,排除感染及免疫性疾病的存在。
(7)B超检查示左眼内高回声实质性占位。
(8)荧光血管造影示肿块早期血管充盈,随时间延长,荧光增强,晚期渗漏。
基于以上几点综合分析,诊断为视网膜血管增生性肿瘤(VPT)。
2.鉴别诊断
(1)视网膜毛细血管瘤(von Hippel):常见于中青年,多位于周边视网膜,但也可位于眼底的任何部位。可伴有视网膜内及视网膜下渗出,渗出性视网膜脱离。有显著扩张迂曲的滋养动脉和回流静脉,这是该疾病与视网膜血管增生性肿瘤最主要的鉴别要点。B超显示实质性包块,荧光血管造影显示瘤体呈现高荧光,晚期有荧光素的渗漏。Von Hippel-Lindau(VHL)病除了有眼部血管瘤以外,伴有皮肤、神经系统等全身肿瘤的改变,可有阳性家族史。
(2)无色素性脉络膜黑色素瘤:脉络膜来源的占位,典型的肿瘤呈现蘑菇样外观,病变区可有橙色色素沉着,同时可伴有渗出性视网膜脱离。B超检查示中低度回声的肿块,有脉络膜挖空征。荧光血管造影(FFA)结合吲哚青绿血管造影(ICG)有助于协助诊断。典型的病例核磁共振检查表现为TI加权高信号,T2加权低信号。若无法确诊,可通过组织活检最终证实。
(3)周边出血渗出性脉络膜病变(PHEC):该病发病年龄更大,肿瘤位于视网膜下,颜色比较深,表面有色素性改变,荧光血管造影显示:没有视网膜血管与肿瘤血管的沟通,可以此与视网膜血管增生性肿瘤相鉴别。
(4)结节病:累及多系统的肉芽肿样病变,以胸腔内脏器受累为特征,眼部受累者很常见。眼部病变包括眼前节病变,如前葡萄膜炎(急性虹膜睫状体炎,慢性肉芽肿性葡萄膜炎),结膜结节,巩膜结节,虹膜结节等,后段病变有玻璃体炎症(典型的为雪球样),脉络膜视网膜结节,静脉周围炎,脉络膜炎,视乳头肉芽肿等。结节性病灶多表现为黄白色炎性肉芽肿性病灶,相比视网膜血管增生性肿瘤,该肿物缺乏血管,视网膜的出血,渗出性改变也较VPT轻。结节病可通过相关实验室检查(血管紧张素转换酶,胸片,胸部CT确诊)。
(5)眼部结核病:可表现为慢性虹膜睫状体炎,玻璃体炎症,视网膜静脉周围炎,脉络膜炎,脉络膜视网膜结节等。可通过实验室检查,结核菌素试验或γ-干扰素释放试验(T-spot)检查)确诊。
(6)犬弓蛔虫病:多见于年轻患者,儿童常见,有小狗、小猫宠物接触史。典型表现为慢性眼内炎(玻璃体的致密炎症),后极部肉芽肿,周边肉芽肿(可有纤维条索从肉芽肿延伸至后极部或视乳头),视网膜内牵引条索可造成视网膜皱襞,牵引性或孔源性视网膜脱离。抽取眼内液(房水或玻璃体液)检测犬弓蛔虫抗体可以确诊。
(7)弓形体感染:最常见为累及内层视网膜的局灶性视网膜炎,表现为视网膜白色病灶,伴周围视网膜水肿,可以是局灶的玻璃体炎或全玻璃体炎。典型的眼内病灶是活动性病灶毗邻于一个陈旧的非活动性的瘢痕。可伴肉芽肿性前葡萄膜炎。可并发白内障,青光眼,虹膜后粘,黄斑囊样水肿,脉络膜新生血管等。局部抗体检测结合PCR分析眼内液体可以有效协助诊断眼弓形虫病。
(8)视网膜毛细血管扩张症(Coat’s):以视网膜毛细血管扩张及微血管瘤样形成,伴有视网膜内及网膜下渗出为特征的病变。主要累及青少年男性,单眼发病,典型的表现为富含脂质的黄色视网膜下渗出,伴有各种血管异常,包括血管迂曲,血管瘤样扩张,局部毛细血管扩张,有时伴有新生血管生成,可伴渗出性视网膜脱离。荧光血管造影表现为视网膜毛细血管扩张,微血管瘤,血管壁的串珠样变。
(9)视网膜星形胶质细胞错构瘤:是一种神经胶质起源的肿瘤,发病年龄更年轻,表现为灰色,半透明,结节样病变,可伴有钙化,多见于赤道后,少见出血,渗出性改变,以此可与视网膜血管增生性肿瘤鉴别。
(10)巨细胞病毒感染:多发生于免疫功能低下的人群,常见于患有获得性免疫缺陷综合征(AIDS)的人群,也见于接受器官移植者和其他接受免疫抑制剂治疗者。病灶常累及血管,表现为白色视网膜病灶,常伴有中度至重度的出血,视网膜水肿,可表现出轻度的玻璃体和前房的炎症反应。可伴孔源性视网膜脱离等并发症。取眼内液标本(房水或玻璃体)行病毒PCR检测可以确诊。
(11)急性视网膜坏死:由疱疹病毒感染引起。可见玻璃体混浊,坏死性视网膜炎,可伴浅层巩膜炎,巩膜炎,前段肉芽肿性葡萄膜炎。视网膜炎表现为深层的多灶性黄白色坏死灶,首先出现在周边部视网膜,向心性融合,并向后极部发展,视网膜病变同时伴有活动性的血管炎,表现为血管周围出血,血管鞘,终末细动脉的闭塞。活动性炎症期可伴有渗出性视网膜脱离,起病后1-2月可出现孔源性视网膜脱离。取眼内液标本(房水或玻璃体)行病毒PCR检测可以确诊。
3.处理方案及基本原则
根据肿瘤的部位、厚度及并发症综合考虑,选择合适的治疗方案。
若患者无主观症状,病灶较小,黄斑未累及,无网膜下液,无渗出(或局限性没有进展),可密切随访观察。
若患者已出现视力下降的症状,可采用以下治疗方法:
(1)冷凝:适用于厚度小于2mm的肿瘤。可联合抗VEGF药物、曲安耐德(TA)玻璃体腔注射以减轻冷凝后的炎症反应。据报道,行冷冻治疗3月后,黄斑前膜可消退。但冷凝也存在持续的黄斑水肿,渗出,继发视网膜前膜等并发症。
(2)光凝:适用于厚度较小,渗出较少的肿瘤。若肿瘤较厚,或渗出较多甚至出现渗出性视网膜脱离,激光则无法有效实施。
(3)光动力疗法(PDT):主要适用于2.03-4.45mm厚度的肿瘤,经治疗后,可使肿瘤缩小,视网膜下渗出消退,视力得到提高。可联合玻璃体腔注射激素以减轻治疗后的炎症反应。但局限性在于视网膜血管增生性肿瘤往往位于周边视网膜,光动力疗法无法达到该部位。
(4)经瞳孔温热疗法(TTT):少量报道显示该方法可使肿瘤缩小,视网膜下渗出消退,视力得到提高。
(5)局部敷贴放疗:106Ru\iodineI125局部放射治疗:适用于病灶较大(厚度大于2.5mm)伴视网膜脱离的肿瘤及其他疗法无效者,106Ru\iodineI125治疗后视力稳定或提高的比例分别达57%和73%,肿瘤消退率分别达88%和97%。放射性治疗的不良反应可有干眼,白内障,放射性视网膜病变,放射性视神经病变,新生血管性青光眼等,但国外研究显示,治疗过程中并未发现放射性并发症的发生,学者认为可能与肿瘤的周边性有关。
(6)玻璃体手术治疗:对于伴有玻璃体积血及广泛视网膜前增殖的病例可采用玻璃体手术治疗,术中针对病灶部位进行光凝或冷凝处理。
(7)抗VEGF药物治疗:长期疗效不确定。针对视网膜血管增生性肿瘤并发的黄斑水肿有效,可提高视力,也可使渗出减少或消退,但肿瘤不一定缩小。也有报道显示,虽然肿瘤缩小,但视力不一定提高。因此目前不推荐单独使用抗VEGF药物治疗视网膜血管增生性肿瘤,主张将其作为辅助疗法,联合冷凝,光凝,玻璃体手术等其他治疗应用。
(8)外科切除:有报道采用经巩膜局部切除病灶,或玻璃体手术局部切除病灶联合气体或硅油填充进行治疗,但目前此法未被普遍采用,仅为少量报道。
问题 1217
患者,女性, 22岁,主诉“发现双眼前暗影半年余”。半年余前无明显诱因下出现双眼前暗影, 无眼红、眼痛,无虹视、雾视, 否认视物变形及色觉异常。既往无类似病史。发现一周时至外院就诊,查OCT(图41-1): “视网膜变薄,余未见明显异常”, 中心视野(图41-2):“双眼视野似有颞侧偏盲改变, 普遍视敏度下降”。予蝶鞍摄片:“蝶鞍大小、形态及骨质未见明显异常, 蝶鞍区未见异常钙化”,头颅MRI: “颅脑MR平扫+增强未见明确异常改变”,FFA(图41-3): “未见明显异常”。予强的松40mgqd2周治疗,未见明显好转, 患者为求进一步诊治至我院门诊。



既往史:
否认全身疾病史。
用药史: 否认眼部及全身用药史。
个人史:足月顺产, 否认疫水毒物接触史。
家族史:否认父母近亲结婚, 否认家族性遗传疾病史。
外伤手术史:否认。
过敏史: 否认。
查体:
眼科专科检查如表41-1所示。



辅助检查:
中心视野(图41-5),周边视野(图41-6): 双眼中心暗区,正常30°。



OCT(图41-7): 黄斑中心凹旁椭圆体带缺失。

自发荧光(图41-8):黄斑中心凹旁低荧光, 向外呈现以中心凹为中心的高荧光环,环外弥漫性低荧光。

ERG(图41-9): 五项标准反应:杆反应振幅轻度降低, 余反应振幅中-重度降低伴明视潜伏期延迟。

mf-ERG(图41-10):双眼后极部弥漫性振幅降低, 伴轻度潜伏期延迟。

图形VEP(图41-11):右眼P1波峰时延迟, 振幅降低,波形宽大; 左眼P

波峰时轻度延迟,振幅降低, 波形宽大。

基因检测(图4-54):经对RHO基因第一、二、三、四、五外显子进行检测, 结果显示RHO基因70A>G处存在杂合突变。

【问题1】
该患者的诊断及诊断依据
【问题2】
还需要与哪些疾病相鉴别?
【问题3】
该患者的处理方案及基本原则
答案:
1.诊断和诊断依据
(1)双眼眼前暗影,发病半年,发展缓慢。
(2)无视物变形、色觉异常主诉,否认家族史。
(3)眼科检查仅见视网膜周边细小色素上皮改变,动脉略细。
(4)辅助检查显示视野双眼中心暗区。OCT示黄斑中心凹旁椭圆体带缺失,相应区域自发荧光减低。电生理振幅降低,潜伏期延长。
(5)基因检测显示RHO基因70A>G处存在杂合突变,为诊断的金标准。
基于以上几点分析:诊断为视网膜色素变性,因并无视网膜骨细胞样色素沉着的表现,故为罕见的无色素型。
2.鉴别诊断
(1)症状的鉴别诊断。
持续存在的眼前暗影:玻璃体后脱离、后葡萄膜炎、玻璃体积血、玻璃体浓缩或碎片、中心性视网膜脉络膜病变、黄斑变性或黄斑裂孔等黄斑部病变、视神经炎及球后视神经炎。
(2)视网膜色素变性的鉴别诊断。
视网膜色素变性的锥杆型变性应与视锥细胞营养不良相鉴别。锥杆型变性不仅累及视锥细胞,也同时累及视杆细胞,最终表现为广泛的视野丧失,暗适应阈值升高,ERG熄灭。视锥细胞营养不良主要累及视锥细胞,反映视杆细胞的外周视野,暗适应阈值及暗适应ERG均相对正常。
非双眼对称的、非进行性的色素性视网膜病变多见于继发性的眼底病,如病毒、梅毒、弓形体病引起的视网膜炎;并发于恶性肿瘤的视网膜病变;药物引起的视网膜病变;外伤及视网膜分支动脉阻塞后的视网膜改变。临床中应注意病史的采集,诊断困难时可以对患者的眼底及视功能作长期追踪观察。常见的需要鉴别的继发性视网膜色素变性如下:
①梅毒性脉络膜视网膜炎:双侧眼底改变,色素沉着和带黄色的斑点较原发性视网膜色素变性者为小,眼底极周边部都常受严重侵犯,夜盲不如本病明显,视野常无环形暗点,视乳头颜色较淡而不似蜡黄。ERGb波可有振幅降低,但不如本病严重降低至无法记录,梅毒血清反应阳性。
②妊娠期麻疹所致胎儿视网膜病变:罕见的幼儿眼底病变,始于胎儿期,因其母于妊娠第3个月患麻疹的影响。患儿出生后眼底病变逐渐发展。起初双眼有散在的点状色素沉着,其后出现典型的骨细胞样色素斑,ERG低下甚至消失。有时鉴别诊断困难。
③病毒所致热疹病后的视网膜色素变性:倾向于传染病全身症状出现后约1周或10日内,两眼视力突然降低,经过一段时间,视力进步,但不能恢复原来水平,视野向心性缩小,在几周到几年内,周边眼底出现色素沉着,甚至类似典型的原发性视网膜色素变性。
在继发性视网膜色素变性,色素沉着与视网膜血管常无关联,多不呈分支或骨细胞状而为点状、圆形或不规则形,并可有脉络膜视网膜萎缩的白色斑块和脉络膜血管硬化。
3.处理方案及基本原则
目前尚无疗效确切的治疗办法,然而应尽可能帮助患者提高视力,处理并发眼病。
(1)对无遗传病史的患者初诊时应行OCT、自发荧光、电生理、视野检查。此外尚需作除外梅毒的血清检验。临床有多指畸形,运动失调及听力困难等全身症状与体征,应建议作相应的实验室检查。另外可以利用ERG检查,早期确定患者家族成员是否患有此病。
(2)诊断确定后应嘱患者定期前来随诊。需每年复查眼底、OCT、视野等项目。合并黄斑囊样水肿者,可谨慎地应用轻能量的格子样激光光凝。
(3)当患眼视力下降至0.2或呈管视状态时可试以助视镜,并予以必要的训练。
(4)对并发白内障需要手术者术前需要重复视功能检查,以预测手术后的效果。人工晶体植入对保持中心视力,减少光学扭曲有益。
(5)药物治疗可长期服用叶黄素、维生素A、玉米黄质、神经营养因子、钙离子拮抗药、血管扩张药等,文献报道可延缓视网膜色素变性的发展。
(6)辅助治疗矫正屈光不正,使用遮光镜。
(7)基因治疗最新的研究利用腺伴随病毒作为载体,将转导基因注入视网膜下腔,可有效转染视杆细胞、视锥细胞和视网膜色素上皮细胞,为基因治疗视网膜色素变性展现出美好的前景。
问题 1218
患者,男性, 21岁,主诉“右眼视力下降2年, 加重4个月”。2年前无明显诱因下出现右眼视力下降,伴间歇性眼部酸胀感, 无脓性分泌物、无虹视等不适,曾于当地医院就诊(视野, 荧光血管造影,眼底OCT分别见图42-1, 42-2,42-3)诊为“右眼葡萄膜炎, 右眼青光眼,右眼视网膜脱离”, 予口服激素治疗(具体剂量不详),未见明显好转, 又转诊去北京某医院(专科检查见表42-1,眼前段及眼底照相见图42-4, 青光眼OCT见图42-5),诊为“右眼葡萄膜炎, 右眼开角型青光眼,右眼视网膜脱离”, 给予更昔洛韦眼用凝胶,od, qid;贝他根眼水, od,bid; 派立明眼水,od, bid;尼目克司, 0.5mg,po, bid,建议手术治疗, 患者未采纳,仍保守治疗, 4月前,右眼视力又突然下降, 今为求进一步诊治来我院门诊(专科检查见表42-2,眼底照相见图42-6)。
既往史:
全身疾病:否认
家族史: 否认。
用药史:眼部及全身用药见现病史。
外伤手术史: 10年前外伤史
过敏史:否认
查体:



辅助检查:
血沉(2014.4.9, 当地医院):阴性。
C反应蛋白(2014.4.9, 当地医院):阴性。
抗nRNP/Sm(2014.4.9, 当地医院):阴性。
抗Sm(2014.4.9, 当地医院):阴性。
抗PO(2014.4.9, 当地医院):阴性。
抗核小体抗体(2014.4.9, 当地医院):阴性。
抗组蛋白抗体(2014.4.9, 当地医院):阴性。
抗Ro52(2014.4.9, 当地医院):阴性。
抗SSA(2014.4.9, 当地医院):阳性。
抗SSB(2014.4.9, 当地医院):阴性。
抗ScL-70(2014.4.9, 当地医院):阴性。
抗Jo-1(2014.4.9, 当地医院):阴性。
抗PM-Sc1(2014.4.9, 当地医院):阴性。
抗PCNA(2014.4.9, 当地医院):阳性。
抗CENPB(2014.4.9, 当地医院):阴性。
AMAM2抗体(2014.4.9, 当地医院):阴性。
抗双链DNA测定(2014.4.9, 当地医院):阴性。
头颅MR(2014.4.9, 当地医院):未见明显异常。
胸部X线(2014.4.9, 当地医院):未见明显异常。
视野(2014.4.9, 当地医院):右眼中心视野基本丧失(见图42-1)。

荧光血管造影(2014.4.9, 当地医院):双眼未见明显血管渗漏及无灌注区(见图42-2)。

眼底OCT(2014.4.9, 当地医院):右眼鼻侧及上方视网膜脱离(见图42-3)

眼前节及眼底照相(2014.7.10, 北京某医院):右眼后极、鼻侧视网膜脱离(见图42-4)。

青光眼OCT(2014.8.27, 北京某医院):右眼各方位神经网膜厚度变薄, 由于乳头上方、鼻侧网脱,RNFL厚度受到干扰(见图42-5)。

眼底B超(2015.5.20, 我院):超声所见: 右眼玻璃体前中段少-中量点状回声。右眼后极、鼻侧、鼻下球壁前探及带状强回声,两端与球壁回声相连, 距离球壁0.5-1mm。左眼玻璃体前中段少+量点状回声。(见图24-6~图42-7)。


【问题1】
该患者的诊断及诊断依据
【问题2】
还需要与哪些疾病相鉴别?
【问题3】
该患者的处理方案及基本原则
答案:
1.诊断和诊断依据
(1)右眼视力下降2年,加重4个月,属于慢性,但有急性加重,后极、上方、鼻侧视网膜脱离,推测是原来的周边视网膜脱离累及黄斑所致。
(2)右眼部酸胀等主诉,眼压高,杯盘比大,但左眼正常,考虑右眼继发性青光眼可能性较大。
(3)结膜不充血,角膜色素性细小KP,无羊脂状KP,前房有丁达尔现象,但无虹膜后粘,玻璃体没有炎症,杯盘比大,不像典型的青睫综合征或前葡萄膜炎,属于前房反应范畴。
(4)辅助检查显示全身体检未见明显异常,视网膜脱离累及黄斑。
基于以上几点分析:初步诊断为右眼孔源性视网膜脱离,右眼继发性青光眼可能。
2.鉴别诊断
(1)症状的鉴别诊断。
①视力下降:原因较多,大概分为屈光不正、屈光介质浑浊、青光眼、玻璃体视网膜疾病、球后视路病、弱视、伪盲等几大类。
②眼痛:常见于青光眼发作、干眼症、睑缘炎、结膜炎、表层巩膜炎、发炎的胬肉、眼表异物、角膜疾病、隐形眼镜相关疾病、眼前段缺血综合征,等等。
(2)视网膜脱离的鉴别诊断。
①渗出性视网膜脱离:眼底表现为视网膜青灰色圆顶状隆起,表面光滑,脱离范围随体位变动而移动。常继发于原发性疾病,炎症性疾病和肿瘤是两大最主要的原因。
②牵引性视网膜脱离:眼底表现为视网膜呈帐篷样隆起,常继发于穿通性眼外伤或增值性玻璃体视网膜病变,如糖尿病视网膜病变、视网膜静脉周围炎、静脉阻塞等。
(3)青光眼的鉴别诊断:
①原发性开角型青光眼:常双眼发病,有特征性的视盘与视野改变。
②继发性开角型青光眼:a.青睫综合征:常可见羊脂状KP;b.Fuchs综合征:星状KP持久不变;虹膜异色,房角可有小血管;后极性白内障;c.其他前房有颗粒的继发性青光眼:色素性青光眼,剥脱综合征,血影细胞性青光眼等。
(4)葡萄膜炎的鉴别诊断。
典型的葡萄膜炎常伴睫状充血,瞳孔后粘,对激素反应良好。
3.处理方案及基本原则
本病治疗的基本原则是行视网膜复位术、消除病因。高眼压,前房反应在视网膜复位成功后,很快自行消失。
问题 1219
患者,男性, 5岁,主诉“发现双眼视物不清2年”。自患儿3岁时, 即发现患儿看电视时喜欢靠近电视屏幕,至当地医院检查治疗, 诊断双眼近视,约-4.00DS, 给予戴框架近视眼镜治疗。近两年来,发现视力仍逐渐下降, 上学前班时,老师多次反映患儿如坐在后则排看不清前面的黑板, 遂至我院诊治。
既往史:有近视戴镜史
家族史: 母亲双眼高度近视,约-18.00DS。右眼5年前发生黄斑出血, 行口服药物治疗,无明显好转。
用药史: 眼部用药见现病史,否认全身用药
过敏史: 否认
查体:
眼科专科检查如表43-1所示。


辅助检查:
①A超眼轴:右眼: 24.85mm,左眼: 24.51mm
②B超提示:双眼后极部巩膜葡萄肿。
【问题1】
还需要与哪些疾病相鉴别?
【问题2】
该患者的处理方案及基本原则
答案:
1.鉴别诊断
(1)单纯性近视:病理性近视需要与单纯性近视区别,如表43-2所示。



豹纹状眼底伴有常表现为后极部变性、萎缩、黄斑出血、变性和龟裂纹
2.处理方案及基本原则
本病治疗的基本原则是应用药物或手术阻止其近视性眼轴延长。
(1)目前认为阿托品眼用制剂是阻止近视性眼轴延长、减缓近视加深的有效药物,但长期应用是否会产生不良反应:如瞳孔大,光照对眼内组织造成光毒性损害等尚不明确。
(2)后巩膜加固手术是目前认为能阻止近视性眼轴延长的有效方法。该患者选择了后巩膜加固手术,在眼球后极部巩膜外植入保存异体硬脑膜加固条带。
问题 1221
患者,男性, 19岁,主诉“双眼视物模糊3年, 戴镜不适2周”。3年前无明显诱因下出现双眼视力逐渐下降,右眼视物模糊更为显著, 不伴眼红、畏光等不适,无脓性分泌物、无虹视、无眼眶痛等不适, 2周前于外院验光,配戴框架眼镜矫正后, 视力明显改善,但视物不适, 久视伴头晕头痛,今为求进一步诊治来我院门诊。
既往史:
神经系统:否认既往头晕、头痛等疾病史。
家族史: 父亲中度近视30年,否认其他家族遗传性疾病史。
用药史: 否认眼部及全身用药史。
外伤手术史:否认重大手术外伤史。
过敏史: 否认食物及药物过敏史。
查体:
眼科专科检查如表45-1所示。


辅助检查:
小瞳综合验光OD:-3.50DS/-0.75DC×160=1.0
OS: -1.00DS/-0.50DC×165=1.0
角膜地形图(图45-1)OD:43.50D@75°43.0D@168°
OS: 42.90D@110°42.60D@20°

【问题1】
该患者的诊断及诊断依据
【问题2】
该患者的处理方案及基本原则
答案:
1.诊断和诊断依据
(1)双眼视物模糊3年,右眼更为显著,属于慢性
(2)2周前自行于外院验光,并配戴框架眼镜后出现头晕头痛等不适症状。
(3)眼部常规检查均未发现异常体征。
(4)辅助检查中综合验光提示有双眼近视、散光,双眼屈光参差;角膜地形图提示角膜低度数顺规散光。
基于以上几点分析:初步诊断为双眼屈光参差。
2.处理方案及基本原则
由于患者双眼屈光度差异达-2.50D,配戴常规框架眼镜存在双眼物象不等大,不能保持双眼单视功能,因此,可以选择通过角膜接触镜进行屈光矫正;18岁以上患者,如度数稳定,在进行全面检查后,也可考虑角膜的屈光手术矫正。可选择的治疗方法如下:
(1)软性角膜接触镜由于软性角膜接触镜存在初戴舒适性好,适应时间短,易于获得等优势,使其成为中低度屈光不正患者配戴接触镜首选。但其该患者全眼散光不超过-1D,因此使用普通球面软性角膜接触镜即可达到良好的矫正效果。若全眼散光超过-1D患者,需考虑使用Toric软性角膜接触镜。
(2)硬性高透氧角膜接触镜(RGP)高透氧的镜片材料使得RGP在维持眼表健康及视觉质量上有着强大的优势,但由于其配戴不及软镜舒适,需要一定的适应时间,临床医生需要有丰富的验配经验,且常规市场不易获得。在与患者进行充分沟通后,希望优先考虑舒适性,因此仍然选择通过软镜矫正。
(3)角膜塑形术(Ortho-K)角膜塑形术是通过使用“逆几何”设计的硬性高透氧角膜接触镜重塑角膜,达到消除或降低屈光度的目的。该患者屈光度及角膜地形图结果均显示适合通过角膜塑形术来矫正其屈光参差,但考虑到镜片及维护成本过高,未能采纳。
(4)角膜屈光手术18周岁成年人,屈光度数稳定的屈光参差者还可考虑施行角膜屈光手术,在进行全面系统的眼部检查,排除手术禁忌证后可进行。需与患者进行详细的术前沟通,并制定全面的术后随访规划。
问题 1222
患者,女性, 47岁,图书管理员, 主诉“双眼酸胀、视物模糊3年”。3年前无明显诱因下出现双眼酸胀,视力进行性下降, 尤其近视力下降更明显,持续阅读10分钟伴眉弓部疼痛, 畏光、头疼等不适,下午和傍晚时最严重, 无虹视、雾视等不适。曾于当地医院就诊,予珍珠明目液、玻璃酸钠滴眼液等治疗, 未见明显好转,今为求进一步诊治来我院门诊。
既往史:
系统回顾:无特殊
药物过敏史: 否认
外伤手术史:否认
家族史: 否认遗传病家族史
既往无配戴眼镜史
查体:
眼科专科检查如表46-1所示。


辅助检查:
主觉验光:
OD: +1.25DS/-0.50DC×175°→1.0
OS:+1.50DS/-1.00DC×165°→1.0
调节功能检查:
融合交叉柱镜(FCC):+1.00d, 调节滞后
正性相对性调节(PRA):-2.00D
负性相对性调节(NRA): +2.50D
调节幅度:4.5D
【问题1】
该患者的诊断及诊断依据
【问题2】
还需要与哪些疾病相鉴别?
【问题3】
该患者的处理方案及基本原则
答案:
1.诊断和诊断依据
(1)双眼酸胀、视物模糊,持续3年,属于慢性疾病。
(2)发病年龄45岁左右,症状随年龄进行性加重,具有年龄相关性特征。
(3)眼部专科检查未发现器质性病变。
(4)视光学检查发现远视性屈光不正和调节功能下降。
(5)经光学矫正,远、近视力可以至正常。
基于以上几点分析:初步诊断为双眼屈光不正,老视。
2.鉴别诊断
(1)症状的鉴别诊断。
①眼胀:常见于青光眼、干眼症、睑缘炎、表层巩膜炎、胬肉等。
②畏光:常见于角膜疾病、结膜炎、葡萄膜炎、巩膜炎、干眼症等。
③年龄增加相关的视力下降:常见于白内障、年龄相关性黄斑变性、青光眼等。
(2)老视的鉴别诊断。
①老年性白内障:多见于50岁以上老年人,以远视力下降为主要特征,早期近视力不下降,甚至有改善,配镜无法矫正,无眼胀、酸痛症状。裂隙灯检查可发现晶状体混浊。
②年龄相关性黄斑变性:远、近视力均明显下降,无法矫正,眼底镜检查可见黄斑区中心凹反光消失,色素紊乱,玻璃膜疣,或脉络膜新生血管膜,OCT和FAG有助于诊断。
③青光眼:远、近视力均进行性下降,无法矫正,可有急性发作或无症状慢性发展,可有/无前房变浅和/或房角关闭,多数伴有眼压升高,眼底检查可发现C/D增大,盘沿切迹或狭窄,以及对应的视野缺损,OCT检查RFLP和GCC厚度有助于早期诊断。
④干眼症:远、近视力均可下降,常伴畏光,光学矫正效果不明显,人工泪液治疗后视力改善,眼前段检查可发现BUT缩短、泪液分泌下降(Schirmer试验),严重可伴有角膜上皮脱落。
3.处理方案及基本原则
本病治疗的基本原则是准确验光,合理配镜,对不接受配镜的患者可行屈光手术。
1.准确验光
使用综合验光仪进行远用屈光度的检查是老视验光的基础。在屈光度完全矫正的前提下,测量调节幅度,按照“半量调节幅度”的经验公式给予老视配镜处方。基本步骤:
①远用屈光度的测量。
②融合交叉柱镜(FCC)或试验性阅读附加。
③负性相对性调节(NRA)和正性相对性调节(PRA)的测量。
④ADD=FCC+1/2(NRA+PRA)。
⑤试镜,测定近视力及清晰视力范围,根据实际需要调整处方。
⑥远、近瞳距测量。
2.合理配镜
常用的老视光学矫正方法有单光老花镜、双光镜、渐进多焦点眼镜,以及与框架眼镜相对应的单光、双光或多焦点角膜接触镜。如图46-1所示。

3.老视屈光手术
问题 1223
患者,男性, 28岁,主诉“近视想要手术矫正”。患者近视10年余, 配戴框架眼镜10年,目前戴的眼镜度数-2.00D, 近两年近视度数增加约-0.25D,一年前配戴过软性角膜接触镜, 约2个月。患者自觉戴镜不便,遂来我院门诊欲行近视激光矫正。
既往史:
外伤手术史:两年前左前臂骨折, 石膏固定。
过敏史:青霉素过敏。
眼部疾病史: 否认。
全身病史:否认。
家族史: 父亲近视-5.00D左右,母亲正视眼。
用药史: 否认。
查体:
眼科专科检查如表47-1所示。


辅助检查:
视光学专科检查或特殊检查如表47-2所示。

处理方案和基本原则是什么?
答案:
屈光手术是一种“锦上添花”的手术,因此患者术后及长期满意的视觉质量是我们追求的目标。
(1)准确的验光:每位患者都要经历电脑验光、小瞳综合验光、扩瞳电脑验光,如果扩瞳度数与小瞳综合验光相差-0.50D或以上,还应扩瞳综合验光,验光仍然遵循最小负镜最佳矫正视力的原则。
(2)手术方式选择:根据患者的年龄、屈光度、角膜厚度、术后恢复周期的要求等来选择手术方式。
(3)手术方案:一般如果患者角膜厚度足够,都会在原来验光结果的基础上多矫正10%左右,因为近视越深,术后屈光回退的程度越高。且年龄小的患者,也会在多矫正10%多基础上多矫正-0.25D左右,因为年龄小的患者不仅要考虑屈光回退,随年龄增长其屈光度也会增加。
问题 1224
患者,男性, 21岁,主诉“双眼近视激光矫正术后6月, 双眼视力下降1月”。双眼6月前因近视于外院行LASEK手术,术后双眼裸眼视力均恢复至1.0, 术后应用0.1%氟米龙眼液约3周后,自行停药。近1月来, 感觉双眼视力明显下降,自测视力右眼0.6, 左眼0.5,无眼红、眼痛。
既往史:
双眼近视12年, 准分子矫正术前右眼近视约-6.00DS, 左眼约-5.00DS,无其他眼病史。
家族史: 父亲双眼高度近视,约-8.00DS。
用药史: 眼部用药见现病史,否认全身用药
过敏史: 否认
查体:
眼科专科检查如表48-1所示。


辅助检查:
影像学检查如图48-1所示。

【问题1】
该患者的诊断及诊断依据
【问题2】
还需要与哪些疾病相鉴别?
【问题3】
该患者的处理方案及基本原则
答案:
1.诊断和诊断依据
(1)年轻男性患者
(2)以双眼LASEK术后视力逐渐下降为主要临床表现。
(3)无眼红、眼痛及畏光流泪。
(4)结膜无充血,裂隙灯检查:角膜上皮下混浊,角膜荧光素染色(-),BUT8s。
基于以上几点分析:LASEK术后角膜上皮下混浊(Haze)。
2.鉴别诊断
(1)症状的鉴别诊断。
LASEK术后视力下降:
①屈光回退:高度近视、术中角膜上皮瓣制作不良以及术后皮质类固醇滴眼液应用不规范等都可导致术后屈光回退。
②近视度本身数加深:由于眼轴延长或者晶状体密度增加导致。
(2)角膜上皮下混浊(Haze)的鉴别诊断。
①角膜炎:角膜炎常伴有角膜刺激症状和角膜荧光素染色阳性,而Haze没有角膜刺激症状,角膜荧光素染色呈阴性。
3.处理方案及基本原则
本病治疗的基本原则应用皮质类固醇滴眼液:
(1)皮质类固醇,Haze多数情况下局部用糖皮质激素滴眼液有效,2级或以下Haze会逐渐减轻至消失。程度较轻的Haze随着时间的推移、角膜组织的重塑,不用药也会逐渐减轻至消退。
(2)非甾体抗炎药物治疗:Haze的发生和手术的创伤反应有关,手术部位有炎性介质的释放和聚集。当应用皮质类固醇眼液造成眼压增高、不适合继续应用时,可局部使用非甾体抗炎药滴眼剂,对减轻Haze有一定的作用。
(3)PRK术中联合丝裂霉素C:Haze发生后常常伴有角膜组织的过度修复和Haze的发生,3级或以上Haze单纯应用皮质类固醇药物效果不佳,可在Haze稳定后,考虑用PRK手术消融Haze,同时消除回退的屈光度,术中需要用棉签沾取稀释的0.02%丝裂霉素C药液,涂抹在激光消融后的角膜组织上,20-30秒后用大量平衡液冲洗。如果术中不应用丝裂霉素C,术后会发生更严重的Haze。
(4)其他疗法:避免紫外线照射,有研究证明,术后早期,紫外线照射可加重Haze。
问题 1225
患者,男性, 27岁,主诉“左眼SMILE术后视物重影一月”。患者1月前在外院行双眼SMILE术, 术后左眼视物重影,无眼红、畏光等不适, 为就进一步诊治,来我院门诊。
既往史:
手术史:1月前在外院行双眼SMILE术。
家族史: 父母高度近视。
用药史:人工泪液4次/天; 0.1%氟米龙眼水2次/天。
查体:
眼科专科检查如表49-1所示。


辅助检查:
综合验光:右眼: plano,矫正视力1.0; 左眼0.00/-0.50X70,矫正视力1.0
像差检查(WASCA): 右眼:垂直慧差Z(3, -3):-0.049, 水平慧差Z(3,+3): 0.051;球差Z(4, 0)0.213;高阶像差HOA0.29; 左眼:垂直慧差Z(3, -3):-0.107, 水平慧差Z(3,+3): -0.039;球差Z(4, 0)0.16;高阶像差HOA0.25。
左眼角膜地形图检查(Pentacam)图19-1: 提示左眼光学区偏心,同时该患者存在瞳孔区角膜表面欠规则。

【问题1】
还需要与哪些疾病相鉴别?
【问题2】
该患者的处理方案及基本原则
答案:
1.鉴别诊断
(1)透镜位置异常在角膜地形图上可表现为厚度变比率一致的偏心,需与透镜残留组织时所致的不规则厚度变化的偏心相鉴别,根据患者的病史以及裂隙灯下的透镜边缘痕迹有助于鉴别诊断,也可结合眼前节OCT结果鉴别。
(2)单眼复视较常见于晶体或人工晶体脱位、多瞳症、黄斑疾病、视网膜脱离,根据患者病史及详细的眼科检查可予以鉴别。
(3)双眼复视:双眼注视单个物体时成两个影像,遮盖任一眼,复视消失。根据此点可鉴别。
2.处理方案及基本原则
最接近视轴与角膜交点的是角膜顶点(apex),角膜顶点稳定可靠。SMILE中,在保持注视的前提下,当水印到达70~80%时,启动吸引,角膜顶点与吸引锥镜的锥顶接触,扫描成形的透镜中心即处于理想位置。
问题 1226
患者,女性, 23岁,主诉“SMILE术后1天, 双眼视物模糊畏光”。患者因双眼近视接受全飞秒激光小切口透镜取出术,手术顺利。术后第1天双眼畏光流泪, 轻度视物模糊,右眼较左眼更甚, 不伴眼红分泌物等其他不适。
既往史:
术前主觉验光: 右眼-4.00DS/-0.50DCx175°,左眼-3.5DS/-1.0DCx10°。
术前矫正视力: 右眼1.0,左眼1.2。
隐形眼镜佩戴史: 近三年偶尔戴,术前停1周。
家族史: 否认高度近视家族史。
过敏史:否认。
全身疾病史: 否认。
查体:
眼科专科检查如表50-1所示。


辅助检查:
相关检查见下图50-1~图50-4。




处理方案和基本原则是什么?
答案:
对于轻度和周边浸润DLK(1及2级)仅予局部糖皮质激素眼水频滴,密集炎性细胞累及角膜中周部时联合糖皮质激素静脉滴注(3级),严重病例(4级)需要掀瓣冲洗,但易诱发散光。
问题 1227
患者,女, 37岁,双眼近视25年, 要求行屈光矫正手术。近两年近视度数稳定,目前戴镜度数右眼-5.75D, 左眼-3.00D。没有角膜接触镜配戴史。
既往史:
外伤手术史: 无。
药物过敏史:无。
全身疾病史: 无。
眼部疾病史:无。
家族史: 无。
查体:
眼科专科检查如表51-1所示:


辅助检查:
Pentacam眼前节分析: 除角膜厚度薄以外,角膜曲率和高度分布都正常(右眼见图51-1, 左眼见图51-2)。


【问题1】
还需要与哪些疾病相鉴别?
【问题2】
该患者的处理方案及基本原则
答案:
1.鉴别诊断
(1)进展性近视:多见于学龄期儿童和部分青少年,表现为近视度数每年增加>=0.50D,多伴随眼轴的增长。
(2)薄角膜的鉴别诊断
①先天性薄角膜:除角膜厚度薄以外,其他角膜地形图数据都是正常,常常是双眼对称,厚度通常<500μm,但角膜前后表面曲率和高度都正常。
②圆锥角膜:表现为角膜厚度变薄,常伴有曲率增高和后表面高度增高,常常出现在角膜中央偏下方,并且双眼往往表现出不对称性。
③边缘角膜变性:表现为角膜周边部变薄和曲率改变,而中央角膜不受累。
2.处理方案及基本原则
薄角膜屈光手术的基本原则是安全第一。在排除圆锥角膜并且角膜厚度>450μm的前提下可以选择角膜激光手术,原则上选择对角膜生物力学影响相对较小的手术方式,并且在手术方案设计时保留安全角膜基质床厚度。在角膜厚度<450μm或者角膜地形图有异常表现的情况下,选择屈光晶体手术。
LASEK:对角膜生物力学的影响小于板层手术,适用于角膜地形图无异常,且角膜最薄厚度>450μm,安全基质床厚度为360μm。
SMILE:对角膜生物力学的影响小于LASIK,适用于角膜地形图无异常,且角膜最薄厚度>480μm,安全基质床厚度为270μm。
ICL/TICL:屈光晶体手术对角膜没有影响,适用于不适合角膜激光手术的患者。
问题 1228
患者,男性, 29岁,主诉“左眼自幼视力差”。患者自幼年期, 无明显诱因下,家人发现其左眼视力差, 无头位偏斜,无明显复视、视物变形、眼胀、眼痛、畏光流泪等症状。年幼时曾戴镜矫正, 但未能坚持,近年来自觉视疲劳严重, 特别在长时间近距离用眼时,为行进一步治疗来我院就诊。
既往史:
系统回顾:自幼健康, 无特殊。
家族遗传史:否认家族遗传性疾病。
预防接种史: 按社会要求接种。
外伤手术史:否认。
过敏史: 否认。
戴镜史:年幼时曾配戴框架眼镜, 但弱视好转后未能坚持,5年前尝试配戴隐形眼镜, 但易引起眼红眼痛,也未能坚持。近年来未配戴眼镜矫正。
查体:
眼科检查如表52-1所示。


辅助检查:
(1)立体视: titmus大于400秒。
(2)屈光专科检查结果如表52-2所示:

(3)左眼术前角膜地形图: 如图52-1所示。

(4)实验室与辅助检查
胸片:心肺未见明显活动性病变。
心电图检查: 窦性心律。
【问题1】
该患者的诊断及诊断依据
【问题2】
还需要与哪些疾病相鉴别?
【问题3】
该患者的处理方案及基本原则
答案:
1.诊断和诊断依据
(1)患儿,男性,29岁,主诉“自幼左眼视力差”
(2)近年来自觉视物疲劳,特别在长时间近距离用眼时
(3)屈光度:右眼+1.50/-0.25×110=1.5左眼+5.25/-0.75×15=1.2。
(4)眼轴长度:右眼23.86mm左眼22.26mm。
基于以上几点分析:初步诊断为左眼高度远视,双眼屈光参差。
2.鉴别诊断
视疲劳症状的鉴别:视疲劳是目前眼科常见的一种疾病,患者的症状多种多样,常见的有近距离工作不能持久,出现眼及眼眶周围疼痛、视物模糊、眼睛干涩、流泪等,严重者头痛、恶心、眩晕。引起视疲劳的常见的原因有:1.屈光不正:包括近视、远视、散光没有得到准确矫正,严重的屈光参差;2.眼位不正:如隐斜患者随年龄增长双眼融合能力下降;3.其他疾病:如干眼、青光眼时眼压高、眶上神经痛以及副鼻窦炎都可引起视疲劳。本例患者出现视疲劳的原因为双眼严重的屈光参差、双眼远视左眼高度远视未予矫正。
3.处理方案及基本原则
屈光参差会严重影响视功能,破坏双眼单视,导致斜视、弱视发生,而且屈光参差发生年龄越小,对视功能的影响越严重。因此,对少年儿童的屈光参差要早期发现,充分矫正,尽早配镜,并坚持戴镜。对于成人,往往不能耐受屈光参差的框架眼镜,因此常用的治疗方式为隐形眼镜或屈光手术治疗。目前准分子激光手术已被广泛应用于成人远视、近视、散光的矫治,其近、远期疗效已得到临床的充分肯定。
问题 1229
患者,女性, 3岁,家长主诉“发现患儿左眼向内偏斜1年”。家长发现患儿从2周岁开始无明显诱因下出现左眼向内偏斜, 不伴眼红、眼痛、畏光等不适,半年前至我院就诊, 扩瞳验光后诊断为双眼远视、共同性内斜视。予按阿托品扩瞳验光后远视度数足配,嘱配镜常戴, 半年后复诊。家长诉戴镜后斜视有所好转。
既往史:
个人史: 足月剖腹产,发育中等, 体重偏轻。
家族史:父母均低度近视, 无其他眼病史。
外伤手术史:否认。
过敏史: 否认。
传染病史:否认。
查体:
眼科专科检查如表53-1所示。


辅助检查:
睫状肌麻痹验光:
阿托品眼水,tid, 3天后剪影验光:
R: +4.50DS
L:+6.00DS/-1.00DCx20
矫正视力不合作
斜视度检查:
1.角膜映光法33cm:

2.三棱镜33cm:


3.注视性质:中心注视。
4.眼球运动: 双眼各方向运动无明显受限,内转较强。
5.特殊体征: Bielschowsky征(-)。
6.代偿头位:无明显代偿头位。
7.A/V征: 无
8.眼球震颤:无
9.眼睑改变: 无
眼位诊断如图53-1、图53-2所示。


【问题1】
该患者的诊断及诊断依据
【问题2】
还需要与哪些疾病相鉴别?
【问题3】
该患者的处理方案及基本原则
答案:
1.诊断和诊断依据
(1)双眼交替性内斜视
(2)阿托品扩瞳验光显示中高度远视
(3)远视眼镜戴镜时仍见内斜,但斜视度较裸眼时明显减少
基于以上几点分析:初步诊断为部分调节性内斜视。
2.鉴别诊断
(1)完全调节性内斜视:内斜度完全由于远视性屈光不正引起,充分麻痹睫状肌或戴全矫眼镜后内斜可矫正达正位。
(2)非屈光性调节性内斜视:又称高AC/A或集合过强型内斜。伴或不伴远视,戴镜后斜视度无改变。看近时,尤其是注视精细视标或精神紧张时,内斜度明显增加,戴全矫眼镜注视精细视标(调节性视标)时,其视近内斜度比视远内斜度大20△以上。视远时内斜可消失。
3.处理方案及基本原则
对于部分调节性内斜视的治疗,首先应完全矫正远视,同时治疗弱视。3个月后复查视近、视远斜视度变化。如果内斜视减少,但仍残留10△以上的内斜视,则应手术治疗,将残留内斜部分手术矫正。调节性内斜视部分应继续戴镜。有些家长不愿意让患儿戴镜,要求把所有斜视度都通过手术来矫正,是不恰当的,应该给家长讲明,即使手术把斜视完全矫正,术后不戴眼镜,斜视还会复发。手术量应根据视远斜视度来设计,手术方式以减弱单眼或双眼内直肌为主。
问题 1230
患者,男性, 4岁,主诉“家属发现患者眼睛往内偏斜半年”。半年前无明显诱因下家长发现患儿眼睛往内偏斜, 刚开始只是间歇性发作,后来逐渐变成持续性, 尤其是在看近物或玩玩具的时候,今为求进一步诊治来我院门诊。
既往史:
眼部疾病史:否认
家族史: 母亲未见明显异常,父亲有弱视病史
个人史: 足月顺产
用药史:否认
外伤史: 否认
手术史:否认
过敏史: 否认
查体:
眼科专科检查见表54-1所示。




辅助检查:
头颅MRI:未见明显异常
B超: 未见肌肉明显增粗肥厚等现象,眼眶内未见明显异常
【问题1】
该患者的诊断及诊断依据
【问题2】
还需要与哪些疾病相鉴别?
【问题3】
该患者的处理方案及基本原则
答案:
1.诊断和诊断依据
(1)发生年龄
(2)右眼高度远视,屈光参差
(3)戴镜后眼位完全正位
基于以上几点分析:初步诊断为“完全性调节性内斜视,右眼弱视”。
2.鉴别诊断
斜视的鉴别诊断
①先天性内斜视:出生后6个月内发病,一般不合并明显屈光异常。单眼性斜视可合并弱视。
②基本型内斜视:常在2岁以后出现,没有明显调节因素,单眼斜视可合并弱视,无明显远视屈光不正,视远视近斜视度相同。
③急性共同性内斜视:发病急,突然出现复视。多发生在5岁以后,因双眼视功能已健全所以才有复视。眼球运动无受限。
④周期性内斜视:3-4岁发病,内斜视呈周期性出现,一般为隔日斜视,在不出现之日可能仅有轻度斜视或隐斜。
3.处理方案及基本原则
本病治疗的基本原则是戴镜矫正和弱视治疗
戴镜:矫正全部远视度数。
遮盖疗法:对于中度弱视(20/40-20/80),每天遮盖2个小时;对于重度弱视(20/100-20/400)每天遮盖6个小时
阿托品治疗:对于中度和重度弱视,每周点两天,推荐周末。
问题 1231
患者,男, 2岁,家长主诉“患儿出生4月时出现眼睛向里面偏斜至今”。患儿自出生4月时起出现眼向内偏斜, 双眼都有出现,不伴眼红、眼痛等不适, 视力情况不详,为求诊治至我院门诊。
既往史:
家族史:否认。
用药史: 否认。
预防接种史:随社会。
外伤手术史: 否认。
早产吸氧史:否认。
过敏史: 否认。
查体:
眼科专科检查如表55-1所示。

辅助检查:
斜视专科检查如表55-2所示。


【问题1】
该患者的诊断及诊断依据
【问题2】
还需要与哪些疾病相鉴别?
【问题3】
该患者的处理方案及基本原则
答案:
1.诊断和诊断依据
(1)出生6个月以内出现内斜视
(2)内斜度数较大,与调节没有关系
(3)屈光度正常:+3.0DS
(4)眼球运动正常,也可合并DVD或下斜肌亢进
(5)无明显中枢神经系统异常或器质性眼病
基于以上几点分析:初步诊断为先天性内斜视。
2.鉴别诊断
(1)症状的鉴别
假性内斜视:由于内眦赘皮遮挡鼻侧部分巩膜,导致视觉上向内偏斜的假象,采用遮盖试验可鉴别。
(2)内斜视的鉴别诊断
按发病年龄分为先天性内斜视和后天性内斜视,前者发病在出生后6个月以内,后者发病在出生后6个月以后。按斜视类型分为共同性内斜视和非共同性内斜视。按是否与调节有关系分为调节性内斜视、部分调节性内斜视。
①调节性内斜视:是由于过度使用调节,引起调节性辐辏过量所致,可分为屈光性调节性内斜、非屈光性调节性内斜。
1)屈光性调节性内斜系远视屈光所致,由于过多使用调节而致调节性集合过强,每一屈光度调节都伴有若干棱镜度调节性集合,这种比例称调节性集合与调节之比,即AC/A比值,患者是否出现内斜,不仅取决于远视程度,也与融合性分开的储备力有关,患儿如无良好的矫正性融合反射,则形成内斜。以2~3岁为最多,也有1/2~1岁的,远视度较高,平均+4.0D。远近注视斜度相等,AC/A比多正常,斜度一般中等,约20~30∆,开始为间歇性后转为恒定性。戴足矫正镜后内斜逐渐消失。
2)非屈光性调节性内斜又称高AC/A型调节性内斜。1~4岁发病,较屈光性调节性内斜稍晚。无屈光不正或度数较小,约+2.0D左右。AC/A比率高,注视近距物体发生过强的调节冲动,从而引起过度的调节性辐辏。正常的AC/A比率约为3~5∆/D,而此型可达7∆/D。视远可正位或轻度的内斜,视近则有20~30°的内斜。
部分调节性内斜:也即调节性内斜+非调节性因素,又称混合性内斜。一部分是由于调节的增加所引起,另一部分可能由于解剖异常所致。发病年龄在6月~15岁,双眼视功能低下,多合并单眼弱视、异常视网膜对应、分离性垂直偏斜(DVD)及下斜肌功能过强等。有中度或高度远视屈光不正,屈光不正矫正后,斜度减少,但不能完全消失。
非调节性内斜在儿童早期发病,无明显远视,也可为近视,戴镜不能矫正,单眼性者多伴有弱视。
继发性内斜包括下列情况:
1)继发于各种麻痹性斜视的内斜眼球运动无障碍。
2)继发于术后的内斜内斜欠矫、外斜过矫。
3)知觉性内斜因出生后早期眼部器质性病变,导致一眼视力低下,如角膜白斑,先天性葡萄膜炎,视神经萎缩或其他眼底病。因幼儿集合力强,故一眼视力低下易引起内斜
⑤特殊型内斜
1)小角度内斜微小斜视一般在10~15∆之内的内斜视,外观表现不显著,往往在发现弱视存在时,才被检查出来。
2)周期性内斜内斜呈规律性周期出现。
3)急性内斜视临床上偶然也见于年长儿童,甚至成年人突然出现复视,发生内斜,易与麻痹性内斜误诊。检查发现患者虽有同侧复视,但眼外肌各向运动皆好,无障碍呈现。
3.处理方案及基本原则
手术治疗:先天性内斜由于发病早,此时视觉发育基础差,易丧失双眼单视,故对手术时间,Parks认为治疗越早越好,最迟宜在2~2.5岁前,矫正眼位或残留10∆(棱镜度)以下的内斜。
问题 1232
患儿,女性, 4岁,家长主诉“发觉患儿眼斜3年”。3年前患儿家长发现患儿出现双眼眼位向内偏斜, 左眼视力欠佳。不伴眼红、畏光,脓性分泌物等不适, 曾于当地医院就诊,诊为双眼内斜。今为求进一步诊治来我院门诊。
既往史:
全身系统:否认全身性疾病。体格发育略迟缓。
家族史及个人史: 否认家族性遗传性疾病。患儿早产剖腹产。
用药史:眼部用药见现病史, 否认全身用药。
外伤手术史:否认。
过敏史: 否认
查体:
眼科专科检查如表56-1所示。


辅助检查:
视光专科检查见表56-2所示。

其他无殊。
【问题1】
该患者的诊断及诊断依据
【问题2】
还需要与哪些疾病相鉴别?
【问题3】
该患者的处理方案及基本原则
答案:
1.诊断和诊断依据
(1)家长首先发现患儿双眼眼位不正,出生后不久即发现。
(2)有生长发育缓慢的表现。
(3)眼部检查无器质性病变,屈光检查发现共同性内斜,双眼远视,单眼矫正视力低下。
(4)辅助检查未显示明显异常。
基于以上几点分析:初步诊断为双眼远视,左眼弱视,双眼共同性内斜。
2.鉴别诊断
(1)症状的鉴别诊断。
①内斜:常见于调节性内斜,或部分调节性内斜。小儿单眼麻痹性内斜少见。
②远视:常见于生理性远视。
③弱视:常见于形觉剥夺性弱视、屈光参差性弱视、斜视性弱视及屈光性弱视。
3.处理方案及基本原则
本病治疗的关键是矫正屈光不正和正规长期的弱视治疗。
1.矫正屈光不正
大多数弱视儿童都伴有不同程度的屈光不正,屈光不正的矫正是弱视治疗的基础和关键。通过戴镜矫正屈光不正,可以使视网膜上获得清晰的物象,在此基础上遮盖疗法又可以消除健眼对弱视眼的抑制作用。远视性屈光不正合并内斜视,配镜时应予以全部矫正,逆规散光和斜轴散光也应予以全部矫正。屈光不正矫正治疗本身也可帮助改善视觉缺陷,增强遮盖疗法的依从性。
2.弱视治疗
①遮盖疗法是一种传统的治疗方法,它是目前弱视治疗中沿用最久,并且是最经济有效的一种治疗方法。通过对优势眼的遮盖,来减缓或消除优势眼对弱视眼的抑制作用,增加弱视眼的使用机会,促使弱视眼视力的提高恢复。对于伴有斜视或是屈光参差的弱视儿童,在戴矫正眼镜后同时给予近距离作业加上遮盖治疗,能更好的治疗弱视,提高视力。患儿和家长的依从性是治疗有效与否的关键。②压抑疗法是利用过矫镜片、欠矫镜片或是点阿托品滴眼液压抑优势眼功能,促进弱视眼的视力提高,这种治疗方法对于轻、中度弱视、遮盖性眼球震颤、遮盖失败或需要维持治疗的儿童特别有效。③多媒体训练治疗是集视觉生理刺激、精细目力训练、同时视和立体视训练为一体的,并同时将电脑游戏和治疗训练相融合,增加智利过程中的趣味性,提高患儿的积极性和依从性,提高弱视的治愈率。④药物治疗弱视主要是为了改变神经元的活性,多巴胺是中枢神经系统重要的神经递质,能增加神经元的活性。胞二磷胆碱则是在中枢神经系统内刺激多巴胺的代谢,促进神经系统修复、功能再生。
问题 1233
患者,女性, 52岁,主诉“双眼逐渐内斜10余年, 近年有加重”。患者在10余年前慢慢出现内斜,并有复视。后复视消失, 但内斜却日益明显,且有眼球活动度明显下降。近年内斜更加明显, 同时右眼各方向活动差,左眼向外及上下活动基本受限, 固定于内下斜位,左眼尤明显。为求进一步诊治来我院门诊。
既往史:
疾病史:无特殊。
家族史: 父亲为高度近视。
用药史:目前无特殊用药。
外伤手术史: 否认
过敏史:否认
查体:
眼科专科检查如表57-1所示。


辅助检查:
患者眼睛术前想如图57-1所示, 术后像如图57-2所示。


眼眶CT:左眼上直肌轻度向鼻侧偏位。
【问题1】
该患者的诊断及诊断依据
【问题2】
还需要与哪些疾病相鉴别?
【问题3】
该患者的处理方案及基本原则
答案:
1.诊断和诊断依据
(1)近几年发生内斜,并呈逐渐加重趋势,双眼程度稍不同,患眼固定于内转或内下转位,不能外转或合并上转受限。
(2)检查发现:眼球向外、上转部分或完全受限,固定于内下斜位,牵拉试验阳性。
(3)有高度近视病史。
基于以上几点分析:初步诊断为高度近视性固定性内斜。
2.鉴别诊断
(1)先天性眼外肌广泛纤维化综合征:是一种先天性眼外肌发育异常,多累及双眼。其病因不清,有家族遗传特性,有认为病变在运动神经或者肌肉本身。临床表现为上睑下垂,眼球固定在某一位置,向其他方向运动均有受限,可有代偿头位,牵拉试验阳性。和高度近视无明显相关性。
(2)慢性进行性眼外肌麻痹:病因不清,有神经核变性,肌肉营养不良等因素之说。疾病呈慢性进展表现,双眼上睑下垂为初始症状,眼球各方向运动逐渐受限,多无复视。被动牵拉试验有明显抵抗。和高度近视无明显相关性。
(3)重症肌无力:是一种自身免疫性疾病,具有缓解和复发的倾向。可有上睑下垂,某一或多条眼外肌受累,且有疲劳症,晨轻暮重等倾向,可有复视等症状。注射新斯的明等抗胆碱酯酶类药物后,症状迅速减轻或消失。
3.处理方案及基本原则
对于这类病例,手术治疗是唯一的选择。
问题 1235
患儿,男性, 7岁,家属主诉“发现患儿双眼歪斜2年余”。患儿约两年前, 无明显诱因下,家人发现其双眼时而向外斜视, 无头位偏斜,无明显复视、视物变形、眼胀、眼痛、畏光流泪等症状。随时间推移, 眼位偏斜幅度逐渐增大,为行进一步治疗, 近期来我院就诊。
既往史:
系统回顾: 自幼健康,无特殊。
家族遗传史: 父亲有共同性外斜病史,至今未治疗。
预防接种史: 按社会要求接种。
外伤手术史:否认。
过敏史: 否认。
查体:
眼科检查如表59-1所示。


辅助检查:
1.斜视检查(如图59-1、图59-2、图59-3)



(1)角膜映光:-15~20°, 可控正位,右眼主斜眼。
(2)眼球运动: 未见明显异常。
(3)遮盖试验如表59-2所示:


(4)同视机检查
(5)A/V征: 无。
(6)代偿头位:无。
(7)特殊体征: 无。
(8)注视性质:双眼均为中心注视。
(9)眼球震颤: 无。
(10)眼睑改变:无。
2.实验室与辅助检查
(1)胸片: 心肺未见明显活动性病变。
(2)心电图检查:窦性心律。
【问题1】
该患者的诊断及诊断依据
【问题2】
还需要与哪些疾病相鉴别?
【问题3】
该患者的处理方案及基本原则
答案:
1.诊断和诊断依据
(1)患儿,男性,7岁,家长主诉“发现患儿双眼歪斜2年余”
(2)随时间推移,眼位偏斜幅度逐渐增大
(3)角膜映光:-15~20°,可控正位,右眼主斜眼
(4)三棱镜斜视度检查斜视度数稳定
基于以上几点分析:初步诊断为间歇性外斜视。
2.鉴别诊断
(1)废用性斜视:多因视力差造成外斜视,多有其他眼病,此患者否认其他眼病史,且视力较好,故排除该诊断。
(2)麻痹性斜视:除了直肌麻痹引起的斜视外,还有直肌以及斜肌运动障碍或上睑下垂等,此患者不符合,故暂不考虑。
(3)动眼神经麻痹性斜视:患眼不同程度的上睑下垂、眼球外上斜视,向上、向下和向内运动受限。眼内肌受累时,瞳孔开大,对光反应消失,近反射消失,调节麻痹。本患儿无此表现,故可鉴别。
(4)肌性斜颈:一般为胸锁乳头肌发育异常,无眼斜位,遮盖一眼单眼注视时头位仍斜。该患儿遮盖一眼后头位明显改善,故不支持此诊断。
3.处理方案及基本原则
本病治疗的目的是改善眼位偏斜以及远注视时较差的双眼视功能,同时保持或改善近注视时的双眼视功能。可以通过手术解决减少偏斜的角度,和(或)通过非手术方式增加融合控制能力。间歇性外斜视的主要治疗方式为手术治疗。
问题 1237
患儿,女, 13岁,父母诉“自幼歪头视物, 双眼上飘”。患儿未经正规治疗,近年来双眼上飘明显, 影响外观,今为求进一步诊治来我院就诊。
既往史:
家族史:无特殊。
用药史: 否认。
外伤手术史:否认。
过敏史: 否认。
查体:
眼科专科检查如表61-1所示。


辅助检查:
眼位的检查如图61-1~图61-4所示:




【问题1】
该患者的诊断及诊断依据
【问题2】
还需要与哪些疾病相鉴别?
【问题3】
该患者的处理方案及基本原则
答案:
1.诊断和诊断依据
(1)双眼自幼上飘。
(2)眼位检查有典型的中性滤光片遮盖眼出现明显的上斜和外旋,非遮盖眼不发生偏斜。
(3)同视机以及斜视角检查提示非注视眼上斜合并外斜和双侧下斜肌功能亢进。
基于以上几点分析:诊断为双眼DVD,间隙性外斜视,双眼下斜肌功能亢进。
2.鉴别诊断
DVD应与下列眼外肌异常相鉴别。
(1)上隐斜:一般多为单眼,行交替遮盖时,上隐斜眼遮盖时眼位上斜,上隐斜眼作注视眼时,另眼被遮盖时则表现为下斜。如右眼为上隐斜,遮盖右眼时该眼上转,如让右眼固视,遮盖左眼时左眼下转,且不伴有隐性眼球震颤。而DVD交替遮盖时双眼均上转,且常伴有隐性眼震。
(2)下斜肌功能过强:表现为内转位上斜最明显,患眼恢复注视时无内旋运动,常伴有上斜肌功能不足和V征。而DVD患者无论正前方或侧方注视时,均可表现上斜,非注视眼恢复注视时出现内旋运动,可以合并上斜肌功能亢进,无V征。
(3)上斜肌功能过强:多继发于直接拮抗肌下斜肌麻痹及对侧常合并上斜肌功能?下直肌麻痹,可合并内斜或外斜,以外斜为多。表现为第一眼位垂直偏斜度小,患眼固视时健眼轻度上斜,健眼固视时患眼轻度下斜。而DVD无论任何眼固视,非固视眼总上斜。
3.处理方案及基本原则
本病治疗以美容为目的,仅当斜视影响外观时才需进行治疗。
1.非手术治疗
一般认为DVD随年龄增长有自愈倾向,故不主张对儿童患者早期施行手术。Duke-Elder,Jories等推荐作双眼视功能训练或戴三棱镜矫正。对DVD程度轻且不合并斜视并具有一定双眼视功能者,可行增强融合功能的训练,如非注视眼为上斜程度重者,患者又不愿手术者,可采用压抑疗法配镜治疗,即应用戴正镜片的方法使经常注视眼的视力低于非注视眼,其目的是使上斜较重的眼变为注视眼,以此控制上斜,起到美容效果。对合并有屈光不正或弱视者均应给予矫正治疗。
2.手术治疗
手术的目的是消除眼球上飘以及合并的其他斜视。可通过悬吊法将上直肌后退8至12mm,当DVD和下斜肌亢进同时存在时(如本例),可采用下斜肌前转位术,将下斜肌的由上转肌转为下转肌。合并其他斜视者,则先矫正明显的斜视,后做定量容易的肌肉。如水平斜视明显者,先矫正水平斜视,但DVD合并先天性内斜或婴幼儿内斜者、手术要比一般内斜保守一些,以免发生过矫,DVD合并外斜者,若先矫正外斜,DVD会可能明显,因此可同时矫正,外斜矫正量应多一些。如上斜视与水平位斜视程度相同时,先矫正上斜视,后做定量容易的水平斜视。
问题 1238
患者,女性, 32岁,主诉“车祸伤后复视2年”。2年前患者因车祸伤昏迷6天, 醒后左眼不能睁开。后患者左眼逐渐能睁开,并诉及出现明显复视, 平时为避免复视影响生活,患者临时用眼罩遮挡左眼。近2年来复视症状未有任何缓解, 为求进一步诊治来我院门诊。
既往史:
家族史: 无特殊。
用药史:否认。
外伤手术史: 否认。
过敏史:否认。
查体:
眼科专科检查如表62-1所示。


辅助检查:
(1)眼位检查; 如图62-1所示:

(2)实验室辅助检查: 空腹血糖,血沉以及梅毒检查均未见异常。头颅MRI未见明显异常。
【问题1】
该患者的诊断及诊断依据
【问题2】
还需要与哪些疾病相鉴别?
【问题3】
该患者的处理方案及基本原则
答案:
1.诊断和诊断依据
(1)车祸伤后昏迷并出现复视2年。
(2)第一眼位左眼外斜,左眼除外转外其余方位功能不足,瞳孔受累。
基于患者主诉及检查,诊断为左眼动眼神经麻痹(不全麻痹)。
2.鉴别诊断
诊断通常是直接的,但:
(1)重症肌无力表现可能像动眼神经麻痹,尤其存在上睑下垂时。可通过病史以及新斯的明实验等加以鉴别。
(2)爆裂性骨折可以有类似垂直运动,限制内直肌以及引起外伤性瞳孔散大。影像学检查可以加以排除。
3.处理方案及基本原则
1.非手术治疗
(1)全面神经科检查,检查所有的脑神经,特别注意邻近的滑车神经和外展神经
(2)应当在所有患者中进行非外伤性的原发性动眼神经麻痹的调查,包括微血管筛查和神经影像学检查
(3)减轻复视(如果上睑下垂不遮盖瞳孔),遮盖患眼通常是必须的
(4)等待自行恢复:那些由于微血管疾病引起的通常恢复,但其他原因却较少如此
2.手术治疗
(1)因为手术治疗效果有限而且可能很复杂,一般不轻易实行。手术一般等到至少4到6个月稳定期后才应当考虑。
(2)在那些希望手术的患者,对眼运动的修复应当在上睑手术抬高上睑下垂之前
进行
(3)完全不可恢复的动眼神经麻痹,手术仅仅是改善第一眼位,眼球的各方向运动仍旧无法改善,复视不能完全消除。对于动眼神经不全麻痹,可后退亢进的同侧拮抗肌来改善患眼的运动,联合截除部分恢复的麻痹肌肉。如果肌肉功能没有恢复,建议采取转位术。后退对侧协同肌,因为它可以改善双眼的协同运动,增加BSV域。
问题 683
病历资料
<1.现病史
患者,女性, 70岁,主诉“双眼自幼视力差, 加重1月”。患者自幼双眼视力差,否认眼红、眼痛, 否认畏光、流泪,否认复视、虹视, 否认眼前黑影漂浮,否认视物变形, 否认外伤史。1月前无明显诱因下出现症状加重,无眼痛、眼红等不适, 遂来我院门诊诊治。
既往史:
否认高血压、糖尿病等全身疾病史
家族史: 两个哥哥视力差,具体不详
用药史: 否认眼部及全身用药
外伤手术史:否认过敏史: 否认
查体:
眼科专科检查如表19-1所示。





辅助检查:
B超:双眼玻璃体前中段少量点状回声, 各方位球壁较厚。
A超:
(1)右眼: 眼轴:15.34mm; 前房深度2.56mm
角膜曲率:D1/D2=45.55D/50.07D
IOL度数(Haigis公式): 57.5D(Ref 0.09D)
(2)左眼:眼轴: 15.87mm;前房深度3.09mm
角膜曲率: D1/D2=46.68D/49.78D
IOL度数(Haigis公式):53.5D(Ref 0.18D)
该患者的诊断与诊断依据是什么?
答案:
(1)双眼自幼视力差,加重1月
(2)双眼外观及眼前节正常
(3)双眼晶状体混浊
(4)患者全身情况可,否认糖尿病、高血压等慢性疾病,否认外伤史
(5)辅助检查显示双眼眼轴极短,右眼为15.34mm,左眼为15.87mm;且各方位球壁增厚基于以上几点分析:初步诊断为“双眼年龄相关性白内障、后部型小眼球”。
问题 684
患者,女性, 70岁,主诉“双眼自幼视力差, 加重1月”。患者自幼双眼视力差,否认眼红、眼痛, 否认畏光、流泪,否认复视、虹视, 否认眼前黑影漂浮,否认视物变形, 否认外伤史。1月前无明显诱因下出现症状加重,无眼痛、眼红等不适, 遂来我院门诊诊治。
既往史:
否认高血压、糖尿病等全身疾病史
家族史: 两个哥哥视力差,具体不详
用药史: 否认眼部及全身用药
外伤手术史:否认过敏史: 否认
查体:
眼科专科检查如表19-1所示。





辅助检查:
B超:双眼玻璃体前中段少量点状回声, 各方位球壁较厚。
A超:
(1)右眼: 眼轴:15.34mm; 前房深度2.56mm
角膜曲率:D1/D2=45.55D/50.07D
IOL度数(Haigis公式): 57.5D(Ref 0.09D)
(2)左眼:眼轴: 15.87mm;前房深度3.09mm
角膜曲率: D1/D2=46.68D/49.78D
IOL度数(Haigis公式):53.5D(Ref 0.18D)
该患者的处理方案及理由是什么?
答案:
本病治疗的基本原则是手术摘除混浊晶状体,术前及术后积极抗炎,并控制眼压。
问题 287
患者,男性, 17岁,右眼畏光流泪, 眼痛7天。检查右角膜缘颞侧可见一灰白色圆形疱疹,周围球结膜局限性充血。患者初步的诊断是什么?
答案:
泡性角膜炎。本病可单独在结膜、角膜或角膜缘发病,也可同时发病。本病最常见于角膜缘部或其半透明组织中,表现为粟粒大的圆形灰白色或淡黄色小圆形泡状隆起,直径约为2~3mm。泡周围局限充血,用手挤压时无疼痛感,数日后结节上皮剥脱,顶端形成小溃疡。
问题 288
患者,男性, 17岁,右眼畏光流泪, 眼痛7天。检查右角膜缘颞侧可见一灰白色圆形疱疹,周围球结膜局限性充血。最适合的治疗方案是什么?
答案:
治疗局部应用糖皮质激素,如防止混合感染,局部加用抗生素滴眼液。
问题 300
患者,女性, 32岁,右眼上睑肿痛, 流泪伴发热1周,查体: 右眼视力正常,右眼上睑红肿, 以外侧明显,呈"S"外观, 外上方可扪及一个鸽蛋大小的包块,压痛明显, 颞侧结膜充血水肿,右侧耳前淋巴结肿大。
1.可能的诊断是什么?
2.可采取的处理措施有哪些?
答案:
1.急性泪腺炎。
2.急性泪腺炎其可能由病毒或细菌感染引起,治疗以全身和局部抗感染治疗为主。可局部点抗生素滴眼液或者冷敷,静脉点滴抗生素,口服抗病毒药物等。
问题 302
患者,女性, 40岁,右眼视力下降1个月, 无眼红、眼痛、畏光、流泪。眼科检查:视力右眼0.6, 左眼1.5,右眼无充血, 角膜透明,KP(+), 星形,弥漫分布于角膜后, 虹膜可见脱色素改变,未见粘连, 前房闪辉(+),未见炎性细胞, 晶状体后囊下轻度混浊,玻璃体轻度混浊, 眼底未见异常,眼压右25mmHg, 左16mmHg。
1.本例诊断为?
2.除降眼压外, 进一步的治疗是什么?
答案:
1.单眼的前段炎症,症状轻没有典型的急性虹膜炎体征,且有特征性的KP,以及虹膜脱色素改变,伴眼压升高,故考虑Fuchs虹膜异色性葡萄膜炎。
2.应用非甾体类抗炎药滴眼液。
问题 306
患者,30岁, 男性,右眼视力下降, 伴眼痛、眼红、流泪1周,否认外伤史, 体检发现前房积脓,瞳孔后粘连, 眼底检查困难。
1.处理措施有?
2.若患者经过两天治疗, 症状明显改善,视力从0.1提高到0.4, 眼底大体可见,未发现明显玻璃体或视网膜的严重病理改变, 前房积脓基本消失。但炎症仍然有,白细胞(++++), 闪辉(+++),因此药物如何调整?
3.患者治疗5天后视力接近0.9,自觉眼睛轻松。前房仍然少量细胞, Tyndall(+),患者要求出院。最后考虑诊断为?
答案:
1.根据患者的症状及检查情况,可能诊断为急性葡萄膜炎,由于眼底观察不详,不排除全葡萄膜炎。因此除局部给药以外同时给予全身药物。可给予激素类眼药水每半小时一次,非甾体类眼药水一日四次,静脉滴注或口服大剂量皮质激素。同时给予散瞳药物,胃黏膜保护药物,补钾,补钙。
2.患者经两天治疗已明显改善,而且发现视网膜和玻璃体大体正常,视力提高较快,因此考虑为前葡萄膜炎。对此局部药物的重要性增大,所以谨慎地减少全身用药。给予激素类眼药水改为每小时一次,非甾体类眼药水一日四次,静脉滴注或口服大剂量皮质激素减至每千克体重1mg。同时给予散瞳药物,胃黏膜保护药物,补钾,补钙。
3.急性前葡萄膜炎。
问题 310
患者,男性, 60岁,右眼视力下降半年多。Vod HM/30cm, Tod 35mmHg,右眼无充血, 角膜透明,前房轴深4C.T., 房水(-),瞳孔缘见米屑样物, 晶状体轻度混浊,C/D0.9。Vos 1.0.Tos 17mmHg, 左眼无充血,角膜透明, 前房轴深4C.T.,房水(-), 瞳孔缘见米屑样物,晶状体轻度混浊, C/D0.3。
1.考虑患者诊断为?
2.对确诊最有价值的检查是什么?
3.降眼压药物患者宜选用的是?
答案:
1.剥脱性青光眼。
2.患者为剥脱综合征继发青光眼患者,典型体征为晶状体表面有灰白色物质沉积,典型者分中央盘区、清洁区和周边颗粒层带三个区。散瞳检查见晶状体前表面的典型改变可确诊。
3.噻吗洛尔滴眼液;布林佐胺滴眼液;溴莫尼定滴眼液;卡替洛尔滴眼液。
问题 316
患者,女性, 58岁,右眼视力下降3个月, 伴眼痛3天。Vod HM/10cm,Tod 38mmHg, Vos 1.0,Tos 12mmHg, 右眼混合充血,角膜透明, 前房轴深3.5C.T.,房水(-), 瞳孔6mm×6mm,色素外翻, 虹膜面见新生血管,晶状体混浊, 视盘轻度水肿,视网膜广泛火焰状出血, 黄斑区水肿。左眼无充血,角膜透明, 前房轴深3.5C.T.,房水(-), 晶状体轻度混浊,眼底正常。患者眼压升高最可能的诊断是什么?
问题 317
患者,女性, 58岁,右眼视力下降3个月, 伴眼痛3天。Vod HM/10cm,Tod 38mmHg, Vos 1.0,Tos 12mmHg, 右眼混合充血,角膜透明, 前房轴深3.5C.T.,房水(-), 瞳孔6mm×6mm,色素外翻, 虹膜面见新生血管,晶状体混浊, 视盘轻度水肿,视网膜广泛火焰状出血, 黄斑区水肿。左眼无充血,角膜透明, 前房轴深3.5C.T.,房水(-), 晶状体轻度混浊,眼底正常。患者用药眼压控制不良, 行小梁切除术。术后3天右眼拆除可调整缝线后眼压升高。Tod 32mmHg,右眼滤过泡轻度隆起, 角膜透明,前房轴深1.5C.T., 中部至周边部前房消失。眼部B超未发现异常。诊断考虑为?
问题 318
患者,女性, 58岁,右眼视力下降3个月, 伴眼痛3天。Vod HM/10cm,Tod 38mmHg, Vos 1.0,Tos 12mmHg, 右眼混合充血,角膜透明, 前房轴深3.5C.T.,房水(-), 瞳孔6mm×6mm,色素外翻, 虹膜面见新生血管,晶状体混浊, 视盘轻度水肿,视网膜广泛火焰状出血, 黄斑区水肿。左眼无充血,角膜透明, 前房轴深3.5C.T.,房水(-), 晶状体轻度混浊,眼底正常。患者可选用什么药物进行治疗?
答案:
局部及全身应用糖皮质激素抗炎治疗;1%阿托品滴眼液3次/日,夜间加用阿托品眼膏;溴莫尼定滴眼液降眼压;20%甘露醇注射剂脱水、浓缩玻璃体。
问题 324
20岁女性患者,双眼视物不清伴眼球转动痛1周, 矫正视力双眼0.1,角膜透明, 房水清,瞳孔大小正常, 对光反应稍迟钝,晶状体无混浊, 眼底视盘边界清,颜色正常, C/D=0.3,A/V=2: 3。
1.最可能的诊断是什么?
2.有意义的检查是什么?
3.首选治疗方法是什么?
答案:
1.急性球后视神经炎。
2.急性球后视神经炎视野检查可确定病变部位,排除颅内占位性病变。
3.首选治疗方法是使用糖皮质激素,大剂量糖皮质激素应用能迅速减轻炎症和水肿,改善视神经的轴浆流,从而恢复视神经的功能。
问题 335
18岁学生,经常歪头视物。眼位: 平视时外斜-30°,向上注视时外斜-43°, 向下注视时外斜-10°。
1.应诊断为?
2.患者应采取的治疗方法是什么?
答案:
1.上下转斜视度变化大于15°,应诊断为外斜Ⅴ征。
2.长期的歪头视物可造成患者颜面部的不对称,所以应尽快手术矫正。
问题 338
65岁的渔民在乡卫生所行右眼胬肉切除术后,术中出血多, 手术时间长。术后第2天有复视,经活血化瘀后, 术后1个月,复视好转, 但右眼内转不足,有外斜视。
1.手术中出血多的原因是什么?
2.患者复视的原因是什么?
3.进一步应进行什么检查?
4.治疗方案是什么?
答案:
1.由于内直肌位置靠前,手术中如果操作不仔细,加上胬肉组织较大,往往会伤及内直肌,损伤肌肉内血管而出血。
2.患者出血吸收,水肿消退后复视好转,但右眼内转不足,有外斜视,因此可判断为内直肌受损,不全断裂及麻痹。
3.进行红玻璃检查,之后根据复像性质,进一步明确是否内直肌受损。
4.如果进行活血化瘀药物治疗后,症状仍不能改善,则可选择内直肌探查术。
问题 342
患者,女性, 55岁,诉双眼干涩、异物感2年, 伴口干及关节痛等全身症状。
1.可能的诊断为?
2.为进一步明确诊断, 对该患者可进行的检查项目有哪些?
答案:
1.

综合征。
2.Schirmertest、脂质干涉成像、泪液蕨类结晶。脂质干涉成像是分析脂质层的技术;Schirmer test评价的是水样泪液的分泌量;泪液蕨类结晶则是体现黏蛋白含量的敏感指标。
问题 344
患者,男性, 32岁,打羽毛球时被同伴的球拍击中右眼, 右眼红痛、视力下降。6小时后右眼视力下降更明显,眼痛加剧伴同侧头痛, 自觉恶心,呕吐一次。Vod FC/30cm, 加镜不能矫正视力,Vos 1.5。眼部检查: 右眼睑红肿、皮下淤血,结膜混合充血(++), 未见巩膜创口,角膜上皮雾样水肿、基质层水肿、后弹力层皱折(++), 前房轴深约3CT、房水呈血性、下方血性液平3mm,瞳孔圆形、直径5mm, 直接和间接对光反射消失,晶状体透明, 眼底检查隐见视盘,未能看清黄斑和视网膜细节。左眼眼部检查未见异常。
1.目前最有必要做的辅助检查是什么?
2.测得患眼眼压50mmHg,最适当的处理是什么?
3.若前房积血不能吸收,高眼压持续, 最常出现的并发症是什么?
答案:
1.外伤后患眼视力明显下降,眼剧痛伴同侧头痛、恶心、呕吐等症状,以及角膜上皮雾样水肿,提示患眼眼压可能急性升高,必须测量眼压以确诊。
2.伤后早期眼压升高,多由外伤性虹膜睫状体炎和前房积血引起,可能为一过性升高,当虹膜睫状体炎消退、前房积血吸收后,眼压可以恢复正常,所以,此时最恰当的处理是应用降眼压药。
3.当前房积血不吸收,持续高眼压时,前房血液内含铁血黄素经损伤的角膜内皮细胞进入基质层而形成角膜血染。
问题 347
患者,女性, 35岁,因"石灰溅入右眼后红、痛伴视力下降半天"就诊。眼部检查: Vod FC/50cm;右眼球结膜水肿(++), 10:00~6: 00点角膜缘苍白,角膜上皮缺损, 基质乳白色混浊水肿,前房结构窥不清。
1.该患者的碱烧伤属于哪一级?
2.可在哪段时间内使用糖皮质激素以减轻炎症反应?
答案:
1. Ⅳ级。碱烧伤可分四级,其中角膜缘缺血>1/2,角膜混浊阻碍虹膜和瞳孔的观察者为Ⅳ级。
2.伤后10天内。
问题 349
患者,男性, 30岁,因"右眼被铁屑击入1天"就诊, 到医院就诊拟诊为"右眼球贯通伤"。
1.眼球贯通伤是指?
2.给出常见并发症及处理?
答案:
1.外界物体伤及眼球,致眼球单侧壁全层裂开者,可同时伴有或不伴有眼内组织的脱出,称为眼球穿通伤。仅角膜穿通者称为角膜穿通伤;仅巩膜穿通者称为巩膜穿通伤;同时伤及角膜缘附近的巩膜者称为角巩膜穿通伤。同一致伤物有进入和穿出眼球壁造成双穿通的称为眼球贯通伤。
2.常见并发症及处理
(1)角膜水肿:角膜内皮细胞功能受损所致。术中应用黏弹剂,术后应用高渗盐水滴眼。眼压升高者,局部滴用降眼压眼液或全身应用降眼压药物。
(2)外伤性眼内炎(traumatic endophthalmitis):是细菌或其他致病微生物由致伤物带入或从伤口侵入眼内引起眼内急性化脓性炎症。常见的感染菌有铜绿假单胞菌(绿脓杆菌)、葡萄球菌、霉菌等,除霉菌感染发生稍晚、相对刺激症状稍轻以外,一般常发生于伤后1~3天,起病急骤,发展迅速,眼痛、头痛,刺激症状明显,视力严重下降,甚至无光感。检查可见球结膜高度水肿、充血,角膜混浊,前房有纤维蛋白炎症渗出或积脓,玻璃体呈雪球样混浊或脓肿形成。
早期散瞳,静脉滴注广谱抗生素及糖皮质激素,配合球结膜下注射,眼内注射。结膜囊伤口处刮片或细菌培养,找病原体。选择敏感的适于眼内注射的抗生素作玻璃体内注射。同时可抽取房水及玻璃体液作细菌及霉菌培养加药敏试验。若保守治疗2~3天后无明显好转时应尽早做玻璃体手术,同时做玻璃体内药物灌注,术中灌注液里加一定浓度的抗生素和激素,术后继续全身应用抗生素及糖皮质激素。
(3)外伤性增生性玻璃体视网膜病变(traumatic proliferative vitreoretinopathy,TPVR):由外伤引起眼内过度的修复反应,纤维组织增生所致,常引起牵拉性视网膜脱离。可行玻璃体手术切开或切除增生组织,解除牵引,以挽救视力。但有不少伤眼最终萎缩。
问题 355
患者,女性, 41岁,因右眼剧烈眼痛、畏光、流泪及视力下降2个月来诊。此前曾在当地给予抗生素、糖皮质激素和抗病毒眼液滴眼治疗, 症状无改善,且有加重趋势。眼部检查: 右眼视力0.5,矫正无提高。结膜混合充血, 上方、鼻侧及颞侧角膜缘溃疡形成,约占3/4象限(8点钟至5点钟), 最宽处位于角膜11点钟约5mm,溃疡与角膜缘之间无透明角膜间隔, 其朝向角膜中央方向有一个潜掘状的浸润进行缘。前房深度正常,房水闪辉(±), 未见积脓。左眼视力1.0,检查未见异常。患者既往身体健康, 否认风湿、类风湿等免疫性疾病,入院后全血细胞计数和分类值正常、全身类风湿因子(RF)、抗核抗体(ANA)、抗中性粒细胞胞浆抗体均为阴性。患者最可能的诊断是什么?
问题 356
患者,女性, 41岁,因右眼剧烈眼痛、畏光、流泪及视力下降2个月来诊。此前曾在当地给予抗生素、糖皮质激素和抗病毒眼液滴眼治疗, 症状无改善,且有加重趋势。眼部检查: 右眼视力0.5,矫正无提高。结膜混合充血, 上方、鼻侧及颞侧角膜缘溃疡形成,约占3/4象限(8点钟至5点钟), 最宽处位于角膜11点钟约5mm,溃疡与角膜缘之间无透明角膜间隔, 其朝向角膜中央方向有一个潜掘状的浸润进行缘。前房深度正常,房水闪辉(±), 未见积脓。左眼视力1.0,检查未见异常。患者既往身体健康, 否认风湿、类风湿等免疫性疾病,入院后全血细胞计数和分类值正常、全身类风湿因子(RF)、抗核抗体(ANA)、抗中性粒细胞胞浆抗体均为阴性。最合适的治疗方案是什么?
问题 357
患者,女性, 41岁,因右眼剧烈眼痛、畏光、流泪及视力下降2个月来诊。此前曾在当地给予抗生素、糖皮质激素和抗病毒眼液滴眼治疗, 症状无改善,且有加重趋势。眼部检查: 右眼视力0.5,矫正无提高。结膜混合充血, 上方、鼻侧及颞侧角膜缘溃疡形成,约占3/4象限(8点钟至5点钟), 最宽处位于角膜11点钟约5mm,溃疡与角膜缘之间无透明角膜间隔, 其朝向角膜中央方向有一个潜掘状的浸润进行缘。前房深度正常,房水闪辉(±), 未见积脓。左眼视力1.0,检查未见异常。患者既往身体健康, 否认风湿、类风湿等免疫性疾病,入院后全血细胞计数和分类值正常、全身类风湿因子(RF)、抗核抗体(ANA)、抗中性粒细胞胞浆抗体均为阴性。为防止复发, 后续的治疗方案是什么?
问题 362
患者,男性, 25岁,双眼红、痛伴分泌物增多3天就诊。自诉无明显诱因出现左眼异物感, 刺痛伴大量水样分泌物,1天后右眼出现相同症状。体征: 视力1.2(双眼),结膜充血(+++), 近穹隆部明显,睑裂区结膜下见小片状出血, 睑结膜乳头增生(+)、滤泡(++),上睑结膜表面见膜性渗出物, 剥离后创面少许渗血。角膜透明,荧光素染色下可见散在点状上皮脱失。眼部起病前2天有咽喉肿痛史, 耳前淋巴结中度肿大。依据病史、症状和体征,此患者的初步诊断是什么?
答案:
根据患者临床特点:起病急、症状重、双眼先后发病,结膜充血、乳头增生、滤泡形成、角膜局部点状上皮下浸润,同时伴有耳前淋巴结增大,可诊断为病毒性角结膜炎。
问题 363
患者,男性, 25岁,双眼红、痛伴分泌物增多3天就诊。自诉无明显诱因出现左眼异物感, 刺痛伴大量水样分泌物,1天后右眼出现相同症状。体征: 视力1.2(双眼),结膜充血(+++), 近穹隆部明显,睑裂区结膜下见小片状出血, 睑结膜乳头增生(+)、滤泡(++),上睑结膜表面见膜性渗出物, 剥离后创面少许渗血。角膜透明,荧光素染色下可见散在点状上皮脱失。眼部起病前2天有咽喉肿痛史, 耳前淋巴结中度肿大。为进一步明确诊断,进行结膜分泌物涂片染色, 最可能见到的细胞类型是?
答案:
病毒性角结膜炎分泌物涂片染色,可见单核细胞特别是淋巴细胞占多数。
问题 364
患者,男性, 25岁,双眼红、痛伴分泌物增多3天就诊。自诉无明显诱因出现左眼异物感, 刺痛伴大量水样分泌物,1天后右眼出现相同症状。体征: 视力1.2(双眼),结膜充血(+++), 近穹隆部明显,睑裂区结膜下见小片状出血, 睑结膜乳头增生(+)、滤泡(++),上睑结膜表面见膜性渗出物, 剥离后创面少许渗血。角膜透明,荧光素染色下可见散在点状上皮脱失。眼部起病前2天有咽喉肿痛史, 耳前淋巴结中度肿大。局部药物治疗方案是什么?
答案:
病毒性角结膜炎急性期可使用抗病毒药物抑制病毒复制,可使用更昔洛韦滴眼液+重组干扰素滴眼液。
问题 365
患者,男性, 25岁,双眼红、痛伴分泌物增多3天就诊。自诉无明显诱因出现左眼异物感, 刺痛伴大量水样分泌物,1天后右眼出现相同症状。体征: 视力1.2(双眼),结膜充血(+++), 近穹隆部明显,睑裂区结膜下见小片状出血, 睑结膜乳头增生(+)、滤泡(++),上睑结膜表面见膜性渗出物, 剥离后创面少许渗血。角膜透明,荧光素染色下可见散在点状上皮脱失。眼部起病前2天有咽喉肿痛史, 耳前淋巴结中度肿大。患者局部治疗后眼部刺激症状减轻,水样分泌物减少, 起病后10天左右,突然眼部刺痛症状加剧, 伴视力下降,结膜充血程度较前有改善, 双眼角膜上出现灶性分布圆点状浸润,直径2~3mm, 荧光素染色阳性,病灶之间隔有透明角膜。此时应在原治疗方案的基础上进行何种调整?
问题 366
患者,男性, 35岁。双眼红肿、开睑困难伴分泌物增多4天。病史:患者发病前2日曾因腹痛而服用头孢类抗生素、小檗碱和多酶片等药物, 其后出现肢体、躯干发疹,反复畏寒、发热、咽痛、咳嗽等症状。否认胸闷、气急、关节酸痛及吞咽困难。眼部检查: 双眼视力:0.5, 双眼结膜充血水肿,结膜囊内大量分泌物, 睑结膜和球结膜表面假膜形成,角膜周边部上皮混浊, 向中央扩展,房水清, 晶状体透明,玻璃体未见混浊, 眼底未查。全身检查:体温38.5℃, 躯干和四肢见大量散在红斑,部分表面有水疱、糜烂, 口腔黏膜、下唇黏膜糜烂、溃破。血白细胞计数13.2THSD/CUMM,中性0.75, 淋巴0.24,单核0.01。患者最可能的诊断是什么?
问题 367
患者,男性, 35岁。双眼红肿、开睑困难伴分泌物增多4天。病史:患者发病前2日曾因腹痛而服用头孢类抗生素、小檗碱和多酶片等药物, 其后出现肢体、躯干发疹,反复畏寒、发热、咽痛、咳嗽等症状。否认胸闷、气急、关节酸痛及吞咽困难。眼部检查: 双眼视力:0.5, 双眼结膜充血水肿,结膜囊内大量分泌物, 睑结膜和球结膜表面假膜形成,角膜周边部上皮混浊, 向中央扩展,房水清, 晶状体透明,玻璃体未见混浊, 眼底未查。全身检查:体温38.5℃, 躯干和四肢见大量散在红斑,部分表面有水疱、糜烂, 口腔黏膜、下唇黏膜糜烂、溃破。血白细胞计数13.2THSD/CUMM,中性0.75, 淋巴0.24,单核0.01。局部治疗方案是什么?
问题 373
中年男性患者,发现视力下降2天, 右眼视力降至0.5,左眼0.6, 眼底检查发现双眼视盘边界稍模糊,视盘充血。黄斑部可疑水肿。其最可能的诊断是什么?
问题 374
中年男性患者,发现视力下降2天, 右眼视力降至0.5,左眼0.6, 眼底检查发现双眼视盘边界稍模糊,视盘充血。黄斑部可疑水肿。初步诊断为葡萄膜大脑炎(VKH)急性期, 为证实这一诊断的重要检查有哪些?
答案:
仔细观察前房及玻璃体炎症改变,检查视网膜水肿特征,询问全身表现
问题 375
中年男性患者,发现视力下降2天, 右眼视力降至0.5,左眼0.6, 眼底检查发现双眼视盘边界稍模糊,视盘充血。黄斑部可疑水肿。应当给予的治疗方案是什么?
答案:
大剂量激素,配合适度的局部药物,暂时不用免疫抑制剂
问题 376
患者熬夜劳累后双眼视力突然下降2周,曾经在半年前有类似发病, 2周后治愈。1年前曾经患梅毒Ⅱ期,但现已经治愈。目前没有皮肤病变, 没有口腔溃疡。在当地医院使用激素等药物视力逐渐恢复。查右眼视力0.3,左眼0.5, 双眼前房闪辉(++),细胞(+++), 玻璃体混浊。首选诊断是什么?
问题 377
患者熬夜劳累后双眼视力突然下降2周,曾经在半年前有类似发病, 2周后治愈。1年前曾经患梅毒Ⅱ期,但现已经治愈。目前没有皮肤病变, 没有口腔溃疡。在当地医院使用激素等药物视力逐渐恢复。查右眼视力0.3,左眼0.5, 双眼前房闪辉(++),细胞(+++), 玻璃体混浊。最为恰当的治疗措施是什么?
问题 378
患者熬夜劳累后双眼视力突然下降2周,曾经在半年前有类似发病, 2周后治愈。1年前曾经患梅毒Ⅱ期,但现已经治愈。目前没有皮肤病变, 没有口腔溃疡。在当地医院使用激素等药物视力逐渐恢复。查右眼视力0.3,左眼0.5, 双眼前房闪辉(++),细胞(+++), 玻璃体混浊。应该给予的医护建议是什么?
答案:
建议生活有规律,休息饮食得当,调整心态,情绪平和等生活习惯
问题 379
青年男性患者,右眼红痛, 畏光,视力下降4天。眼部检查: 右眼视力0.8,矫正无提高, 右眼结膜睫状充血+,尘状KP(++), Tyn(+),房水细胞(+), 瞳孔圆,直径约2.5mm, 晶状体透明,玻璃体未见混浊, 眼底未见异常。左眼视力1.0,无充血, 角膜透明,KP(-), Tyn(-),瞳孔3.5mm, 晶状体透明,眼底未见异常。眼压正常。其最可能的诊断是什么?
问题 380
青年男性患者,右眼红痛, 畏光,视力下降4天。眼部检查: 右眼视力0.8,矫正无提高, 右眼结膜睫状充血+,尘状KP(++), Tyn(+),房水细胞(+), 瞳孔圆,直径约2.5mm, 晶状体透明,玻璃体未见混浊, 眼底未见异常。左眼视力1.0,无充血, 角膜透明,KP(-), Tyn(-),瞳孔3.5mm, 晶状体透明,眼底未见异常。眼压正常。根据患者目前的病情, 首选的治疗措施是什么?
问题 381
患者女性,71岁。生气后突然发生右侧剧烈头痛、呕吐、眼球胀痛及眼球充血。血压高达180/110mmHg, 内科以高血压、脑血管小卒中而收入院,经内科降压及对症治疗症状缓解。但瞳孔仍大, 留院观察治疗一月。出院后第二天,上述头痛眼胀复发, 伴右眼视物模糊不清就诊于眼科。既往因类风湿性关节炎,长年口服强的松10mg/日。根据病史, 急诊最好应先进行哪些检查?
答案:
视力;裂隙灯检查;眼底检查;眼压测量;房角镜检查
问题 382
患者女性,71岁。生气后突然发生右侧剧烈头痛、呕吐、眼球胀痛及眼球充血。血压高达180/110mmHg, 内科以高血压、脑血管小卒中而收入院,经内科降压及对症治疗症状缓解。但瞳孔仍大, 留院观察治疗一月。出院后第二天,上述头痛眼胀复发, 伴右眼视物模糊不清就诊于眼科。既往因类风湿性关节炎,长年口服强的松10mg/日。检查提示: 右眼视力4.0(0.1),左眼4.7(0.5), -3.0D矫正至5.1(.2)。右眼睫状充血(++),角膜轻水肿, 瞳孔5mm,对光反应极弱, 周边前房深度1/5CT。眼压右34.4mmHg,左20.55mmHg。初步诊断考虑哪种疾病?
问题 383
患者女性,71岁。生气后突然发生右侧剧烈头痛、呕吐、眼球胀痛及眼球充血。血压高达180/110mmHg, 内科以高血压、脑血管小卒中而收入院,经内科降压及对症治疗症状缓解。但瞳孔仍大, 留院观察治疗一月。出院后第二天,上述头痛眼胀复发, 伴右眼视物模糊不清就诊于眼科。既往因类风湿性关节炎,长年口服强的松10mg/日。急诊应尽快作哪些处理?
答案:
缩瞳剂,1-3%匹罗卡品滴右眼;醋氮酰胺500mg即刻口服;50%甘油150ml;20%甘露醇静脉点滴
问题 384
患者女性,71岁。生气后突然发生右侧剧烈头痛、呕吐、眼球胀痛及眼球充血。血压高达180/110mmHg, 内科以高血压、脑血管小卒中而收入院,经内科降压及对症治疗症状缓解。但瞳孔仍大, 留院观察治疗一月。出院后第二天,上述头痛眼胀复发, 伴右眼视物模糊不清就诊于眼科。既往因类风湿性关节炎,长年口服强的松10mg/日。根据以上情况应进一步作哪些检查?
答案:
双眼中心视野及周边视野;电眼压;房角镜检查
问题 385
患者女性,71岁。生气后突然发生右侧剧烈头痛、呕吐、眼球胀痛及眼球充血。血压高达180/110mmHg, 内科以高血压、脑血管小卒中而收入院,经内科降压及对症治疗症状缓解。但瞳孔仍大, 留院观察治疗一月。出院后第二天,上述头痛眼胀复发, 伴右眼视物模糊不清就诊于眼科。既往因类风湿性关节炎,长年口服强的松10mg/日。根据以上结果, 结合病史考虑哪些诊断?
答案:
高血压病;类风湿关节炎;右眼急性闭角型青光眼(慢性期);左眼近视眼;左眼急性闭角型青光眼(临床前期)
问题 386
患者女性,71岁。生气后突然发生右侧剧烈头痛、呕吐、眼球胀痛及眼球充血。血压高达180/110mmHg, 内科以高血压、脑血管小卒中而收入院,经内科降压及对症治疗症状缓解。但瞳孔仍大, 留院观察治疗一月。出院后第二天,上述头痛眼胀复发, 伴右眼视物模糊不清就诊于眼科。既往因类风湿性关节炎,长年口服强的松10mg/日。需要施行手术治疗的青光眼有哪些?
答案:
原发性闭角型青光眼;用药物治疗不能控制病情发展的原发性开角型青光眼;先天性青光眼(婴幼儿型);用药物治疗不能解除的继发性青光眼
问题 387
患者女性,71岁。生气后突然发生右侧剧烈头痛、呕吐、眼球胀痛及眼球充血。血压高达180/110mmHg, 内科以高血压、脑血管小卒中而收入院,经内科降压及对症治疗症状缓解。但瞳孔仍大, 留院观察治疗一月。出院后第二天,上述头痛眼胀复发, 伴右眼视物模糊不清就诊于眼科。既往因类风湿性关节炎,长年口服强的松10mg/日。本病可选择哪些术式?
问题 388
患儿男性,14岁。因右眼视网膜脱离, 行玻璃体切除,硅油填充术。术后给予百力特滴眼液qlh, (逐渐递减),泰利必妥滴眼液qid, 1%阿托品qd,复方托品卡胺tid, 点术眼。从术后2个月开始,患儿自觉右眼异物感明显, 并伴有流泪、畏光等症状。眼部检查发现右眼混合充血,角膜上皮粗糙, 弥漫荧光素染色,怀疑有病毒感染可能, 停用百力特滴眼液,并给予1%阿昔格韦滴眼液qlh, 同时加用贝复舒,唯地息等药物治疗, 患儿症状仍无明显好转。患儿角膜病变最可能的是什么?
问题 389
患儿男性,14岁。因右眼视网膜脱离, 行玻璃体切除,硅油填充术。术后给予百力特滴眼液qlh, (逐渐递减),泰利必妥滴眼液qid, 1%阿托品qd,复方托品卡胺tid, 点术眼。从术后2个月开始,患儿自觉右眼异物感明显, 并伴有流泪、畏光等症状。眼部检查发现右眼混合充血,角膜上皮粗糙, 弥漫荧光素染色,怀疑有病毒感染可能, 停用百力特滴眼液,并给予1%阿昔格韦滴眼液qlh, 同时加用贝复舒,唯地息等药物治疗, 患儿症状仍无明显好转。进一步眼部检查包括哪些?
答案:
前房内有无硅油珠;前房内炎症情况;眼压;角膜内皮计数;角膜有无基质水肿;晶状体情况;视网膜复位情况
问题 390
患儿男性,14岁。因右眼视网膜脱离, 行玻璃体切除,硅油填充术。术后给予百力特滴眼液qlh, (逐渐递减),泰利必妥滴眼液qid, 1%阿托品qd,复方托品卡胺tid, 点术眼。从术后2个月开始,患儿自觉右眼异物感明显, 并伴有流泪、畏光等症状。眼部检查发现右眼混合充血,角膜上皮粗糙, 弥漫荧光素染色,怀疑有病毒感染可能, 停用百力特滴眼液,并给予1%阿昔格韦滴眼液qlh, 同时加用贝复舒,唯地息等药物治疗, 患儿症状仍无明显好转。应给予的治疗措施是什么?
答案:
使用不含防腐剂的眼部润滑剂;停用目前所有药物;眼部热敷
问题 391
患儿男性,14岁。因右眼视网膜脱离, 行玻璃体切除,硅油填充术。术后给予百力特滴眼液qlh, (逐渐递减),泰利必妥滴眼液qid, 1%阿托品qd,复方托品卡胺tid, 点术眼。从术后2个月开始,患儿自觉右眼异物感明显, 并伴有流泪、畏光等症状。眼部检查发现右眼混合充血,角膜上皮粗糙, 弥漫荧光素染色,怀疑有病毒感染可能, 停用百力特滴眼液,并给予1%阿昔格韦滴眼液qlh, 同时加用贝复舒,唯地息等药物治疗, 患儿症状仍无明显好转。经上述处理后患儿角膜情况好转,但是仍有反复, 采取的治疗措施有哪些?
答案:
局部糖皮质激素应用;包扎患眼;配戴软性角膜接触镜;自家血清点眼
问题 392
患者女性,47岁, 因左眼疼痛、怕光、流泪、视力下降件发热天就诊。此前一周患感冒,有糖尿病史。查体: 体温38.5℃,左耳前淋巴结肿大, 睫状充血明显,角膜水肿混浊, 右眼正常。为明确诊断,应当行哪些专科检查?
答案:
查视力;裂隙灯;角膜荧光素染色;角膜知觉检查
问题 393
患者女性,47岁, 因左眼疼痛、怕光、流泪、视力下降件发热天就诊。此前一周患感冒,有糖尿病史。查体: 体温38.5℃,左耳前淋巴结肿大, 睫状充血明显,角膜水肿混浊, 右眼正常。提示:裂隙灯检查发现: 左眼睫状充血显著,角膜呈树枝状灰白色浑浊, 荧光素染色着色,房水闪光阳性, 角膜知觉减退。该患者左眼诊断应考虑为?
问题 394
患者女性,47岁, 因左眼疼痛、怕光、流泪、视力下降件发热天就诊。此前一周患感冒,有糖尿病史。查体: 体温38.5℃,左耳前淋巴结肿大, 睫状充血明显,角膜水肿混浊, 右眼正常。该患者左眼初步诊断为单纯疱疹病毒性角膜炎,其可能的致病病原体是哪些?
问题 395
患者女性,47岁, 因左眼疼痛、怕光、流泪、视力下降件发热天就诊。此前一周患感冒,有糖尿病史。查体: 体温38.5℃,左耳前淋巴结肿大, 睫状充血明显,角膜水肿混浊, 右眼正常。哪些实验室检查可以诊断单纯疱疹病毒性角膜炎?
答案:
中和实验;补体实验;免疫组化;病毒分离;核酸杂交技术
问题 396
患者女性,47岁, 因左眼疼痛、怕光、流泪、视力下降件发热天就诊。此前一周患感冒,有糖尿病史。查体: 体温38.5℃,左耳前淋巴结肿大, 睫状充血明显,角膜水肿混浊, 右眼正常。该患者左眼治疗应采用哪些措施?
答案:
双眼滴无环鸟苷眼液;左眼滴碘苷眼液;口服抗病毒药;左眼结膜下注射阿糖胞苷
问题 397
患者女性,47岁, 因左眼疼痛、怕光、流泪、视力下降件发热天就诊。此前一周患感冒,有糖尿病史。查体: 体温38.5℃,左耳前淋巴结肿大, 睫状充血明显,角膜水肿混浊, 右眼正常。提示:经治疗, 患者左眼病情仍进行性加重,角膜出现大片溃疡, 前房积脓。治疗措施是什么?
答案:
前房穿刺术;加用静滴抗病毒药;病灶清除术;碘伏灼病灶组织
问题 398
患者女性,47岁, 因左眼疼痛、怕光、流泪、视力下降件发热天就诊。此前一周患感冒,有糖尿病史。查体: 体温38.5℃,左耳前淋巴结肿大, 睫状充血明显,角膜水肿混浊, 右眼正常。提示:经药物治疗, 患者左眼病情仍进行性加重,角膜溃疡已达基质深层, 后弹力层膨出于溃疡处。此时应采用哪些治疗措施?
答案:
结膜瓣遮盖术;睑缘缝合术;板层角膜移植术;穿透性角膜移植术
问题 403
患者男性,26岁。因右眼被虾刺穿角巩膜缘部引起外伤性白内障, 于伤后35天行白内障摘除人工晶体植入术,手术顺利, 矫正视力4.9(0.8),但术后二周复查时发现术眼瞳孔缘有小结节, 人工晶体表面有沉着物。一月后因左眼视物模糊来诊。查:右眼角膜后大块沉着物, 瞳孔边缘有结节,人工晶体表面被沉着物部分覆盖。左眼轻度睫状充血, 黄斑部视网膜水肿,浅层脱离, 眼底周边可见黄白色脉络膜渗出点。初步考虑哪些疾病?
问题 404
患者男性,26岁。因右眼被虾刺穿角巩膜缘部引起外伤性白内障, 于伤后35天行白内障摘除人工晶体植入术,手术顺利, 矫正视力4.9(0.8),但术后二周复查时发现术眼瞳孔缘有小结节, 人工晶体表面有沉着物。一月后因左眼视物模糊来诊。查:右眼角膜后大块沉着物, 瞳孔边缘有结节,人工晶体表面被沉着物部分覆盖。左眼轻度睫状充血, 黄斑部视网膜水肿,浅层脱离, 眼底周边可见黄白色脉络膜渗出点。最好应先进行哪些检查?
答案:
双眼周边视网膜检查;荧光造影检查;眼电生理检查;免疫学方面检查;血沉
问题 405
患者男性,26岁。因右眼被虾刺穿角巩膜缘部引起外伤性白内障, 于伤后35天行白内障摘除人工晶体植入术,手术顺利, 矫正视力4.9(0.8),但术后二周复查时发现术眼瞳孔缘有小结节, 人工晶体表面有沉着物。一月后因左眼视物模糊来诊。查:右眼角膜后大块沉着物, 瞳孔边缘有结节,人工晶体表面被沉着物部分覆盖。左眼轻度睫状充血, 黄斑部视网膜水肿,浅层脱离, 眼底周边可见黄白色脉络膜渗出点。应尽快作哪些处理?
答案:
按一般色素膜炎治疗;散瞳;口服大量水杨酸钠;使用广谱抗生素;皮质类固醇治疗;抗淋巴细胞血清
问题 406
患者男性,26岁。因右眼被虾刺穿角巩膜缘部引起外伤性白内障, 于伤后35天行白内障摘除人工晶体植入术,手术顺利, 矫正视力4.9(0.8),但术后二周复查时发现术眼瞳孔缘有小结节, 人工晶体表面有沉着物。一月后因左眼视物模糊来诊。查:右眼角膜后大块沉着物, 瞳孔边缘有结节,人工晶体表面被沉着物部分覆盖。左眼轻度睫状充血, 黄斑部视网膜水肿,浅层脱离, 眼底周边可见黄白色脉络膜渗出点。哪些情况易发生交感性眼炎?
答案:
穿通伤晚期愈合或不完全愈合的眼球;眼球穿通伤有色素膜或晶体嵌顿于伤口;球内有异物;睫状体区的伤口;眼内恶性肿瘤
问题 408
患者男性,26岁。因右眼被虾刺穿角巩膜缘部引起外伤性白内障, 于伤后35天行白内障摘除人工晶体植入术,手术顺利, 矫正视力4.9(0.8),但术后二周复查时发现术眼瞳孔缘有小结节, 人工晶体表面有沉着物。一月后因左眼视物模糊来诊。查:右眼角膜后大块沉着物, 瞳孔边缘有结节,人工晶体表面被沉着物部分覆盖。左眼轻度睫状充血, 黄斑部视网膜水肿,浅层脱离, 眼底周边可见黄白色脉络膜渗出点。交感性眼炎重要的临床症状有哪些?
答案:
穿孔性眼外伤,伤眼炎症长期不退,角膜后见沉着物;被交感眼的前部或后部葡萄膜发生同样炎症;初发症状是:有KP(+),房水中有细胞成份;视力急剧下降(交感眼);眼底网膜水肿,周边部葡萄膜炎或乳头炎
问题 409
患者男性,26岁。因右眼被虾刺穿角巩膜缘部引起外伤性白内障, 于伤后35天行白内障摘除人工晶体植入术,手术顺利, 矫正视力4.9(0.8),但术后二周复查时发现术眼瞳孔缘有小结节, 人工晶体表面有沉着物。一月后因左眼视物模糊来诊。查:右眼角膜后大块沉着物, 瞳孔边缘有结节,人工晶体表面被沉着物部分覆盖。左眼轻度睫状充血, 黄斑部视网膜水肿,浅层脱离, 眼底周边可见黄白色脉络膜渗出点。交感性眼炎重要的病理学改变有哪些?
答案:
交感眼与被交感眼的病理学改变完全相同;在葡萄膜,以单核细胞浸润为主;有类上皮细胞与巨细胞,呈结节性集合;约有25%与晶体蛋白过敏性葡萄膜炎共存
问题 410
患者男性,26岁。因右眼被虾刺穿角巩膜缘部引起外伤性白内障, 于伤后35天行白内障摘除人工晶体植入术,手术顺利, 矫正视力4.9(0.8),但术后二周复查时发现术眼瞳孔缘有小结节, 人工晶体表面有沉着物。一月后因左眼视物模糊来诊。查:右眼角膜后大块沉着物, 瞳孔边缘有结节,人工晶体表面被沉着物部分覆盖。左眼轻度睫状充血, 黄斑部视网膜水肿,浅层脱离, 眼底周边可见黄白色脉络膜渗出点。短时间全身皮质类固醇疗法必须遵循哪些原则?
答案:
初期大量投入;大量投入后逐渐减量;全身投入量渐减的同时,局部用量渐增;要考虑预防副作用的对策
问题 411
患者男性,26岁。因右眼被虾刺穿角巩膜缘部引起外伤性白内障, 于伤后35天行白内障摘除人工晶体植入术,手术顺利, 矫正视力4.9(0.8),但术后二周复查时发现术眼瞳孔缘有小结节, 人工晶体表面有沉着物。一月后因左眼视物模糊来诊。查:右眼角膜后大块沉着物, 瞳孔边缘有结节,人工晶体表面被沉着物部分覆盖。左眼轻度睫状充血, 黄斑部视网膜水肿,浅层脱离, 眼底周边可见黄白色脉络膜渗出点。皮质类固醇引起的全身性代谢性生理改变有哪些?
答案:
NaCl贮留;K与Ca排出增加;糖原合成脂肪动员消耗的增加;嗜酸细胞增加
问题 415
患者男性,28岁。在施工时, 右眼不慎溅入水泥半小时。处理措施是什么?
答案:
马上用清水冲洗眼部;冲洗时间尽量足够,至少维持30分钟以上;冲洗时需翻转眼睑,转动眼球彻底冲洗化学物质;冲洗眼部后送医院处理
问题 416
患者男性,28岁。在施工时, 右眼不慎溅入水泥半小时。提示:经现场处理后, 患者眼部的化学物质基本冲洗干净。后续治疗是什么?
答案:
使用胶原酶抑制剂;阿托品扩瞳;有时间限制的局部及全身使用激素;使用0.5%EDTA-2Na眼液;使用VitC;玻璃棒分离防止睑球粘连;局部及全身使用抗生素
问题 417
患者男性,28岁。在施工时, 右眼不慎溅入水泥半小时。提示:经药物治疗后, 角膜及结膜出现坏死。处理措施是什么?
答案:
并发症处理;角膜缘干细胞移植;羊膜移植;手术切除坏死组织;板层角膜移植
问题 418
患者男性,65岁。双眼视力逐渐减退5年, 近1年加重,行动困难。自视力减退以来, 有过怕光流泪及剧烈头痛、恶心、呕吐等病史。提示:双眼视力眼前手动。应作哪些必要的眼部检查帮助诊断?
答案:
视功能检查,包括光感、光定位、色觉;眼压;眼底;视网膜电图;裂隙灯检查眼前段
问题 419
患者男性,65岁。双眼视力逐渐减退5年, 近1年加重,行动困难。自视力减退以来, 有过怕光流泪及剧烈头痛、恶心、呕吐等病史。老年性白内障在与其它类型白内障作鉴别时病史方面应考虑询问什么?
答案:
视力减退的确切年龄;有无眼外伤史;视力减退的过程及症状;病程是否很短,如24小时即失明;是否有过手足搐搦史;是否患过色素膜炎;有无糖尿病史
问题 420
患者男性,65岁。双眼视力逐渐减退5年, 近1年加重,行动困难。自视力减退以来, 有过怕光流泪及剧烈头痛、恶心、呕吐等病史。老年性白内障的初发期可有哪些临床症状?
答案:
可无任何不适症状;复视或多视(单眼);出现虹视;眼前出现固定的小黑点
问题 421
患者男性,65岁。双眼视力逐渐减退5年, 近1年加重,行动困难。自视力减退以来, 有过怕光流泪及剧烈头痛、恶心、呕吐等病史。对视力减退为避免将其它眼病误诊白内障早期而延误治疗应做哪些必要检查?
答案:
必须详细询问病史;用裂隙灯鉴别虹视之性质;测眼压;用B超作眼部检查;散瞳查裂隙灯,检查晶体是否混浊;散瞳用彻照法查晶体是否透明;查眼底
问题 422
患者男性,65岁。双眼视力逐渐减退5年, 近1年加重,行动困难。自视力减退以来, 有过怕光流泪及剧烈头痛、恶心、呕吐等病史。提示:右眼视功能检查3万l光定位鼻侧(-), 色觉红、绿色正常。眼压18mmHg,眼位正, 双眼无眼球震颤。右眼视功能不佳可能发生的原因有哪些?
答案:
眼底有视网膜血管病如视网膜中央静脉颞上枝阻塞;眼内肿瘤;视网膜脱离
问题 423
患者男性,65岁。双眼视力逐渐减退5年, 近1年加重,行动困难。自视力减退以来, 有过怕光流泪及剧烈头痛、恶心、呕吐等病史。老年白内障成熟期手术禁忌证有哪些?
答案:
视功能差,光感及光定位不确者;频繁发作心绞痛;角膜炎症
问题 424
患者男性,65岁。双眼视力逐渐减退5年, 近1年加重,行动困难。自视力减退以来, 有过怕光流泪及剧烈头痛、恶心、呕吐等病史。单眼无晶体眼如何矫正视力达到双眼单视?
答案:
戴角膜接触镜;人工晶体植入;角膜表层镜片术
问题 425
患者男性,65岁。双眼视力逐渐减退5年, 近1年加重,行动困难。自视力减退以来, 有过怕光流泪及剧烈头痛、恶心、呕吐等病史。如何防止白内障摘出过程中出现并发症?
答案:
降低眼压(术前);必须做好眼局部的麻醉包括球后注射,眼轮匝肌麻醉务必正确;应用超声晶体乳化术(如有仪器);采用现代囊外摘除手术取代原先的白内障囊外或囊内摘出手术
问题 426
患者,男性, 35岁。因双眼睑肿胀、眼球突出3个月来诊。眼部检查Vod 1.2 vos 1.2,双眼睑轻度肿胀, 无明显压痛,眶缘未触及明显肿物, 眼球突出度右眼19mm,左眼18mm, 眼球运动正常,眼球检查基本正常。该患者需要考虑哪些疾病的诊断与鉴别诊断?
答案:
该患者是双眼发病,以眼睑肿胀和眼球突出为特征,需要考虑引起双眼眶病变的疾病,如甲状腺相关眼病、炎性假瘤。
问题 429
病历摘要:某男, 65岁,因右眼视力渐进性下降三年, 不见物二个月,不伴有红痛症状, 家族无传染病及遗传病史,全身无特殊不适。你认为最可能是何种眼病?
问题 430
病历摘要:某男, 65岁,因右眼视力渐进性下降三年, 不见物二个月,不伴有红痛症状, 家族无传染病及遗传病史,全身无特殊不适。为进一步诊疗, 你认为还需要作哪些检查?提示: 病人右眼视力:手动/20cm, 右眼角膜透明,前房未见异常, 晶体明显混浊,眼底不能窥见。
问题 431
病历摘要:某男, 65岁,因右眼视力渐进性下降三年, 不见物二个月,不伴有红痛症状, 家族无传染病及遗传病史,全身无特殊不适。就目前情况, 你认为应该采取哪些处理措施?提示: 病人超声波检查发现玻璃体混浊,并出现眼球前壁有相连光带, 散瞳检查眼底极为模糊。
答案:
白内障术后仔细检查眼底,寻找视网膜裂孔,再择期手术;用超声乳化摘除晶体,联合折叠式人工晶体植入术
问题 432
病历摘要:某男, 65岁,因右眼视力渐进性下降三年, 不见物二个月,不伴有红痛症状, 家族无传染病及遗传病史,全身无特殊不适。根据病人目前情况, 你认为采用何种治疗措施较妥?提示: 病人白内障术后眼底检查见上方视网膜脱离,并见马蹄形裂孔。
答案:
裂孔处巩膜冷凝、视网膜下放液加巩膜外加压术
问题 433
病历摘要:某男, 65岁,因右眼视力渐进性下降三年, 不见物二个月,不伴有红痛症状, 家族无传染病及遗传病史,全身无特殊不适。你认为可能是哪种情况出现? 提示:病人八个月后出现视力下降, 检查视力仅为0.1,B超检查视网膜平伏。
问题 434
病历摘要:某男, 65岁,因右眼视力渐进性下降三年, 不见物二个月,不伴有红痛症状, 家族无传染病及遗传病史,全身无特殊不适。你认为应该采取哪些处理措施? 提示:病者右眼经后囊膜YAG激光切开术后, 视力又提高至0.5。
答案:
病人术后可口服一些消炎痛类药物止痛;适当应用一些降眼压类药
问题 435
病历摘要:某男, 65岁,因右眼视力渐进性下降三年, 不见物二个月,不伴有红痛症状, 家族无传染病及遗传病史,全身无特殊不适。应该如何处理这些裂孔? 提示:病人术后复查时发现上方周边视网膜出现干性裂孔。
问题 436
病历摘要:某男, 65岁,因右眼视力渐进性下降三年, 不见物二个月,不伴有红痛症状, 家族无传染病及遗传病史,全身无特殊不适。病人行视网膜激光光凝术后, 应采取哪些措施?提示: 病人经用激光光凝视网膜后,视网膜未见脱离。
答案:
让病人定期复查眼底;让病人服用一些维生素类物质;口服些消炎止痛类药物,减轻术眼部疼痛;病人多休息
问题 437
患者男性,42岁。左眼外伤后睁眼因难1小时, 检查见左侧眉弓有一15mm横形裂伤,深达眶骨膜, 眼睑轻度肿胀。提示:上睑缘遮盖瞳孔上3/4, 结膜下片状出血。应诊断为?
答案:
左上睑皮肤裂伤;左球结膜挫伤;左提上睑肌断裂
问题 438
患者男性,42岁。左眼外伤后睁眼因难1小时, 检查见左侧眉弓有一15mm横形裂伤,深达眶骨膜, 眼睑轻度肿胀。辅助检查包括哪些?
问题 439
患者男性,42岁。左眼外伤后睁眼因难1小时, 检查见左侧眉弓有一15mm横形裂伤,深达眶骨膜, 眼睑轻度肿胀。治疗措施包括哪些?
答案:
涂抗生素眼膏;滴抗生素眼液;全身用抗生素;手术治疗
问题 440
患者男性,52岁。因左眼单纯疱疹角膜炎导致视力减退, 行穿透性角膜移植术。急性炎症已消退6个月。供体符合要求,行常规手术。术后前3天植片透明, 第4天角膜上皮出现水肿,植片透明度降低, 基质厚度增加,房水混浊, 受体角膜透明,眼压20mmHg。最可能的诊断是什么?
问题 441
患者男性,52岁。因左眼单纯疱疹角膜炎导致视力减退, 行穿透性角膜移植术。急性炎症已消退6个月。供体符合要求,行常规手术。术后前3天植片透明, 第4天角膜上皮出现水肿,植片透明度降低, 基质厚度增加,房水混浊, 受体角膜透明,眼压20mmHg。需要鉴别的疾病有哪些?
答案:
角膜基质炎;原发性角膜内皮失代偿;移植排斥反应
问题 442
患者男性,52岁。因左眼单纯疱疹角膜炎导致视力减退, 行穿透性角膜移植术。急性炎症已消退6个月。供体符合要求,行常规手术。术后前3天植片透明, 第4天角膜上皮出现水肿,植片透明度降低, 基质厚度增加,房水混浊, 受体角膜透明,眼压20mmHg。如果治疗, 可采用?
问题 443
患者男性,64岁, 突然右眼黑朦半小时就诊。无头疼、恶心、呕吐。既往有高血压病史20余年。查体:血压170/95mmHg, 右眼视力光感,左眼视力1.0。为明确诊断, 目前应该做哪些必要的检查?
问题 444
患者男性,64岁, 突然右眼黑朦半小时就诊。无头疼、恶心、呕吐。既往有高血压病史20余年。查体:血压170/95mmHg, 右眼视力光感,左眼视力1.0。提示: 裂隙灯检查双眼前节正常,晶体轻度混浊, 玻璃体透明。眼底:右眼视盘色白, 边缘模糊,视网膜后极部弥漫性乳白色水肿, 黄斑区呈樱桃红色,中心凹光反射不清, 视网膜动脉极细,左眼视网膜动脉细, 反光增强,可见动-静脉交叉压迹。患者目前的诊断应考虑为哪些?
答案:
右眼视网膜中央动脉阻塞;双眼老年性白内障;双眼高血压视网膜病变
问题 445
患者男性,64岁, 突然右眼黑朦半小时就诊。无头疼、恶心、呕吐。既往有高血压病史20余年。查体:血压170/95mmHg, 右眼视力光感,左眼视力1.0。提示: 初步诊断为右眼视网膜中央动脉阻塞。急救应采用哪些处理措施?
答案:
吸入亚硝酸异戊酯;含化硝酸甘油片;球后注射2%利多卡因2ml+妥拉苏林12.5mg;按摩眼球;全身应用血管扩张剂;静脉滴注20%甘露醇注射液
问题 446
患者男性,64岁, 突然右眼黑朦半小时就诊。无头疼、恶心、呕吐。既往有高血压病史20余年。查体:血压170/95mmHg, 右眼视力光感,左眼视力1.0。提示: 经急救处理后2小时,患者右眼逐渐恢复光感。收入院治疗。收入院后还要进行哪些处理?
答案:
血生化检查;心电图;继续应用血管扩张剂;高压氧治疗;中药
问题 447
患者男性,64岁, 突然右眼黑朦半小时就诊。无头疼、恶心、呕吐。既往有高血压病史20余年。查体:血压170/95mmHg, 右眼视力光感,左眼视力1.0。提示: 入院后1天,患者病情平稳, 用降血压药后血压正常,心电图正常, 拟行眼底荧光血管造影检查。视网膜中央动脉阻塞的眼底荧光血管造影可能有哪些表现?
答案:
视网膜动脉无灌注;视网膜动脉充盈迟缓;黄斑周围动脉小分枝无灌注
问题 448
患者男性,64岁, 突然右眼黑朦半小时就诊。无头疼、恶心、呕吐。既往有高血压病史20余年。查体:血压170/95mmHg, 右眼视力光感,左眼视力1.0。视网膜中央动脉阻塞疾病的发展及预后可能是?
答案:
患眼视力完全丧失;若抢救及时得当,可保留一定的视力;视力的恢复程度与动脉阻塞的部位有关;可造成大范围的视野缺损
问题 449
患者男性,32岁, 双眼视力逐渐下降3年,加重6月。眼部检查: 视力Vod 0.5 Jr1,Vos0.2 Jr4; 双眼球结膜无充血,角膜透明, 前房轴深正常。周深1.5CT,瞳孔圆形, 直径4mm,晶状体及玻璃体透明, 视网膜无明显异常,眼压右28mmHg, 左42mmHg。否认青光眼家族史。有助于明确诊断和指导治疗的检查有哪些?
问题 450
患者男性,32岁, 双眼视力逐渐下降3年,加重6月。眼部检查: 视力Vod 0.5 Jr1,Vos0.2 Jr4; 双眼球结膜无充血,角膜透明, 前房轴深正常。周深1.5CT,瞳孔圆形, 直径4mm,晶状体及玻璃体透明, 视网膜无明显异常,眼压右28mmHg, 左42mmHg。否认青光眼家族史。提示:该患者左眼经用多种药物治疗, 眼压仍无法控制正常,需手术治疗。对于左眼, 可选择的手术有?
答案:
非穿透性小梁手术联合应用抗代谢药物;小梁切除术联合应用抗代谢药物
问题 451
患者男性,32岁, 双眼视力逐渐下降3年,加重6月。眼部检查: 视力Vod 0.5 Jr1,Vos0.2 Jr4; 双眼球结膜无充血,角膜透明, 前房轴深正常。周深1.5CT,瞳孔圆形, 直径4mm,晶状体及玻璃体透明, 视网膜无明显异常,眼压右28mmHg, 左42mmHg。否认青光眼家族史。提示:患者左眼接受滤过性手术, 手术作以穹隆部为基底的结膜瓣。术后第一天,左眼视力: 0.02Ⅱ度浅前房,瞳孔直径5mm, 眼压TA 4mmHg。该患者左眼术后的并发症可能有?
答案:
睫状体脉络膜脱离;脉络膜上腔出血;并发性白内障;滤过泡渗漏;滤过道引流过畅
问题 452
患者男性,32岁, 双眼视力逐渐下降3年,加重6月。眼部检查: 视力Vod 0.5 Jr1,Vos0.2 Jr4; 双眼球结膜无充血,角膜透明, 前房轴深正常。周深1.5CT,瞳孔圆形, 直径4mm,晶状体及玻璃体透明, 视网膜无明显异常,眼压右28mmHg, 左42mmHg。否认青光眼家族史。提示:患者左眼已出现常见的滤过性手术并发症, 需积极处理如处理不当,可能出现的严重并发症有哪些?
答案:
广泛周边虹膜前粘连;白内障加速发展和形成;低眼压性黄斑病变;滤过泡疤痕化;前房积血;角膜内皮失代偿
问题 453
患者男性,34岁。无明显诱因出现左眼视力下降, 伴眼部疼痛,畏光, 流泪1个月。检查左眼眼睑痉挛,角膜见一约3mm大小角膜水肿溃疡病灶, 角膜后KP(+),前房及后节无异常。有帮助诊断及指导治疗价值的检查是?
答案:
细菌培养加药物敏感试验;PCR技术;角膜刮片;真菌培养;角膜共焦显微镜
问题 454
患者男性,34岁。无明显诱因出现左眼视力下降, 伴眼部疼痛,畏光, 流泪1个月。检查左眼眼睑痉挛,角膜见一约3mm大小角膜水肿溃疡病灶, 角膜后KP(+),前房及后节无异常。提示: 细菌培养阴性,角膜刮片找到菌丝。可以确定的诊断是?
问题 455
患者男性,34岁。无明显诱因出现左眼视力下降, 伴眼部疼痛,畏光, 流泪1个月。检查左眼眼睑痉挛,角膜见一约3mm大小角膜水肿溃疡病灶, 角膜后KP(+),前房及后节无异常。提示: 细菌培养阴性,角膜刮片找到菌丝。治疗是?
答案:
必要时手术;阿托品扩瞳;全身使用抗真菌药;局部使用抗真菌药
问题 458
患者男性,28岁。因盛氨水容器爆炸, 氨水溅入双眼,当时感眼痛、流泪、视物不清。提示: 眼部检查见双眼中度红肿,睁眼困难, 睑球结膜轻度充血,球结膜中度水肿, 角膜混浊.水肿,隐约见虹膜纹理及瞳孔。荧光素染色见大片角膜上皮剥脱着色, 余结构不清。8小时之内还需进一步做哪些处理?
答案:
彻底冲洗结膜囊;清除坏死结膜组织,放射状切开球结膜,结膜下冲洗;结膜下注射维生素C;阿托品散瞳
问题 459
患者男性,28岁。因盛氨水容器爆炸, 氨水溅入双眼,当时感眼痛、流泪、视物不清。化学性眼烧伤早期并发症有哪些?
答案:
眼、球结膜坏死;前葡萄膜炎;角膜溃疡;角膜穿孔
问题 460
患者男性,28岁。因盛氨水容器爆炸, 氨水溅入双眼,当时感眼痛、流泪、视物不清。入院后早期需要进行哪些治疗?
答案:
泪液代用品点眼;全身使用抗生素;结膜抹涂大量抗生素眼膏;降眼压
问题 461
患者,女性, 58岁,右眼视物不清, 眼前固定黑影3天。3天前患者无明显诱因晨起后出现右眼视物模糊,眼前黑影, 相对固定,1天后未能缓解, 黑影逐渐增大,变暗, 发展为上半侧黑影。无畏光、流泪,无眼红、眼痛。患者否认心脏病、糖尿病、高血压等全身病史。平时血压偏低。眼科检查: VOD0.3,VOS1.0, 双眼前段正常。根据上述症状,需要哪些检查?
答案:
散瞳孔检查双眼、小瞳下直接检眼镜。根据患者的症状,青光眼基本可以排除,多考虑眼底问题,如果直接检眼镜能发现问题最好,但是直接检眼镜所能见到的眼底范围有限,对于中周部的眼底病变较容易漏诊,而且眼底病有些为双眼病变,部分单眼病变,双眼检查可双眼对照比较,比如视神经的病变。
问题 462
患者,女性, 58岁,右眼视物不清, 眼前固定黑影3天。3天前患者无明显诱因晨起后出现右眼视物模糊,眼前黑影, 相对固定,1天后未能缓解, 黑影逐渐增大,变暗, 发展为上半侧黑影。无畏光、流泪,无眼红、眼痛。患者否认心脏病、糖尿病、高血压等全身病史。平时血压偏低。眼科检查: VOD0.3,VOS1.0, 双眼前段正常。根据患者症状,多考虑哪些疾病?
答案:
玻璃体积血、视网膜脱离、老年黄斑变性、视网膜分支动脉阻塞、视神经病变。上述病变都是老年人经常出现的眼底病变,都可以出现眼前固定黑影,所以检查眼底时,要注意观察相应眼底部位,以逐一排除。
问题 463
患者,女性, 58岁,右眼视物不清, 眼前固定黑影3天。3天前患者无明显诱因晨起后出现右眼视物模糊,眼前黑影, 相对固定,1天后未能缓解, 黑影逐渐增大,变暗, 发展为上半侧黑影。无畏光、流泪,无眼红、眼痛。患者否认心脏病、糖尿病、高血压等全身病史。平时血压偏低。眼科检查: VOD0.3,VOS1.0, 双眼前段正常。根据上述描述,最有可能的疾病是?
问题 464
患者,女性, 58岁,右眼视物不清, 眼前固定黑影3天。3天前患者无明显诱因晨起后出现右眼视物模糊,眼前黑影, 相对固定,1天后未能缓解, 黑影逐渐增大,变暗, 发展为上半侧黑影。无畏光、流泪,无眼红、眼痛。患者否认心脏病、糖尿病、高血压等全身病史。平时血压偏低。眼科检查: VOD0.3,VOS1.0, 双眼前段正常。这个患者做哪些进一步检查以明确诊断?
答案:
视野。前段缺血性视神经病变的视野改变是比较有特征性的,多数为弓形暗点或象限性视野缺损,对诊断有价值。
问题 465
患者,女性, 58岁,右眼视物不清, 眼前固定黑影3天。3天前患者无明显诱因晨起后出现右眼视物模糊,眼前黑影, 相对固定,1天后未能缓解, 黑影逐渐增大,变暗, 发展为上半侧黑影。无畏光、流泪,无眼红、眼痛。患者否认心脏病、糖尿病、高血压等全身病史。平时血压偏低。眼科检查: VOD0.3,VOS1.0, 双眼前段正常。进一步治疗是?
答案:
改善全身情况;神经生长因子;视神经营养药物;血管扩张药物
问题 466
患者男性,57岁。左眼视力下降伴视物变形1周。视力: 右眼1.0;左眼0.1。眼底检查发现左眼黄斑区视网膜下片状出血。该患者需要做哪些眼科检查?
问题 467
患者男性,57岁。左眼视力下降伴视物变形1周。视力: 右眼1.0;左眼0.1。眼底检查发现左眼黄斑区视网膜下片状出血。左眼最可能的诊断是什么?
问题 468
患者男性,57岁。左眼视力下降伴视物变形1周。视力: 右眼1.0;左眼0.1。眼底检查发现左眼黄斑区视网膜下片状出血。可选的治疗方法有哪些?
答案:
玻璃体内注射Macugen;光动力疗法联合玻璃体内注射抗VEGF制剂;经瞳孔温热疗法;玻璃体内注射Lucentis;光动力疗法;玻璃体切割术
问题 469
患者女性,57岁。诉右眼视力突然下降3个月。患者既往有2型糖尿病史10年, 高血压史8年。检查:血压150/90mmHg; 视力vod HM/眼前,矫正无助; Vos0.4矫正0.6。双眼晶体周边皮质轻度混浊,右眼玻璃体积血, 眼底看不见,左眼玻璃体无混浊, 眼底视网膜见散在点片状出血,血管瘤, 硬性及软性渗出,出血及渗出累及黄斑, 黄斑中心凹反光消失。为进一步处理,尚需做的检查有哪些?
问题 470
患者女性,57岁。诉右眼视力突然下降3个月。患者既往有2型糖尿病史10年, 高血压史8年。检查:血压150/90mmHg; 视力vod HM/眼前,矫正无助; Vos0.4矫正0.6。双眼晶体周边皮质轻度混浊,右眼玻璃体积血, 眼底看不见,左眼玻璃体无混浊, 眼底视网膜见散在点片状出血,血管瘤, 硬性及软性渗出,出血及渗出累及黄斑, 黄斑中心凹反光消失。按糖尿病视网膜病变分期标准,右眼的分期是?
问题 471
患者女性,57岁。诉右眼视力突然下降3个月。患者既往有2型糖尿病史10年, 高血压史8年。检查:血压150/90mmHg; 视力vod HM/眼前,矫正无助; Vos0.4矫正0.6。双眼晶体周边皮质轻度混浊,右眼玻璃体积血, 眼底看不见,左眼玻璃体无混浊, 眼底视网膜见散在点片状出血,血管瘤, 硬性及软性渗出,出血及渗出累及黄斑, 黄斑中心凹反光消失。提示:患者右眼行玻璃体切割及光凝术, 1个月后,再改发生玻璃体出血。可能的原因是?
问题 472
患者女性,57岁。诉右眼视力突然下降3个月。患者既往有2型糖尿病史10年, 高血压史8年。检查:血压150/90mmHg; 视力vod HM/眼前,矫正无助; Vos0.4矫正0.6。双眼晶体周边皮质轻度混浊,右眼玻璃体积血, 眼底看不见,左眼玻璃体无混浊, 眼底视网膜见散在点片状出血,血管瘤, 硬性及软性渗出,出血及渗出累及黄斑, 黄斑中心凹反光消失。提示:患者右眼行玻璃体切割及光凝术, 1个月后,再次发生玻璃体出血。右眼玻璃体切割及光凝手术后第天, 患者诉眼痛、流泪,应考虑的原因有哪些?
问题 473
患者男性,38岁。因复视, 右眼眼球突出5个月而就诊。逐渐出现眼红,睑浮肿, 偶有胀痛。眼球突出及红痛有时缓解,但隔数周会加重。无怕热、多汗、多食、体重减轻症状。检查: 压迫右眼入眶有阻力,未扪得眶内肿块及颈部淋巴结。应考虑先作哪些检查?
答案:
视力;屈光;眼球突出度;眼底;眼眶正侧位X线片;眼球运动
问题 474
患者男性,38岁。因复视, 右眼眼球突出5个月而就诊。逐渐出现眼红,睑浮肿, 偶有胀痛。眼球突出及红痛有时缓解,但隔数周会加重。无怕热、多汗、多食、体重减轻症状。检查: 压迫右眼入眶有阻力,未扪得眶内肿块及颈部淋巴结。提示: 右眼视力4.5(0.4),左眼5.1(1.2)。右眼+2.00DS视力增至4.8(0.7), 突眼度右眼超出左眼4mm。眼底检查视网膜后极部有张力线。右眼向颞及上、下方注视均略受限制。眼睑闭合良好应进一步作哪些检查?
答案:
眼眶A、B型超声扫描;眼眶CT扫描;口服皮质类固醇后观察病情
问题 475
患者男性,38岁。因复视, 右眼眼球突出5个月而就诊。逐渐出现眼红,睑浮肿, 偶有胀痛。眼球突出及红痛有时缓解,但隔数周会加重。无怕热、多汗、多食、体重减轻症状。检查: 压迫右眼入眶有阻力,未扪得眶内肿块及颈部淋巴结。提示: 超声及CT检查眶后部有占位性病变。口服皮质类固醇一周后,眼球胀痛减轻, 结膜充血稍减退,突眼度无明显改变。目前诊断考虑为?
问题 476
患者男性,38岁。因复视, 右眼眼球突出5个月而就诊。逐渐出现眼红,睑浮肿, 偶有胀痛。眼球突出及红痛有时缓解,但隔数周会加重。无怕热、多汗、多食、体重减轻症状。检查: 压迫右眼入眶有阻力,未扪得眶内肿块及颈部淋巴结。应如何治疗?
答案:
全身使用皮质类固醇和抗生素;若危及视力应开眶切除占位性病变
问题 477
患者男性,38岁。因复视, 右眼眼球突出5个月而就诊。逐渐出现眼红,睑浮肿, 偶有胀痛。眼球突出及红痛有时缓解,但隔数周会加重。无怕热、多汗、多食、体重减轻症状。检查: 压迫右眼入眶有阻力,未扪得眶内肿块及颈部淋巴结。提示: 治疗后右眼结膜充血,轻度水肿, 眼球突出度大于左眼6mm,眼睑闭合不全, 下1/4角膜混浊。目前对右眼主要应进行哪些检查?
答案:
角膜荧光素染色;眼球运动;眼眶A 、E型超声扫描;眼眶CT扫描;取肿块作活组织检查;视力检查;眼底检查
问题 478
患者男性,38岁。因复视, 右眼眼球突出5个月而就诊。逐渐出现眼红,睑浮肿, 偶有胀痛。眼球突出及红痛有时缓解,但隔数周会加重。无怕热、多汗、多食、体重减轻症状。检查: 压迫右眼入眶有阻力,未扪得眶内肿块及颈部淋巴结。提示: 右眼视力4.5(0.3),角膜下方1/5F1(+), 眼球运动各方向均受限制,后极部视网膜有张力线。B超示眶后部占位性病变, 眼肌肥大。活检病理诊断为炎性肉芽肿。应先采取哪些处置?
答案:
全身使用皮质类固醇和抗生素;涂抗生素眼膏纱布覆盖;睑缘缝合术
问题 479
患者男性,42岁, 右眼翼状胬肉切除术后2个月出现术眼轻度胀痛,视物模糊。检查: Vod0.8,Vos1.2, 右眼轻度充血,角膜轻度云雾状水肿, 周边前房约1CT,眼底C/D=0.4, 左眼前节正常,眼底C/D=0.4。该病人还需做哪些眼部检查?
问题 480
患者男性,42岁, 右眼翼状胬肉切除术后2个月出现术眼轻度胀痛,视物模糊。检查: Vod0.8,Vos1.2, 右眼轻度充血,角膜轻度云雾状水肿, 周边前房约1CT,眼底C/D=0.4, 左眼前节正常,眼底C/D=0.4。该病人右眼眼压38mmHg, 前房角为宽角。追问病史,胬肉术后一直点用典必殊未停。最可能的诊断是什么?
问题 481
患者男性,42岁, 右眼翼状胬肉切除术后2个月出现术眼轻度胀痛,视物模糊。检查: Vod0.8,Vos1.2, 右眼轻度充血,角膜轻度云雾状水肿, 周边前房约1CT,眼底C/D=0.4, 左眼前节正常,眼底C/D=0.4。明确诊断后应首先采取哪些治疗措施?
问题 482
患者女性,32岁。诉右眼红, 疼痛,视物模糊1周。1个月前患带状疱疹(腰部)。眼科检查: 视力右0.4,矫正无助; 左1.2。右眼睫状充血,角膜后羊脂状KP, Tydall(+),瞳孔等大正圆, 晶体透明,玻璃体内可见中等量炎性细胞。眼底: 视盘轻度充血,界清, 视网膜轻度水肿,动脉细, 周边及中周部动脉呈白线,有白鞘, 周边部视网膜可见片状黄白色渗出灶及点片状出血。该患者最可能的诊断为?
问题 483
患者女性,32岁。诉右眼红, 疼痛,视物模糊1周。1个月前患带状疱疹(腰部)。眼科检查: 视力右0.4,矫正无助; 左1.2。右眼睫状充血,角膜后羊脂状KP, Tydall(+),瞳孔等大正圆, 晶体透明,玻璃体内可见中等量炎性细胞。眼底: 视盘轻度充血,界清, 视网膜轻度水肿,动脉细, 周边及中周部动脉呈白线,有白鞘, 周边部视网膜可见片状黄白色渗出灶及点片状出血。该病荧光眼底血管造影的表现有哪些?
答案:
晚期视盘高荧光;部分视网膜呈斑驳状强荧光;动静脉充盈迟缓,动脉节段充盈,血管壁有荧光素渗漏
问题 484
患者女性,32岁。诉右眼红, 疼痛,视物模糊1周。1个月前患带状疱疹(腰部)。眼科检查: 视力右0.4,矫正无助; 左1.2。右眼睫状充血,角膜后羊脂状KP, Tydall(+),瞳孔等大正圆, 晶体透明,玻璃体内可见中等量炎性细胞。眼底: 视盘轻度充血,界清, 视网膜轻度水肿,动脉细, 周边及中周部动脉呈白线,有白鞘, 周边部视网膜可见片状黄白色渗出灶及点片状出血。目前该患者的治疗方式是?
答案:
全身应用抗病毒药;全身应用激素;玻璃体切割术;在正常视网膜与病变区交界处行激光光凝术
问题 485
患者男性,38岁。右眼剧烈眼痛, 畏光,流泪及视力下降, 检查见混合性充血,颞侧明显, 角膜点至点周边部基质层出现浸润。
1.最可能的诊断为?
2.如果需要, 需进一步检查的项目有哪些?
3.需鉴别的疾病有哪些?
4.治疗措施有哪些?
答案:
1.蚕蚀性角膜溃疡。
2.风湿因子;血常规;尿常规;抗核抗体。
3.带状角膜变性;真菌性角膜炎;细菌性角膜炎;Terrien角膜边缘变性。
4.FK-506点眼;环抱素A点眼;板层角膜移植;局部皮质类固醇点眼;2%半胱氨酸眼液点眼。
问题 490
患者男性,32岁。左眼被歹徒用小刀刺伤2小时, 伴疼痛及视力障碍,于当晚9时急诊入院。既往体健, 无眼病史。查体:意识清, T:37℃, P:74次/分, R:27次/分, BP:135/mmHg, 视力右1.5,左手动/眼前10cm, 左眼结膜充血及外侧结膜下出血,角膜缘2点外6mm处有一垂直于角膜缘的6mm长结膜, 巩膜伤口,伤口内嵌有葡萄膜组织, 角膜透明,前房积血, 余组织不能窥见。提示:拟急诊手术。该患者作何种手术最理想?
答案:
脱出葡萄膜还纳,结膜和巩膜伤口缝合及局部电凝术
问题 491
患者男性,32岁。左眼被歹徒用小刀刺伤2小时, 伴疼痛及视力障碍,于当晚9时急诊入院。既往体健, 无眼病史。查体:意识清, T:37℃, P:74次/分, R:27次/分, BP:135/mmHg, 视力右1.5,左手动/眼前10cm, 左眼结膜充血及外侧结膜下出血,角膜缘2点外6mm处有一垂直于角膜缘的6mm长结膜, 巩膜伤口,伤口内嵌有葡萄膜组织, 角膜透明,前房积血, 余组织不能窥见。提示:入院后10天伤口对合良好, 前房积血已大部分吸收,但视力仍不增加(手动/25cm)。该患者视力不增进的原因有哪些?
答案:
继发性青光眼;外伤性白内障;玻璃体积血;视网膜脱离
问题 492
患者男性,32岁。左眼被歹徒用小刀刺伤2小时, 伴疼痛及视力障碍,于当晚9时急诊入院。既往体健, 无眼病史。查体:意识清, T:37℃, P:74次/分, R:27次/分, BP:135/mmHg, 视力右1.5,左手动/眼前10cm, 左眼结膜充血及外侧结膜下出血,角膜缘2点外6mm处有一垂直于角膜缘的6mm长结膜, 巩膜伤口,伤口内嵌有葡萄膜组织, 角膜透明,前房积血, 余组织不能窥见。提示:用Schiotz氏眼压计测眼压: 右2mmHg,左21mmHg。该患者视力障碍应进一步作哪些检查才能明确原因?
问题 493
患者男性,32岁。左眼被歹徒用小刀刺伤2小时, 伴疼痛及视力障碍,于当晚9时急诊入院。既往体健, 无眼病史。查体:意识清, T:37℃, P:74次/分, R:27次/分, BP:135/mmHg, 视力右1.5,左手动/眼前10cm, 左眼结膜充血及外侧结膜下出血,角膜缘2点外6mm处有一垂直于角膜缘的6mm长结膜, 巩膜伤口,伤口内嵌有葡萄膜组织, 角膜透明,前房积血, 余组织不能窥见。提示:B超显示晶体, 玻璃体混浊,无视网膜脱离, PVEP未引出波形(健眼波幅为17uv,潜伏期98ms)FVEP波幅8uv, 潜伏期87ms。为了增进视力最有效的处理是什么?
问题 494
患者男性,32岁。左眼被歹徒用小刀刺伤2小时, 伴疼痛及视力障碍,于当晚9时急诊入院。既往体健, 无眼病史。查体:意识清, T:37℃, P:74次/分, R:27次/分, BP:135/mmHg, 视力右1.5,左手动/眼前10cm, 左眼结膜充血及外侧结膜下出血,角膜缘2点外6mm处有一垂直于角膜缘的6mm长结膜, 巩膜伤口,伤口内嵌有葡萄膜组织, 角膜透明,前房积血, 余组织不能窥见。哪些疾病是眼后节玻璃体切割术的适应证?
答案:
眼球穿通伤合并玻璃体积血及网膜脱离;眼球内非磁性异物伤;玻璃体机化及网膜前膜
问题 495
患者男性,32岁。左眼被歹徒用小刀刺伤2小时, 伴疼痛及视力障碍,于当晚9时急诊入院。既往体健, 无眼病史。查体:意识清, T:37℃, P:74次/分, R:27次/分, BP:135/mmHg, 视力右1.5,左手动/眼前10cm, 左眼结膜充血及外侧结膜下出血,角膜缘2点外6mm处有一垂直于角膜缘的6mm长结膜, 巩膜伤口,伤口内嵌有葡萄膜组织, 角膜透明,前房积血, 余组织不能窥见。提示:该患者经晶体, 玻璃体切割及IOL植入术后,视力已达1.0, 但术后一周视力又下降至0.5,炎症一直不消退。而且未伤眼也突然出现怕光流泪视远物不清, 试镜:-1.25DS→1.2以上情况应首先考虑什么病?
问题 496
患者男性,32岁。左眼被歹徒用小刀刺伤2小时, 伴疼痛及视力障碍,于当晚9时急诊入院。既往体健, 无眼病史。查体:意识清, T:37℃, P:74次/分, R:27次/分, BP:135/mmHg, 视力右1.5,左手动/眼前10cm, 左眼结膜充血及外侧结膜下出血,角膜缘2点外6mm处有一垂直于角膜缘的6mm长结膜, 巩膜伤口,伤口内嵌有葡萄膜组织, 角膜透明,前房积血, 余组织不能窥见。提示:经过几天观察, 双眼的视力继续下降,初步诊断为交感性眼炎。哪些是临床诊断交感性眼炎的依据?
答案:
外伤或手术史;双眼视力迅速下降;双眼先后出现葡萄膜炎;眼底发现Dalen-Fuchs结节;来伤眼有羊脂状柳;荧光造影显示乳头水肿
问题 497
患者男性,32岁。左眼被歹徒用小刀刺伤2小时, 伴疼痛及视力障碍,于当晚9时急诊入院。既往体健, 无眼病史。查体:意识清, T:37℃, P:74次/分, R:27次/分, BP:135/mmHg, 视力右1.5,左手动/眼前10cm, 左眼结膜充血及外侧结膜下出血,角膜缘2点外6mm处有一垂直于角膜缘的6mm长结膜, 巩膜伤口,伤口内嵌有葡萄膜组织, 角膜透明,前房积血, 余组织不能窥见。提示:拟对交感性眼炎进行抢救。可选择哪些方法进行抢救?
答案:
全身及局部用大量皮质类固醇;抗生素、维生素;散瞳;免疫抑制剂
问题 517
患儿女,10岁。因双眼视力逐渐下降2年来就诊。无夜盲史。检查: 双眼视力为0.1,验光结果: OD:-1.5 DS、OS: -1.75 DS,双眼矫正视力0.2; 外眼正常,屈光间质透明, 眼底检查未见异常。为进一步诊断,应进行的检查有哪些?
问题 518
患儿女,10岁。因双眼视力逐渐下降2年来就诊。无夜盲史。检查: 双眼视力为0.1,验光结果: OD:-1.5 DS、OS: -1.75 DS,双眼矫正视力0.2; 外眼正常,屈光间质透明, 眼底检查未见异常。目前主要考虑的诊断包括?(提示: FFA显示脉络膜湮灭。)
问题 520
患儿女,10岁。因双眼视力逐渐下降2年来就诊。无夜盲史。检查: 双眼视力为0.1,验光结果: OD:-1.5 DS、OS: -1.75 DS,双眼矫正视力0.2; 外眼正常,屈光间质透明, 眼底检查未见异常。你主要考虑的疾病是?(提示: 半年后随访观察,患者双眼视力下降到0.06, 眼底检查:双眼黄斑颞侧视网膜出现散在黄色斑点, 黄斑色泽正常,中心凹光反射略减弱, 其余同初诊时眼底改变。FFA检查:除脉络膜湮灭征征象外。双眼黄斑区及对应于黄斑颞侧的黄色斑点处, 出现了斑点状“窗样缺损”荧光损害,荧光异常范围大于眼底检查所见范围。)
问题 521
患儿女,10岁。因双眼视力逐渐下降2年来就诊。无夜盲史。检查: 双眼视力为0.1,验光结果: OD:-1.5 DS、OS: -1.75 DS,双眼矫正视力0.2; 外眼正常,屈光间质透明, 眼底检查未见异常。该患者的诊断是?
问题 528
患者右眼戴接触镜后,红痛5d, 检查右眼矫正视力为0.8,结膜混合充血, 角膜上有直径为1mm的灰白色浸润灶,荧光素染色阳性, 前房Tyndall阳性但无积脓。该病最可能的诊断是什么?
问题 529
患者右眼戴接触镜后,红痛5d, 检查右眼矫正视力为0.8,结膜混合充血, 角膜上有直径为1mm的灰白色浸润灶,荧光素染色阳性, 前房Tyndall阳性但无积脓。最重要的治疗方法首选?
问题 530
患者女,60岁, 主因右眼流泪且伴有视物不清15年,近半年加重。查: 视力:右眼手动, 右眼泪囊区挤压可见黏脓性分泌物。右眼晶体白色混浊,眼底窥不进。对于本病例诊断是什么?
问题 531
患者女,60岁, 主因右眼流泪且伴有视物不清15年,近半年加重。查: 视力:右眼手动, 右眼泪囊区挤压可见黏脓性分泌物。右眼晶体白色混浊,眼底窥不进。对于本病的处理, 最好的治疗措施是什么?
问题 553
患者,男, 5岁,发现眼斜2年, 检查:全身一般情况可, 视力右0.2,左0.1, 角膜映光法检查眼位于:右眼映光点在角膜中央, 左眼映光点在颞侧瞳孔缘,阿托品膏散瞳验光示: 右+4.50DS=0.6左+5.50DS=0.5,眼球运动无受限。最可能的诊断为?
问题 554
患者,男, 5岁,发现眼斜2年, 检查:全身一般情况可, 视力右0.2,左0.1, 角膜映光法检查眼位于:右眼映光点在角膜中央, 左眼映光点在颞侧瞳孔缘,阿托品膏散瞳验光示: 右+4.50DS=0.6左+5.50DS=0.5,眼球运动无受限。最可能的病因为?
问题 555
患者,男, 5岁,发现眼斜2年, 检查:全身一般情况可, 视力右0.2,左0.1, 角膜映光法检查眼位于:右眼映光点在角膜中央, 左眼映光点在颞侧瞳孔缘,阿托品膏散瞳验光示: 右+4.50DS=0.6左+5.50DS=0.5,眼球运动无受限。斜视角约为?
问题 556
患者,男, 5岁,发现眼斜2年, 检查:全身一般情况可, 视力右0.2,左0.1, 角膜映光法检查眼位于:右眼映光点在角膜中央, 左眼映光点在颞侧瞳孔缘,阿托品膏散瞳验光示: 右+4.50DS=0.6左+5.50DS=0.5,眼球运动无受限。应首先考虑何种治疗措施?
问题 557
患者,男, 5岁,发现眼斜2年, 检查:全身一般情况可, 视力右0.2,左0.1, 角膜映光法检查眼位于:右眼映光点在角膜中央, 左眼映光点在颞侧瞳孔缘,阿托品膏散瞳验光示: 右+4.50DS=0.6左+5.50DS=0.5,眼球运动无受限。治疗目的是什么?
问题 562
某女性患者,75岁, 右眼白内障摘除联合人工晶体植入术后25天,疼痛、视物不清7天, 20年前行"双眼虹膜周边切除术"。眼部检查:右眼视力: 眼前手动,角膜水肿, 前房明显变浅,周边小于1/4CT, 瞳孔约4mm×4mm大小,对光反应迟钝, 人工晶体位置正,眼压40mmHg; 左眼视力:0.12, 角膜清亮,前房浅, 周边小于1/3CT,瞳孔约3.5mm×3.5mm大小, 晶体混浊,眼底模糊不清, 眼压17mmHg。该患者右眼最主要诊断该考虑为?
问题 563
某女性患者,75岁, 右眼白内障摘除联合人工晶体植入术后25天,疼痛、视物不清7天, 20年前行"双眼虹膜周边切除术"。眼部检查:右眼视力: 眼前手动,角膜水肿, 前房明显变浅,周边小于1/4CT, 瞳孔约4mm×4mm大小,对光反应迟钝, 人工晶体位置正,眼压40mmHg; 左眼视力:0.12, 角膜清亮,前房浅, 周边小于1/3CT,瞳孔约3.5mm×3.5mm大小, 晶体混浊,眼底模糊不清, 眼压17mmHg。该患者右眼最有价值的辅助检查是什么?
问题 564
某女性患者,75岁, 右眼白内障摘除联合人工晶体植入术后25天,疼痛、视物不清7天, 20年前行"双眼虹膜周边切除术"。眼部检查:右眼视力: 眼前手动,角膜水肿, 前房明显变浅,周边小于1/4CT, 瞳孔约4mm×4mm大小,对光反应迟钝, 人工晶体位置正,眼压40mmHg; 左眼视力:0.12, 角膜清亮,前房浅, 周边小于1/3CT,瞳孔约3.5mm×3.5mm大小, 晶体混浊,眼底模糊不清, 眼压17mmHg。最佳治疗方案为?
问题 569
男,35岁, 主因左眼视力下降伴虹视2天。查:左眼视力0.6, 左眼(NCT)58mmHg,角膜水肿, 可见多量羊脂状KP呈三角形分布,周边前房约1/2CT, 房水闪辉(+),瞳孔圆, 直径约3mm对光反应迟钝,眼底查: C/D=0.3。该病例可能诊断是什么?
问题 570
男,35岁, 主因左眼视力下降伴虹视2天。查:左眼视力0.6, 左眼(NCT)58mmHg,角膜水肿, 可见多量羊脂状KP呈三角形分布,周边前房约1/2CT, 房水闪辉(+),瞳孔圆, 直径约3mm对光反应迟钝,眼底查: C/D=0.3。合理的治疗措施是什么?
问题 571
患者,女, 45岁,双眼睑红肿伴眼眶疼痛半月。检查: 视力右1.0,左1.0, 双眼上睑呈S型,皮肤红肿, 上睑外侧,压痛, 颞上穹窿部可见红肿的睑部泪腺,外侧球结膜充血水肿(+), 角膜透明,眼底未见异常, 136.5℃,血压130/80mmHg, 有感冒病史,全身浅表淋巴结无肿大。最可能的诊断为?
问题 572
患者,女, 45岁,双眼睑红肿伴眼眶疼痛半月。检查: 视力右1.0,左1.0, 双眼上睑呈S型,皮肤红肿, 上睑外侧,压痛, 颞上穹窿部可见红肿的睑部泪腺,外侧球结膜充血水肿(+), 角膜透明,眼底未见异常, 136.5℃,血压130/80mmHg, 有感冒病史,全身浅表淋巴结无肿大。为明确诊断, 需进一步的检查有哪些?
问题 573
患者,女, 45岁,双眼睑红肿伴眼眶疼痛半月。检查: 视力右1.0,左1.0, 双眼上睑呈S型,皮肤红肿, 上睑外侧,压痛, 颞上穹窿部可见红肿的睑部泪腺,外侧球结膜充血水肿(+), 角膜透明,眼底未见异常, 136.5℃,血压130/80mmHg, 有感冒病史,全身浅表淋巴结无肿大。最佳治疗方案为?
问题 575
患者,女性, 40岁,左眼视物变形、视力下降1周而就诊。检查左眼视力0.6, 黄斑水肿,未出血病灶。眼底检查: (如图)最有可能的诊断是什么?


问题 576
患者,女性, 40岁,左眼视物变形、视力下降1周而就诊。检查左眼视力0.6, 黄斑水肿,未出血病灶。眼底检查: 该病的荧光血管造影改变是什么?
问题 577
某男,65岁, 高血压病史30年,突然出现右眼视物不清5天, 眼部检查:视力R: 0.02,不能矫正, L:1.0, 右眼前节未见明显异常,晶体轻度混浊, 眼底可见视乳头边界不清,色淡, 周围可见浅层视网膜下出血,视乳头周围血管纹理不清, 黄斑中心反射不清,周边视网膜未见明显异常, 眼压18mmHg。对该患者的诊断首先应考虑为?
问题 578
某男,65岁, 高血压病史30年,突然出现右眼视物不清5天, 眼部检查:视力R: 0.02,不能矫正, L:1.0, 右眼前节未见明显异常,晶体轻度混浊, 眼底可见视乳头边界不清,色淡, 周围可见浅层视网膜下出血,视乳头周围血管纹理不清, 黄斑中心反射不清,周边视网膜未见明显异常, 眼压18mmHg。最有价值的辅助检查是什么?
问题 579
某男,65岁, 高血压病史30年,突然出现右眼视物不清5天, 眼部检查:视力R: 0.02,不能矫正, L:1.0, 右眼前节未见明显异常,晶体轻度混浊, 眼底可见视乳头边界不清,色淡, 周围可见浅层视网膜下出血,视乳头周围血管纹理不清, 黄斑中心反射不清,周边视网膜未见明显异常, 眼压18mmHg。治疗措施中最重要的是什么?
问题 580
男性,30岁。主诉: 右视力下降1个半月,自觉右眼前有黑影, 视物发暗变形,无眼红、眼痛史。三年前左眼曾有同样情况, 经治疗约一年视力有恢复。最近患者工作紧张。检查:视力右4.6(0.4), 左4.9(0.8)。双外眼未见异常。屈光间质清晰。小瞳眼底检查:双眼视乳头正常, 视网膜动脉稍细,静脉正常, 右眼黄斑部稍隆起,有黄白色点状物, 左眼黄斑部色素紊乱、中心凹光反射暗淡。为了作出初步诊断,还需作哪些检查?
答案:
凡怀疑为眼底疾病者,均应当首先散瞳检查眼底,这是一个基本原则。荧光眼底血管造影在眼底病的诊断与鉴别诊断中具有十分重要的作用。视力不正常者,应常规验光,以确认是否存在屈光不正。既然已经怀疑为黄斑疾病,且患者有眼前黑影的主诉,因此作中心视野检查有助于诊断。
问题 581
男性,30岁。主诉: 右视力下降1个半月,自觉右眼前有黑影, 视物发暗变形,无眼红、眼痛史。三年前左眼曾有同样情况, 经治疗约一年视力有恢复。最近患者工作紧张。检查:视力右4.6(0.4), 左4.9(0.8)。双外眼未见异常。屈光间质清晰。小瞳眼底检查:双眼视乳头正常, 视网膜动脉稍细,静脉正常, 右眼黄斑部稍隆起,有黄白色点状物, 左眼黄斑部色素紊乱、中心凹光反射暗淡。根据病史及初步检查,考虑双眼患有哪些疾病? 提示:右+0.50D.S→0.8, 左+0.75D.S→1.2。眼底:右眼黄斑部稍隆起, 有黄白色斑点状渗出物,中心凹光反射消失。荧光眼底血管造影: 动脉期右眼黄斑区见荧光渗漏,呈“冒烟样”扩大。中心视野: 右眼中央有8度左右相对性暗点,左眼未见异常。
答案:
双眼远视;右眼中心性浆液性视网膜脉络膜病变(中浆);左眼陈旧性中心性视网膜脉络膜病变
问题 582
男性,30岁。主诉: 右视力下降1个半月,自觉右眼前有黑影, 视物发暗变形,无眼红、眼痛史。三年前左眼曾有同样情况, 经治疗约一年视力有恢复。最近患者工作紧张。检查:视力右4.6(0.4), 左4.9(0.8)。双外眼未见异常。屈光间质清晰。小瞳眼底检查:双眼视乳头正常, 视网膜动脉稍细,静脉正常, 右眼黄斑部稍隆起,有黄白色点状物, 左眼黄斑部色素紊乱、中心凹光反射暗淡。本病引起视物变形的病理机制是什么?提示: Amsler氏方格表检查:右眼线条弯曲, 方格变形,变小约1/3, 左眼线条稍呈凹形,方格不缩小。
答案:
黄斑区视网膜下积液,将神经上皮层推起向前弯曲,使视觉细胞间彼此位置发生改变;黄斑区浆液性视网膜脱离,使视细胞的正常排列平面发生改变
问题 583
男性,30岁。主诉: 右视力下降1个半月,自觉右眼前有黑影, 视物发暗变形,无眼红、眼痛史。三年前左眼曾有同样情况, 经治疗约一年视力有恢复。最近患者工作紧张。检查:视力右4.6(0.4), 左4.9(0.8)。双外眼未见异常。屈光间质清晰。小瞳眼底检查:双眼视乳头正常, 视网膜动脉稍细,静脉正常, 右眼黄斑部稍隆起,有黄白色点状物, 左眼黄斑部色素紊乱、中心凹光反射暗淡。本例患者中心暗点出现的原因是什么?
答案:
右眼黄斑区视网膜神经上皮层脱离;右眼黄斑区视网膜色素上皮层脱离;右眼黄斑区视锥细胞功能损害
问题 584
男性,30岁。主诉: 右视力下降1个半月,自觉右眼前有黑影, 视物发暗变形,无眼红、眼痛史。三年前左眼曾有同样情况, 经治疗约一年视力有恢复。最近患者工作紧张。检查:视力右4.6(0.4), 左4.9(0.8)。双外眼未见异常。屈光间质清晰。小瞳眼底检查:双眼视乳头正常, 视网膜动脉稍细,静脉正常, 右眼黄斑部稍隆起,有黄白色点状物, 左眼黄斑部色素紊乱、中心凹光反射暗淡。根据双眼荧光眼底血管造影所见,其荧光表现特征是? 提示:荧光素血管造影: 右眼黄斑区在动脉期出现一点状荧光渗漏,并逐渐增强与扩散形成磨菇状, 至造影晚期仍呈高荧光表现。左眼在动脉早期黄斑区显现斑点状荧光,随背景荧光增强而增强, 随背景荧光消退而消失。
答案:
右眼荧光素积存;右眼荧光渗漏喷出型(烟囱现象);左眼窗样缺损
问题 586
男性,30岁。主诉: 右视力下降1个半月,自觉右眼前有黑影, 视物发暗变形,无眼红、眼痛史。三年前左眼曾有同样情况, 经治疗约一年视力有恢复。最近患者工作紧张。检查:视力右4.6(0.4), 左4.9(0.8)。双外眼未见异常。屈光间质清晰。小瞳眼底检查:双眼视乳头正常, 视网膜动脉稍细,静脉正常, 右眼黄斑部稍隆起,有黄白色点状物, 左眼黄斑部色素紊乱、中心凹光反射暗淡。本病应与哪些病进行鉴别诊断?
答案:
老年黄斑变性;Stargardt黄斑变性;黄斑囊样水肿
问题 587
男性,30岁。主诉: 右视力下降1个半月,自觉右眼前有黑影, 视物发暗变形,无眼红、眼痛史。三年前左眼曾有同样情况, 经治疗约一年视力有恢复。最近患者工作紧张。检查:视力右4.6(0.4), 左4.9(0.8)。双外眼未见异常。屈光间质清晰。小瞳眼底检查:双眼视乳头正常, 视网膜动脉稍细,静脉正常, 右眼黄斑部稍隆起,有黄白色点状物, 左眼黄斑部色素紊乱、中心凹光反射暗淡。本病目前最有效的治疗方法是?提示: 本病预后好,视力恢复好, 局部残留色素上皮萎缩或见脱色素斑。避免精神因素及过劳可以减少复发。
问题 588
男性,30岁。主诉: 右视力下降1个半月,自觉右眼前有黑影, 视物发暗变形,无眼红、眼痛史。三年前左眼曾有同样情况, 经治疗约一年视力有恢复。最近患者工作紧张。检查:视力右4.6(0.4), 左4.9(0.8)。双外眼未见异常。屈光间质清晰。小瞳眼底检查:双眼视乳头正常, 视网膜动脉稍细,静脉正常, 右眼黄斑部稍隆起,有黄白色点状物, 左眼黄斑部色素紊乱、中心凹光反射暗淡。如何用激光治疗本病?
答案:
直接光凝:光凝荧光渗漏点处;间接光凝:光凝浆液性脱离区内非荧光渗漏点的任何部位;光凝点距中心凹不能<2/3PD;如荧光渗漏点位于视盘~黄斑束下,则光凝时应降低能量强度;无荧光渗漏的陈旧性中心性视网膜脉络膜病变不宜作光凝
问题 589
男性,30岁。主诉: 右视力下降1个半月,自觉右眼前有黑影, 视物发暗变形,无眼红、眼痛史。三年前左眼曾有同样情况, 经治疗约一年视力有恢复。最近患者工作紧张。检查:视力右4.6(0.4), 左4.9(0.8)。双外眼未见异常。屈光间质清晰。小瞳眼底检查:双眼视乳头正常, 视网膜动脉稍细,静脉正常, 右眼黄斑部稍隆起,有黄白色点状物, 左眼黄斑部色素紊乱、中心凹光反射暗淡。本病的预后如何?
答案:
是一种良性病变;多数能自愈;药物治疗不能改善预后;激光治疗只能缩短病程,不能改善预后;多次复发或病程持续较久,可致永久性视力减退;大多数病人的视力可恢复到原有水平;极少数病人会发生黄斑囊样变性
问题 590
李××,男, 63岁,就诊时间2006年1月17日
主述: 左眼反复视

发作伴眼胀、同侧头痛1年。
现病史:2006年1月12日因为左眼反复视物模糊伴眼胀和左侧头痛1年诊断为"原发性闭角型青光眼(晚期)"在某院行"左眼小梁切除术"。VOD: 0.3,+2.00DS=1.0; VOS:0.1, 加镜无助。
左眼角膜透明,KP(+), 周边前房消失,中央前房浅, 上方虹膜周切口清晰可见,瞳孔5mm, 除青光眼性视盘改变外余眼底未见异常。如左眼眼压为3mmHg。请写出诊断,分析可能的原因及治疗原则。
答案:
(1)诊断:抗青光眼术后低眼压性浅前房(Ⅱ度)(左眼)
(2)诊断依据:
①病史:原发性闭角型青光眼,左眼小梁切除术后5天。
②体查:左眼视力0.1,加镜无助;左眼周边前房消失,中央前房浅;眼压3mmHg。
(3)可能的原因:
①结膜切口渗漏或结膜瓣渗漏
滤过泡渗漏有两种情况:一种是手术技术引起的,如结膜伤口对合不好、缝合不密、结膜撕裂、缝线松脱等原因;另一种是薄壁滤过泡,大多与抗代谢药物使用有关。2%荧光素染色作Seidel试验,滤过泡区域结膜渗漏处呈绿色溪流冲刷现象为阳性。
治疗:a.药物治疗,如碳酸酐酶抑制剂、肾上腺素β受体阻滞剂等抑制房水生成,减少房水经渗漏处流动;b.机械性处理,以绷带加压包扎最常用,但效果不确定,大直径软性角膜接触镜、胶原盾及睑球粘连环对滤枕的加压效果更好.c.滤过泡旁或滤过泡内自体血注射,促进渗漏口愈合;d.上述治疗方法效果不佳,渗漏仍持续存在时考虑手术修复,包括直接缝合修复、转移结膜瓣或移植组织修复等。
②滤过过强
要表现为滤过泡的隆起度和滤过区的范围异常增大,Seidel试验阴性。可能发生原因:过大的滤口,薄而小或边缘对合不良甚至缺损的巩膜瓣,巩膜瓣缝线数目少而松弛甚至没有缝合,过早拆除或松解巩膜瓣缝线,抗代谢药物使用不当,手术指征和手术滤过量的判断失误。
治疗:滤枕加压包扎,联合应用抑制房水生成药物,滤过泡内自家血注射等;如效果不明显可考虑手术修复,包括重新缝合巩膜瓣、移植新的巩膜瓣、切除变性囊样滤泡组织并游离转移新的结膜瓣等。
③睫状体脉络膜脱离
眼底检查和B超对发现睫状体和周边部的脉络膜脱离有其局限性,即使眼底检查和B超无阳性发现,也不能排除睫状体脉络膜脱离。可行超声生物显微镜(UBM)或眼前节光学相干断层扫描(OCT。)检查。
治疗:a.加强抗炎,局部和全身使用糖皮质激素;b.局部使用长效抗胆碱能制剂,如1%阿托品眼药水;c.前房注入粘弹剂,适度提高眼压,迫使睫状体脉络膜上腔的液体流出,恢复房水循环。
④房水生成减少
手术刺激、睫状体炎症、抗代谢药物的毒副作用、持续性低眼压、睫状体-脉络膜脱离、术前长期应用房水生成抑制剂等可导致房水生成的减少。
治疗:主要针对病因进行治疗。
⑤术后虹膜睫状体炎
治疗:1%阿托品、10%新福林散瞳,糖皮质激素局部和全身使用。
⑥渗出性视网膜脱离
眼部B超检查可进行判断。
治疗:散瞳,局部和全身使用糖皮质激素。如Ⅱ度浅前房持续时间过长或出现Ⅲ度浅前房,考虑行前房重建术,术中注意探查和引流脉络膜上腔积液。
问题 592
刘××,男, 45岁,诉右眼眼痛并眼前黑影4天。否认外伤史。体查: VODFC/眼前,VOS1.0。IOP: OD27mmHg,OS18mmHg。右眼结膜充血, 角膜透明,瞳孔圆, 4mm,光反应(+), 晶状体透明,玻璃体腔内可见大量白色絮状混浊。视乳头边界欠清, 网膜灰白色隆起,可见大量黄白色斑块状病灶及散在片状出血, 血管迂曲,动脉周围可见白色血管鞘, 部分血管闭塞。最可能诊断是什么?
答案:
最可能的诊断:急性视网膜坏死综合征(右眼)并发渗出性视网膜脱离、继发性青光眼。
诊断依据:
(1)右眼发病
(2)临床表现
症状:右眼眼痛并眼前黑影4天。
体征:VODFC/眼前、VOS1.0,IOP:OD27mmHg,OS18mmHg。右眼结膜充血,玻璃体腔内可见大量白色絮状混浊。视乳头边界欠清,网膜灰白色隆起,可见大量黄白色斑块状病灶及散在片状出血,血管迂曲,动脉周围可见白色血管鞘,部分血管闭塞。
问题 593
刘××,男, 45岁,诉右眼眼痛并眼前黑影4天。否认外伤史。体查: VODFC/眼前,VOS1.0。IOP: OD27mmHg,OS18mmHg。右眼结膜充血, 角膜透明,瞳孔圆, 4mm,光反应(+), 晶状体透明,玻璃体腔内可见大量白色絮状混浊。视乳头边界欠清, 网膜灰白色隆起,可见大量黄白色斑块状病灶及散在片状出血, 血管迂曲,动脉周围可见白色血管鞘, 部分血管闭塞。鉴别诊断是什么?
答案:
鉴别诊断
(1)巨细胞病毒性视网膜炎均发生于免疫抑制或全身感染巨细胞病毒的新生儿,病程长,进展慢,疾病早期常累及后极部视网膜,颗粒状外观的炎症改变,沿弓状血管走行分布,常累及视神经,玻璃体炎症反应较轻。其视网膜坏死有独特的"破碎的干酪"样外观,视网膜脱离发生率较急性视网膜坏死综合征低。
(2)梅毒性视网膜炎梅毒可引起视网膜动脉炎、片状视网膜混浊和玻璃体炎,密螺旋体和疏螺旋体血清学检查有助于诊断。
(3)眼弓形体病对于免疫抑制者,弓形虫可引起广泛的视网膜坏死及严重的玻璃体炎,眼内液和血清特异性抗体检查有助于诊断。
问题 594
刘××,男, 45岁,诉右眼眼痛并眼前黑影4天。否认外伤史。体查: VODFC/眼前,VOS1.0。IOP: OD27mmHg,OS18mmHg。右眼结膜充血, 角膜透明,瞳孔圆, 4mm,光反应(+), 晶状体透明,玻璃体腔内可见大量白色絮状混浊。视乳头边界欠清, 网膜灰白色隆起,可见大量黄白色斑块状病灶及散在片状出血, 血管迂曲,动脉周围可见白色血管鞘, 部分血管闭塞。需进一步做什么检查?
答案:
进一步检查
(1)眼底血管造影
(2)眼B超
(3)实验室检查,如血清学检查、眼内液抗体测定、玻璃体及视网膜活检等。
问题 595
刘××,男, 45岁,诉右眼眼痛并眼前黑影4天。否认外伤史。体查: VODFC/眼前,VOS1.0。IOP: OD27mmHg,OS18mmHg。右眼结膜充血, 角膜透明,瞳孔圆, 4mm,光反应(+), 晶状体透明,玻璃体腔内可见大量白色絮状混浊。视乳头边界欠清, 网膜灰白色隆起,可见大量黄白色斑块状病灶及散在片状出血, 血管迂曲,动脉周围可见白色血管鞘, 部分血管闭塞。如何治疗?
答案:
治疗方案
(1)抗病毒治疗
(2)抗凝剂
(3)糖皮质激素
(4)手术治疗
问题 662
病历资料
<1.现病史
患者,男性, 28岁,主诉“双眼先后眼红、畏光、流泪、异物感9天, 左眼视力下降2天”。患者半月前曾至公共浴室洗浴,其后出现左眼红, 流泪,异物感等症状, 无明显分泌物,2天后右眼亦出现同样症状, 去医院就诊为“急性结膜炎”,予以局部抗病毒、抗生素滴眼液治疗, 但病情进一步发展,而且左眼出现视力下降, 遂至我院就诊。
<2.既往史
全身疾病:否认高血压、糖尿病等。
外伤手术史: 无。
过敏史:否认。
<3.体格检查
眼科专科检查如表1-1所示。




<4.实验室及影像学检查或特殊检查:
无。
<5.诊治经过
患者双眼先后红、畏光、流泪、异物感9天,左眼视力下降2天。无明显的分泌物。发病前曾至公共洗浴中心洗浴。体检示睑结膜、球结膜充血, 上睑假膜形成。左眼角膜上皮下数枚灰白色浸润灶。触诊双侧耳前淋巴结肿大。以上均提示该患者为流行性角结膜炎。遂予以上睑结膜假膜擦除,局部人工泪液、更昔洛韦滴眼液以及抗生素滴眼液继续治疗。3周后双眼眼红畏光流泪等症状完全消失, 但左眼角膜上皮下浸润仍存在,并伴有轻度的视力下降。予以人工泪液继续维持治疗, 左眼加用0.1%氟米龙滴眼液每天3次,2周后复诊角膜病灶消退。
1.该患者的诊断与诊断依据是什么?
2.该患者的处理方案及理由是什么?
答案:
1.(1)半月前曾至公共洗浴中心洗浴。
(2)洗浴五天后双眼先后眼红、流泪、畏光。无明显分泌物。
(3)眼科检查睑结膜、球结膜充血,睑结膜假膜形成。
(4)耳前淋巴结肿大
(5)发病1周后左眼角膜中央上皮下散在数枚圆形灰白色浸润。
基于以上几点分析:流行性角结膜炎诊断成立。
2. 本病为传染性疾病故治疗时首先要嘱患者做好隔离,避免传染他人。此外该病为自限性疾病,缺乏特效治疗方法,治疗目的主要是缓解患者眼部不适症状。若睑结膜假膜形成需擦除,以避免假膜对角膜上皮的摩擦和减轻眼部刺激症状,局部药物可使用人工泪液、抗病毒药物以及为防止继发感染和混合感染而使用抗生素滴眼液。若眼部刺激症状显著或角膜上皮下浸润影响视力可酌情使用低浓度的局部皮质类固醇滴眼液。
问题 664
病历资料
<1.现病史
患者,男性, 11岁,因“反复双眼眼红眼痒3年, 右眼畏光,视物模糊1周”。3年前无明显诱因下出现双眼眼红, 眼痒症状明显,揉眼后无缓解, 伴畏光,流泪等不适, 有黏性分泌物、无视力下降,曾于当地医院就诊, 诊断为“过敏性结膜炎”,予抗过敏眼水点眼, 症状稍缓解,此后仍反复发作, 有一定的季节性,春夏季发作频繁, 秋冬季较少,发病后予抗过敏眼水尚能部分控制症状。1周前, 自觉右眼视力下降,畏光加重, 有明显的眼部刺激症状,今为求进一步诊治来我院门诊。
<2.既往史
其他过敏性病史: 有过敏性鼻炎病史3年,平素使用布地奈德喷雾剂控制症状。
家族史: 父亲有过敏性结膜炎和过敏性鼻炎病史
用药史:眼部用药见现病史, 否认全身用药
外伤手术史:否认
过敏史: 有过敏体质,具体过敏原未检测
<3.体格检查
眼科专科检查如表1-2所示。




<4.实验室及影像学检查或特殊检查。
过敏原皮肤点刺检测: 屋尘螨、粉尘螨均为强阳性(见图2-5)。

<5.诊治经过
3年前患者因双眼眼红眼痒,于当地医院就诊, 拟“双眼过敏性结膜炎”予肥大细胞稳定剂“色甘酸钠滴眼液”,抗组胺眼水“帕坦洛滴眼液”, 用药后症状稍好转,此后仍反复发作, 有一定的季节性,春季发作频繁, 秋冬季较少发作,起病后予抗过敏眼水尚能部分控制症状。1周前, 自觉右眼视力下降,畏光加重, 有明显的眼部刺激症状,为求进一步诊治来我院门诊。根据眼科专科检查和辅助检查, 初步诊断为“双眼春季卡他性角结膜炎”,给予免疫抑制剂治疗: ①他克莫司滴眼液ou bid,思然眼水ou tid, ②2周眼科随访复查。
1.该患者的诊断与诊断依据是什么?
2.该患者的处理方案及理由是什么?
答案:
诊断与诊断依据:(1)双眼反复眼红眼痒3年,属于慢性。
(2)发病有明显的季节性,春夏季明显。
(3)症状:奇痒和畏光,眼刺激症状明显。
(4)体征:乳头增生、胶样隆起、盾形溃疡。
(5)父亲及本人有过敏性体质。
(6)过敏原皮肤点刺检测发现屋尘螨和粉尘螨强阳性。
基于以上几点分析:初步诊断为春季卡他性角结膜炎。
处理方案及理由:本病治疗的基本原则是避免过敏原、药物控制,缓解症状,谨防角膜病变
1.避免刺激因素:行过敏原检测,明确过敏原后尽可能的避免接触。有针对性的进行脱敏治疗,如尘螨制剂舌下含服,但往往脱敏周期较长,患者较难坚持。
2.局部用药:
(1)在高发季节开始前预防性用药,持续使用2-3周,可以考虑使用肥大细胞稳定剂,如色甘酸纳或吡嘧司特钾滴眼液。
(2)轻中度的患者可使用抗组胺药物如:埃美丁或帕坦洛;亦可加用非甾体类抗炎药物如:普拉洛芬或双氯芬酸钠滴眼液。
(3)对于病情严重的患者可以滴用激素类药物,如:氟米龙,地塞米松等眼药水。激素类药物应在医生指导下应用,避免长期使用,使用期间应监测眼压。对于病情迁延难治的患者可使用环孢素眼药水或者他克莫司眼药水。
(4)若出现盾形溃疡时,需要加用局部类固醇消除炎症以及局部抗生素预防感染;对于刺激症状明显的大龄患者可以考虑治疗性角膜接触镜,促进溃疡愈合。
问题 666
病历资料
<1.现病史
患者,女性, 54岁,主诉“左眼红痛、视力下降1月”。1月前清洗抽油烟机时不慎污水溅入左眼, 后出现眼红、眼痛、视力下降。曾于当地医院就诊,诊为角膜炎, 予可乐必妥眼水,托百士眼水, 更昔洛韦滴眼液频点,但病情未见明显好转, 今为求进一步诊治来我院门诊。
<2.既往史
全身疾病:否认高血压、糖尿病等。
外伤手术史: 1月前污水溅入左眼,否认手术史。
过敏史: 否认
用药史:眼部用药见现病史, 否认全身用药
<3.体格检查
眼科专科检查如表3-1所示。




<4.实验室及影像学检查或特殊检查
(1)角膜刮片:未找到细菌及真菌菌丝, 见棘阿米巴包囊(图3-3)。

(2)角膜共聚焦显微镜检查:见棘阿米巴包囊(图3-4)。

(3)细菌培养、真菌培养(—)。
<5.诊治经过
患者左眼红痛视力下降一月, 曾有污水溅入,经抗生素滴眼液、抗病毒滴眼液频繁点眼, 疗效不佳。该患者角膜环形浸润明显,伴有严重的眼部疼痛, 且经抗生素和抗病毒局部滴眼液治疗效果不佳,提示棘阿米巴感染可能。遂进行细菌、真菌、阿米巴涂片, 细菌及真菌培养,角膜共聚焦显微镜检查。涂片和共聚焦显微镜均找到棘阿米巴包囊, 其他病原微生物检查阴性,因此左眼“棘阿米巴角膜炎”诊断成立。予以0.02%洗必泰滴眼液, 0.2%甲硝唑滴眼液,每半小时一次频繁滴眼, 并联合局部左眼氟沙星眼水一天四次,病情控制后洗必泰和甲硝唑滴眼液酌情减少滴眼频次, 经治疗感染控制。
1.该患者的诊断与诊断依据是什么?
2.该患者的处理方案及理由是什么?
答案:
诊断与诊断依据:(1)左眼红视力下降伴明显眼痛1月。
(2)发病前污水溅入史。
(3)角膜病变呈现基质环形浸润。
(4)经局部抗生素、抗病毒药物治疗无效。
(5)角膜刮片、角膜共聚焦显微镜检查发现棘阿米巴包囊。
基于以上几点分析:左眼棘阿米巴角膜炎诊断成立。
处理方案及理由:本病以局部药物治疗为主,基本原则是局部频繁使用抗棘阿米巴原虫的药物,并保证足够的疗程和患者的依从性。若药物治疗无法控制,角膜频临穿孔可以行治疗性穿透性角膜移植术。
(1)抗阿米巴药物治疗:目前抗阿米巴的药物较少,缺乏市售药物,临床使用的药物多为各单位自行配制的。棘阿米巴角膜炎的药物治疗应及早、足量并持续长期用药才能取得较好的治疗效果。目前临床常用的抗阿米巴药物包括:0.02%洗必泰和0.2%甲硝唑滴眼液,治疗初期可以每30min~1h滴眼,病情控制后可酌情减量至每1h~2h滴眼,治疗期间应密切随访,合理使用共聚焦显微镜观察病情转归,治疗应保证足够疗程,一般治疗应维持3~6个月。由于棘阿米巴角膜炎可合并细菌感染,治疗时可联合使用局部抗生素滴眼液。
(2)手术治疗:棘阿米巴角膜炎手术治疗效果欠佳,术后复发可能性大,一般仅在药物治疗病变无法控制,角膜频临穿孔时可以行治疗性穿透性角膜移植术。术后继续联合抗阿米巴药物治疗,早期禁用皮质类固醇激素。
问题 668
病历资料
<1.现病史
患者,女性, 24岁,主诉“左眼红、异物感、视力下降2天”。患者为接触镜佩戴者, 发病前曾佩戴过夜,后出现眼红、异物感、视力下降, 眼黑出现白点,并不断扩大, 遂来我院就诊。
<2.既往史
全身疾病:否认高血压、糖尿病等。
外伤手术史: 否认。
过敏史:否认。
用药史: 否认局部及全身用药史。
<3.体格检查
眼科专科检查如表4-1所示。



<4.实验室及影像学检查或特殊检查
(1)角膜刮片细菌和真菌涂片:未找到细菌及真菌菌丝。
(2)角膜共聚焦显微镜检查: 未见真菌菌丝。
(3)细菌培养、真菌培养。细菌培养铜绿假单疱菌生长,真菌培养无生长。
<5.诊治经过
患者左眼红、异物感、视力下降2天。接触镜佩戴者, 发病前曾佩戴过夜。结合病史和裂隙灯检查,感染性角膜炎诊断成立, 遂行角膜病灶刮片细菌真菌涂片检查,以查找病原微生物, 但结果均为阴性,角膜共聚焦显微镜检查亦未发现真菌菌丝。虽然细菌及真菌培养结果尚需等待, 但该患者发病迅猛,角膜病变发展很快, 病灶表面有脓性分泌物,考虑细菌感染尤其是铜绿假单疱菌感染可能性大, 遂即刻给予局部左氧氟沙星滴眼液、妥布霉素滴眼液频点,全身头孢他啶静脉滴注。3天后病情显著好转(图4-2), 细菌培养证实铜绿假单疱菌生长,左氧氟沙星和妥布霉素均敏感, 故继续维持治疗,感染控制。

1.该患者的诊断与诊断依据是什么?
2.该患者的处理方案及理由是什么?
答案:
1. 诊断与诊断依据(1)左眼红、异物感、视力下降2天。
(2)发病前隐形眼镜佩戴过夜。
(3)角膜病变呈现黄白色基质脓样伴前房积脓。
(4)细菌培养铜绿假单疱菌生长。
基于以上几点分析:左眼铜绿假单胞菌性角膜炎诊断成立。
2. 处理方案及理由:本病治疗以局部药物治疗为主,病情严重者可联合全身抗生素应用。基本原则是在病原微生物检查取材后即给予广谱抗生素滴眼液足量频繁使用,药物治疗无法控制,可行结膜瓣遮盖、板层角膜移植或穿透性角膜移植术:
(1)局部抗生素滴眼液的使用:细菌性角膜炎的治疗在病原学检查结果没有出来之前,应迅速给予广谱抗生素滴眼液频繁使用,例如左氧氟沙星滴眼液、妥布霉素滴眼液。对于发展迅速、病变位于角膜中央的患者,正如本病例之患者,尤要高度重视,本病例最初24小时使用频率是首小时两种药物5分钟交替使用,而后每30分钟交替使用。由于本病例病变发展迅速,视力危害极大,所以同时联合全身抗生素的应用。用药24小时后应复诊观察药物治疗效果,并注意跟踪细菌培养结果,及时根据药敏调整用药。
(2)手术治疗:经过规范的抗生素应用,绝大多数细菌性角膜炎可以控制。若病变不能控制可以采取手术治疗,如病灶清创联合结膜瓣遮盖、板层角膜移植手术。若溃疡穿孔则需要行穿透性角膜移植术。
问题 670
病历资料
<1.现病史
患者,女, 69岁,主诉“双眼异物感8月余”。8月患者在当地医院就诊为“双眼真菌性角膜炎”, 开始频点那他霉素,逐渐出现双眼异物感, 伴眼红、畏光,无分泌物增多, 无虹视,无眼胀等, 且未曾停用那他霉素,遂来我院就诊。
<2.既往史
眼部: 否认眼部疾病史。
全身疾病:否认高血压、糖尿病等。
外伤手术史: 否认
过敏史:否认
<3.体格检查
眼科专科检查如表5-1所示。




<4.实验室及影像学检查或特殊检查
荧光素染色: 如图5-3、图5-4所示。


泪液分泌实验:右眼12mm/5min, 左眼10mm/5min
<5.诊治经过
患者”双眼异物感8月余”。8月患者在当地医院就诊为“双眼真菌性角膜炎”,开始频点那他霉素, 逐渐出现双眼异物感,伴眼红、畏光, 无分泌物增多,无虹视, 无眼胀等,且未曾停用那他霉素, 遂来我院就诊。给予停那他霉素,及对症治疗: 玻璃酸钠眼液(无防腐剂) ou q2h;0.1%氟美瞳眼液 ou tid; 小牛血清蛋白凝胶ou tid。经上述治疗2周后,患者自觉明显好转, 来我院门诊复诊,治疗后的两眼情况如表5-2所示。





1.该患者的诊断与诊断依据是什么?
2.该患者的处理方案及理由是什么?
答案:
1. 诊断与诊断依据:(1)双眼异物感8月余;
(2)8月前外院曾诊断“双眼真菌性角膜炎”,经那他霉素频滴(次数不详),且持续8月;
(3)经停那他霉素,并给予玻璃酸钠眼液(无防腐剂)、0.1%氟美瞳眼液 、小牛血清蛋白凝胶治疗后,角膜基质浸润及上皮损伤有明显好转;
(4)辅助检查:荧光素染色明确角膜上皮修复明显改善。
基于以上几点分析:“双眼药物毒性角膜炎”诊断成立。
2. 处理方案及理由:本病治疗的基本原则是消除病因、拮抗炎症、促进修复:
(1)立即停用所有原来眼部用药
(2)玻璃酸钠眼液(无防腐剂) ou q2h; 0.1%氟美瞳眼液 ou tid;小牛血清蛋白凝胶ou tid。
问题 672
病历资料
<1.现病史
患者,男性, 68岁,因“左眼视力下降2月余”。2月前无明显诱因下出现左眼视力下降, 伴眼红、异物感等不适,无脓性分泌物。曾于当地医院就诊, 诊为“虹膜炎、继发性青光眼”,予以局部皮质类固醇激素、降眼压药物治疗, 病情曾好转,但不久病情反复并进一步加重, 遂来我院就诊。
<2.既往史
眼部:曾有类似病史2次, 后缓解,具体治疗不祥。
全身疾病: 否认高血压、糖尿病等。
外伤手术史:否认
过敏史: 否认
<3.体格检查
眼科专科检查如表6-1所示。



<4.实验室及影像学检查或特殊检查
右眼眼部B超检查:玻璃体后脱离。
角膜共聚焦显微镜检查: 未见明显真菌菌丝和阿米巴包囊。
<5.诊治经过
患者左眼视力下降,伴眼红异物感2月, 在当地医院曾诊为“虹膜炎、继发性青光眼,”予以局部激素和降眼压治疗, 病情有好转,但不久病情反复并加重。结合眼科专科检查、辅助检查以及既往曾有两次相似病史等资料, 初步诊断为“左眼单纯疱疹病毒性角膜炎(内皮型)”,给予局部及全身抗病毒治疗和局部皮质类固醇治疗: ①百力特眼药水 os qid,更昔洛韦凝胶os tid; ②口服阿昔洛韦片 400mg 每天5次;③2周复查。治疗两周后患者病情明显好转(图6-2)。

1. 该患者的诊断与诊断依据是什么?
2. 该患者的处理方案及理由是什么?
答案:
1. 诊断与诊断依据(1)左眼视力下降、眼红2月。
(2)曾局部使用皮质类固醇激素好转,提示局部角膜病变可能与免疫相关。
(3)角膜灰白色混浊水肿增厚、后弹力层皱褶,上皮局部有水泡并伴轻微前房葡萄膜反应。提示角膜内皮炎症可能。
(4)既往曾有类似病史2次。单纯疱疹病毒性角膜炎有反复发作的特征。
基于以上几点分析:初步诊断为:单纯疱疹病毒性角膜炎内皮型。
2. 处理方案及理由:本病治疗主要以药物治疗为主,包括抗病毒治疗和皮质类固醇激素治疗,病变反复发作内皮功能失代偿或引起角膜白斑可行角膜移植术提高视力。
(1)抗病毒药物治疗:可使用局部抗病毒药物,如阿昔洛韦滴眼液、更昔洛韦滴眼液或凝胶。对于病情严重和反复发作的患者可口服抗病毒药物,如阿昔洛韦、伐昔洛韦或更昔洛韦。目前阿昔洛韦片应用较多,治疗剂量为400mg口服每天5次,维持剂量为400mg 每天2次。长期口服维持量阿昔洛韦可减少复发。
(2)糖皮质类固醇激素治疗:大部分患者局部用糖皮质激素滴眼液即可,如妥布霉素地塞米松滴眼液、醋酸泼尼松龙滴眼液。
(3)降眼压药物治疗:少数患者会伴有眼压升高,可予以局部降眼压药物治疗。
(4)角膜移植手术:内皮功能失代偿,角膜基质无明显混浊的患者可行角膜内皮移植术,明显的角膜基质混浊或形成白斑者可行穿透性角膜移植手术改善视力。
问题 674
病历资料
<1.现病史
患者,男性, 58岁,因“左眼红痛、视力下降4月”。5月前患者左侧头面部带状疱疹, 经全身口服抗病毒药物后皮肤损害消退。其后出现眼红、眼痛、视力下降。曾于当地医院就诊,诊为角膜炎, 予可更昔洛韦滴眼液、可乐必妥滴眼液频点,但病情未见好转, 视力进一步下降,为求进一步诊治来我院门诊。
<2.既往史
全身疾病: 否认高血压、糖尿病等。
外伤手术史:无。
过敏史: 否认
用药史:眼部用药见现病史, 曾口服伐昔洛韦。
<3.体格检查
眼科专科检查如表7-1所示。



<4.实验室及影像学检查或特殊检查
(1)角膜刮片:未找到细菌、真菌菌丝及棘阿米巴包囊。
(2)角膜共聚焦显微镜检查: 未见真菌菌丝及棘阿米巴包囊.
(3)细菌培养、真菌培养(—)。
(4)患侧角膜知觉较检测显著降低。
<5.诊治经过
患者左眼红痛视力下降4月,有同侧头面部带状疱疹病史。经抗生素滴眼液、抗病毒滴眼液频繁点眼, 疗效不佳。患侧角膜知觉明显减退,角膜病变形态呈现上皮缺损区边缘上皮过度增生, 伴基质灰白色浸润。病原学检查细菌、真菌阿米巴均为阴性。故诊断为“神经麻痹性角膜炎”。予以羊膜覆盖联合睑裂缝合(颞侧)术,术后患者病情逐步好转(见图7-2)。

1. 该患者的诊断与诊断依据是什么?
2. 该患者的处理方案及理由是什么?
答案:
1. 诊断与诊断依据:(1)左侧头面部带状疱疹5月。
(2)左眼红痛视力下降4月。
(3)患侧角膜知觉减退。角膜病变上皮缺损区边缘上皮过度增生并高起。
(4)经局部抗生素、抗病毒药物治疗无效。
(5)角膜刮片、角膜共聚焦显微镜检查未发现病原微生物。
基于以上几点分析:神经麻痹性角膜炎诊断成立。
2. 处理方案及理由 :本病治疗包括病因治疗、局部药物治疗和手术治疗。首先找到造成神经麻痹的病因进行相应治疗,但往往各种原因造成的三叉神经麻痹不可恢复。治疗中最主要的是停止使用角膜上皮毒性的药物,并根据疾病的不同阶段来选择局部治疗方法。若仅角膜上皮缺损但不伴有明显的角膜基质病变可以使用无防腐剂的人工泪液联合预防性局部抗生素,对同时存在的炎症可以谨慎使用糖皮质激素滴眼液或局部环孢素滴眼液。当上述治疗无效,病变进一步发展时可行羊膜覆盖、睑裂缝合等手术治疗。
问题 676
病历资料
<1.现病史
患者,男性, 31岁,因“左眼视物模糊2天”。6天前因左眼圆锥角膜行左眼深板层角膜移植术, 手术顺利,术后使用典必舒眼水QID点眼。术前裸眼视力0.1, 矫正无助;术后第一天裸眼视力0.2。
<2.既往史
家族史: 否认
用药史:眼部用药见现病史, 否认全身用药
外伤手术史:右眼因圆锥角膜7年前在外院行右眼穿透性角膜移植术。
过敏史: 否认
<3.体格检查
眼科专科检查如表8-1所示。



<4.实验室及影像学检查或特殊检查
(1)眼前节OCT:植片与患者植床(后弹力层)之间见散在高亮致密病灶(图8-2)

(2)角膜激光共聚焦显微镜: 植片与患者植床(后弹力层)之间见中高反光的团块状病灶(图8-3),无明确细胞结构, 可融合成片如云雾样(图8-4)。


(3)角膜保存液细菌培养、真菌培养:阴性。
<5.诊治经过
经过分析病史和影像学资料, 初步判断为低毒力性细菌感染。给予可乐必妥QID点眼,观察一天无明显改善。遂于术后第7天行“植片更换+层间冲洗术”, 原植片取下后一半进行细菌和真菌培养,另一半进行病理学检查。层间棉拭取样进行细菌和真菌涂片, 并使用抗生素溶液和氟康唑溶液进行层间冲洗。之后给患者更换甘油保存植片重新缝合。术后使用可乐必妥滴眼液Q2H,氟康唑滴眼液Q2H, 氟美童滴眼液Tid。术后层间病变无任何好转或改善(图8-5)。

层间棉拭涂片结果:细菌和真菌均为阴性。病理检查结果: 在取下的植片的后表面(即植片植床层间)见酵母菌样病原体附着(图8-6)。植片培养结果:念珠菌属(图8-6), 经质谱分析鉴定为光滑假丝酵母菌。


因此该患者的最终诊断为“深板层角膜移植术后念珠菌感染所致的层间角膜炎”,给予两性霉素滴眼液q2h, 氟康唑滴眼液q2h,可乐必妥滴眼液q2h, 他克莫司滴眼液tid。治疗四天后病变仍无法控制,最后患者接受穿透性角膜移植术。术后根据病原培养和药敏结果, 给予两性霉素滴眼液q2h,伏立康唑滴眼液q2h, 他克莫司滴眼液tid。术后随访6个月,感染未复发。
1. 该患者的诊断与诊断依据是什么?
2. 该患者的处理方案及理由是什么?
答案:
1. 诊断与诊断依据:
(1)深板层角膜移植术后早期发生的视力下降
(2)病变位于植片与植床(患者后弹力层)层间
(3)共聚焦显微镜在层间未见到有类上皮细胞样结构,可以排除上皮植入
(4)病原学检查结果
2. 处理方案及理由:本病治疗的基本原则是控制感染,消除病因,保护植片。
<1. 抗感染治疗:在病原学检查结果和药敏试验结果未明确之前,先根据经验性用药,使用耐药率较低的药物进行治疗。待培养和药敏结果明确之后,再调整用药。
<2. 抗排斥治疗:真菌感染时禁用糖皮质激素,因此需要使用免疫抑制剂如环孢素、他克莫司等进行抗排斥治疗,尽可能保护植片的功能。使用时需要注意药物的不良反应。
<3. 其他治疗:可适当使用无防腐剂人工泪液等,减少频繁使用抗感染药物对眼表组织的毒性反应。
问题 678
病历资料
<1.现病史
患者,男, 22岁,因“右眼出现白点, 伴视力下降1周”。1周前无明显诱因下发现右眼出现白点,伴视力下降、畏光, 无虹视,无眼胀等, 在当地医院就诊为“右眼角膜炎”,经左氧氟沙星眼液、阿昔洛韦眼液, 牛重组促上皮生长因子凝胶治疗,未见好转, 遂来我院就诊。
<2.既往史
眼部:近视, 双眼视力欠佳。
全身疾病:否认高血压、糖尿病等。
外伤手术史: 否认
过敏史:否认
<3.体格检查
眼科专科检查如表9-1所示。




<4.实验室及影像学检查或特殊检查
验光: OD: 视力无法矫正提高, OS: -5.00DS/-2.00DC×175=0.7
角膜地形图: 图9-3.

<5.诊治经过
患者“右眼出现白点,伴视力下降1周”。1周前无明显诱因下发现右眼出现白点, 伴视力下降、畏光,无虹视, 无眼胀等,在当地医院就诊为“右眼角膜炎”, 经左氧氟沙星眼液、阿昔洛韦眼液,牛重组促上皮生长因子凝胶治疗, 未见好转,遂来我院就诊。
1. 该患者的诊断与诊断依据是什么?
2. 该患者的处理方案及理由是什么?
答案:
1. 诊断与诊断依据(1)右眼出现白点,伴视力下降1周;
(2)于外院曾诊断“右眼角膜炎”,左氧氟沙星眼液、阿昔洛韦眼液,牛重组促上皮生长因子凝胶治疗后,症状未见好转;
(3)右眼角膜中央圆形隆起,可见空泡,基质水肿、浑浊,而左眼角膜中央稍前凸;
(4)辅助检查:
角膜地形图: 高度散光,角膜屈光力>48D
基于以上病史、眼部表现及辅助检查结果分析:双眼圆锥角膜(右眼急性圆锥)诊断明确。
2. 处理方案及理由:圆锥角膜治疗的基本原则是早期框架眼镜矫正、中期控制进展、晚期角膜移植:
<1、早期:对于规则散光或低度不规则散光进行框架眼镜矫正,角膜表层镜片术;
<2、中期:无角膜瘢痕者,可选择RGP佩戴,角膜厚度>400 um,可进行核黄素紫外线角膜交联术治疗,深板层角膜移植术;
<3、晚期:穿透性角膜移植术。此患者右眼可行穿透性角膜移植术,左眼可选择RGP佩戴。
问题 680
病历资料
<1.现病史
患者,女性, 50岁,因“左眼痛畏光10天”。10天前无明显诱因下出现左眼痛, 刺激症状明显,无脓性分泌物、无视力下降、无虹视、无眼眶痛等不适, 曾于当地医院就诊,予利巴韦林眼水tid, 左氧氟沙星眼水tid点眼一周,未见明显好转, 今为求进一步诊治来我院门诊。
<2.既往史
相关病史:近3年来双眼反复存在沙粒感、眼红、畏光, 平素口干症状明显
家族史:无家族遗传病史
用药史: 眼部用药见现病史,否认全身用药
外伤手术史: 否认
过敏史:否认
<3.体格检查
眼科专科检查如表11-1所示。




<4.实验室及影像学检查或特殊检查
抗核抗体(ANA)检查: 阴性(见图11-3)。
抗SSA/Ro: 阴性(见图11-3)。
抗SSB/La: 阴性(见图11-3)。
类风湿性因子(RF):未见升高
免疫球蛋白G: 轻度升高
血沉:轻度加快

唇腺活检: 唇腺腺体未见明显萎缩,个别脂肪细胞浸润, 见1灶淋巴细胞浸润(见图11-4)。

<5.诊治经过
患者左眼疼痛畏光2周,在当地医院就诊, 拟“左眼角膜炎”予利巴韦林眼水,可乐必妥眼水os tid使用1周未见明显好转来我院门诊, 根据角膜特征性病变和泪液分泌量严重下降,追问病史发现患者近3年来双眼反复存在沙粒感、眼红、畏光, 并伴有明显的口干症状,拟诊为“Sjogren综合征”, 嘱患者于风湿免疫科进行排查确诊,但自身抗体报告显示抗核抗体, 抗SSA和抗SSB均为阴性,暂不能确诊。因此进一步建议患者于口腔科进行唇腺活检, 病理显示存在淋巴细胞浸润灶。结合患者的眼部特征和病理表现,确诊为“Sjogren综合征”, 风湿免疫科给予帕夫林、羟氯喹全身药物口服治疗,眼科给予局部抗炎治疗和人工泪液补充: ①0.1%氟米龙眼水 ou tid,思然眼水 ou prn。并嘱患者定期风湿免疫科和眼科随访复查。
1. 该患者的诊断与诊断依据是什么?
2. 该患者的处理方案及理由是什么?
答案:
1. 诊断与诊断依据:(1)近3年来患者有双眼沙粒感、眼红、畏光等眼部不适症状,平素有明显口干症状,属于慢性疾病
(2)双眼结膜充血,角膜染色表现为弥漫性的点状上皮糜烂,左眼部分糜烂上皮融合成斑片状,下方见一角膜卷丝,左眼角膜卷丝引起的眼痛以及明显的刺激症状是本次患者就诊的主要原因。泪液分泌量检测双眼均为0mm/5min,泪膜破裂时间极短,结合患者有明确的口干症状,高度怀疑“Sjogren综合征”。
(4)辅助检查显示抗核抗体(-)、抗SSA(-)、抗SSB(-)和类风湿因子未见升高,自身抗体的阴性结果暂不支持“Sjogren综合征”的诊断
(5)唇腺活检报告中发现有淋巴细胞浸润灶存在,根据病理结果可以明确诊断
基于以上几点分析:诊断为双眼干眼症,Sjogren综合征。
2. 处理方案及理由:对于干燥综合征相关性干眼治疗的基本原则是全身治疗的基础上联合眼部抗炎和眼表保湿。
1、全身治疗
风湿免疫科会诊,进行免疫调节,抑制进一步的免疫损伤,临床用药有激素、抗疟疾药物(羟氯喹)、免疫抑制剂(环孢素A、硫唑嘌呤、甲氨蝶呤、麦考酚酸、来氟米特),生物制剂(抗TNF-α、抗CD20)。
2、眼科局部用药
(1)眼部保湿:人工泪液或凝胶的补充,泪道栓塞,湿房镜等
(2)局部抗炎治疗:干燥综合征往往引起重度干眼,眼表以及泪液中有大量炎症因子的存在,局部抗炎治疗有助于缓解患者干眼的症状和体征,常用药物有激素和免疫抑制剂,局部激素建议低强度短期使用。
3、其他
注意口腔保护,谨防口腔念珠菌病。干燥综合征作为一种全身系统性疾病,在累及其他器官系统时,应及时就诊。此外SS患者患淋巴瘤发病率明显升高,需要定期体检。
问题 730
患者,女, 18岁,以“车祸伤后左眼外斜1年”来我院门诊就诊。
现病史: 患者1年前车祸伤后昏迷,颅内多发损伤, 经神经外科治疗后全身状况逐渐稳定。清醒后即出现左眼外斜,眼球运动受限等症状。为求进一步诊治就诊于我院眼科。
既往史、个人史及家族史均无特殊。
眼部检查: 视力:右眼0.9, 左眼0.8。第一眼位:右眼注视, 左眼-45°,左眼不能正位注视(内转不可到中线)。角膜映光检查: 右眼注视,左眼大于-45°(-140

)。双侧眼睑位于角膜上缘下1.5mm, 双侧对称。眼球运动:右眼眼球运动各方向正常, 左眼外转正常,内转及下转不能、上转轻受限(病例1图1)。左眼被动牵拉试验: 各方向无限制。双眼角膜清亮,Kp(-), 前房中深,Tyn(-), 瞳孔等大等圆,直接及间接对光反射(+), 晶状体透明,眼底未见异常。

1.该患者的诊断?
2.该患者如何治疗?
答案:
1.诊断
左眼动眼神经不全麻痹。
诊断思路:根据患者的临床体征:左眼外斜、左眼眼球内转、上转、下转有不同程度受限,被动牵拉试验各个方向均无限制可以诊断左眼动眼神经麻痹,患者的左眼无上睑下垂、瞳孔无散大,因此考虑为左眼动眼神经不全麻痹。根据患者的车祸外伤史可以明确左眼动眼神经麻痹的病因是外伤所致。
2.治疗
患者车祸伤治疗稳定后,眼球偏斜情况稳定3~6个月,可通过斜视手术改善外观。完善术前检查及准备后,全麻下行左眼外直肌后退联合内直肌眶缘骨膜固定术。
问题 731
患儿,男, 4岁,因“发现右眼向外偏斜3年, 加重半年”就诊。
现病史:患儿家长3年前发现其间断出现右眼向外偏斜, 未曾就诊。近半年发现右眼偏斜发作频繁,为进一步诊治, 来我院就诊。
既往史、个人史及家族史均无特殊。
眼部检查:裸眼视力: 右眼0.9,左眼0.8。散瞳验光检查: 右眼:-0.50DS→1.0, 左眼-0.50DS/+0.75DC×120°→1.0,眼压: 右眼15mmHg,左眼16mmHg。双眼角膜透明, Kp(-),前房深, 房闪(-),虹膜无前后粘连, 瞳孔等大等圆,直径3mm, 直接、间接对光反射灵敏,晶状体透明, 眼底视盘色淡红,边界清, C/D=0.3,黄斑中心凹反光存在。角膜映光检查: 左眼注视,右眼-15°; 右眼注视,左眼-15°(病例2图1)。三棱镜检查: 左眼注视,右眼-40

; 右眼注视:左眼-40

。33cm和6m眼位检查相同。主导眼为左眼。眼球运动正常, 无AV征(病例2图2)。同视机检查:同时视: 重合点-16°,融合功能: 无,远立体视: 无;近立体视: 200秒。

注:患者注意力不集中时出现左眼注视, 右眼外斜,约-15°

1.该患者的诊断?
2.该患者如何治疗?
答案:
1.诊断
双眼间歇性外斜视。
2.治疗
全麻下行双眼外直肌后退,术中双眼外直肌后退8mm。
问题 732
患儿,男, 4岁,因“发现歪头3年余”就诊。
现病史: 患儿出生后6个月时家长发现歪头视物,未曾就诊, 未进行治疗。近半年来发现“某些角度眼神不正常”较明显,为进一步诊治, 就诊我院。
既往史、个人史及家族史均无特殊。
眼部检查:裸眼视力: 右眼0.9,左眼0.8。散瞳验光检查: 右眼:-0.50DS→1.0, 左眼-0.50DS/+0.75DC×120°→1.0,眼压: 右眼13mmHg,左眼16mmHg。双眼角膜透明, Kp(-),前房深, 房闪(-),虹膜无前后粘连, 瞳孔等大等圆,直径3mm, 直接、间接对光反射灵敏,晶状体透明, 眼底视盘色淡红,边界清, C/D=0.3,黄斑中心凹反光存在, 左眼底像外旋。面
部轻度不对称,右侧面部欠饱满。角膜映光检查: 左眼注视:L/R5°; 右眼注视:L/R5°(病例3图1)。三棱镜检查: 左眼注视:L/R17

, 右眼注视:L/R14

。歪头试验: 左侧阳性(病例3图2)。33cm和6m斜视度数相同。主导眼为右眼。眼球运动左眼内上转亢进+2,左眼内下转落后-1(病例3图1)。同视机检查: 同时视:重合点+2°L/R5°, 融合功能:-3°~+2°, 远立体视:有; 近立体视:200秒。

注: 第一眼位左眼上斜视,左眼内转时上转, 内上转亢进,内下转不足

注: 头向左肩倾,左眼上斜, 头向右肩倾,无明显垂直斜视足
1.该患者的诊断?
2.该患者如何治疗?
答案:
1.诊断
左眼先天性上斜肌麻痹。
2.治疗
全麻下行左眼下斜肌后退,术中下斜肌后退至下直肌颞侧止端外2mm、下直肌颞侧止端后4mm。
问题 733
患儿,女, 3岁,因“出生后2个月家长发现眼斜”就诊。
现病史: 家长在患儿出生后2个月发现左眼斜,于当地医院就诊, 诊断为斜视,未予处理。2岁时发现左眼注视差, 阿托品散瞳验光右眼+2.50DS,左眼+3.25DS, 未予配镜,予以遮盖右眼每天4小时, 定期复诊。现为求进一步诊治,就诊于我院。
既往史、个人史及家族史均无特殊。
眼部检查: 裸眼视力:右眼0.5, 左眼0.5。阿托品散瞳验光检查:右眼+2.00DS→0.8, 左眼+2.25DS→0.8,眼压: 右眼13mmHg,左眼13mmHg。双眼角膜透明, Kp(-),前房深, 房闪(-),虹膜无前后粘连, 瞳孔等大等圆,直径3mm, 直接、间接对光反射灵敏,晶状体透明, 眼底视盘色淡红,边界清, C/D=0.3,黄斑中心凹反光存在。角膜映光检查: 左眼注视:右眼+20°; 右眼注视:左眼+20°(病例4图1)。三棱镜检查: 左眼注视:右眼+80

, 右眼注视:左眼+80

。33cm和6m斜视度数相同。主眼为右眼。眼球运动正常, 无AV征。同视机检查:同时视: 无,融合功能: 无,远立体视: 无;近立体视: 无。

1.该患者的诊断?
2.该患者如何治疗?
答案:
1.诊断
双眼先天性内斜视。
2.治疗
全麻下行双眼内直肌后退,术中双眼内直肌后退5.5mm,左眼外直肌折叠8mm。
问题 734
患儿,女, 7岁,因出生后4个月发现“左眼向内偏斜”就诊。
现病史: 患儿4月龄时家长发现其左眼向内偏斜,伴眼球转动异常, 于当地医院就诊,未予明确诊断, 嘱其暂观察,具体不详。近7年来病情无明显变化, 因即将进入小学上学,家长考虑患儿外观欠佳, 为求进一步诊断和治疗就诊于我院。
既往史、个人史及家族史均无特殊。
眼部检查:裸眼视力: 右眼0.5,左眼0.5, 近视力:双眼Jr2。阿托品散瞳验光: 右眼+3.25DS+1.00DC×90°=0.7;左眼+3.00DS+1.75DC×80°=0.5。眼压: 右眼13.4mmHg,左眼15.2mmHg。双眼角膜透明, Kp(-),前房深, 房闪(-),瞳孔等大等圆, 直径3mm,直接、间接对光反射灵敏, 晶状体透明。眼底:双眼视盘界清色可, 黄斑中心凹光反射存在,视网膜在位。角膜映光检查: 右眼注视:看近看远左眼均+5°, 左眼注视:看近看远右眼+30°(病例5表1, 病例5图1)。


眼球运动检查:第一眼位: 右眼为主视眼,左眼+5; °水平右转:双眼均可到位; 水平左转:右眼可到位, 左眼刚到中线;垂直上转: 双眼均可到位;垂直下转: 双眼均可到位;右上转: 双眼均可到位;右下转: 双眼均可到位;左下转: 右眼可到位,左眼颞侧角膜缘距外眦-3mm; 左上转:右眼可到位, 左眼颞侧角膜缘距外眦-3mm。左眼外转时睑裂高度:8mm, 内转时睑裂高
度:5mm; 无明显代偿头位(病例5图2)。

MRI-眼运动神经检查显示:右侧展神经显示良好(白色箭头), 左侧展神经未显示(黄色箭头);左侧动眼神经与外直肌异常相邻(红色箭头); 双眼外肌、眼眶均未见明显异常(病例5图3)。

同视机检查:Ⅰ级功能: 客观角:+5°R/L1°; Ⅱ级功能:无; Ⅲ级功能:无; 近立体视:100秒。
1.该患者的诊断?
2.该患者如何治疗?
答案:
1.诊断
(1)左眼眼球后退综合征。
(2)左眼弱视。
(3)双眼屈光不正。
2.治疗
双眼按散瞳验光度数配镜,遮盖右眼每天2小时并辅助弱视训练,包括红闪仪、穿珠器,每次持续30分钟,每天2次,每3~6个月复诊。因本例患者第一眼位偏斜角度较小,存在一定的近立体视功能,且不存在上射或下射,不考虑手术治疗。
问题 735
患者,男, 28岁,因“摔伤后左眼红肿不愈20天”就诊。
现病史: 患者20天前骑车不慎摔倒,左眼被树枝扎伤, 自行拔出刺入左眼上睑的树枝。伤后左眼视力下降,眼球突出伴结膜充血水肿, 曾在当地做眼睑伤口的清创缝合和抗感染治疗(具体不详),病情好转但红肿不愈。为进一步诊治就诊我院。
既往史、个人史及家族史无特殊。
眼部查体: 左眼最佳矫正视力0.1,上睑充血肿胀, 轻度下垂,上睑重睑皱褶外侧可见已愈合的皮肤伤口。眼球轻内移位, 外转不能,其余各方向运动明显受限, 颞侧球结膜充血水肿,脱出睑裂外, 左眼较对侧突出5mm(病例6图1)。指试眶压(++)。左眼角膜下方白斑,前房深, 瞳孔轻度散大,直径4mm, 直接光反射、间接光反射迟钝,晶状体无混浊, 眼底未见明显异常。右眼前节、后节未见明显异常。左侧额、睑及颜面部感觉迟钝。眼眶CT示(病例6图2)左眼眶外侧弥散软组织影,边界不清, 与外直肌分辨不清,蔓延至眶尖部。颅内条形低密度影位于眶上裂后方和海绵窦旁。眼眶MRI检查显示眶内软组织病变的T

和T

加权像均为中信号, 边缘毛糙,T

加权像增强抑脂显像可明显增强。颅内条形占位病变在T

和T

加权像均为低信号影, 不增强(病例6图3)。

注:A示左眼上睑轻度下垂, 眼球突出伴向内侧移位,颞侧球结膜充血水肿, 脱出睑裂外。眼球外展受限;B示左眼上睑外侧可见树枝刺穿皮肤后愈合的伤口

注: 显示左眼眶外侧少量弥散软组织影,与外直肌关系密切, 眼眶中部少量低密度点状影。眶上裂后方见纵行条状低密度影

注:T

加权像合并增强抑脂像显示眶内软组织影可增强, 颅内异物低信号影
1.该患者的诊断?
2.该患者如何治疗?
答案:
1.诊断
(1)左侧颅内异物残留。
(2)左眼眶软组织损伤伴异物残留。
(3)左眼暴露性角膜炎。
(4)左眼外伤性瞳孔麻痹。
(5)左侧三叉神经感觉减退。
2.治疗
入院后全身麻醉下行左侧双重睑皮肤切口并向外侧延长约2/cm,截取外侧眶缘后,分离至外壁骨膜下间隙。向后剥离颞肌前缘,磨钻磨除眶外侧壁骨质深至眶上裂,在眶骨膜和脑膜间形成的腔隙内置入0°高清鼻内镜。
问题 736
患儿,男, 5岁,因“左眼睑红肿1个月”就诊。
现病史: 患儿于2016年6月7日无明显诱因出现左眼上睑红肿,无其他不适, 当地医院就诊,考虑“霰粒肿”, 给予热敷、点眼药水(具体不详),1周后眼睑红肿进行性加重。6月10日眼眶CT(病例7图1)显示左眼睑内侧皮下软组织影, 边界尚清。6月19日于当地诊所给予“头孢类”药物抗感染治疗3天,无明显好转。6月24日左眼上睑红肿加重, 复查眼眶CT(病例7图2)显示肿物波及整个眼睑,厚度明显增加, 且向眶内侧蔓延,眼球向外侧移位, 考虑“眶蜂窝织炎”,给予“头孢类”抗生素(具体不详)静脉滴注6天, 6月28日在当地医院怀疑“眶周脓肿”全麻下行左眼上睑病灶穿刺抽脓,未见脓性分泌物流出。病情持续加重, 为进一步诊治,7月1日就诊我院眼眶科门诊。

注: 左眼睑内侧软组织肿物,边界欠清

注: 左眼睑软组织肿物范围扩大至整个眼睑,并向眶内蔓延, 深至球后
既往史:无特殊。
个人史: 2胎2产,足月顺产, 生后无窒息,母亲妊娠期间无放射性物质及化学药物接触史, 生后母乳喂养,生长发育与正常同龄儿童相似。
家族史: 父亲及姐姐均体健,父母非近亲婚配, 家族中无家族性、遗传性及相关病史。
眼部及全身检查:左眼上睑完全下垂, 高度隆起,皮肤暗红色, 边界尚清,内上方可见既往穿刺手术遗留的微小切口2个(病例7图3)。眼睑触诊质地坚硬, 未及波动感。眼睑不能拉开,无法做眼科其他检查。下睑轻肿胀。右眼未见异常。全身检查: 无发热,双侧颌下各可触及一枚肿大淋巴结, 左侧大小约2cm×2cm,质硬, 无活动,右侧大小约1cm×1.5cm, 质硬,无活动,
余浅表淋巴结未及肿大。右下侧切牙对应的牙龈轻度肿胀。患儿诉双下肢、尾骨及口腔牙龈有自发疼痛,起始于6月27日, 后频次增多,影响夜间睡眠。怀疑血液系统疾病可能, 急行血常规检查:白细胞数6.01×10

/L, 中性粒细胞2.73×10

/L,血红蛋白105g/L, 血小板136×10

/L,白细胞分类示: 原始幼稚细胞占6010。进一步行骨髓细胞学穿刺检查,原始幼稚细胞占69.0%。骨髓免疫流式、融合基因检测均支持伯基特淋巴瘤。遂转我院儿科治疗。

注: 左眼上睑高度肿胀,隆起, 皮肤暗红色,边界欠清, 上睑完全下垂,下睑轻肿胀。上睑内侧两个微小结痂为既往穿刺抽脓的部位
1.该患者的诊断?
2.该患者如何治疗?
答案:
1.诊断
伯基特淋巴瘤左眼睑及眶内侵犯。
2.治疗
完善各项检查后,给予静脉及腰椎穿刺鞘内注射化疗药物。先后给予COP预处理方案,COPADM1和COPADM2方案,CYVE1和CYVE2方案。以上化疗药物不良反应包括:神经系统毒性、骨髓抑制、耳毒性、肝肾损害、胃肠道反应等不适,故化疗同时给予碱化、水化、止吐、保心、保肝治疗。
问题 737
患儿,男, 5岁,主因“左眶周磕伤后家长发现眼球运动受限伴恶心呕吐3天”就诊。
现病史: 3天前患儿在幼儿园玩耍时不慎被桌角磕伤左眼下方,伤后出现恶心呕吐, 就诊当地医院急诊科,怀疑“脑震荡”, 拍摄头颅CT未见明显异常,遂回家休息。后家长发现患儿左眼上下转动受限, 为进一步诊治就诊于我院眼科。
既往史、个人史及家族史无特殊。
眼部检查:双眼视力1.0。左眼下睑近内眦部皮肤小片状淤血斑, 无明显眼睑水肿。左眼眼位正,上、下转动受限, 内、外转动到位(病例8图1)。无上睑下垂,无球结膜淤血或水肿。眶压(-), 无眼球突出或凹陷。牵拉下直肌有明显阻力。双眼角膜透明,前房深, 瞳孔等大等圆,直径3mm, 对光反射灵敏,晶状体透明, 眼底未见异常。眼眶CT显示左眼眶下壁裂隙状骨折,左眼下直肌肌腹部部分嵌塞于骨折裂隙中(病例8图2)。

注: 患儿左下睑皮肤小片淤血斑,眼位正, 上下转动受限,其余方向转动到位

注: 左眼眶下壁trapdoor骨折,部分下直肌嵌塞于骨折裂隙
1.该患者的诊断?
2.该患者如何治疗?
答案:
1.诊断
(1)左眼眶下壁trapdoor骨折。
(2)左眼下直肌嵌塞。
2.治疗
入院后完善全麻术前准备,急诊行左眼眶骨折修复及下直肌松解术。以下睑结膜入路,分离至眶下缘后向眶底探查,见裂隙状骨折位于眶下神经沟内侧,下直肌的肌腹部嵌塞在骨折缝隙中。扩大骨折的范围,松解下直肌,将下直肌全程充分游离并还纳眶内。牵拉下直肌无阻力后,植入适当大小的可吸收修复材料重建眼眶下壁
问题 738
患者,男, 43岁,因“甲状腺功能亢进1年, 双眼视力下降6个月”就诊。
现病史:患者1年前出现双眼胀痛, 不适,无眼红, 无视力下降,当地内分泌科查甲功, 发现甲状腺功能亢进,诊断Graves病, 给予抗甲状腺药物“赛治(甲巯咪唑)”治疗(具体用法不详)后甲功逐渐降至正常。6个月前发现双眼视力进行性下降,无明显眼球突出, 当地医院给予“甲泼尼松”冲击治疗无明显好转(每天1g,共3天), 为进一步诊治转诊就诊于我院。
既往史、个人史与家族史均无特殊。
眼部检查:矫正视力: 右眼0.2,左眼0.02。双眼上、下睑轻水肿, 无充血,无上睑退缩, 无上睑迟落征,双下睑轻退缩, 球结膜无充血或水肿,泪阜轻充血(病例9图1)。眼球各方向运动不到位。眼球突出度: 右眼16mm,左眼17mm。指试双眶压(+++)(注: 压迫眼球,感受球后的对抗阻力, 阻力如额头为+++,如鼻尖为++, 如口唇+)。双眼角膜透明,Kp(-), 前房深,房闪(-), 晶状体透明,虹膜无前后粘连, 瞳孔等大等圆,直径约3mm。右眼直接光反射、间接光反射存在, 左眼直接光反射迟钝,间接光反射存在。双眼眼底: 未见明显异常。双眼眼压正常。眼眶轴位CT(病例9图2):双眼内直肌增粗, 以左眼为重,左眼外直肌增粗; 双眼眶尖部拥挤,视神经受压明显; 双侧筛骨纸样板受压变形,以左侧为重, 呈“可乐瓶”征。眼眶冠状位CT(病例9图3):左眼四条直肌明显增粗, 右眼上、内、下直肌增粗。色觉检查显示右眼色弱,左眼色盲。视野(病例9图4A和病例9图4B): 双眼颞上及下方视野缺损。

注:上下睑轻度水肿, 无眼睑征,泪阜轻充血

注: 双眼内直肌增粗,以左眼为重, 左眼外直肌增粗。双眼眶尖部拥挤,视神经受压明显。双侧筛骨纸样板受压变形, 以左侧为重,呈“可乐瓶”征

注: 左眼四条直肌明显增粗,右眼上、内、下直肌增粗

1.该患者的诊断?
2.该患者如何治疗?
答案:
1.诊断
(1)双眼甲状腺相关眼病。
(2)双眼压迫性视神经病变。
2.治疗
完善术前准备后全麻下行左眼眶最大化眼眶减压术,术中切除眼眶外侧壁至眶上裂,切除眼眶内壁及部分下壁,实现最大程度的眶腔扩大和压力释放。
问题 739
患儿,男, 11岁,因“左眼视力下降1年”就诊。
现病史: 患儿1年前发现左眼视力逐渐下降,未予重视, 1个月前拍摄眼眶CT及磁共振,发现左眼眶内肿瘤, 遂就诊于我院。
既往史、个人史、家族史无特殊。
眼部检查:左眼视力0.1, 矫正不能提高,眼压Tn。指试眶压(+)。左眼无上睑下垂。眼位正, 眼球各方向运动到位,眼球轴位突出, 较对侧眼突出3mm。左眼眼睑、结膜无充血,余眼前节检查无明显异常。眼底: 视盘边界清,色稍淡。右眼未见异常。CT扫描可见左眼眶内段视神经呈梭形增粗, 前段稍细,稍迂曲。增粗的视神经边界清, 均质,视神经管增粗(病例10图1)。磁共振显示增粗的视神经在T

加权像呈中低信号, T

加权像呈中高信号,管内段视神经增粗, 信号与眶内段相同。增强扫描显示视神经肿瘤增强明显,强化均匀, 颅内鞍上可见颅内段视神经呈片状增强,提示肿瘤颅内蔓延, 但未累及视交叉(病例10图2)。

注:A示左侧视神经梭形增粗, 边界清,均质, 前端变细,眶尖部膨大, 稍扭曲;B示视神经管较对侧明显增粗

注: A示轴位磁共振T

加权像显示左侧视神经肿瘤呈中信号;B示轴位磁共振T

加权像显示肿瘤呈高信号; C示轴位磁共振T

加权像并增强抑脂扫描显示视神经肿瘤增强明显,均匀, 视神经前端未见增强;D示轴位磁共振T

加权像并增强抑脂扫描显示颅内段视神经增粗, 明显增强
1.该患者的诊断?
2.该患者如何治疗?
答案:
1.诊断
(1)左眼视神经肿瘤颅内蔓延(视神经胶质瘤)。
(2)左眼弱视。
2.治疗
采用SGS-Ⅱ型伽马射线治疗系统,以70%等剂量曲线包绕肿瘤,处方剂量为DT20Gy/10Fx(分10天给予20Gy的伽马射线照射剂量),休息1个月后再给予相同处方剂量,总剂量40Gy
问题 740
患者,女, 69岁,因“右眼胀痛伴视力下降8天”就诊。
现病史: 8天前患者无明显诱因出现右眼胀痛伴视力下降,伴头痛、恶心、呕吐等不适, 无虹视、眼前遮挡感,就诊于当地医院, 测眼压右眼大于60mmHg,诊断为“青光眼”, 给予甘露醇250ml静脉滴注联合布林佐胺漓滴眼液2次/天、毛果云香碱滴眼液3次/天降眼压药物治疗,眼压控制不佳, 建议去上级医院治疗。患者为求进一步诊治,就诊于我院眼科。
既往史、个人史、家族史均无特殊。
眼部检查: 视力:右眼HM/30cm, 左眼0.6,眼压: 右眼25.1mmHg(用药情况下),左眼19.1mmHg(用药情况下)。右眼结膜混合性充血, 角膜水肿,色素性Kp(+), 中央前房2CT,周边前房裂隙状, 房闪(+),周边虹膜膨隆, 部分后粘连,瞳孔不圆, 直径约5mm(应用毛果云香碱滴眼液后),光反射消失, 晶状体前囊下不规则片状混浊(青光眼斑,病例11图1A).对状体核混浊, 核硬度Ⅱ级,眼底窥不入; 左眼角膜透明,中央前房2CT, 周边前房1/4CT,房闪(-), 瞳孔圆,直径约1.5mm(应用毛果云香碱滴眼液后病例11图1B), 对光反射迟钝,晶状体皮质、核混浊, 核硬度Ⅱ级,眼底: 视盘边界清,色淡红, C/D=0.3,视网膜血管走形大致正常, 视网膜平伏,黄斑中心凹反光不清。房角镜检查: 右眼因角膜水肿未查,左眼房角入口10°全周N4, 动态下可见1/2功能小梁,色素Ⅰ级。眼部A型超声测量眼轴长度: 右眼22.3mm,左眼22.4mm。角膜内皮细胞计数: 右眼角膜水肿无法分析,左眼2755个/mm

。

注: A示右眼,结膜混合性充血, 角膜水肿,瞳孔不圆, 直径约5mm(应用毛果云香碱滴眼液后),晶状体前囊下不规则片状混浊; B示左眼,角膜透明, 瞳孔圆,直径约1.5mm(应用毛果云香碱滴眼液后)
1.该患者的诊断?
2.该患者如何治疗?
答案:
1.诊断
(1)双眼急性闭角型青光眼(右眼急性发作期,左眼临床前期)。
(2)双眼年龄相关性白内障。
2.治疗
入院后给予右眼卡替洛尔滴眼液2次/天,溴莫尼定滴眼液2次/天、布林佐胺滴眼液2次/天、毛果云香碱滴眼液3次/天控制眼压,同时给予妥布霉素地塞米松滴眼液3次/天,地塞米松注射液2.5mg球周注射减轻高眼压导致的眼部炎症反应。完善术前检查后在局部麻醉下行右眼复合式小梁切除术。
问题 741
患者,女, 39岁,因“右眼视物发雾3周”之主诉就诊。
现病史: 3周前患者无明显诱因出现右眼视物发雾,偶伴眼胀, 就诊于当地医院,测量眼压右眼29mmHg, 左眼22mmHg,诊断为“双眼青光眼”, 给予“噻吗洛尔滴眼液、布林佐胺滴眼液”降眼压治疗。患者为求进一步治疗,就诊于我院眼科门诊。
既往史、家族史及个人史均无特殊。
眼部检查: 视力:右眼0.12, 矫正0.8,左眼0.12, 矫正0.8。眼压:右眼17mmHg(用药情况下), 左眼14mmHg(用药情况下)。双眼结膜无明显充血,角膜透明, 大量色素性Kp(+),呈垂直纺锤形分布(病例12图1), 前房深,房闪(-), 浮游细胞(-),瞳孔圆, 右眼直径4mm,对光反射迟钝, 左眼直径3mm,对光发射灵敏, 晶状体无明显混浊,眼底视网膜平伏, 双眼视盘边界清,右眼色苍白, C/D=0.9,左眼色淡, C/D=0.5。房角镜检查:双眼均为宽角, 小梁网可见大量色素颗粒沉着,右眼Ⅲ~Ⅳ级(Scheie分级法), 左眼Ⅲ级(病例12图2)。OCT检查:右眼广泛RNFL变薄, 左眼颞下方RNFL变薄。视野检查:右眼上下弓形视野缺损, 左眼旁中心暗点(病例12图3)。UBM提示双眼房角开放,虹膜后凹(病例12图4A)。

注: 双眼角膜内皮附着大量色素性Kp,呈垂直纺锤形分布, A示右眼,B示左眼

注: 右眼下方房角功能小梁网可见密集色素颗粒沉积,Schwalbe线以及非功能小梁
网可见细小色素颗粒沉积

注: A示右眼,上下弓形视野缺损; B示左眼,旁中心暗点

注: A示虹膜后凹,与晶状体悬韧带及前表面接触; B示激光虹膜周切术后,虹膜恢复平坦, 与晶状体悬韧带及前表面分离
1.该患者的诊断?
2.该患者如何治疗?
答案:
1.诊断
(1)双眼色素性青光眼。
(2)双眼屈光不正(近视)。
2.治疗
因右眼已是晚期青光眼,建议患者行滤过性手术,如患者要求保守治疗,给予双眼YAG激光虹膜周边切开术,解除反向瞳孔阻滞,激光术后给予普拉洛芬滴眼液3次/天,连用3天,同时联合降眼压药物治疗(患者自备药,噻吗洛尔联合布林佐胺)
问题 742
患者,男, 60岁,因“右眼胀痛伴视力下降4个月”之主诉入院。
现病史: 患者4个月前无明显诱因开始出现右眼胀痛,伴视力下降, 无头痛、恶心、呕吐等不适,于当地医院就诊, 给予眼药水(具体不详)治疗,眼胀痛未缓解, 视力逐渐下降。3天前患者再次就诊于当地医院,测量眼压右眼达59mmHg, 诊断为“右眼青光眼”,给予甘露醇注射液静脉滴注、醋甲唑胺片口服降眼压治疗, 普拉洛芬滴眼液、妥布霉素滴眼液抗感染治疗,建议上级医院进一步诊治, 患者遂来我院。
既往史:既往体健, 个人史及家族史均无特殊。眼部检查:视力: 右眼0.5,左眼0.8, 眼压:右眼50.3mmHg(用药情况下), 左眼14.6mmHg。右眼结膜轻度充血,角膜未见明显水肿, Kp(-),前房深, 房闪(+),虹膜纹理清晰, 瞳孔圆,直径约4mm, 对光反射迟钝,瞳孔缘可见灰白色头皮屑样物质沉积(病例13图1), 晶状体轻度混浊,散瞳后可见周边部环状灰白色颗粒混浊带(病例13图2), 眼底视盘边界清,色苍白, C/D约0.8,视网膜平伏, 黄斑中心凹反光不清。左眼检查未见明显异常。前房角镜检查:双眼均为宽角, 右眼色素3级,左眼色素1~2级, 部分色素越过Schwalbe线,形成Sampaolesi线(病例13图3)。视野检查: 右眼管状视野,左眼未见明显异常。OCT检查: 右眼视盘周围视网膜视神经纤维层厚度广泛变薄。

注:瞳孔缘可见灰白色头皮屑样物质沉积

注: 晶状体前囊周边部环状灰白色颗粒样混浊带

注:房角呈宽角, 小梁网上较多色素沉着,部分色素越过Schwalbe线, 形成Sampaolesi线
1.该患者的诊断?
2.该患者如何治疗?
答案:
1.诊断
(1).右眼剥脱性青光眼。
(2).双眼年龄相关性白内障。
2.治疗
入院后给予右眼溴莫尼定滴眼液、布林佐胺滴眼液、噻吗洛尔滴眼液联合甘露醇注射液静脉滴注降眼压治疗,完善术前检查排除手术禁忌证后,局部麻醉下行右眼复合式小梁切除术。
问题 743
患者,男, 76岁,因“左眼视力下降2年, 加重伴明显胀疼2周”之主诉就诊。
现病史:2年前患者无明显诱因自觉左眼视力下降, 无眼红、眼胀等不适,未予以重视。2周前患者发现左眼视力下降加重, 伴明显胀疼不适,于当地医院就诊, 测量左眼眼压高(具体不详),诊断为“左眼青光眼”, 给予静脉滴注甘露醇降眼压治疗,未见明显好转。现为求进一步诊治, 遂来我院。
既往史:否认全身慢性病病史, 7年前于外院行右眼白内障手术;个人史、冢族史无特殊。
眼部检查: 视力:右眼0.6, 左眼光感/30cm;眼压: 右眼8.2mmHg,左眼37.0mmHg(用药情况下)。右眼结膜无充血, 角膜透明,Kp(-), 前房深,房闪(-), 瞳孔直径3mm,对光反射灵敏, 人工晶状体位正,眼底未见明显异常。左眼结膜混合性充血, 角膜雾状水肿,Kp(+), 前房深,房闪(++).瞳孔直径4mm, 对光反射消失,晶状体混浊, 隐见前囊破裂,皮质溢出(病例14图1)眼底窥不入。眼部B超检查未见明显异常。角膜内皮镜检查因角膜水肿内皮细胞无法分析。角膜共聚焦显微镜: 左眼角膜内皮细胞计数约为2424个/mm

,细胞边界欠清, 可见中高反光物质沉积,基质层混浊, 角膜上皮层水肿可见大泡。

注:左眼结膜混合性充血, 角膜水肿,晶状体混浊, 隐见前囊破裂,皮质溢出
1.该患者的诊断?
2.该患者如何治疗?
答案:
1.诊断
(1)左眼晶状体溶解性青光眼。
(2)左眼年龄相关性白内障(过熟期)。
(3)右眼人工晶状体眼。
2.治疗
入院后给予左眼卡替洛尔滴眼液、布林佐胺滴眼液、溴莫尼定滴眼液、醋甲唑胺片降眼压治疗,泼尼松龙滴眼液联合地塞米松注射液2.5mg左眼半球后注射(1次/天)抗炎治疗3天后再次检查患者状况。此时术前检查已完善,无手术禁忌证,遂在球后阻滞麻醉下行左眼白内障囊外摘除联合小梁切除术。
问题 744
患者,男, 50岁,因“右眼间歇性疼痛伴视力下降1个月”入院。
现病史: 患者1个月前无明显诱因自觉右眼胀痛伴视力下降,伴头痛、恶心, 就诊于当地医院,诊断为“右眼青光眼, 右眼白内障”,收入院拟行右眼青光眼白内障联合手术, 术中发现晶状体悬韧带断裂,手术终止, 建议上级医院就诊,患者遂来我院。
既往史、个人史及家族史均无特殊。
眼部检查: 视力:右眼0.25, 左眼1.0,眼压: 右眼33mmHg(用药情况下),左眼15mmHg。右眼结膜混合性充血, 上方片状结膜下出血,12: 00位结膜下可见长方形巩膜瓣痕迹(病例15图1A),角膜无明显水肿, 鼻上方和颞上方可见透明角膜切口及辅助切口,Kp(-), 中央前房1CT,周边前房消失(病例15图2A), 房闪(-),瞳孔圆, 直径约3mm,对光反射存在, 晶状
体皮质混浊。左眼角膜透明,Kp(-), 中央前房3~4CT,周边前房1/2CT(病例15图2B), 房闪(-),瞳孔圆, 直径约3mm,对光反射灵敏, 晶状体皮质轻度混浊。眼底:双眼视盘边界清, 色淡红,C/D右眼0.4, 左眼0.3,双眼视网膜平伏。眼部B超检查未见明显异常, 眼轴长度右眼24.2mm,左眼23.9mm。

注: A示结膜混合性充血,上方片状结膜下出血及长方形巩膜瓣痕迹; B示YAG虹
膜激光术后1个月,结膜充血减轻, 巩膜瓣痕迹清晰

注:A示右眼, 角膜无明显水肿,中央前房1CT, 周边前房消失;B示左眼, 角膜透明,中央前房3~4CT, 周边前房1/2CT
1.该患者的诊断?
2.该患者如何治疗?
答案:
1.诊断
(1)右眼继发性青光眼。
(2)右眼晶状体不全脱位。
(3)双眼年龄相关性白内障。
2.治疗
患者右眼在当地医院制作巩膜瓣以及白内障透明角膜切口后仅3天,故未行UBM检查,给予甘露醇注射液250ml静脉滴注后行右眼YAG激光虹膜周边切开术,术后给予噻吗洛尔滴眼液、布林佐胺滴眼液、溴莫尼定滴眼液降眼压治疗以及普拉洛芬滴眼液抗感染治疗。建议患者1个月后来我院行脱位晶状体摘除术。
问题 745
患者,男, 82岁,因“左眼胀痛2周”之主诉就诊。
现病史: 2周前患者无明显诱因出现左眼胀痛,无虹视、头痛、鼻根部抽痛, 无眼前遮挡感,无恶心、呕吐等不适, 就诊于当地医院,诊断为“左眼青光眼”, 建议上级医院治疗。患者为求进一步诊治,就诊于我院眼科。
既往史、家族史及个人史均无特殊。
眼部检查: 视力:右眼0.3, 左眼手动/20cm。眼压:右眼11.5mmHg, 左眼36.9mmHg(用药情况下)。右眼结膜无明显充血,角膜透明, 老年环(+),Kp(-), 前房深,房闪(-), 瞳孔圆,直径3mm, 对光反射灵敏,晶状体皮质、核混浊, 核硬度Ⅲ级,眼底模糊, 见视网膜平伏。左眼结膜轻度充血,角膜上皮轻度水肿, 老年环(+),Kp(-), 前房浅,中央2CT, 周边1/4CT,房闪(-), 瞳孔圆,直径6mm, 对光反射消失,晶状体膨胀(病例16图1), 皮质、核混浊,核硬度Ⅳ级, 眼底窥不入。UBM提示左眼前房浅,房角关闭(病例16图2)。眼A超测量眼轴长度右眼24.03mm, 左眼24.06mm。眼B超未见异常。

注:角膜上皮轻度水肿, 前房浅,瞳孔圆, 直径6mm,晶状体膨胀、混浊, A示裂隙光,B示弥散光

注: A示左眼,中央前房深度仅为1.32mm, 房角关闭,晶状体膨胀、混浊; B示右眼,中央前房深度2.37mm, 房角狭窄
1.该患者的诊断?
2.该患者如何治疗?
答案:
1.诊断
(1)左眼继发性青光眼。
(2)双眼年龄相关性白内障(左眼膨胀期)。
2.治疗
入院后给予布林佐胺滴眼液、溴莫尼定滴眼液降眼压治疗,在局部麻醉下行左眼白内障囊外摘除、人工晶体植入联合小梁切除术。
问题 746
患者,女, 42岁,因“双眼胀伴视力下降5年”之主诉就诊。
现病史: 5年前患者无明显诱因出现双眼胀伴视力下降、头痛,无虹视、恶心、呕吐等不适, 就诊于当地医院,诊断为“双眼青光眼”, 分别行双眼小梁切除术,术后未规律复诊。1个月前患者就诊于我院眼科门诊, 怀疑双眼睫状环阻性青光眼,为行手术治疗收入院。
既往史、家族史均无特殊。
个人史: 戴近视眼镜近10年。
眼部检查:视力: 右眼0.12,矫正0.4(-6.5DS), 左眼0.05,矫正0.5(-6.25DS)。眼压: 右眼22.2mmHg,左眼16.2mmHg。双眼结膜滤过泡平坦, 角膜透明,Kp(+), 中央前房1CT,右眼周边前房消失(病例17图1A、病例17图1C), 左眼颞侧裂隙状,余周边前房消失(病例17图1B、病例17图1D), 双眼虹膜部分后粘连,周切口通畅, 瞳孔欠圆,直径约3mm, 对光反射存在,晶状体皮质混浊, 右眼重。眼底:双眼视盘边界清, 右眼色苍白,左眼色淡, 视网膜平伏。UBM提示双眼前房极浅,未提示睫状体脱离、晶状体脱位(病例17图2)。眼部B超未见异常。视野: 右眼下方弓形暗点及鼻上象限缺损,左眼旁中心暗点(病例17图3)。眼轴长度: 右眼21.6mm,左眼21.5mm。

注: A、B分别示右眼和左眼虹膜周切口通畅,瞳孔不圆, 虹膜部分后粘连;c、D分别示右眼和左眼中央前房1CT, 周边前房几乎消失


注:A示右眼下方弓形暗点及鼻上象限缺损, B示左眼旁中心暗点
1.该患者的诊断?
2.该患者如何治疗?
答案:
1.诊断
(1)双眼睫状环阻滞性青光眼
(2)双眼并发性白内障。
(3)双眼高度近视。
(4)双眼抗青光眼术后。
2.治疗
入院后给予双眼复方托品卡胺眼液3次/天麻痹睫状肌治疗,拟行右眼白内障超声乳化吸出+人工晶体植入+房角分离+前部玻璃体切割术。
问题 747
患者,男, 46岁,因“左眼视力下降3个月, 胀痛伴头痛2周”之主诉就诊。
现病史:3个月前患者无明显诱因出现左眼视力下降, 就诊于当地医院,诊断为“左眼视网膜中央静脉阻塞”(病例18图1), 给予药物保守治疗(具体不详),视力无明显改善, 患者就诊于西安某三甲医院,眼底出血、水肿进一步加重(病例18图2), 给予玻璃体腔注射抗血管内皮生长因子(vascularen-dothelialgrowthfactor,VEGF)药物治疗。近2周患者出现左眼胀痛, 伴头痛、鼻根部抽痛,再次就诊于当地医院, 诊断为“左眼新生血管性青光眼”,给予降眼压药物治疗, 建议上级医院诊治。6天前患者就诊于我院眼科门诊,测量眼压右眼13.3mmHg, 左眼T+2,为行左眼青光眼手术治疗收入院。

注: 视盘边界不清,充血水肿, 视网膜大片火焰状出血,视网膜水肿

注: 视盘高度充血水肿,视网膜广泛出血水肿
既往史: 心绞痛病史6年,高血压病史3年, 口服药物血压控制平稳。
家族史、个人史均无特殊。
眼部检查:视力: 右眼1.0,左眼光感/20cm(颞侧)。眼压: 右眼11.7mmHg,左眼43.5mmHg。右眼前后节未见明显异常。左眼结膜混合性充血, 角膜水肿,Kp(+), 前房深,房闪(+), 浮游细胞(+),瞳孔直径5mm, 对光反射迟钝,瞳孔缘色素外翻, 瞳孔下缘可见新生血管(病例18图3),晶状体皮质混浊, 眼底窥不入。眼部B超未见异常。因左眼角膜水肿未做房角镜检查。

注:结膜混合性充血, 角膜水肿,瞳孔5mm, 瞳孔缘色素外翻,瞳孔下缘可见新生血管
1.该患者的诊断?
2.该患者如何治疗?
答案:
1.诊断
(1)左眼新生血管性青光眼。
(2)左眼白内障。
(3)左眼视网膜中央静脉阻塞。
2.治疗
入院后予左眼卡替洛尔滴眼液2次/天,布林佐胺滴眼液3次/天,溴莫尼定滴眼液3次/天联合甘露醇250ml静脉滴注降眼压治疗,同时予半球后注射地塞米松注射液2.5mg减轻高眼压导致的炎症反应。排除手术禁忌证后在局麻下行左眼复合式小梁切除术
问题 748
患者,男, 50岁,因“双眼视力下降4个月, 加重5天”入院。现病史:患者4个月前无明显诱因开始出现双眼视力下降, 无明显眼胀、虹视、头疼等不适,当时未重视, 未就诊。5天前出现双眼视力下降明显,伴眼胀不适, 于当地医院检查眼压高,诊断为“双眼青光眼”, 予降眼压药物治疗(拉坦前列腺素滴眼液、卡替洛尔滴眼液及甘露醇注射液静脉滴注),效果不佳, 患者为求进一步诊治遂来我院。
既往史:确诊“鼻咽癌”5年, 曾行放疗、化疗(具体方案和剂量不详)。2年前双眼因“泪囊炎”行手术治疗。诊断“陈『日性肺结核”1年,无明显症状, 未治疗。家族史无特殊。
入院眼部检查:视力: 右眼0.6,左眼0.2, 眼压:右眼46.5mmHg(用药情况下), 左眼53.9mmHg(用药情况下)。双眼角膜透明,Kp(-), 前房深,房闪(-), 虹膜瞳孔缘可见新生血管(病例19图1)。双眼瞳孔圆,右眼直径约3mm, 对光反射存在,左眼直径约4mm, 对光反射迟钝。双眼晶状体皮质轻度混浊。眼底:右眼视盘边界清, 色稍红,可见细小新生血管, 视网膜平伏;左眼视盘边界清, 色淡,C/D约0.6, 视网膜平伏.颞侧血管旁条索状出血,鼻侧和颞侧周边部视网膜血管呈白线状(病例19图2)。前房角镜检查双眼房角开放, 全周可见细小新生血管。视野检查:左眼管状视野, 右眼结果可’靠性差。OCT检查:左眼视盘上方和下方视网膜神经纤维层变薄。眼B超未见异常。FFA检查可见双眼视网膜周边部大量片状无灌注区, 末梢血管荧光素渗漏,其间多发新生血管, 提示为双眼视网膜静脉周围炎(病例19图3)。

注:A示右眼, 角膜透明,瞳孔直径3mm, 虹膜瞳孔缘可见细小新生血管;B示左眼, 角膜透明,瞳孔直径5mm, 虹膜瞳孔缘可见细小新生血管

注:A示右眼, 血管弓上方散在点状出血;B示左眼, 视盘颞下方血管旁条索状出血,鼻侧和颞侧周边部视网膜血管呈白线状

注: A1~A6(上方6张图)示右眼,视盘强荧光, 周边部视网膜可见新生血管荧光素渗漏及大片毛细血管无灌注区;B1~B6(下方6张图)示左眼, 视盘上方以及鼻侧近中周部新生血管网,周边部视网膜大片毛细血管无灌注区
1.该患者的诊断?
2.该患者如何治疗?
答案:
1.诊断
(1)双眼新生血管性青光眼。
(2)双眼视网膜静脉周围炎。
(3)双眼年龄相关性白内障。
2.治疗
入院后给予眼局部降眼压药物联合甘露醇注射液静脉滴注,为了尽快降低眼压,保护视功能,于行局麻下行左眼复合式小梁切除术
问题 749
患者,男, 75岁,因“左眼间歇性胀痛1个月”之主诉就诊。现病史: 1个月前患者着凉后突然出现左眼胀痛,伴视力下降、头痛、恶心、呕吐等不适, 就诊于当地医院,诊断为“倒睫”, 给予拔倒睫以及抗感染药物治疗(具体不详),上述症状无明显改善。近1个月来上述症状反复发作, 今为求进一步治疗就诊于我院,门诊以“左眼继发性青光眼”收入院。
既往史: 8个月前因咳嗽咳痰就诊于“唐都医院”,胸部CT提示右肺团块影, 考虑恶性肿瘤,支气管镜活检提示纤维组织增生伴慢性炎症, 6个月前复查胸部CT较前好转,1个月前再次咳嗽咳痰, 一直未予治疗,无发热、胸痛、胸闷、气短等不适。家族史无特殊。
眼部检查: 视力:右眼0.2, 左眼0.2。眼压:右眼6.5mmHg, 左眼9.9mmHg(用药情况下)。右眼结膜无明显充血,角膜透明, Kp(-),前房轴深4CT, 周边>1/2CT,房闪(-), 瞳孔圆,直径3mm, 对光反射迟钝,虹膜无前后粘连, 晶状体皮质、核混浊,眼底模糊见视盘边界清晰, 色淡红,C/D=0.4, 视网膜平伏。左眼结膜混合性充血,角膜上皮轻度水肿, Kp(-),前房浅, 中央2.SCT,周边1/2CT, 房闪(-),瞳孔不圆, 直径4mm,对光反射消失, 虹膜部分后粘连,鼻侧虹膜后可见占位性病变(病例20图1), 晶状体皮质、核混浊,眼底模糊可见鼻下方玻璃体腔占位性病变, 视盘界清色淡,杯盘比不清, 余观察不清。UBM提示左眼前房浅,房角关闭, 5:00~8: 30位,睫状体中低回声占位性病变, 5:00~9: 00位睫状体脱离(病例20图2)。眼部A超测量眼轴长度右眼23.54mm,左眼23.75mm。眼部B超提示左眼球壁团状不均匀中低回声, 凸向玻璃体腔,伴视网膜脱离(病例20图3)。眼部彩色多普勒超声提示球壁隆起肿物, 大小约14.7mm×9.5mm,边缘清晰, 显示膜样回声,眼部彩色多普勒超声血流成像(CDFI)示其周边可见散在的血流信号, 考虑视网膜或脉络膜隆起病变并膜下积血不除外(病例20图4)。

注:结膜混合性充血, 角膜上皮轻度水肿,前房浅, 瞳孔不圆,直径4mm, 鼻侧虹膜后可见占位性病变

注:A示房角关闭, 睫状体中低回声占位性病变;B示房角关闭, 睫状体脱离

注:球壁团状不均匀中低回声, 凸向玻璃体腔,伴视网膜脱离

注: 球壁隆起肿物,大小约14.7mm×9.5mm, 边缘清晰,显示膜样回声, CDFI在病灶周边可见散在的血流信号
1.该患者的诊断?
2.该患者如何治疗?
答案:
1.诊断
(1)左眼继发性青光眼。
(2)左眼球壁占位性病变(转移癌?黑色素瘤?)。
(3)眼睫状体脱离。
(4)左眼视网膜脱离。
(5)双眼年龄相关性白内障。
2.治疗
入院后给予布林佐胺滴眼液、卡替洛尔滴眼液降眼压治疗。眼眶CT提示左眼玻璃体腔弧形密度增高影,眼环后壁鼻侧结节状密度增高影,合并视网膜脱离、视网膜下积液。眼眶增强MRI提示:左眼球壁鼻侧下、后方可见丘状、弧状T

WI低信号、T

WI低信号影,其内信号欠均,增强扫描呈中等强化。胸部X线摄影正侧位片提示左上肺以及右上肺小片状影。呼吸科会诊,结合患者既往咳嗽咳痰病史,考虑肺部肿瘤待排,完善肿瘤标志物检查。非小细胞肺癌相关抗原21-1升高至5.04ng/ml(正常参考范围0~3.3ng/ml),此时高度怀疑眼部占位来自肺癌转移。
患者左眼前房浅,虹膜膨隆,房角关闭,入院后第3天在表面麻醉下行左眼YAG激光虹膜周边切开术。
问题 750
患者,女, 25岁,因“体检发现眼压高诊断高眼压症1年”就诊。
现病史: 患者1年前在外院体检时发现双眼眼压高,查日曲线眼压: 右眼21~26.4mmHg,左眼25.7~31.1mmHg, 中央角膜厚度(CCT):右眼542μm, 左眼537μm(具体测量方法不详),Octopus视野未见异常(病例21图1), 诊断为双眼高眼压症,给予前列腺素类滴眼液, 1次/晚,眼压可控制在正常范围。近2个月来患者停用降眼压药物, 为求进一步诊断和治疗就诊于我院。

既往史:双眼近视12年, 右眼-5.75DS=1.0,左眼-6.25DS=1.0。家族史: 父亲有高眼压症病史,奶奶有青光眼(具体类型不详)病史。
眼部检查: 矫正视力:双眼1.0, 眼压:右眼19.7mmHg, 左眼22.2mmHg。双眼角膜透明,Kp(-), 前房深,房闪(-), 虹膜无前后粘连,瞳孔等大等圆, 直径约3mm,直接、间接对光反射灵敏, 晶状体透明。眼底:双眼豹纹状, 视盘斜入,颞侧可见脉络膜萎缩弧, 视盘色淡红边界清,右眼C/D=0.3, 左眼C/D=0.5,左眼颞下方盘沿窄, 可见束状视网膜神经纤维层(RNFL)缺损(病例21图2)。双眼视网膜未见出血、渗出。前房角镜检查双眼房角开放。CCT:右眼552μm, 左眼548μm(超声角膜测厚法)。Hum-phrey视野:右眼正常, 左眼旁中心暗点(病例21图3)。RTVueOCT:右眼颞上、左眼颞下RNFL薄, 双眼视网膜神经节细胞复合体(GCC)变薄(病例21图4)。



1.该患者的诊断?
2.该患者如何治疗?
答案:
1.诊断
(1)双眼原发性开角型青光眼。
(2)双眼屈光不正。
2.治疗
继续给予前列腺素类滴眼液,1次/晚,嘱患者规律用药。
问题 751
患者,男, 31岁,以“右眼视物不清伴眼胀4年余”之主诉就诊。
现病史: 患者4年来无明显诱因下出现右眼视物不清,伴有眼胀, 偶有雾视,不伴眼红、头疼等不适, 未予重视。现自觉视物不清伴视野缩小来就诊。
既往体健,个人史、家族史无特殊。
查体: 患者右颞侧颜面部皮肤可见葡萄酒色血管瘤(病例22图1),余全身检查未见明显异常。眼部检查: 视力:右眼0.6, 左眼1.2。眼压:右眼28.0mmHg, 左眼13.7mmHg。右眼球结膜及巩膜可见血管瘤,角膜透明, Kp(-),前房深, 房闪(-),虹膜纹理清晰, 无前后粘连,瞳孔圆, 直径约3mm,对光反射迟钝, 晶状体透明,眼底视盘边界清, 色苍白,C/D=1.0, 视网膜平伏。左眼前后节无特殊。双眼房角镜检查:宽角, 全周开放,色素Ⅰ级。视野检查: 右眼颞侧视岛。吲哚菁绿脉络膜血管造影(ICGA):未见脉络膜血管瘤。头颅CT: 未见异常。

1.该患者的诊断?
2.该患者如何治疗?
答案:
1.诊断
(1)Sturge-Weber综合征。
(2)右眼继发性青光眼。
2.治疗
应用卡替洛尔滴眼液2次/天,布林佐胺滴眼液3次/天,溴莫尼定滴眼液3次/天降眼压后,如眼压控制不佳,局部麻醉下行右眼小梁切除术。
问题 752
患者,女, 62岁,因“左眼磨痛、视力下降2周”之主诉就诊。
现病史: 2周前患者无明显诱因出现左眼磨痛、视力下降,伴眼红不适, 就诊于我院眼科门诊,发现角膜上皮剥脱, 转至眼表专科。
既往史:高血压病5年, 2型糖尿病10年。1个月前在我院行左眼白内障超声乳化吸出人工晶状体植入术。
家族史及个人史均无特殊。
眼部检查:视力: 右眼0.6,左眼0.2。眼压: 右眼16.3mmHg,左眼15.5mmHg。右眼结膜无充血, 角膜透明,Kp(-), 前房深,房闪(-), 瞳孔圆,直径3mm, 对光反射灵敏,晶状体皮质混浊。左眼结膜充血, 角膜透明,Kp(-), 上皮弥散性点状剥脱,瞳孔下方弧形浅基质浸润灶(病例23图1A), 荧光素着染(病例23图1B),前房深, 房闪(-),浮游细胞(-), 瞳孔圆,直径3mm, 对光反射灵敏,人工晶状体位正。双眼底视网膜平伏, 视盘边界清,色淡红, C/D=0.3。

注:A示结膜充血, 角膜上皮点状剥脱,瞳孔下方弧形浅基质浸润灶; B示荧光素染色,上皮弥散性点状着染, 瞳孔下方片状着染
1.该患者的诊断?
2.该患者如何治疗?
答案:
1.诊断
(1)左眼干眼。
(2)左眼人工晶状体眼。
(3)右眼年龄相关性白内障。
2.治疗
给予左眼重组牛碱性成纤维细胞生长因子眼液4次/天,不含防腐剂的人工泪液3次/天,氟米龙滴眼液2次/天,同时嘱患者热敷左眼2次/天。
问题 753
患者,男, 40岁,因“右眼视力下降17小时”就诊。
现病史: 患者17小时前无明显诱因出现右眼视力下降,不伴有眼疼、眼胀、眼红等症状, 在当地医院就诊,诊断为“右眼视网膜中央动脉阻塞”(cen-tralretinalarterocclusion, CRAO),给予前房穿刺及药物治疗(具体不详), 患者自觉视力无改善,13小时前就诊于我院急诊眼科, 诊断为“右眼视网膜中央动脉阻塞”,给予尿激酶、长春西汀静脉滴注, 无好转,以相同诊断收
住院。
既往史: 否认糖尿病、高血压病史。个人史及家族史无特殊。
眼部检查:矫正视力: 右眼:LP, 左眼:1.0, 眼压:右眼16.7mmHg, 左眼17.1mmHg。双眼角膜透明,Kp(-), 前房深,房闪(-), 虹膜无前后粘连,瞳孔等大等圆, 直径约3mm,直接、间接对光反射灵敏, 晶状体轻度混浊,玻璃体絮状混浊。眼底: 右眼视盘边界欠清,色苍白, 后极部视网膜灰白水肿,视网膜动脉变细, 呈白线样,视网膜平伏, 黄斑区可见樱桃红点。左眼视盘边界清楚,色淡红, 视网膜血管走形比例可,未见明显渗出及出血, 动脉血管变细,黄斑中心凹反光可见(病例24图1)。FFA示: 右眼动脉充盈明显延迟(病例24图2至病例24图4)。




1.该患者的诊断?
2.该患者如何治疗?
答案:
1.诊断
右眼CRAO。
2.治疗
入院当天(约发病22小时后)紧急行经右侧滑车上动脉穿刺眼动脉逆行溶栓术
问题 754
患者,男, 48岁,工人, 因“高压电击中左侧头部1个月,视力下降1周”之主诉就诊。
现病史: 患者1个月前高空作业时被高压电击中左侧头部,立即意识丧失, 半小时后自行苏醒后送至当地医院,发现左侧头部及右侧上臂大面积皮肤深Ⅱ度电击烧伤, 给予对症治疗。1周前自觉左眼视力逐渐下降,遂再次就诊于当地医院, 诊断为左眼电击性白内障,行左眼白内障超声乳化吸出联合人工晶状体植入术, 术后视力0.6。术后1周患者自觉左眼视力下降伴视物变形,遂就诊于我院眼科。
既往史、个人史及家族史均无特殊。
眼科检查: 视力右眼0.8,左眼0.3。双眼角膜透明, 前房深,房闪(-), 瞳孔圆,直径3mm, 对光反射灵敏,右眼晶状体透明, 左眼人工晶状体在位。右眼底未见明显异常,左眼底视盘边界清, 色淡红,视网膜动静脉血管走形可, 黄斑色素紊乱,中心凹反光不清, 视网膜未见明显出血、渗出及隆起。免散瞳眼底照相(Optos200Tx)提示左眼视网膜黄斑区一黄白色斑点(病例25图1)。眼底自发荧光(FAF):左眼视网膜黄斑区可见一点状强荧光(病例25图2)。OCT(海德堡HRA+OCT)显示左眼黄斑中心凹神经上皮局限性水肿, RPE完整(病例25图3)。


注:左眼底脂褐素相关自发荧光(FAF)黄斑区可见一点状强荧光

1.该患者的诊断?
2.该患者如何治疗?
答案:
1.诊断
(1)左眼电击伤性黄斑病变。
(2)左眼人工晶状体眼。
2.治疗
给予患者抗炎、活血及营养神经等对症治疗。1个月后患者复诊,考虑是否给予YAG激光晶状体后囊切开术,余治疗同前。
问题 755
患者,男, 55岁,以“左眼视力下降半个月”为主诉就诊。
现病史: 半月前患者无明显诱因出现左眼视力下降,无眼红、眼痛等不适, 发病后未予任何诊治,现就诊于我院眼科。
既往史: 既往体健,个人史无特殊。无遗传性家族史。
眼部检查: 视力:右眼1.2, 左眼0.15。眼压:右眼12.5mmHg, 左眼15.9mmHg。双眼外眼(-),结膜无充血, 角膜清亮,Kp(-), 前房深,房闪(-), 瞳孔圆,直径3mm, 对光反射灵敏,晶状体透明。眼底: 右眼未见异常。左眼视盘色淡红,边界清, C/D=0.3,颞上血管弓周围可见视网膜下2PD大小橘红色隆起性肿物, 表面光滑,无出血及渗出, 黄斑区神经上皮浆
液性脱离。眼部彩色多普勒超声检查:左眼球后壁占位性病变, 考虑为脉络膜血管瘤(病例26图1)。荧光素眼底血管造影(FFA)检查:早期左眼颞上血管弓周围可见脉络膜血管形态强荧光, 中晚期荧光素渗漏融合,成一个强荧光斑团, 病灶周围视网膜荧光素积存,累及黄斑区, 考虑为左眼脉络膜血管瘤(病例26图2)。

注:眼球后壁可见一个扁平状肿块, 大小约6.4mm×2.4mm,自视盘周围向玻璃体内隆起, 隆起度约2.4mm,边缘光滑整齐, 内部呈实质均质性强回声,未见有脉络膜凹陷征和声影, 肿块前面有膜样带状回声,CDFI示其内散在血流信号

注: 左眼颞上血管弓周围可见2PD大小橘红色病灶(箭头),早期可见脉络膜血管形态强荧光, 中晚期荧光素渗漏融合,成一个强荧光斑团, 病灶周围视网膜荧光素积存,累及黄斑区
1.该患者的诊断?
2.该患者如何治疗?
答案:
1.诊断
(1)左眼脉络膜血管瘤。
(2)左眼渗出性视网膜脱离。
2.治疗
给予经瞳孔温热疗法(TTT),SLX810nm型红外半导体激光治疗仪(IRIS公司),激光治疗参数:波长810nm,功率350~800mW,光斑直径依脉络膜血管瘤的直径而定,本病例选择光斑直径2mm,每个光斑照射60秒。治疗范围:以光斑覆盖对准橘红色病灶进行治疗,治疗范围为病灶最大径线稍扩大一些。为了控制血管瘤发展,TTT治疗后第3天给予雷珠单抗(0.5mg/0.05ml)玻璃体腔注射。
问题 756
患者,女, 57岁,以“右眼视力下降伴中心暗影5个月”之主诉就诊。
现病史: 5个月前患者无明显诱因自觉右眼视力下降伴中心暗影,无畏光、流泪, 无眼红、眼痛等其他不适,为求诊治患者就诊于我院眼科门诊。
既往史、个人史及家族史无特殊。
眼部检查: 视力:右眼0.05, 左眼0.4。眼压:右眼13mmHg, 左眼16.2mmHg。双眼结膜无充血,角膜透明, Kp(-),前房深, 房闪(-),瞳孔圆, 对光反应灵敏,晶体轻度混浊。眼底: 右眼视盘边界清,色淡红, 视网膜平伏,黄斑区可见约2PDx3PD大小灰黄色病灶, 伴视网膜下出血、渗出;左眼视盘边界清, 色淡红,视网膜平伏, 视盘及黄斑之间散在灰黄色病灶,黄斑中心凹反光不清(病例27图1)。右眼FFA+ICGA: 早期黄斑区片状弱荧光,脉络膜低灌注, 黄斑上方可见强荧光新生血管形态,中晚期荧光素渗漏。右眼OCT: 黄斑RPE-脉络膜毛细血管层中断,局限性增厚向上隆起, 下方高反射团块,视网膜层间液性暗区以及颗粒状高反射信号(病例27图2)。


1.该患者的诊断?
2.该患者如何治疗?
答案:
1.诊断
(1)双眼年龄相关性黄斑变性(右眼CNV型)。
(2)双眼年龄相关性白内障。
2.治疗
给予右眼雷珠单抗(0.05ml)玻璃体腔注射。术后第3天行右眼光动力治疗,光照剂量50J/cm

,光照射时间83秒,治疗区域3000μm,术后避光48小时。
问题 757
患者,女, 33岁,因“双眼急剧视力下降2天”就诊于我院。
现病史: 2天前患者无明显诱因出现双眼视力急剧下降,伴头痛, 无恶心、呕吐、颈项强直,无耳鸣、听力下降等不适, 无头发变白等,为求治疗患者就诊于我院眼科。
既往史、个人史、家族史均无特殊。
眼科检查: 视力:右眼0.05, 左眼0.12;眼压: 右眼12.SmmHg,左眼12.8mmHg。双眼角膜透明, Kp(-),前房深, 房闪(-),晶状体透明, 玻璃体可见炎性细胞。眼底(散瞳后):视盘边界清, 色稍红,视盘周围以及血管弓周围多发泡样视网膜灰白色病灶, 黄斑区视网膜放射状皱褶。FFA:动静脉期视盘周围、黄斑区片状弱荧光, 中晚期视盘荧光增强,视盘周围以及后极部视网膜泡样脱离区呈多湖状荧光素积存, 周围多发针尖样强荧光。ICGA:后极部以及血管弓周围大量小片状弱荧光斑, 提示脉络膜层的炎症(病例28图1、病例28图2)。

注:A: 视盘周围视网膜泡状灰白色病灶;B: FFA动静脉期,视网膜泡样脱离区呈弱荧光; C~H:FFA中期, 视网膜泡样脱离区呈弱荧光,脱离区周围荧光素积存以及针尖样强荧光; I:FFA晚期, 多湖状荧光素积存,视盘强荧光

注: A:视盘周围视网膜泡状灰白色病灶、黄斑区视网膜皱褶; B:FFA动静脉期, 视网膜泡样脱离区弱荧光;C~E: FFA中期可见视网膜泡样脱离区弱荧光,脱离区周围荧光素积存及针尖样强荧光点; F:FFA晚期, 多湖状荧光积存,视盘强荧光; G:ICGA早期, 多发弱荧光斑;H: ICGA中期散在强荧光渗漏点;I: ICGA晚期,视盘周围强荧光渗漏点仍未退散, 视网膜脱离区呈弱荧光
1.该患者的诊断?
2.该患者如何治疗?
答案:
1.诊断
Vogt-小柳原田病(葡萄膜炎期)。
2.治疗
给予甲基泼尼松龙琥珀酸钠注射液500mg静脉滴注,每天1次,连续3天,同时给予患者补钾、补钙和保护胃黏膜治疗。
问题 758
患者,男, 32岁,因“右眼视力下降伴鼻侧固定黑影遮挡5天”就诊。
现病史: 患者5天前无明显诱因出现右眼视力下降,伴鼻下方黑影遮挡, 黑影迅速扩大,未受外伤, 为求诊断和治疗就诊于我院。
既往史:双眼高度近视23年, 11年前在西京医院行“双眼角膜屈光手术”。个人史、家族史无特殊。
眼部检查:视力: 右眼0.06(矫正不提高),左眼0.3(矫正不提高), 眼压:右眼8.3mmHg, 左眼17.2mmHg。右眼结膜无充血,角膜透明, 前房深,瞳孔圆, 直径3mm,对光反射灵敏, 晶状体无明显混浊,玻璃体可见较多色素颗粒, 眼底视盘边界清,色淡红, 5:00~3: 00位视网膜脱离,累及黄斑, 5:00~11: 00位周边视网膜裂孔形成,孔缘翻转, 2:00位周边视网膜可见大小约1.5PD马蹄形裂孔(病例29图1); 左眼结膜无充血,角膜透明, 前房深,瞳孔圆, 直径3mm,对光反射灵敏, 晶状体无明显混浊,玻璃体部分液化, 眼底视盘边界清,色淡红, 视网膜平伏,呈豹纹状眼底改变, 10:30~3: 00位赤道部视网膜格子样变性区。

注:5: 00~11:00位视网膜裂孔形成, 孔缘翻转,2: 00位周边视网膜约1.5PD大小马蹄形裂孔
1.该患者的诊断?
2.该患者如何治疗?
答案:
1.诊断
(1)右眼巨大裂孔性视网膜脱离。
(2)左眼视网膜变性。
(3)双眼角膜屈光手术后。
2.治疗
右眼:在神经阻滞麻醉下行玻璃体切割+视网膜激光光凝+重水/硅油置换术
问题 759
患者,男, 39岁,因“双眼视力下降5个月”就诊。
现病史: 患者5个月前血糖波动较大,出现双眼视力下降, 视物模糊,一直未予重视, 1周前就诊于我院眼科门诊,检查发现右眼视网膜广泛纤维血管膜形成, 建议手术治疗。
既往史:2型糖尿病5年, 阿卡波糖50mg,三餐时嚼服; 格列美脲6mg,午餐前30分钟口服。屈光不正20年。
眼部检查: 视力右眼0.02,矫正0.04, 左眼0.15,矫正0.4, 眼压:右13.4mmHg, 左16.6mmHg。右眼结膜无充血,角膜透明, 前房深,瞳孔圆, 3mm,对光反射灵敏, 晶状体混浊C3NIP1,眼底视盘边界清色淡红, 视盘新生血管,视盘及视盘上方可见广泛视网膜前纤维血管膜形成, 伴局限牵拉性视网膜浅脱离(病例30图1)。左眼结膜无充血,角膜透明, 前房深,瞳孔圆, 3mm,对光反射灵敏, 晶状体混浊C3NIP1,眼底视盘边界清色淡红, 后极部至赤道部视网膜可见大量微血管瘤,局部可见棉絮斑。入院查糖化血红蛋白7.5%。

注: 视盘及视盘上方大面视网膜前纤维血管膜形成,伴局限牵拉性视网膜浅脱离
1.该患者的诊断?
2.该患者如何治疗?
答案:
1.诊断
(1)糖尿病性视网膜病变(右眼增生期左眼重度非增生期)。
(2)代谢性白内障(双眼)。
(3)屈光不正(双眼)。
(4)糖尿病。
2.治疗
围术期请内分泌科会诊后给予胰岛素泵控制血糖。右眼:在神经阻滞麻醉下行白内障超声乳化+人工晶体植入+玻璃体切割+视网膜前膜剥离+全视网膜激光光凝+注硅油术
问题 760
患者,男, 23岁,因“右眼视力下降2天”就诊。
现病史: 2天前患者无明显诱因出现右眼视力下降,上方黑影遮挡, 无眼红、眼痛,就诊于我院眼科门诊。
既往史: 屈光不正病史5年,未戴镜治疗。
眼部检查: 视力:右眼0.02, 矫正无提高,左眼0.12, 矫正1.0。眼压:右眼9.8mmHg, 左眼12.2mmHg。双眼前节未见明显异常。右眼玻璃体内可见棕色色素颗粒,眼底视盘界清色淡红, 下方视网膜青灰色、近圆形隆起,累及黄斑区, 视盘下方至下方视网膜可见Y形视网膜前增生膜,膜内可见血管, 膜下见数个视网膜撕裂孔,黄斑下方视网膜下膜, 颞下视网膜血管部分
白线状(病例31图1)。左眼视盘界清色淡红,A: V=2/3,视网膜平伏, 黄斑中心凹反光欠清,颞侧周边部分网膜血管迂曲。OCT检查提示右眼黄斑区神经上皮脱离(病例31图2)。眼部B超提示右眼视网膜脱离(病例31图3)。FFA检查提示双眼视网膜血管部分远端闭塞伴侧支循环形成以及新生血管荧光素渗漏(病例31图4、病例31图5)。




注: A:黄斑下方及视网膜血管鼻下支区域脉络膜背景荧光低; B、C:视网膜下方黄斑静脉分支小血管及毛细血管扩张, 可见微血管瘤;D、E: 视网膜颞下支静脉远端闭塞,侧支循环形成, 新生血管荧光素渗漏;F: 视网膜血管鼻下支区域脉络膜背景荧光低;G: 视网膜鼻下支静脉远端迂曲,有侧支循环形成, 管壁荧光素着染;H: 视网膜下方静脉远端闭塞,侧支循环形成, 新生血管荧光素渗漏;I: 晚期可见视网膜下方黄斑静脉末端瘤样扩张,侧支循环形成, 新生血管荧光素渗漏

注:A、B、D、F: 视网膜静脉颞下支远端闭塞,可见微血管瘤, 新生血管荧光素渗漏;C: 视网膜静脉鼻下支远端侧支循环形成,可见血管瘤
1.该患者的诊断?
2.该患者如何治疗?
答案:
1.诊断
(1)双眼视网膜静脉周围炎
(2)右眼视网膜脱离
(3)右眼增生性玻璃体视网膜病变
(4)双眼屈光不正
2.治疗
入院后完善胸片以及结核菌素试验。排除手术禁忌证后,在局部麻醉下行右眼玻璃体切除、剥膜、光凝、注硅油术(23G)。